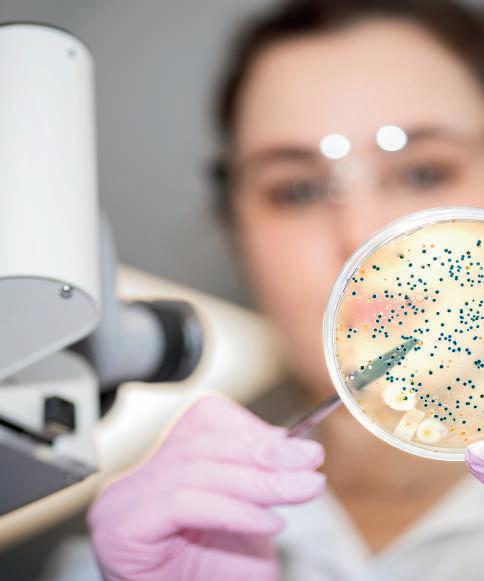

1 June - 15 June 2024

Vol. 20 Issue 11, Pages 220
FORMULATERS PRODUCT PROFILE: 116-118 20th Years of Publications















Vol. 20 Issue 11, Pages 220 LORNOXICAM INH ETHYL OLEATE IP/BP/ USP SUCRALFATE USP With GMP and DMF For More Products Please Visit Page No. 29 marketing@progresslifesciences.com +91 22 4978 1414 Manufacturer and Exporter of P PR RO OG GR RE ES SS S LI IFFE E S SCCIIEENNCCEES S P PVVT T L LT TD www.mazadapharmaguide.com 1 June - 15 June 2024 PRUDENCE PHARMA CHEM – Ankleshwar sales@prudencepharma.com 0091-2646-222825 Cell No: + 91-9825205460 / 9624042444 MANUFACTURER & EXPORTER OF l RIVAROXABAN l MEMANTINE l SILODOSIN l GLIMEPIRIDE l TORSEMIDE l FEBUXOSTAT l GLIBENCLAMIDE l CELECOXIB l ETORICOXIB l LEVAMLODIPINE l PIRFENIDONE lll lll Manufacturing & Exporting Superior Quality Precious Metal Chemicals, Compounds of Rhodium, Gold, Silver, Palladium, Platinum, Iridium, Osmium, Ruthenium, Indium, Bismuth, Molybdenum Etc. INdIAN PlATiNUM PVT. LTd. Email: indianplatinum@gmail.com For Product Refer Page No. 170 FORMULATERS PRODUCT PROFILE: 116-118 20th Years of Publication
THE MAZADA PHARMA GUIDE 3

4 THE MAZADA PHARMA GUIDE

THE MAZADA PHARMA GUIDE 5




6 THE MAZADA PHARMA GUIDE



THE MAZADA PHARMA GUIDE 7

ADD:- C-208, Ashok Nagar Co-Op Hsg. Society, Ambadi Road, Vasai Road (W). Dist-Palghar- 401202
Tel No:- 0250- 2338969/2346503, Mob No:- Mr. Manish Shah: 9923413821 & Sales: 7768057208
Email:- sales@kahanpharmaceuticals.com; info@kahanpharmaceuticals.com Visit us:- www.kahanpharmaceuticals.com
READY STOCK PRODUCT
1ALBENDAZOLE (PLAIN / MICRONISED) 2ACECLOFENAC 3AMLODIPINE BESILATE IP
BETAMETHASONE DI PROPIONATE
CHLORZOXAZONE IP
CINNARAZINE IP
CITICOLIN SODIUM IP
DI HCL
PROPIONATE IP/USP
DAPOXETIN HCL I.H.S./IP
IP/IN-H
SODIUM PHOSPHATE IP/BP/USP
HBR IP/BP
IP
POTASSIUM
SODIUM IP/BP
IP/BP
MAGNESIUM IP/USP
IP / USP
PROPIONATE USP
82VITAMIN B12 IP SR.
42 LOSARTAN POTASSIUM USP
IN-H
HCL IP
ACID IP
MELOXICAM IP / BP
COBLAMINE IP / JP
MOMETASONE FUROATE IP / BP
MONTELUKAST IP
NIMESULIDE BP 52NIACINAMIDE 53 OLMESARTAN USP / IP
55ORNIDAZOLE
56OMEPRAZOLE MAGNESIUM IP / USP
57OXFENBENDAZOLE
58PARACETAMOL
58 PANTOPRAZOLE SODIUM IP / BP
60PHENYLEPHRINE HCL
61 PIROXICAM IP / BP / USP
62PREGABALIN
63POVIDONE IODINE
64 RABEPRAZOLE SODIUM IP
65RICOBENDAZOLE
66 SALBUTAMOL SULPHATE IP
67 SILDENAFIL CITRATE IP
68SILODOCIN IN-H
69 SODIUM PICOSULPHATE I.H.S.
70 SUMATRIPTAN I.H.S.
71SERRATIOPEPTIDASE
72SITAGLIPTIN PHOSPHATE
73SUCRALFATE USP
74 TADALAFIL
75 TERBINAFINE HCL IP / BP / EP
76 TERBUTALINE SULPHATE
77 TRICLABENDAZOLE IP
78TRANEXAMIC ACID
79URSODEOXYCHOLIC ACID
80VERAPAMIL HCL
81VIT. B25
C.P.M. PELLETS 4 MG
OMEPRAZOLE EC PELLETS (7.5% / 8.5%)
ESOMEPRAZOLE 40 MG EC + DOMEPERIDONE 30 MG SR
ESOMEPRAZOLE 40 MG + LEVOSULPIRIDE PELLETS 30 MG
PANTOPRAZOLE 40 MG EC + DOMPERIDONE 30 MG SR
RABEPRAZOLE 20 MG EC + LEVOSULPRIDE 75 MG SR
RABEPRAZOLE 20 MG EC + DOMEPERIDONE 30 MG SR
PANTOPRAZOLE 40 MG EC + LEVOSULPRIDE 75 MG SR ITRACONAZOLE
8 THE MAZADA PHARMA GUIDE
Quality and Service.”
“We belive in
(22% / 40%/ 44%) OMEPRAZOLE 20 MG+ DOMPERIDONE 10 MG PELLETS PELLE PELLETS PRODUDUCT LIST
4AZITHROMYCIN 5AMBROXOL 6
7
8
9
10
13
15DAPAGLIFLOZIN 16 DEXAMETHASONE
17 DEXTROMETHARPHON
18DIACERIN
19 DICLOFENAC
20 DICLOFENAC
21 DICYCLOMINE
22 DOMEPERIDONE
23 ESOMEPRAZOLE
24 ETORICOXIB
25 FEBUXOSTAT IP/IN-H 26 FENBENDAZOLE BP VET 27FEXOFENADINE 28 FLUCINOLONE ACETONIDE IP/BP 29 FLUCONAZOLE IP / USP 30 FLUPIRITINE MALEATE I.H.S. 31GABAPENTIN
33GLIMEPIRIDE
34 HALOBETASOLE
35
36 ISOXSUPRINE
37ITRACONAZOLE 38 LEVOCETRIZINE DI HCL IP 39LEVOFLOXACIN 40 LEVOSULBUTAMOL IP 41 LIGNOCAINE
IP
BP
USP
45 MEFENAMIC
46
47
48METFORMIN 49
50
BECLOMETHASONE IP
11CETIRIZINE
12CLOBETASOLE
14 DEFLAZACORT
BP
HCL IP
IP
32GUAIFENESIN IP
IRBESARTAN USP
HCL IP
HCL
/
/
43LULICONAZOLE
44MEBEVERINE
METHYL
51
54OFLOXACIN
NAME NO.
PRODUCT NAME NO.
PRODUCT
SR.





THE MAZADA PHARMA GUIDE 9

10 THE MAZADA PHARMA GUIDE



























THE MAZADA PHARMA GUIDE 11

12 THE MAZADA PHARMA GUIDE















Khushboo Scientific
15th Floor, Jolly Maker Chambers II, Nariman Point, Mumbai - 400 021, Maharashtra, India +91-22-4884 4859 / 98 sales@khushbooscientific.com www.khushbooscientific.com MumbaiDelhiChennai PuneAhmedabad

















THE MAZADA PHARMA GUIDE 13
World Class Lab Tes trumen For Business Inquiry ts
Authorized Distributors For
High - Performance Liquid Chromatograph (HPLC) Gas Chromatography (GC) Water Teas�ng Kit Benchtop Tintometer Model F/Fx Color Compartor Discs Spectrophometric Colorimeters PFXi Series Viscosity Standards Fluids
300 ViscoQC Accessories PTD 100 Cone-PlateHeli-Plus Portable Density meter DMA 35 USA UK Austria DIS A Paint & Powder CoatingCorrosion & WeatheringColour Spectro SurfaceAdhesive PackagingPlasticPaper Printing & Ink Oil/ Petroleum Chemical Pharma & Food Cosmetic Textile ISO 9001 2015 CERTIFIED 043QM-032 Certification
Fourier
Transform Infrared Radia
(FTIR)
ViscoQC
Quality Control Testing Instruments For ViscoQC 100 Swiss Analy al Semi-Micro / Micro Balances Compact Coulometric / Volumetric Easy KFV /Pro Titrators Halogen Moisture Analyzer (HE53, HE73 , HC103) UV Vis Spectrophotometer pH / Conduc�vity Meter




14 THE MAZADA PHARMA GUIDE
1& 2 Vaze Compound, Davadi Naka, MIDC Phase 1, Dombivli (E), Dist. Thane - 421203, India.
Email: psg.psgdrytech@gmail.com | Mob: 9820402073

THE MAZADA PHARMA GUIDE 15
PHASE TRANSFER CATALYST
Tetra Butyl Ammonium Bromide (TBAB)
Tri Ethyl Benzyl Ammonium Chloride (TEBAC)
Tetra Butyl Ammonium Hydrogen Sulphate (TBAHS)
Ethyl Tri Phenyl Phosphonium Bromide (ETPPBR)
Cetrimide (CT)
Strong Cetrimide Solution (CT SOL)
Phenyl Tri Methyl Ammonium Chloride (PTMAC)
Tetra Butyl Ammonium Iodide (TBAI)
Tetra Butyl Ammonium Hydroxide 40% Solution (TBAOH)
Tetra Ethyl Ammonium Bromide (TEAB)
Tetra Propyl Ammonium Bromide (TPAB)
Benzyl TriButyl Ammonium Chloride (BTBAC)
Tetra Butyl Ammonium Chloride (TBAC)
Cetyl Pyridinium Chloride (CPC)
Benzalkonium chloride 50% (BKC 50% / 80%)
INTERMEDIATES & SPECIALITY CHEMICALS
2-Cyanoacetamide (CAD)
N, N- Diisopropylethylamine (DIPEA)
Meta Bromo Nitro Benzene (MBNB)
Tri-n-Butyl Amine (TNBA)
Methyl Cyanoacetate (MCA)
Cis -Bromo Benzoate (CBB)
Cis Tosylate (CTS)
2 -Amino - 3, 5- Dibromobenzaldehyde (ADBA)
2,2 - Dibromo - 3 – Nitrilopropionamide (DBNPA)
BROMINE & BROMINE DERIVATIVES
Liquid Bromine (BR)
1-Bromo-3-chloropropane (1,3 BCP)
Hydrobromic Acid 48 % in water (HBR 48%)
Hydrobromic acid 33% in Glacial acetic acid (HBR 33%)
Hydrobromic Acid 62 % in water (HBR 62%)
N-Propyl Bromide (NPBR)
N-Butyl Bromide (NBBR)
Iso Propyl Bromide (IPBR)
Ethylene Di Bromide (EDBR)
Ethyl Bromide (EBR)
Hexyl Bromide / 1 Bromohexane (NHBR)
Allyl Bromide (ABR)
Pentyl Bromide (PBR)
N Bromosuccinimide (NBS)
1,3-Dibromo - 5, 5 Dimethyl Hydantoin (DDH)
1,3- Dibromo Propane (1,3-DBP)
1, 4- Dibromo Butane (1,4-DBB)
Sodium Bromide Powder / Sodium Bromide
Solution 45% (NABR)
Calcium Bromide Solution 52% (CABR 52%)
LITHIUM COMPOUNDS
Lithium Hydroxide Monohydrate (LIOH)
Lithium Bromide Powder / Lithium Bromide Solution
55% (Plain / Molybdate / Chromate base (LIBR)
Lithium Chloride Powder / 40 % Solution (Plain / Chromate base) (LICL)
Lithium Carbonate (LC)
Lithium Sulphate Anhydrous (LS)
Lithium Nitrate (LN)
Lithium Molybdate - Powder & Solution (LIMO)
Lithium Acetate (LA)
Lithium Stearate (LIS)
Lithium Hydroxy Stearate (LHS)








Mr. Rahul Rajpurohit / Mr. Chetan Satpute
N-4, Addl. M.I.D.C., Anand Nagar, Ambernath (E) - 421 506, Dist. Thane, (MH), INDIA. T :0251-2621525, 2620464, 2620415, Fax : 2620416 M :+91 93224 67890, +91 93211 65565
info@pacificorganicsltd.com , chetans@pacificorganicsltd.com rahulr@pacificorganicsltd.com
www.pacificorganicsltd.com
16 THE MAZADA PHARMA GUIDE
QM 003EM 004OHSMS 001
Pacific 0rganics Pvt Limited ISO 9001:2015, ISO 14001:2015 & ISO 45001:2018 CERTIFIED COMPANY BROMO OTBN (B-OTBN) CLICK TO DOW NLOAD PDF

MFG: ANIMAL, CATTLE, AQUA & POULTRY FEED SUPPLEMENTS / ADDITIVES
MANUFACTURING SPECIALITY
Choline Chloride 60%Cereal Base
Choline Chloride 60%Corn Base
Choline Chloride 50%Silica Base
Choline Chloride 50%Corn Base
Choline Chloride 75%Liquid
Choline Chloride 70%Liquid
Choline Chloride 60%Liquid
Choline Chloride 97-98%Pure
Di-Calcium Phosphate (Dcp)
Tri-Calcium Phosphate (Tcp)
Monocalium Phosphate (Mcp)
Toxin Binder (Datox)
Phytase 5000昀u/Granular/Powder
Cocktail Enzymes
Mono Sodium Phosphate
Vitamin Premix
MANUFACTURING SPECIALITY
Choline Chloride75/90/60 Liquid For Oil Driling
AGRO PRODUCTS
Rice Ddgs
Rice Bran
Rice Bran Oil
De Oil Rice Bran
Soyabeen Oil
Rice Gluten
Chickpeas
Groundnut Meal
Soyabeen Meal
Co琀onseed Meal
Rapeseed Meal
Cocopit Powder
Cereal Maize
Maize Bran Powder
Wheat Bran Powder
Rice Flour
Corn Flour
Corn (Yelloow Maize)
Soybean Meal
Soya Protein Powder
Soya Protein Isolate
Broken Rice
Wheat Grains

MINERALS
Hydrated Lime
Precipitataed Silica
Bentonite Powder
Quick Lime
Dolomite Powder
Dextrose Monohydrate
Salt (Sodium Chloride)
Table Salt
Industrial Salt
Iodised Salt
Copper Sulphate
Zinc Sulphate
Zinc Oxide


Ferrous Sulphate (Crysal/Powder)
Cobalt Sulphate
AMINO ACIDS
Dl-Methionine F.G.99%
L-Lysine (Hcl)
L-Theronine F.G.98.5%
OTHER PRODUCTS
Acidifier
Formic Acid
Bronopol
Humic Acid
Mono Sodium Glutante
Magnesium Sulphate
Manganese Sulphate
Sodium Bi Carbonate
Sodium Humate
Sodium Perborate
Sodium Percarbonate
Calcium Propionate
Calcium Carbonate
Calcium Sulphate
Calcium Chloride
Di Amonium Phosphate
Potassium Nitrate
Potassium Chloride
VITAMINS
Vitamin-A 1,00,000i.U
Vitamin-E 50%
Vitamin D 600/50,000 I.U
Vitamin Ad3 1000/200
Vitamin-Ad2
Vitamin-A 98.5%Liquid
L-Tryptophan 98.5%
Chlortetracycline 15%
Tylosin Phosphate 10%
Tiamulin Funerate 10%
ENZYMES
Phytase 5000 Granules
Xylanase
Alkaline Protease
Beta Glucanase
Cellulase
Lipase
Neutral Protease
Pec琀nase
Cocktail Enzyme
Enzymes With Probio琀cs

FISH MEAL POWDER
Steam Sterilized Fish Meal
Sun Dry Fish Meal
Aquaculture Fish Meal
60+ Protein Fish Meal Powder
DRY FISH FOR POULTRY
Dry Jawla Fish
Bhel Kuta Mix Dry Fish
Sun Dry Fish
SHRIMP MEAL POWDER
Shrimp Head Powder
Steam Shrimp Meal Powder
Shrimp Meal Powder
Steam Jawla Fish Powder
FISH OIL
OTHER FISH PRODUCTS
Castor Meal
Organic Manure
Fish Manure
Meat Bone Meal
Bone Meal


FLAVOURS & AROMA CHEMICALS AND OILS
HERBAL POWDERS
CONTRACT MANUFACTURING CAN BE DONE IF REQUIRED
Contact Us: 101 Neelkanth Apartment, F.p No. 284, Opp. Ram Mandir Extn. Road, Opp. Janki Mata Mandir, Vazira Naka, Borivali West, Mumbai, Maharashtra - 400091, India
Mob: Harish S. Anandpara: 91-9820048309 | Sagar H. Anandpara: 91-9930160151
Email: harishanandpara@yahoo.in / sagaranandpara007@gmail.com / info@sdaproducts.com Web: www.sdaproducts.in, www.indiamart.com/sdaproducts

THE MAZADA PHARMA GUIDE 17




18 THE MAZADA PHARMA GUIDE

THE MAZADA PHARMA GUIDE 19




20 THE MAZADA PHARMA GUIDE


THE MAZADA PHARMA GUIDE 21
DMPHARMA
Phno.:+914428172391/2/3/4 Email:sales@dmpharma.in

Web:www.dmpharma.in
PRODUCTSPRODUCTSPRODUCTS
Acebrophylline
AceclofenacIP/BP/EP
Acefylline
ALPHABETAARTEETHER
AmbroxolHcl
ARTEMETHER
ARTESUNATE
AscorbicAcidIP/BP/EP/USP
AtorvastatinCalciumCrystalline IP/BP/EP/USP
BenfotiamineIH
BifnozoleBP/EP
BromhexineHcl
Budesonide
CalciumCarbonate
CalciumIodide
CalciumLactate
CapsaicinPowder
CarbamazepineIP/BP/EP/USP
CaricaPapayaLeafdryextract 40%
CefuroximeAxetilAmorphous
Celecoxib
ChlorpheniramineMaleate
Chlorzoxazone
Cilinidipine
CiticolineSodium
ClindamycinPhosphate
ClobestasolePropionate
ClotrimazoleBP/EP/USP
Cycloserine
DanazoleIP/USP
Deflazacort
Desagestrel
Desloratadine
Desogestrel
DextromethorphanHBr
DextropoxypheneHydrochloride
DextropropoxypheneNapsylate
DiclofenacResinate
DicofenacDaenol
DicofenacDeithylamineBP
DicofenacEpolamine
DicofenacfreeAcid
DIHYDROARTEMISININ
DiphenhydramineHydrochloride
Doxophylline
Drospirenone
Dutasteride
Emtricitabine
Etofylline
FENOFIBRATE
FlucocinoloneAcetonide
FluconasonePropionate
Fluconazole
FolicAcidIP/Nutra
GabapentinIP/EP/USP
Gestidene
Glicazide
Glimepride
Guaifenesin
HalobetasolePropionate
HydrocholorothiazideEP/USP
HYDROXOCOBALAMIN
HYDROXOCOBALAMINACETATE
HYDROXOCOBALAMINCHLORIDE
HYDROXOCOBALAMINSULPHATE
IbuprofenIP/BP
IRONSORBITOL
Itraconazole
IvabradineHcl
KetoprofenEP
Levetiracetam
Levocetrizine
Levosalbutamolsulphate
Levosulpiride
Linelozid
LithiumCarbonate
L-methylfolate
Loratadine
Lornoxicam
Luliconazole
MagnesiumOxideLight/Heavy
Metadoxine
METHYLCOBALAMIN
MometasoneFuroate
Montelukast
N-AcetylcysteineBP
Niacinamide
Nicorandal
Nizatidine
OleoresinPaprika
Olmesartanmedixomil
OlmesartanMedoxomilEP/BP
Oxcarbazepine
ParacetmolIP/BP/USP
PotassiumIodide
PotassiumMagnesiumCitrate
PovidoneIodine
PovidoneIodineStabilised
QuinineHydrocholoride
QuinineSulphate
RactopamineHcl
RosuvastatinIP/EP
SAMe
SetralineBP/EP/USP
SevelamerCarbonate
SevelamerHCl
SilverSulfadiazine
SodiumCitrate
Teneligliptin
Tenofovir
Theobromine
Theophyllinie
ThiocolchecosideIP/FP
Tibolone
TretinoinUSP
Triamcinolone
TRIPROLIDINEHCL
TurmericCurcuminPowder95%
TurmericOleoresin
UlipristolAcetate
VenlafaxineBP/EP/USP
Venpocitine
Voglibose
Zincoxide
22 THE MAZADA PHARMA GUIDE





THE MAZADA PHARMA GUIDE 23




G-2 Om Mayureshwar Co-Op. Housing Society Limited, L. T. Road, Dharamdas Marg, Babhai Naka, Opp. Dwara Hotel, Borivali (West), Mumbai - 400 092. Tel. No.: 8655448030 | Email: novachemie1@gmail.com
l Amoxicillin Sodium Sterile
l Aceclofenac
l Albendazole
l Alpha Beta Arteether
l Ambroxol Hcl
l Amlodipine Besilate
l Ampicillin Plain/Comp/Sterile
l Artemether
l Artesunate ( Oral & Injectable )
l Azithromycin Dihydrate
l Beclomethasone Dipropionate
l Betamethasone Di Propionate
l Betamethasone Sodium Phosphate
l Betamethasone Valerate
l Brinzolamide
l Bupropion Hcl
l Caffeine Anhydrous
l Carisoprodol
l Cefixime Trihydrate Compoacted
l Cefalexin Compacted
l Cefadroxil
l Cefpodoxime Proxetil
l Ceftriaxone Sodium Sterile
l Cefoperazone Sodium Sterile
l Celecoxib
l Cetirizine Dihydrochloride
l Chlorzoxazone
l Chymotrypsin
l Ciprofloxacin Salts
l Citicoline Sodium
l Clarithromycin
l Clobetasol Propionate
l Clopidogrel Bisulphate
l Cloxacillin Plain/Comp/Sterile
l Colloidal Silicon Dioxide
l Dapoxetine Hcl
l Deflazacort
l Dexamethasone Sodium Phosphate
l Dextromethorphan Hbr
l Diclofenac Salts
l Dicloxacillin Sodium Sterile
l Dicyclomine Hcl
l Diethyl Carbamazine Citrate
l Di Dihydro Artemesinin
l Diloxanide Furoate
l Dimenhydrinate
l Diphenhydramine Hcl/Base
l Doxophylline
l Enrofloxacin
l Erythromycin Estolate
l Erythromycin Ethyl Succinate
l Erythromycin Stearate
l Esomeprazole Mg. Trihydrate
API PRODUCT LIST
l Etoricoxib
l Febuxostat
l Fenbendazole
l Fenofibrate
l Ferrous Ascorbate/Dc Grade
l Finasteride
l Flucinolone Salts
l Fluconazole
l Fluticasone Propionate
l Folic Acid
l Furosemide
l Glimepiride
l Glucosamine Hcl
l Glucosamine Sulphate Potassium Chloride.
l Glucosamine Sulphate Sodiumchloride.
l Hydrocortisone Salts
l Irbesartan
l Ketoconazole
l Levetiracetam
l Levocetirizine Hcl
l Levofloxacin Hemihydrate
l Levosulpiride
l Lornoxicam
l Luliconazol
l Lumefantrine
l Mefenamic Acid
l Meropenem Sterile

l Mesalamine
l Metformin Hcl
l Methyl Prednisolone Acetate
l Methylcobalamin
l Metoclopramide Hcl
l Metoprolol Succinate
l Metoprolol Tartrate
l Metronidazole Salts
l Miconazole Nitrate
l Mometasone Furoate
l Montelukast Sodium
l Moxifloxacin
l Niacin
l Niacinamide
l Nimesulide
l Nitazoxanide
l Norfloxacin
l Ofloxacin
l Olmesartan Medoxomil
l Ondansetron Hydrochloride
l Ornidazole
l Pancreatin
l Paracetamol
l Phenazone
l Phenytoin Base/Sodium
l Picosulfate Sodium
l Pioglitazone Hcl
l Pipercillin + Tazobactum
Sodium Sterile (8:1)
l Praziquantel
l Pregabalin
l Propyl Gallate
l Quinine Salts
l Risperidone
l Rosuvastatin Calcium
l Roxythromycin
l Secnidazole
l Serratiopeptidase Plain /Coated
l Silver Sulfadiazine
l Sulbactum Sodium Sterile
l Tamsulosin Hcl
l Tapentadol
l Telmisartan
l Teneligliptin Hbr
l Tetracycline Hcl
l Tolnaftate
l Tolfenamic Acid ( Oral & Injectable )
l Tricholine Citrate
l Trypsin
l Vildagliptin
l Vitamin B1 Hcl / Mono
l Vitamin B12 (Cyanocobalamin)
l Vitamin B2 (Riboflavin)
l Vitamin B2 5 Phosphate
l Vitamin B6 (Pyridoxol 5 Phosphate)
l Vitamin C ( Plain & Coated )
24 THE MAZADA PHARMA GUIDE
: All Products Available in IP / BP / EP / USP / JP Forms.
Note
BARODA
NEW BRANCH AT

◊ ASHWAGANDHA EXTRACT ◊ BLACK PEPPER EXTRACT 95% ◊ BOSWELLIA EXTRACT
◊ CRANBERRY EXTRACT
◊ CURCUMIN EXTRACT 95%
◊ GUGGUL EXTRACT 2.5%
◊ GINSENG EXTRACT 4%
◊ GINKGO BILOBA EXTRACT 24%
◊ MILK THISTLE EXTRACT 80%
◊ NATURAL CAFFEINE 99%


◊ ALMOND OIL ◊ ARGAN OIL ◊ BLACK SEED OIL ◊ EUCALYPTUS OIL ◊ FLAXSEED OIL ◊ OLIVE OIL
◊ SAW PALMETTO OIL
◊ PEPPERMINT OIL ◊ ROSEMARY OIL ◊ TEA TREE OIL
◊ ALOE VERA EXTRACT
◊ CHAMOMILE EXTRACT
◊ CALENDULA EXTRACT
◊ CUCUMBER EXTRACT
◊ GREEN TEA EXTRACT
◊ GRAPES SEED EXTRACT
◊ HIBISCUS EXTRACT
◊ LEMON PEEL EXTRACT
◊ LIQUORICE EXTRACT
◊ TURMERIC EXTRACT
◊ VITAMIN E ACETATE
THE MAZADA PHARMA GUIDE 25 Manufacturers & Exporters SCAN ME... DOWNLOAD BROCHURE PRODUCT LIST E-Mail: sales@global-merchants.in | Phone no.: +91 75065 06197 R-322, M.I.D.C., T.T.C. Industrial Estate, Rabale, Navi Mumbai, Maharashtra - 400701. India Web.:www.global-merchants.in HERBAL EXTRACTS ESSENTIAL | NATURAL OIL’S PERSONAL CARE EXTRACTS INGREDIENTS
◊
◊
◊
◊ CO ENZYME Q10 ◊ CREATINE MONOHYDRATE
D-BIOTIN
GLYCINE POWDER ◊ MCCP
PVP K-30 ◊ POTASSIUM SORBATE ◊ PROPYLENE GLYCOL ◊ SORBITOL POWDER



26 THE MAZADA PHARMA GUIDE
THE MAZADA PHARMA GUIDE 27

28 THE MAZADA PHARMA GUIDE

PROGRESS LIFE SCIENCES PVT. LTD.
ActivePharmaceuticalIngredientCASNumberDocumentationStatus NSAIDS
Meloxicam-BP/USP71125-38-7OpenpartDMFCommercial Lornoxicam-INH70374-39-9OpenpartDMFCommercial Tenoxicam-BP/USP59804-37-4-UnderDevelopment Piroxicam-BP/USP36322-90-4TechpackCommercial Piroxicam-β-Cyclodextrincomplex96684-40-1/121696-62-6-UnderDevelopment Pregabalin-INH/USP148553-50-8TechpackCommercial Respiratory
BromhexineHCl-IP/BP/USP611-75-6OpenpartDMFCommercial SalmeterolXinafoate-EP94749-08-3TechpackCommercial AmbroxolHCl-BP/USP23828-92-4-UnderDevelopment Anti-Allergic Fexofenadine-IP/BP/USP83799-24-0TechpackCommercial Cetirizine83881-51-0-UnderDevelopment Anti-Diabetic
Glimepiride-EP/USP93479-97-1TechpackCommercial Canagliflozin-INH842133-18-0TechpackCommercial Linagliptin-INH668270-12-0OpenpartDMFCommercial Sitagliptin-INH486460-32-6-UnderDevelopment Anti-Ulcer Sucralfate-USP54182-58-0TechpackCommercial Ophthalmic OlopatadineHCl140462-76-6-UnderDevelopment Excipient(Oleaginousbase)
EthylOleate-IP/BP/USP111-62-6TechpackCommercial ChlorobutanolHemihydrate6001-64-5UnderDevelopment Nutritionalsupplement IronSucrose8047-67-4-UnderDevelopment
Note:Productsarenotofferedincountrieswheretheyarecoveredunderpatent.However,ultimateresponsibilityremainsofthecustomer. Landline: +912249781414 Email: marketing@progresslifesciences.com;progress@progresslifesciences.com Web: www.progresslifesciences.com

THE MAZADA PHARMA GUIDE 29

A
D Pharmachem P h a r m a c h e m P v t L t d (ISO 9001:2015 & 14001:2015 Certified Company)
API / Agro Intermediates & Fine Chemicals Cas No.
N-Bromo Succinimide (NBS) 128-08-5
N-Butyl Bromide (NBB) 109-65-9
Tetra Butyl Ammonium Bromide (TBAB) 1643-19-2
Tetra Butyl Ammonium Hydrogen Sulphate (TBAHS) 32503-27-8
Tetra Butyl Ammonium Iodide (TBAI) 311-28-4
Tri Ethyl Benzyl Ammonium Chloride (TEBAC) 56-37-1
Phenyl Tri Methyl Ammonium Chloride (PTMAC) 138-24-9
4-Bromomethyl-2-Cyanobiphenyl (Bromo OTBN) 114772-54-2
Ethyl Tri Phenyl Phosphonium Bromide (ETPPBr) 1530-32-1
Methyl Tri Phenyl Phosphonium Bromide (MTPPBr) 1779-49-3
Iso Propyl 2-Bromo Iso Butyrate (IPBIB) 51368-55-9
Di Ethyl Bromo Malonate (DEBM) 685-87-0
Contact Manufacturer Unit 1 : G-39/9, MIDC, Waluj, Aurangabad - 431136, Maharashtra Unit 2 : A-86 MIDC, Paithan, Aurangabad - 431107 Maharashtra Mobile : +91 9326149185 l Email : adpharmachem@gmail.com

30 THE MAZADA PHARMA GUIDE

THE MAZADA PHARMA GUIDE 31

32 THE MAZADA PHARMA GUIDE



KINDLY CONTACT FOR YOUR

A-602, 6TH FLOOR, HERITAGE PLAZA, TELLI GALLI CROSS ROAD, NR. CITI POINT ANDHERI (EAST), MUMBAI – 400069. Tel. No.: + 91 22 4002 3345 /4002 4456 l E-mail : apex.pravinchandra@gmail.com
THE MAZADA PHARMA GUIDE 33 METHYLCOBALAMIN IP / JP HYDROXYCOBALAMIN METHYLPREDNISOLONE IP METHYLPREDNISOLONE ACETATE DIACEREIN IP / EP
WE OFFER FOLLOWING PRODUCTS BEING MANUFACTURED BY AURANGABAD
REQUIREMENT:









34 THE MAZADA PHARMA GUIDE


















SPECIALITY CHEMICALS
l Ortho Phthalaldehyde
l Glycolic Acid
l 4-Chlorothymol
l Cinnamyl Chloride
l Para Chloro Benzoyl Chloride
l Para Chloro Benzyl Cyanide
l Para Hydroxy Benzaldehye
l Ortho Toluic Acid
l Meta Toluic Acid
l Para Toluic Acid
l 3,5 Dimethyl Benzoyl Chloride
l Sodium Borohydride Powder
COSMETICS ENZYMES
l Lipase
l Protease
l Amylase
l Cellulase
PHARMACEUTICALS ENZYMES
l Veg Pancreatain(Ip/Bp/Usp)
l Animal Pancreatain(Ip/Bp/Usp)
l Lipase
l Serratiopeptidase
l Amylase
l Protease
l Trypsin
l Pepsin
l Bromelain
l Papain
l Lactase
l Chymotrypsin
l Pectinase
l Diastase
l Alpha-Galactosidase
l Nattokinase
INTERMEDIATES
Ethyl 1-(4-methoxyphenyl)-7-oxo-6- 503614-91-3 APIXABAN (4-(2-oxopiperidin-1-yl)phenyl)4,5,6,7tetrahydro-1h-pyrazolo[3,4-c]pyridine3-carboxyalate.
3-CHLORO-5,6-DIHYDRO-1- 536760-29-9 APIXABAN (4-NITROPHENYL)-2-(1H)-PYRIDINONE
2-(2-Hydroxyphenyl)-4H-1, 1218-69-5 DEFERASIROX 3-benzoxazin-4-one
(+/-)-3-carbamoylmethyl)-5- 181289-15-6 Pregabalin methylHexanoicAcid
4-Chloro4-HydroxyBenzophenone 4201-78-3 Finofibrate
ParaChloroBenzophenone 134-85-0 Levocetirizine Cetirizine (R)1-[1-(4-chlorophenyl) 130018-88-1 Levocetirizine phenylmethyl]piperazine
5-NitroSalicylicAcid 96-97-9 Mesalamine/5-Amino Salicylic Acid
Formamidine Acetate
3473-63-0 Itraconazole
2-Bromo-3-Chloropropiophenone 34911-51-8 Bupropion (+)Chloro phenyl glycine methyl ester 141109-14-4 Clopidogrel Bisulfate tartarate salt
(D-(+)-Methyl-(2-thienylethamino)2- 141109-19-5 Clopidogrel Bisulfate chlorophenyl)acetate hydrochloride
4-BromophenylAceticAcid 1878-68-8 Bilastine/Macitentan
Ethyl 2-Chloroacetoacetate 609-15-4 Apixaban
N.O-Dimethylhydroxylamine Hydrochloride 6638-79-5 Isoniazid
R-(+)-N-Benzyl-1-phenylethamine 38235-77-7 Chemical Synthesis for Pharma compound
4-Nitrobenzenesulfonyl chloride 56553-60-7 Foscmprenavir,Darunavir and Amprenavir
N-Butyl Nitril 544-16-1 New Generation nitrating agents Phthalide 87-41-2 Pharma Intermediates
Address: 211- B Wing ,Crystal Plaza ,Opp Infinity Mall Link Raod,Andheri(W).Mumbai-400054 Phone: +91 9920082277 | Email: sales@asielchempharma.com,asielchempharma@gmail.com | Web: www.asielchempharma.com
THE MAZADA PHARMA GUIDE 35
CAS NO END USE
























36 THE MAZADA PHARMA GUIDE
DIPTI CHEMICALS AND PHARMACEUTICALS
l Ce琀listat ODMF
l Linaglip琀n DMF
l Ledipasvir Co Povidine
l Sofosbuvir
l Tenofovir Alafenamide Fumarate ODMF
l Tofaci琀nib Citrate
l Velpatasvir Co Povidine API
ONCOLOGY PRODUCTS
l Abiratone Acetate
l Bosu琀nib
l Enzalutamide
l Erlo琀nib Hcl
l Gemcitamine HCL
l Ibru琀nib ODMF
l Ima琀nib Mesylate
l Olaparib
l Palbociclib
l Pazopanib
l Ventoclax
O
ffi
Amisulpride Intermediate
INTERMEDIATES
l 2-Methoxy-4-amino-5-ethylsulphonyl benzoic acid CAS NO 71675-87-1
Carprofen, Ketoprofen, Darifinacin Intermediate
l 2-Cyclohexene-1-one CAS NO 930-68-7. ( For Export Only)
Dapagliflozin, Empagliflozin, Bexagliflozin Intermediate
l 2-Chloro-5-bromo benzoic acid CAS NO 21739-92-4
Fingolimod Intermediate
l N-Octyl benzene CAS NO 2189-60-8
Linaglip琀n Intermediate
l 3 Methyl Xanthine
l 8-Bromo 3 Methyl Xanthine CAS NO 93703-24-3
l 8-Bromo-3-methyl-7-but-2-ynyl Xanthine CAS NO 666816-98-4
l 2-(Chloromethyl)-4-Methyl Quinazoline CAS NO109113-72-6
l R 3 Boc- Aminopiperidine CAS No : 309956-78-3
l Ortho Cyano Benzyl Bromide ( For Export Only )
l (2 R 4S)- 5-(Biphenyl 4 yl)-4-(tert-butoxycarbonyl amino) 2-methylpentanoic acid CAS NO 1012341-50-2
ce : 53, Highway Avenue, Sai Kripa Complex, Kashigoan, Mira Road-401107
Email : info@dip琀pharma.com, dip琀farma@gmail.com l Mobile No : 8448085663 / 9930305464 Works : 124/15 GIDC Nandesari Vadodara 391340 Gujarat
THE MAZADA PHARMA GUIDE 37
PRODUCT
Acyclovir IP
Ambroxol HCl IP/BP
Articaine HCl USP
Benfotiamine IH
Benzocaine IP/BP/USP
Bupivacaine HCl IP/BP/USP
Clotrimazole IP/BP/USP
Drotaverine HCl IP
Prilocaine HCl BP/USP
Lidocaine IP/USP
Valacyclovir HCl/USP
INTERMEDIATE & FINE CHEMICAL
PRODUCT
Cyclopentanone
Dicyclohexyl Ketone (DCHK)
Propiophenone
DL-Serine Hydrazide HCl
Ethyl (ethoxy methylene) cyano acetate
Meta-Chloropropiophenone
(3'-Chloropropiophenone)
2,3,4-Trihydroxybenzaldehyde
2,6 Diamino-4-chloro pyrimidine
2-chloro-n-(2-methylphenyl)
Propanamide
2-pipecolinoxylidide IH
APIs & INTERMEDIATES
Rishiraj Sharma
General Manager (India Sales) rishiraj@shamrockindia.com Mobile: +91 98205 35349
THERAPEUTIC CATEGORY
Antiretroviral
Mucolytic agent
Local Anesthetic
Vitamin B1
Local Anesthetic
Local Anesthetic
Antifungal
Antispasmodics
Local Anesthetic
Local Anesthetic
Antiviral
END USE
Irbesartan,Gliclazide, Cyclopentolate HCl
Dicyclomine Perhexiline
MCPP, Bupropion
Benserazide
Allopurinol
Bupropion
Benserazide
Minoxidil
Prilocaine
Bupivaicaine / Mepivacaine / Ropivacaine
OPERATION & LOGISTICS
Sahil Shah Sr.Executive (India Sales) sahil@shamrockindia.com Mobile: +91 97029 27092
DIRECTOR (INDIA SALES)
Jitendra Parakh
indiasales@shamrockindia.com Mobile: +91 97694 48078
CAS NO. 120-92-3
119-60-8 93-55-0
55819-71-1 94-05-3 34841-35-5 2144-08-03 156-83-2 19281-31-3 15883-20-2

38 THE MAZADA PHARMA GUIDE www.shamrockpharmagroup.com
R.O.: 83-E, Hansraj Pragji Building, Off Dr. E. Moses Road, Worli, Mumbai - 4000 018 Phone.: + 91 22 4077 8866 / 8877 (100 Lines)
APIs PRODUCTS PORTFOLIO










THE MAZADA PHARMA GUIDE 39


PARSHWA
PHARMA CHEM PRIVATE LIMITED
Kamlesh Doshi : DEALERS IN : PHARMACEUTICALS RAW MATERIALS, VITAMINS, FINE CHEMICALS, SOLVENTS, ESSENTIAL OIL & FOOD COLOURS
PARSHWA PHARMA CHEM IS A CONVENIENCE STORE / SOLUTION FOR ALL API / CHEMICAL / BULK DRUG / SOLVENT’S REQUIREMENTS
WE CAN PROVIDE ANY TIME ANY QUALITY ( SMALL / BIG ) OTHER THEN ABOVE AS PER YOUR VALUABLE REQUIREMENTS.
l ACCECLOFENAC
l ALBENDAZOLE
l ALLOPURINOL
l AMBROXOL HCL
l ATOMOXETANE HCL
l BROMHEXINE HCL
l CLOTRIMAZOLE
l CIPROFLOXACIN HCL
l CHLOROQUINE PHOSPHATE
l CHLORZOXAZONE
l CROSS CARMILOSE SODIUM
l CLOBETASOLE
l DICLOFENAC POTASSIUM
l DICLOFENAC SODIUM
l DICYCLOMINE HCL
l DROTAVERINE HCL
l DMR
l DEFLAZACORT
l DOMPERIDON
l ERYTHROYCIN STERATE
l ENROFLOXACIN
l FERROUS ASCORBATE
l FERROUS ASCORBATE DC GRADE
l FOLIC ACID
l FLUCONAZOLE
l GLYCERINE
l GLIMIPRIDE
l GRISOFULVIN
l IPA


l IVERMECTINE
l KETOCONAZOLE
l LACTOSE
l LEVOCETRIZINE HCL
l LISINOPRIL
l L LYSIN
l LORATIDINE
l MCCP
l METHYL COBALAMINE
l METHYL FOLATE CALCIUM
l METFORMIN HCL
l METRONIDAZOLE
l MAIZ STARCH POWDER
l NIACINAMIDE
l NIMUSULIIDE
l ORNIDAZOLE
l OFLOXACIN
l PARACETAMOL
l PENTOPRAZOLE SODIUM
l POVIDON IODIN
l PROGESTERONE
l PREGABALIN
l SUCRALFATE
l THIAMINE HCL
l TERBUTALINE SULPHATE
l TRIFLUPERAZINE HCL
l TRANEXAMIC ACID
l VITAMIN A ACETATE
Registered Add: A/06, Shivshakti Apt., Sangeetawadi, Shiv Mandir Road, Dombivli (E), Thane 421201, Maharashtra Office Add: Office no. 232, Commerce Plaza, Near godrej showroom, Manpada Road, Dombivali (E) 421201. Maharashtra Office: 7900001075 / 9323613209 | Email: doshikamlesh84@gmail.com
MAZADA PHARMA
40 THE
LIST
GUIDE
PRODUCT
Mr.
9325352677 9222241417 Chlorzoxazone USP Samarth l Serra琀opep琀dase Enzyme










THE MAZADA PHARMA GUIDE 41
CHEMICALS • BOROSIL / RIVIERA GLASSWARES • SCIENTIFIC INSTRUMENTS • SARTORIUS /PALL / MILLIPORE MAMBRANE FILTERS • PHARMA RAW MATERIAL • WHATMAN FILTER PAPERS • HPLC SOLVENTS / COLUMNS.
AUTHORISED STOCKISTS : METALAB / SHANTI SCI. INDUSTSRIES • JAYANT / SHITAL SCL. INSTRUMENTS • THOMAS BAKER CHEMICALS LTD. • SHIMADZU BALANCES
Dealers / Stockists : SDFCL• MERCK
We Stock & Supply :
Chemicals and Bio- Chemicals for Research and Industry Manufactured by Merck (Germany), BDH (UK), Sigma (USA), Aldrich (USA), Difco & Oxoid Culture Media , Lancaster (UK), ICN (USA).
Chemicals : Glaxo , E-merck, BDH, SRL -SD's , Ranbaxy, Loba - Chemie Spectrochem, Hi - Media.
Sartorius (German) / Pall (UK) / Millipore Membrane Filter Papers, Prefilteres and Filtration Assemblies, Filter Pads, all sizes with or without hole as per required sized, Filter Cartridges.

Whatman Filter Papers, Thimbles, Chromatography Sheets and Glass Microfibre Filters for Enviornment and Pollution Control Testing. Laboratory Sealing & Parafilm.
TLC/ HPTLC / Gas Chromatography Equipments and Spares, GC/ HPLC Grade Chemicals, Phases, Supports, Columns etc. Top/Hamilton (USA), SGE, Micro Syrings Reference Standards.
Pharmaceutical Raw Materials, Solvents ( Bulk & Small Packing).
Precoated TLC, Plates Merck
(Germany) for TLC/HPTLC. Certified Reference Material (Standards). Ethanol for UV & HPLC /AR 99.95% China /Hayman (UK) & Merck (Germany) Borosil / Riviera Glasswares, Glass Assemblies upto 200 Ltr. Hydrometers, Hygrometers
Silicawares, Proceleinwares, Tefton items, Tarson Plasticwares, Thermometers.
(with certificate for ISO 9000) Scientrific Instruments of Imported and Reputed Indian make, Quartiz Cells, Refractometers.
KIRAN TRADERS

l ACEBROPHYLLINE
l ACECLOFENAC BP/IP
l ALPHA LIPOIC ACID USP 28/30
l AMBROXOL
l AMOXYCILLIN TRIHYDRATE BP/IP COMP
l ATROVASTATIN CALCIUM IP
l AZITHROMYCIN IP/EP/USP
l BACLOFEN IP
l BETAHISTINE DI HCL IP
l BROMHEXINE HCL BP/IP
l CARBIDOPA IP
l CEFIXIME TRIHYDRATE IP (COMPACTED)
l CEFTRIAXONE SODIUM STERILE USP/IP
l CEFUROXIME AXETIL AMORPHOUS IP
l CHLORZOXAZONE USP
l CITICOLINE SODIUM IP
l D-BIOTEEN USP/EP
l DEFLAZACORT
l DICYCLOMINE HCL IP/BP
l ESCITALOPRAM OXALATE IP
l ETODOLAC IP
l ETORICOXIB IP
l FAROPENEM SODIUM
l GLICLAZIDE BP/IP
l ISOXSUPRINE HCL IP
l LEVO SALBUTAMOL SULPHATE IP
l LISINOPRIL USP
l LOSARTAN POTASSIUM IP/USP
l LULICONAZOLE IP
l MEFENAMIC ACID IP/BP
l METFORMIN HCL IP / BP
l METHYL COBALAMINE I.P
l METOPROLOL SUCCINATE USP/IP
l MONTELUKAST SODIUM IP
l NADIFLOXACIN IP
l OFLOXACIN IP
l ORNIDAZOLE IP
l OXACEPROL
l PANTAPRAZOLE SODIUM IP
l PARACETAMOL IP
l PAROXETINE HYDROCHLORIDE HEMIHYDRATE IP
l PREGABALIN I.P.
l PROCHLORPERAZINE MALEATE IP
l QUETIAPINE FUMARATE IP
l RANOLAZINE
l ROSUVASTATIN CALCIUM IP
l SALBUTAMOL SULPHATE
l SALBUTAMOL SULPHATE IP/BP
l SULTAMYCILLIN TOSYLATE
l TELMISARTAN IP/EP/USP
l TENELIGLIPTIN
l TERBINAFINE HYDROCHLORIDE EP/ USP/BP
l TERBUTALINE SULPHATE IP.
l TICAGRELOR
l TRANEXAMIC ACID IP
l URSODEOXYCHOLIC ACID IP/EP.
l VILDAGLIPTIN
42 THE MAZADA PHARMA GUIDE 43, Hanifabai Manzil, Room No. 18, Ground Floor, Kapad Bazar, Mahim, Mumbai – 400 016 Tel.: 24472816 | Fax: 24472817 | Mobile: 9323766144 Email: shriya97@hotmail.com / shriya@mtnl.net.in IMPORTERS & AGENTS: BULK DRUGS / CHEMICALS / SOLVENTS SHRIY SHRIYA PH PHARMRMA & SUR SURGICGICAL
PRODUCT LIST
• 3 M SOLUTIONS • MAHEK INDUSTRIES
•
• QUALIGENS • ACROSS • LANCASTER • WHATMAN • HIMEDIA
RANBAXY
SARTORIUS BOROSIL WATER PALL REMI HYPERSIL MILLIPORE TEMPO ZORABAX WHATMAN METALAB J & W SHIMADZU DHONA H. P. VITROSIL PATHAK SGE ZEAL TOP COLUMNS ERMA LABOMED HAMILTON • EXPORTERS • IMPORTERS • MANUFACTURERS • STOCKISTS 14/A, DEVKARAN MANSION COMPOUND, PATHAKWADI, PRINCESS STREET, MUMBAI - 400 002. TEL .: 022-2201 4039 / 022-40113132 / M-8082191974 E-mail : kirantraders1979@gmail.com ESTD.1979 SYRINGE FILTERS MILLIPORE / WHATMAN / INDIAN
AGR EN ENTERPRIERPRISES is an In India based ased distribu ribu琀on co compmpany es establiblished ed in 199991 Ever sinince ce our ur in incecep琀on, we are performinrming co consistently and offerinring standadard qualility ty pr prododucts to our ur clilients We have evolved ed as one of the leadeadining suppliuppliers of orgaganinic and in inorgaganinic chemimicacals ca caterinring to a numb number of do domes es琀c and in internrna琀onal clilients The co compmpany currurrently se serves es clilients ac across oss br broad oad specectrum rum of in industriries es rangining from ph pharmrmaceaceu琀ca cal, ag agrocochemimicacals, coa琀ngsgs, painint, dyeses, prin琀ng ink ink, cos cosme琀cs cs, pl plas as琀c & se several other in industririal ver琀ca cals
PRODUCT
ACETONE BENZENE ISOPROPYL ALCOHOL
1,2,3-TRICHLRO BENZENE
1,2,4-TRICHLORO BENZENE
2,3-DICHLORO NITROBENZENE
4-CHLRO BUTYRYL CHLORIDE
ANILINE OIL
CHLORINATED PARAFFIN
CHLORO SULPHONIC ACID DASDA
ISONOANOYL CHLORIDE
META DICHLORO BENZENE 70%
META NITRO CHLRO BENZENE
META NITRO TOLUENE
META TOLUDIDINE
MONO CHLORO BENZENE

MIX XYLENE PHENOL TOLUENE
NITROBENZENE
ORTHO DICHLORO BENZENE
ORTHO NITRO CHLORO BENZENE
ORTHO NITRO TOLUENE
ORTHO TOLUDINE
PARA NITRO CHLORO BENZENE
PARA NITRO TOLUENE
PARA TOLUDINE
PIVALOYL CHLORIDE
SODIUM NITRATE
SODIUM NITRITE
VALERYL CHLORIDE
VINYL SULPHONE ESTER
INDL. NITRO CELLULOSE
WE ARE OFFERING PRODUCTS DIRECTLY FROM MANUFACTURERS:
Chemieoieorgrganic ic Pvt. Ltd.
Steeeel Au Authority of India ia Ltd
GRN RN Ce Cellllulose Pvt. Ltd.
Rashtriya Ispspat Nigam Ltd
Registered Office 1132 / 33, Hubtown Solaris, Prof NS Phadke Marg, Opp. Telli Galli Signal, Andheri (East), Mumbai – 400069
Tata Steeeel BSL Ltd
Jindal Steeeel & Power Ltd.
Haldia ia Petrocochemicaicals Ltd
Deeeepak Phenolicics Ltd




THE MAZADA PHARMA GUIDE 43
6911 1111 (100 Lines)
Web:
Tel: +91 22
Email: sales@agr11.com
www.agr11.com Follow us:



44 THE MAZADA PHARMA GUIDE




THE MAZADA PHARMA GUIDE 45

46 THE MAZADA PHARMA GUIDE





THE MAZADA PHARMA GUIDE 47




Full Page 10,500/- 5,700/- 183mm x 250mm Half Page 6,000/- 3,000/- 183mm x 120mm
1/3 Page ---- 2,250/- 183mm x 78mm
1/4 Page 3,900/- 1,800/- 90mm x 120mm
1/6 Page ---- 1,125/- 90mm x 785mm
PREMIUM POSITION (M/C ONLY)
FRONT COVER 30,000/- FRONT INSIDE COVER 30,000/BACK COVER 22,500/- BACK INSIDE COVER 22,500/-
Advertise in Our Print Magzine & Get Free Advertisement in our Website: www.mazdapharmaguide.com
MAZDA PUBLICATIONS
Gala No. 1A, Sharma Compound, Old Nagardas Road, Andheri (East), Mumbai 400069, India.
Mobile: 9860066753 / 8652813388 / 9773223314
Email: mazdapharmaguide@gmail.com Web: www.mazdapharmaguide.com




48 THE MAZADA PHARMA GUIDE Send Your DD Favouring Mazda Publication Payble In Mumbai (India) On Below Address. You Can Pay Through Our Bank of Baroda A/c. 04150200000909 The Profile of users includes CEO, Director, Marketing Executive, Purchase Managers, R&D Personnel, Dealers, Importers / Exporters, Indentors, Consultants, Educational / Government Institutions, Libraries, Banks / Institutions & Consulates. Magazine Subscription Rate: 1 Years for Rs1,500/- (24 Issues) & 2 Years for Rs.3,000/- (48 Issues)
SIZE M/C B/W Dimensions

















THE MAZADA PHARMA GUIDE 49




50 THE MAZADA PHARMA GUIDE
NATURAL INGREDIENTS
NATURAL INGREDIENTS
Shea Butter (Refined)
Shea Butter (Refined)
Kokum Butter
Kokum Butter
Sandalwood Powder (Pure)
Sandalwood Powder (De-Oiled)
Sandalwood Hard Resin (Ethanol Based)
Sandalwood Hard Resin (Ethanol Based)
Sandalwood Hard Resin (Hexene Based)
Soapnut Extract Powder
Soapnut Extract Liquid
Soapnut Extract Liquid
ESSENTIAL
OILS
Lemongrass Oil
Citronella Oil (Java, Ceylon)
Gurujan Balsam Oil
Tea Tree Oil
Buddhawood Oil
Lavender Oil
Cinnamon Bark Oil
Cinnamon Leaf Oil
Cedarwood Oil
Mcgregory Oil
Saffron
Spices Grounds
Spice Extracts

www.aditiessentialoil.com
CORE PRODUCTS
CORE PRODUCTS
Sandalwood Oil (Indian, African, Australian)
Vetiver Oil (Haiti, Java, Indian)
Amyris Oil (Haiti)
Geranium Oil (Indian, Chinese, Egyptian)
Patchouli Oil (Indonesia, Sulawesi & Sumatra)
Sugandmantri Oil


OTHER PRODUCTS anubhav@aditiessentialoil.com amar@aditiessentialoil.com
THE MAZADA PHARMA GUIDE 51
DISTRIBUTION PARTNER OF AROMAX LLC. S. A. HAITI FOR VETIVER OIL AND AMYRIS OIL.
+91 9819785911 / 7738295007 +91 22 2682 3910

52 THE MAZADA PHARMA GUIDE


THE MAZADA PHARMA GUIDE 53
















































































































































































54 THE MAZADA PHARMA GUIDE

MARUTI PETROCHEM

SOLVENTS
l ACETONE ( IMPORTED )
l ACETONITRILE (IMPERIAL )
l TOLUENE (BULK / DRUMS)
l DI ISOPROPYL ETHER (CHINA / EXXON)
l ACETIC ACID (BULK / DRUMS)
l MIX XYLENE (IN DRUM / TANKER)
l EDC (IN BULK / DRUMS)
l MIBK(TAIWAN)
l BENZENE (IN DRUMS)

l ETHYL ACETATE – LAXMI (INTACT)
l TERTIARY BUTANOL
l IPA (DEEPAK/ LEE CHANG TAIWAN)
l BUTYL ACETATE (RUSSIA)
l CHLOROFORM
l MDC(GACL/CHINA/RUSSIA/SRF)
l CYCLOHEXANONE (TAIWAN)
l DMSO
l DI ISOPROPYL ETHER
l N BUTANOL (IN BULK / DRUMS)
l N PROPANOL (TAIWAN / GERMANY)
l TETRA HYDRO FURAN
l ORTHO- XYLENE (IN DRUMS)
l DIMETHYLFORMAMIDE -DMF (KOREA/TURKEY / CHINA)
l MENTHOL
l N PROPYL ACETATE (TAIWAN / GERMANY)
l METHOXY PROPANOL
l ETHYL CELLOSOLVE (IGL)
“We Access to Future”
Importers & Stockist of Speciality Chemicals and Solvents
CHEMICAL INTERMEDIATES
l 1,2,3, BENZOTRIZOLE (GRANULE)
l 1,2,3, BENZOTRIZOLE (NEEDLE)
l BENZYL ALCOHOL
l CAUSTIC SODA AND POTASH FLAKES
l CITRIC ACID MONO /ANHYDROUS
l CYCLOHEXANE ( CHINA)
l D TARTARIC ACID
l DEG (BULK/DRUMS)
l DEG (IN BULK/ DRUMS)
SPECIALITY CHEMICALS
l 4-FLUORO ANILINE
l AEROSIL
l TRIFLUORO ACETIC ACID
l LAURIC ACID
l ORANGE OIL (BRAZIL)
l PEG 400
l MEG (BULK /DRUMS)
l TEA 85%
l ALPHOX 200
l METHANE SULFHONYL CHLORIDE
l TEA 99%
l DEP l DETA/TETA ( DELAMINE)
l EPICHLOROHYDRINE
l ETHOXY PROPANOL
l FORMIC ACID 85% AND 99%
l GLYCERINE USP(VVF / GODEJ/ IMPORTED)
l HEDP 60%
l L+TARTARIC ACID (CHINA)
l LIQUID GLUCOSE
l METHOXY PROPYL ACETATE
l TRIFLUORO ACETIC ACID ANHYDRIDE
l DIBOC (DI-TERT-BUTYL DICARBONATE)
l DIPEA (N,N-DIISOPROPYLETHYLAMINE)
l OLEIC ACID
l ETHYL BENZENE
l TRISS BUFFER AR 99.9%
l GLUTARALDEHYDE
l SALICYLALDEHYDE
l SEBACIC ACID
l XANTHAN GUM

l MEG (IN BULK / DRUMS)
l MORPHLINE (IMPORTED )
l N METHYL PIPERAZINE
l PARAFORMALDEHYDE 91%-96% (SPAIN / CHINA)
l POTASH FLAKES
l POTASSIUM CARBONATE POWER & GRANULAR
l SODA ASH
l SORBITOL
l LIGHT LIQUID PARAFFIN
l TERT BUTYL DIMETHYL CHLOROSILANE
l MANNITOL
l SODIUM BOROHYDRIDE POWER
l PEG 200
l METHYLPARABEN
l PROPYLPARABEN
l PROPYLENE GLYCOL (USP SHELL SINGAPORE / KOREA)
l PROPYLENE GLYCOL – IMPORTED (TECHNICAL GRADE)
THE MAZADA PHARMA GUIDE 55
“We take pride in offering you, Only the BEST” ISO 9001:2015 cer琀fied Importers & Stockist of Speciality Chemicals and Solvents Sister Concern M'LUNIAS BIOCHEM OVERSEAS PRIVATE LIMITED Authorised Distributor of Ethyl Acetate for l Pure Material l No Shortage l Quick Delivery Head Office: 508-510, Goyal Trade Center, Opp. HDFC Bank Ltd., Shantivan, Borivali (E), Mumbai-400066 Warehouses: Silvassa, Bhiwandi, Vapi, Nagpur, Indore, Haridwar, Guwahati Contact: 9223250911 / 7218742627 / 7715947888 / 9323150911 Email Id: marutipetrochem@gmail.com, info@mlunias.com ISO 9001:2015 cer琀fied
56 THE MAZADA PHARMA GUIDE

THE MAZADA PHARMA GUIDE 57


58 THE MAZADA PHARMA GUIDE










THE MAZADA PHARMA GUIDE 59





Scientist
Lab Manager and Technicians
Quality Control Manager
Quality Assurance Manager
Research and Developments
Manager
Chemist & Bio-chemist
Microbiologist and Pathologist
Lab Directors
Analyst
Dealers and Distributors
Purchase and Supply Chain




60 THE MAZADA PHARMA GUIDE GET IN TOUCH VISIT US: www.asialabex.com Ms. Poonam Pal WHO CAN VISIT US JULY 2024 HELIPAD EXHIBITION CENTRE, GANDHINAGAR, GUJARAT, INDIA 14TH EDITION INTERNATIONAL EXHIBITION & SEMINAR ON LABORATORY TECHNOLOGY, ANALYSIS, BIOTECHNOLOGY, DIAGNOSTICS INSTRUMENTS, CHEMICAL & CONSUMABLES
poonam@fenzaexhibitions.com GET IN TOUCH +91-9971109776 VISIT US: www.asialabex.com CONCURRENT SHOW Engage, Enlighten, and Empower 250+ Exhibitors 2000+ Brands 5000+ Products 8000+ Visitors PANEL DISCISSION A dynamic and engaging way to explore complex topics, foster debate, and share knowledge among experts and audiences alike. For Delegate Registration For Visitor E-Badge Registration


SADHANAENTERPRISES
DealersAndImportersInPharmaceuticalsRawMaterial, Chemicals&Solvents
AceclofenacIp
AlbendazoleIp
AmbroxolHclIp
AmisulprideIp
BenfothiamineIh
BenzocaineIp
Betahis nDiHclIp
BromohexineHclIp
BupropionHclIp
ChlorphenramineMaleateIp
ChlororomazineIp
ChromiumPicolinateUsp
Dapoxi nHclIp
DextromethorphenHbrIp
DiacereneIp
DiclofenacDiethylamineIp
DycylomineHclIp
DiethylcarbamazineCitrateIp
Dil azemHclIp
DivalporexSodiumIp
DomperidonBp
Dutestride
E zolamJp
FluconazoleIp/Usp
Flu casoneDiPropionateIp
FolicAcidIp
FurazolidoneIp
GliclazideIp
GlimiprideIp
HyosinButylBromideIp
IrbesertanUsp
Ima nibMesylate
Ivermec nIp
LevosalbutamolSulphateIp
LevosulprideIhs
LornoxicamIh
MethylcobalaminIp
Meman neHcl
MetronidazoleIp
MetronidazoleBenzoateIp
MinoxidilIp
MitrazipineIp
MupirosinUsp
MupirosinIp
NaproxenUsp
NiacinamideIp/Bp
OndensetronHclIp
PantaprazoleSodiumIp
PhenylephrineHclIp
PregabalinIp
ProcyclidineHclIp
SilverSulphadiazineUsp
SulphacetamideSodiumIp
SodiumValporateIp
TadalafilIp
TamsulosinHclIp
TrihexyphenidylHclIp
UrsodeoxicholicAcidIp
ValporicAcidIp
VitaminAAcetateIp
VogliboseIp
Add:J-47/602,PoonamSagarComplex,NearAllahabadBank,Miraroad(E),Thane-401107,Maharashtra(India) Tel.:022-28100190/28100191 | Email:sadhanaenterprises77@gmail.com
THE MAZADA PHARMA GUIDE 61
SANDEEPMEHTA:+919322334989/+919322403205
ProductList











62 THE MAZADA PHARMA GUIDE HARIDWAR, UTTARAKHAND BOOK YOUR STALL FEBRUARY 2025 20 21 22 SUPPORTED BY: OPP. VIKAS BHAVAN, SIDCUL GOLD SPONSORS: BADGE PARTNER:ASSOCIATION PARTNER: MEDIA PARTNER: www.amptechindia.com










THE MAZADA PHARMA GUIDE 63











64 THE MAZADA PHARMA GUIDE Pharma machinery & Lab Equipment Expo & Conference Mr. Chirag Solanki +91 99040 44745 chirag@amptechindia.com Get ready for the upcoming India Pharmaceutical and Laboratory Exhibition in Emerging Markets! Book Your Stall 17-19 October, 2024 Vadodara, Gujarat Association Partner: Gold Sponsor: Sponsor: Badges Partner: www.amptechindia.com MEDIA PARTNER



120mm
THE MAZADA PHARMA GUIDE 65 Send Your DD Favouring Mazda Publication Payble In Mumbai (India) On Below Address. You Can Pay Through Our Bank of Baroda A/c. 04150200000909 The Profile of users includes CEO, Director, Marketing Executive, Purchase Managers, R&D Personnel, Dealers, Importers / Exporters, Indentors, Consultants, Educational / Government Institutions, Libraries, Banks / Institutions & Consulates. Magazine Subscription Rate: 1 Years for Rs.600/- (12Issues) & 3 Years for Rs.1500/- (36 Issues) MAZDA PUBLICATIONS Gala No. 1A, Sharma Compound, Old Nagardas Road, Andheri (East), Mumbai 400069, India. Mobile: 9860066753 / 8652813388 / 9773223314 Email: mazdapharmaguide@gmail.com Web: www.chemicalsourcingguide.com Advertise in Our Print Magzine & Get Free Advertisement in our Website: www.chemicalsourcingguide.com SIZE M/C B/W Dimensions Full Page 15,000/-
x 250mm Half Page ----
PREMIUM POSITION
ONLY) FRONT COVER 30,000/- FRONT INSIDE COVER 30,000/BACK COVER 22,500/- BACK INSIDE COVER 22,500/-
7,500/- 183mm
4,500/- 183mm x 120mm 1/3 Page ---- 3,000/- 183mm x 78mm 1/4 Page ---- 2,250/- 90mm x
Visiting Card Size ( Bold Listing ) ---- 1,500/- 90mm x 55mm
(M/C

66 THE MAZADA PHARMA GUIDE

DEALING IN : PHARMACEUTICAL RAW MATERIALS, CHEMICAL, INORGANIC CHEMICAL, INTERMEDIATE
WAREHOUSE : GALA NO. 19 & 20, 1ST FLOOR, GHAR NO. 1055, BHATIYA COMPLEX, PURANA VILLAGE, BHIWANDI 421 302.
Address : SHOP NO.4, GORAI DISHA CHS LTD., L.T. ROAD, GORAI 2, PLOT NO. 50, OPP. SHANTIDHAM ASHRAM, BORIVALI (W), MUMBAI 400 092. • Email : info@hapenterprise.com • 022 28677670 / 71 / 72 • Mob. : 9324265877 / 9324517446
ACTIVE PHARMACEUTICAL INGREDIENTS
v ACECLOFENAC
v v ALLOPURINOL
v v AMITRIPTYLINE
v v AMLODIPINE BESILATE
v v ARIPIPRAZOLE
v v ARTEMETHER
v v ATROVASTATIN CALCIUM
v v BACLOFEN
v v BENFOTIAMINE
v v BENZOCAINE
v v BETAHISTINE DI HCL
v v BROMHEXINE HCL
v v CALCITROL
v v CALCIUM DOBESILATE
v v CARBAMAZEPINE
v v CARVEDILOL
v v CELECOXIB
v v CETIRIZINE DI HCL
v v CHLORPHENIRAMINE MALEATE
v v CHONDROITIN SODIUM
v v CILNIDIPINE
v v CINNARIZINE
v v CITICOLINE SODIUM
v v CLOBETASOL PROPIONATE
v v CLOMIPHENE CITRATE
v v CLOMIPRAMINE HCL
v v CLOPIDOGREL BISULPHATE
v v CLOTRIMAZOLE
v v CLOZAPINE
v v CYCLOBENZAPRINE HCL
v v CYPROHEPTADINE
v v DAPOXETINE HCL
v v D-BIOTIN
v v DEFLAZACORT
v v DESLORATADINE
v v DESVENLAFAXINE SUCCINATE
v v DEXAMETHASONE PLAIN /SODIUM
v v DEXTROMETHORPHAN HYDROBOMIDE
v v DIACEREIN
v v DICLOFENAC DIETHYLAMINE
v v DICLOFENAC POTASSIUM
v v DICLOFENAC SODIUM
v v DICYCLOMINE HCL
v v DOTHIEPIN HCL
v v DOXEPIN HCL
v v DOXYLAMINE SUCCINATE
v v DULOXETINE HCL
v v DUTASTERIDE
v v EBASTIN
v v EPERISONE HCL
v v ESCITALOPRAM OXALATE
v v ETHAMSYLATE
v v ETODOLAC
v v ETORICOXIB
v v FEBANTEL
v v FEBUXOSTAT
v v FENOFIBRATE / MICRONISED
v v FEXOFENADINE
v v FLUCONAZOLE
v v FLUNARIZINE
v v FLUPENTIXOL HCL
v v FOLIC ACID
v v FUROSEMIDE
v v FUSIDIC ACID
v v GABAPENTIN
v v GLICLAZIDE
v v GLIMEPIRIDE
v v HYDROXYZINE HCL
v v IMIPRAMINE HCL
v v INDOMETACIN
v v ISOTRETINOIN
v v ITOPRIDE
v v IVERMECTIN
v v KETOPROFEN
v LABETALOL
v LACOSAMIDE
v LAMOTRIGINE
v LEFLUNOMIDE
v LEVO SALBUTAMOL SULPHATE
v LEVOCETIRIZINE HYDROCHLORIDE
v LEVOSULPRIDE
v LINAGLIPTIN
v LINEZOLID
v LOPERAMIDE
v LORATADINE
v LORNOXICAM
v LOSARTAN POTASSIUM
v LULICONAZOLE
v LUMEFANTRINE
v METOCLOPRAMIDE
v METOPROLOL SUCCINATE/ TARTRATE
v MINOXIDIL
v MIRTAZAPINE
v MONTELUKAST SODIUM
v MOXIFLOXACIN
v MUPIROCIN
v MEBEVERINE HCL
v MEFENAMIC ACID
v MECLIZINE
v MELATONIN
v MELITRACEN HCL
v MELOXICAM
v MESALAMINE
v METADOXINE
v METFORMIN HCL
v METHYLCOBALAMINE
v METHYLPREDNISOLONE
v NIACINAMIDE
v NIFEDIPINE
v NIMESULIDE
v NORTRIPTYLINE HCL
v OLANZAPINE
v OLMESARTAN MEDOXOMIL
v ONDANSETRON
v PANTOPRAZOLE SODIUM
v PAROXETINE HCL
v PHENYLEPHRINE HYDROCHLORIDE
v PIOGLITAZONE HCL
v PIROXICAM
v PREGABALIN
v PROGESTERONE
v PYRANTEL PAMOATE
v QUETIAPINE FUMRATE
v v RACECADOTRIL
v v RIBOFLAVIN SODIUM PHOSPHATE
v v ROSUVASTATIN CALCIUM
v v S - AMLODIPINE
v v SERTACONAZOLE NITRATE
v v SILDENAFIL CITRATE
v v SMX / TMP
v v SODIUM FUSIDATE
v v SULFASALAZINE
v v SULPHADIAZINE
v v TACROLIMUS
v v TADALAFIL
v v TAMSULOSIN HCL
v v TELMISARTAN
v v TENELIGLIPTIN
v v TICAGRELOR
v v TOLPERISONE
v v TOPIRAMATE
v v TORSEMIDE
v v TRANEXAMIC ACID
v v TRIFLUOPERAZINE HCL
v v TRIHEXYPHENIDYL HCL
v v TRIMETAZIDINE
v v VENLAFAXINE HCL
v v VILDAGLIPITIN
v v VITAMIN C PLAIN & COATED
v v VITAMIN E 50%
THE MAZADA PHARMA GUIDE 67
CORE PRODUCTS:
l Hydroquinone (HQ)
l Tert-Butylhydroquinone (TBHQ)
l Propionic Acid
l Butylated Hydroxyanisole (BHA)
l Butylated Hydroxytoluene (BHT)
l Tert-Butylcatechol (TBC)
l Iodine
ACIDS:
l Ace c Acid
l Acrylic Acid
l Adipic Acid
l Benzoic Acid
l N-Butyric Acid
l Citric Acid - Anhydrous (CAA)
l Citric Acid - Monohydrate (CAM)
l 2-Ethylhexanoic Acid (2-EHA) / Octoic Acid
l Formic Acid 85%
l Formic Acid 99%
l Isobutyric Acid
l Lac c Acid 80%
l Lac c Acid 88%
l Oxalic Acid
l Phosphoric Acid 85% - Food Grade
l Phosphoric Acid 85% - Technical Grade
l Sulphamic Acid
l Sorbic Acid
SOLVENTS:
l Acetone
l n-Butanol
l Tert-Butanol (TBA)
l Chloroform
l Cyclohexane
l Cyclohexanone
l Dimethyl Formamide (DMF)
l Dimethyl Sulfoxide (DMSO)
l Ethyl Acetate
l 2-Ethylhexanol (2-EH) / Octanol
l Isopropyl Alcohol (IPA)
CHEMSTAR
l Methylene Chloride (MDC)
l Propylene Glycol (PG) - Technical Grade
l Tetrahydrofuran (THF)
l Toluene
l mixed-Xylene
l Ortho-Xylene
SPECIALTY CHEMICALS:
l Acetophenone
l Ac vated Carbon
l Amprolium
l Anisole
l Ascorbyl Palmitate (AP)
l Benzotriazole
l Butylated Octylated Diphenylamine (BODPA)
l Tert-Butylchloride (TBC)
l Calcium Propionate (CP) - Feed Grade
l Calcium Propionate (CP) - Food Grade
l Catechol
l Chloranil
l Chloro Acetyl Chloride (CAC)
l Dicyandiamide (DCDA)
l Diortho Tolylguanidine (DOTG)
l Di tert-Butylhydroquinone (Di-TBHQ)
l Etamsylate
l Ethyl Vanillin
l Glycerine
l Glycerol Monostearate (GMS)Non-Self Emulsifying (NSE) Grade
l Glycerol Monostearate (GMS)Self Emulsifying (SE) Grade
l Glycerol Monooleate (GMO)
l Isopropyl Myristate (IPM)
l Isopropyl Palmitate (IPP)
l Maleic Anhydride
l Methylene Diphenyl Diisocyanate (MDI)
l Mono Methyl Ether of Hydroquinone (MEHQ)
l Paraformaldehyde 91%
l Paraformaldehyde 96%
l Polyols
l Polypropylene Glycol (PPG)
l Polysorbate 80 (Tween 80)
l Sodium Formate
l Sodium Propionate - Food Grade
l Sodium Selenite
l Stearic Acid
l Toluene Diisocyanate (TDI)
l Tolyltriazole
l Vanillin
l Xanthan Gum
METALLIC SALTS:
l Cobalt Sulphate
l Copper Sulphate
l Ferrous Sulphate
l Manganese Sulphate
l Potassium Iodate
l Potassium Iodide
l Zinc Oxide
l Zinc Sulphate
AROMA CHEMICALS:
l Benzyl Isoeugenol
l Caryophyllene
l Caryophyllene Acetate
l Clove Oil (Bud)
l Clove Oil (Leaf)
l Dihydro Eugenol
l Dimethyl Hydroquinone (DMHQ)
l Eucalyptol
l Eucalyptus Oil
l Eugenol
l Eugenyl Acetate
l Green Patchouli Absolute
l Isoeugenol
l Isoeugenyl Acetate
l Methyl Eugenol
l Methyl Isoeugenol
l Patchoulol
l Tabac Dodecane
And many more products....
68 THE MAZADA PHARMA GUIDE PRODUCT LIST: 601 Nestor Court, 6th Floor, Baji Prabhu Deshpande Marg, O S.V. Road, Kamala Nagar, Vile Parle (West), Mumbai - 400056, Maharashtra, India. | Landmark: Next to Vinayak CHS Telephone: +91 22 26100790 | Email: apurva@chemstarglobal.co.in Apurva Jhaveri: +91-9920366780
Contact Details:
LLP
GLOBAL PRODUCTS

THE MAZADA PHARMA GUIDE 69

70 THE MAZADA PHARMA GUIDE




THE MAZADA PHARMA GUIDE 71





Bulk Drugs, Intermediates, Excipients & Formula ons
Email: info@pgshah.com
Tel: +91-22-28990032; +91-22-28980312
Web: www.pgshah.com
APIs :
l Azathioprine
l l Ci coline
l Dil azem HCl
l Esomeprazole Magnesium Trihydrate
l l Fexofenadine HCl
l l Fluconazole
l l Itraconazole
l Levocetrizine Di HCl
l l Tadalafil
l l Iron Sucrose
l l Levosalbutamol Sulphate
l Levothyroxine Sodium
l Efinaconazole
l Mycophenolate Mofe l/Sodium
ll Tigecycline
Vetrinary APIs :
l l Albendazole
l l Butaphosphan
l l Clorsulon
l l Diminazene Di Aceturate
Excipients :
l l Cellulose Acetate Phthalate(CAP)
l l Hypromellose Phathalte(HPMCP)
l l Calcium Carbonate
ll Dapagliflozin
l Pantoprazole Sodium
l Rabeprazole Sodium
l Riboflavin Phosphate Sodium
l Enoxaparin
l Vardenafil
l l Sildodosin
l l Bilas ne
l Tirofiban
l Terbutaline Sulphate
l Tramadol HCl
l Valsartan
l Salbutamol Sulphate
l Sumatriptan Succinate
l Heparin Sodium
l Fenbendazole
l Triclabendazole
l Flunixin Meglumine
l Oxfendazole
l Talcum
l Dibasic Calcium Phosphate




72 THE MAZADA PHARMA GUIDE
P. G. Shah
& Co.

THE MAZADA PHARMA GUIDE 73
YEVE CHEMICALS INDUSTRIES
SPECIALIZED CHEMICALS AND RAW MATERIAL TRADERS
MANJEERA TRINITY CORPORATE, Plot No. S2, Survey No. 1050, Unit No. 810 & 811, Kukatpally, JNTU Road, Ranga Reddy District, Hyderabad, Telangana, 500072.
Contact Person: Mrs.Akanksha Golwala (Managing Partner), Mr.Pra k Golwala (Proprietor) PHONE: 9924125003, 9075530925 l EMAIL: yevechemicals@gmail.com, pra k.golwala@ymail.com
CORE PRODUCTS:
l 1, 4 –Dioxane
l 1, 2 Dichloro Ethane (EDC)
l 1, 2-Dimethoxy Ethane (Monoglyme)
l 1, 3-dichloro acetone
l 2, 2-dimethoxy propane
l 2-Chloro Thiophene
l 3-Chloro Propionyl Chloride
l 4-Chloro Benzophenon
l 2-Methyl THF
l Acetyl Chloride
l Acetonitrile
l Alpha Picoline
l 2- Bromo Butane
l Benzene Sulfonyl Chloride (BSC)
l Benzophenone
l Benzyl Chloride
l Benzoyl Chloride
l Boron Trifluoride Diethyl Etherate (BF3)
l Chloroacetyl chloride (CAC)
l Chlorosulfonic acid (CSA)
l Diglyme
l Di Iso Propyl Amine (DIPA)
l Di iso propyl ether (DIPE)
l Di Iso Propyl Ethyl Amine (DIPEA)
l Diethyl Ether (DEE)
l Dimethyl Carbonate (DMC)
l Dimethyl Formamide (DMF)
l Dimethyl Malonate
l Dimethyl Sulfoxide (DMSO)
l Ethyl Bromide
l Ethyl Chloro Formate
l Ethyl Format
l Fluorobenzene
l Heptane
l Hydrazine Hydrate HH 80%
l Imidazole
l Iso Propyl Acetate
l L+Tartaric Acid
l Malonic Acid
l Methyl Acrylic Acid
l Methane Sulfonic Acid
l Methane Sulfonyl Chloride
l MIBK (Methyl Iso Butyl Ketone)
l Mono Chloro Benzene (MCB)
l MTBE (Tert Butyl methyl Ether)
l Meta Amino Phenol
l N, N – BIS (2-Chloro Ethyl Amine) HCL
l N-Heptane
l N-Hexane
l N-Propanol (NPA)
l N, N Dimethyl Acetamide (DMAC)
l N, N Dimethyl Aniline
l N-Butanol (NBA)
l N Methyl 2 Pyrrolidine (NMP)
l N Methyl Morpholine
l N-Pentane
l Ortho Nitro Chloro Benzene (ONCB)
l Para Nitro Chloro Benzene (PNCB)
l Paraformaldehyde (96% & 91%)
l Propionoldehyde
l Propionyl Chloride
l Piperdine
l Piperzine Anhydrous
l Pyridine
l Sodium Boro Hydride Powder
l Sodium Metal
l Sulphuryl Chloride
l Tetra Isopropyl Titanate (TIPT)
l Titanium Iso Propoxide
l Titanium Tetra Chloride
l Tetra N Butyl Titanates
l Tert Butanol (TBA)
l Tetra Hydro furan (THF)
l Triethylamine (TEA)
l Triethanolamine (TEA)
l Thionyl Chloride
74 THE MAZADA PHARMA GUIDE
AND
ALL INDUSTRIAL SOLVENTS.

THE MAZADA PHARMA GUIDE 75


l ALBENDAZOLE CP / IP
l AMITRAZ IP
l AMPROLIUM BP VET
l BUTAPHOSPHAN
l CARPROFEN
l CLOPIDOL B VET
l CLOSANTEL BASE
l COLLISTIN SULPHATE
l DIAVERIDINE HCL
l ETHOPABATE BP VET
l ETHOXYQUINE 66.6%
l ENROFLOXACIN BASE
l FENBENDAZOLE BP / VET
l FLUNIXIN MEGLUMIN
l FURAZOLIDONE BP
l IVERMECTIN EP 2000
l LEVAMISOLE HCL BP
l NEOMYCINE SULPHATE
l OXYCLOSANIDE BPV
l OXYTETRACYCLINE BP
l PRAZIQUENTEL USP
l RAFOXANIDE BPV
l STREPTOMYCIN SULPHATE
l SULPHAQUINOXALINE SODIUM
l TOLTRAZURIL

l VITAMIN ALL
MUMBAI, MAHARASHTRA. Mob: 09820141331 / 09322218073
Email: crystalpharma9@gmail.com / hls_crystal10@yahoo.com
Website: www.crystalpharma.co.in
76 THE MAZADA PHARMA GUIDE

THE MAZADA PHARMA GUIDE 77

1,4 - Butanediol
Acetic Acid
Acetophenone
Acrylic Acid
Acrylonitrile
Adipic Acid
Benzoic Acid
Bisphenol A
Butyl Acrylate
Butyl Carbitol
Butyl Carbitol Acetate
Butyl Cellosolve
Butyl Cellosolve Acetate
DEG
Diethanolamine
Dimethyl Formamide
Dimethyl Sulfoxide
Epichlorohydrin
Ethyl Acetate
Ethyl Carbitol
Ethyl Cellosolve
Ethyl Cellosolve Acetate
Hexamine
Isobutanol
Maleic Anhydride
MDI
MEG
Methacrylic Acid
Methoxy Propanol
Methoxy Propyl Acetate
Methyl Carbitol
Methyl Cellosolve
Methyl Methacrylate
Mix Xylene
Monoethanolamine
PEG 200/400/600/6000
PPG 400/1000/2000
Propylene Glycol
PTMEG 1000/2000
TEG
THF
Toluene
Triethanolamine
Vinyl Acetate



78 THE MAZADA PHARMA GUIDE
98200 34250
PRODUCT LIST







THE MAZADA PHARMA GUIDE 79
SINCE 1985

AMINO
l BCAA 2:1:1
l BETA ALANINE
ACID
l CREATINE MONO 200 MESH
l D-ASPARTIC ACID
l GLYCINE
l INOSITOL
l L- GLUTATHIONE REDUCED
l L- THERONINE
l L-ARGININE BASE
l L-ARGININE HCL
l L-CARNITINE BASE
l L-CARNITINE L-TARTARATE
l L-CITRULLINE DL MALATE
l L-CITRULLINE PLAIN
l L-GLUTAMINE
l L-HISTIDINE HCL
l L-LYSINE HCL
l L-PROLINE
l L-TRYPTOPHAN
l L-TYROSINE
l MELATONIN
l N-ACETYL L-CYSTEINE
l SODIUM HYALURONATE
l TAURINE
SWEETENERS
l ACESULFAME K
l ASPARTAME
l ERYTHRITOL
l FRUCTOSE
l NEOTAME
l SODIUM SACCHARINE
l SORBITOL POWDER
l SUCRALOSE
l XYLITOL
FEED PRODUCTS
l BIOTIN 2%
l DL METHIONINE
l L-LYSINE HCL
l VITAMIN AD3
l VITAMIN E 50 % POWDER
Address: Neelkant Business Park, D-506 5th Floor, Vidyavihar West, Behind Bus Depot, Mumbai -400086
Landline : 022 6210 9999
EMail.: nikeoncorp@gmail.com | URL.: www.nikeon.com
VITAMINS
l ALPHA LIPOIC ACID
l CO-ENZYME Q 10
l D BIOTIN
l FOLIC ACID
l VITAMIN A DRY POWDER
l VITAMIN A PALMITATE 1.7
l VITAMIN B1 MONO/ HCL
l VITAMIN B12 (CYANOCOBALAMIN)
l VITAMIN B2 (RIBOFLAVIN)
l VITAMIN B3 (NIACINAMIDE)
l VITAMIN B5 (CALCIUM D PANTOTHENATE)
l VITAMIN B6 (PYRIDOXINE HCL) IP
l VITAMIN C (ASCORBIC ACID)
l VITAMIN D3
l VITAMIN E ACETATE- BASF
EXTRACTS
l GRAPE SEED EXTRACT 95%
l SILYMARIN UV 80%
EXCIPIENTS
l BETA CYCLODEXTRIN
l CAFFEINE ANHYDROUS
l CITRIC ACID MONO /ANHYDROUS
l COLLOIDAL SILICON DIOXIDE (AEROSIL)
l DIMETHYL FORMAMIDE (DMF)
l DIPROPYLENE GLYCOL (DPG)
l EDTA DI SODIUM SALT
l EDTA TETRA SODIUM SALT
l GLYCERIN
l ISOPROPYL ALCOHOL
l LACTIC ACID 88%
l LACTIC ACID POWDER
l LACTOSE 200 MESH
l MAGNESIUM STEARATE
l MANNITOL IP/BP/USP
l METHYLENE DICHLORIDE (MDC)
l PARACETAMOL IP/ BP/USP
l POTASSIUM SORBATE
l PROPYLENE GLYCOL - SK PIC GLOBAL KOREA
l PVP K-30
l PVP K-90
l SODIUM CITRATE
l SODIUM CMC
l SORBIC ACID
l TITANIUM DIOXIDE (TIO2)
l XANTHAN GUM
l XANTHAN GUM TRANSPARENT
AUTHORISED DISTRIBUTOR WACKER CHEMIE, GERMANY & CJ BIO, KOREA
KESHARIYA CORPORATION
v Aerosil (Madhusilica)
v Acetic Acid Glacial
v Acetone
v Ammonium Bi Carbonate (RCF)
v Ammonium Chloride (IP) (China)
v Carbon Tetra Chloride
v Caustic potash Flakes
v Di Ammonium Phosphate (DAP)
v Ethanol Denature.
v Ferric Chloride Anhydrous
v Glycerine(Indonasia)
v Iso Propyl Alcohol. (Taiwan / Deepak)
v Liquid Light Paraffin
v Magnesium Nitrate.
v Methyl Ethyl Ketone (M.E.K)
v Methanol
v Malto Dexstrine (Ambuja)
v Mono Ethanol Amine.(M.E.A)
v Phosphrous Acid (China)
v Pottasium Chloride
v Potassium Sorbate (China)
v Refined Salt(GHCL)
v Sodium Benzoate
v Soda Ash (Dense / Light)
v Sodium Sulphate Anhydrous
v Sodium Starch Glycolate
v Sodium Bi Carbonate
v Sorbitol
v Sulphamic Acid
v Sodium Sulphate Flakes (Yellow)
v Thioure (Imported)
v Urea Techincal Grade
v Yellow Dextrin.
v White dexstrine
202, Bldg A/56, Sector-3, Shanti Nagar, Mira Road (East). Dist-Thane, Pin-401 107. Maharashtra. Mobile:9820430709 / 9222447459
Email:keshariya_cor@yahoo.co.in, infokc9@gmail.com www.keshariyacorporation.com www.keshariyacorporation.co.in










80 THE MAZADA PHARMA GUIDE
MANUFACTURING PRODUCTS
Rivaroxaban
l Glimepiride l Torsemide l Celecoxib l Silodosin
l Febuxostat l Memantine Hydrochloride
l Pirfenidone l Phenylephrine Hydrochloride
l Etoricoxib l Glibenclamide [Glyburide]
l Amlodipine Besilate l Amlodipine maleate
l Amlodipine camsylate
l S- Amlodipine Besylate [Leva Amlodipine Besilate]
MANUFACTURING PRODUCTS INTERMEDIATES
l 5-Chlorothiophene-2-Carboxylic acid for Rivaroxaban
l (S)-2-(oxiran-2-ylmethyl isoindoline-1,3-dione (or) (S)-Glycidylphthalimidefor Rivaroxaban
l 4-(4-Aminophenyl) morpholin-3-one forRivaroxaban l 4 Hydroxy Pyridine 3 Sulfonic Acid for Torsemide
l 4-(3-Methyl Phenyl) Amino-3-Pyridine Sulfonamide forTorsemide
l Amlodipine Base l S-Amlodipine Base [Leva Amlodipine Base]
l Sulphonamide of Glimipride l Sulphonamide of Glibenclamide
l 1-(4-Methylphenyl)-4,4,4-Trifluoro-butane-1,3-Dione of CELECOXIB
l 4-Sulfonamido Phenyl Hydrazine Hydrochloride ofCELECOXIB
l 4-HYDRAZINOBENZOIC ACID-HCL (4-HBA) for Deferasirox
l 2-(2-Hydroxyphenyl)-4H-benzo[e][1,3]oxazin-4-one for Deferasirox
l Ketosulfone of Etoricoxib l Ketosulfone of Etoricoxib l CDT-Salt OR HF Salt of Etoricoxib
Note: Open part of DMF / Technical data package available on request.
PRUDENCE PHARMA CHEM
(GMP & ISO 9001:2015 CERTIFIED COMPANY)
Plot No.7407, G.I.D.C. Estate,Ankleshwar 393 002. Gujarat, India. Ph No.: 0091 2646 222825 | Fax No.: 0091 2646 222824. | Cell No.: 0091 9825205460 / 0091 9624042444 Email: sales@prudencepharma.com; inquiry@prudencepharma.com | Web: www.prudencepharma.com

Mumbai Office: 211-212, Goldcrest Business Park, Opp. Shreyas Cinema, LBS Marg, Ghatkopar (West), Mumbai - 400 086. Tel: + 91-22-4973 0577 / 4973 0677 | Email: kipchemicals@gmail.com / sachin.shah@kip.co.in | Website: www.kip.co.in Contact Person: Sachin Shah - Mob: +91 9892492782
MANUFACTURER AND DISTRIBUTOR OF BELOW PRODUCTS
COSMETIC INDUSTRY
l Acetone Cyanohydrin
l Thiophene
l Bulyraldehyde
l Glyoxylic Acid -50%
l Glutaraldehyde-50%
l Isobulyraldehyde
l Gamma Butyrolactone
l 5 - Bromo Indole / 5 - Cyano Indole
l 2 Pyrrolidone
l 1,5 Pentanediol Liquid
l 5-5 Dimethyl Hydantoin & Derivatives
l 2- Bromo/ 2- Chloro / 2 – Nitro / 2- Acetyl Thiophene
l Meta Bromo Anisole / Meta Chloro Anisole
l 5 - Acetyl Salicylamide
l Di Ethyl Pyro Carbonate
l Anti-Ozone Softener l Ester Quat Fabric Softener
INDUSTRIAL CHEMICALS
l 1,6-Hexanediol l BCDMH- Bromo Chloro Dimethyl Hydantoin Powder
l Vulkanox BKF- Rubber Antioxidant l Methyl Cyclohexane
l Rheovis – HEUR PU Thickener for Paint Industry
l Isododecane
l Allantoin l DMDM Hydantoin
l Thioglycolic Acid 80 / 99% & Derivative
l Acrylate Copolymer – Liquid / Powder (Thickener)
l Benzophenone 3 & 4
l Behentrimonium Chloride 85% pellet form
l Silicon Quaternium-22 Conditioning Agent
l Pearlcare DS-400- Cold process pearlizing Agent
l Carbomers Series – Rheology Modifier
l PEG 150 Distearate
l APG- Alkyl Polyglucoside
l Acid Thickener l PCMX – Para Chloro Meta Xylenol l Ethoxylate Series – Powder/ Liquid

R1/103, 1st Floor, Munishuvarat Complex, Phase 2, Munidhara Warehousing, Rahanal Village, Bhiwandi, Thane - 421302. Maharashtra. Mob: 98209 29367 | Email: vijendra@ompharmachem.com
608 Atlan c Tower, 6th Floor, Bldg No 2, R.B Mehta Road, Ghatkopar East, Mumbai 400 077 Email Id :Arihant.Jayu11@Gmail.Com Landline No: 913 603 3431/3432, 92234 33432
THE MAZADA PHARMA GUIDE 81
PHARMA INDUSTRY TEXTILE INDUSTRY HOME / PERSONAL CARE INDUSTRY
PRODUCTS API & INTERMEDIATES
MANUFACTURING
API
Website: www.ompharmachem.com AVAILABLE IN READY DELIVERY METHYLCOBALAMINE IP IVERMECTIN IP CO-ENZYME Q10 (NUTRACEUTICAL) PREGABALIN IP ALBENDAZOLE IP/USP MICRONISED EDC / MIBK DEG / MEG / MTO / HEXANE / MEK ETHYL ACETATE (SATYAM / SOMAIYA / LAXMI / GNFC) TOLUENE / METHANOL / CYCLOHEXANONE BUTYL ACETATE / BUTANOL THINNER HEXAMINE / DMF / DI ACETONE ALCOHOL / FORMLDEHYDE TETA / DETA / MIBK / TCE / PCE / CTC / ALL GLYCOLS PROPYLENE GLYCOL / ACETONE / GLYCERINE / CYCLOHEXANE IPA
ARIHANT ENTERPRISES Product List










82 THE MAZADA PHARMA GUIDE

PANCHSHEEL ORGANICS LIMITED
Add: 137-138 Hubtown Solaris Prof. N.S.Phadke Marg, Opp.Teli gali, Andheri (East), Mumbai-400069. Ph: 022-68634200 /4214/4213/4212/4219/4218 l Fax No.: 022-22063929
Email: poltd@panchsheelorganics.in l Web: www.panchsheelorganics.com / www.panchsheelorganicsltd.com
l ACAMPROSATE CALCIUM
l AMIODARONE
l ATOMOXETINE
l BACLOFEN
l BISOPROLOL FUMARATE
l CANDESARTAN
l CARBAMAZEPINE
l CARNOCISTEINE
l CHLORDIAZEPOXIDE
l DENATONIUM BENZOATE / SACCHARIDE
l DIL TIAZEM
l DISULFIRAM
l DOBUTAMINE
l DOPAMINE HCL
l DOXYCYCLINE MONOHYDRATE
l DUTASTERIDE
l ESLICARBAZEPINE
l FLUTAMIDE
l GATLFLOXACIN
l GRANISETRON HCL
l HYDROQUINONE
l HYDROXYPROGESTERONE CAPROATE
l HYDROXYZINE HCL
l IMIPRAMINE HCL / PAMOATE
l IRBESARTAN
l LAMOTRIGINE
l LEFLUNOMIDE
l LITHIUM CARBONATE
l LOMEFLOXACIN HCL
l L- THYROXINE SODIUM
l MELATONIN
l MERCAPTOPURINE
l NAPHAZOLINE / NITRATE
l NEOSTIGMINE METHYL SULFATE
l NITROFURANTOIN MONO / ANHYDROUS
l NITROFURAZONE
l OXCARBAZEPINE
l PERINDOPRIL ERBUMINE
l PHENAZONE
l PIRFENIDONE
l PRAMIPEXOLE DI HCL
l PRAZIQUANTEL
l PROPYLTHIOURACIL
l PYRIDOSTIGMINE BROMIDE
l RUTIN
l SODIUM CROMO GLYCATE
l THALIDOMIDE
l TOLFENAMIC ACID
l TORSEMIDE
l TRIAMTERENE
l VERAPAMIL
l VITAMIN K 1
l XYLOMETAZOLINE HCL
l ZINC BACITRACIN
* AVAILABLE AS PER LATEST PHARMACOPEA & CUSTOMER SPECIFICATIONS
HORMONES & STEROIDS
l ADRENALINE BITARTRATE
l CYPROTERONE ACETATE
l DESOGESTREL
l DROSPIERENONE
l ESTRADIOL / VALERATE / PHENYL
l PROPIONATE / BENZOATE
l ETHINYL ESTRADIOL
l BETASTEROL
l CHONDROITIN SULFATE
l FINASTERIDE
l HYDROCORTISONE ACETATE
l L-THYROXINE SODIUM
l LEVONORGESTREL
l NANDROLONE PHENYL PROPIONATE/ DECANOATE
l NORANDRENALINE BITARTRATE
l DOCOSAHEXANOIC ACID (DHA ) VEG POWDER
l EICOSAPENTAENOIC ACID (EPA ) POWDER
l GAMMALINOLENIC ACID (GLA ) POWDER
l GINSENG POWDER / EXTRACT .
l ISOTRETINOIN
l L-ARGININE L ASPARTATE
l NORGENTAMINE
l NORGESTREL
l NORTHISTERONE / ACETATE
l PREDNISOLONE ACETATE / METHYL PREDNISOLONE ACETATE
l TESTOSTERONE ENANTHENTE / DECANOATE/ CYPIONATE / UNDECANOATE / METHYL
l LYSINE MONO ACETATE
l OMEGA 3 FATTY ACID POWDER
l PHYTOMENADIONE PREMIX
l PHYTOSTEROL AND OTHER ESTER
l TRETINOIN / MICROSPHERES
l VITAMIN E 50% ( PHARMA GRADE )
l VITAMIN K2-7 ( MENAQUINONE )
l ZINC MONOMETHIONINE
* THE ABOVE PRODUCT LIST AS PER THE LATEST PHARMACOPEIA
THE MAZADA PHARMA GUIDE 83
(W.H.O GMP Certified
API PRODUCT LIST
NUTRACEUTICALS
HEALTHCARE
Company)
&

Sukhanand Krupa, Phiroz Shah Sta on, Santacruz(


Mehta Road, Near Santacruz Railway W), Mumbai-400 054
Contact:
Kamlesh S. Mehta: 9324283220 / Dakshesh S. Mehta: 9322224602
Kairav K. Mehta: 8082051218 / Smith D. Mehta: 9967805997
Email: inffoo@mehtaassociates.co.in / sales@mehtaassociates.co.in
Web: www.mehtaassociates.co.in
ty
A-202, Shanti Bldg. No.2, Opp. Atul Tower, Mathuradas Extn. Road, Kandivli (W), Mumbai – 400067, INDIA Off: 022 28052244 / 28052255 Email: bpankajco@gmail.com Mob: +91 9082811397


CorpOffice:E-101,ZarnaEnclaveChsl.,NearSaiDhamTemple, WesternExpressHighway,AshaNagar,Kandivali(East)Mumbai–400101 Mob:9324311273/9029752732
Email:suprimc@yahoo.com*Web:www.suprimchemical.com Works:PlotNo.E-76,Tarapur,M.I.D.C.,Boisar-401506,ThaneDist.,Maharashtra
84 THE MAZADA PHARMA GUIDE
DL-MethionineBP L-GlutamicAcidBP L-LYSINEHYDROCHLORIDEU.S.P L-ThreonineUSP “ReadyStock” B.Pankaj & Co. FOLIC ACID IP / BP METHYL FOLATE CALCIUM L CARNITINE L TARTARATE LEVOCARNITINE USP L CARNITINE FUMARAT
CLOTRIM A DIETHYL CARBA M METHYL SA L READY 402,
Since 1985 ZOLE IP/BP CITRA AZINE ATTE IP LICYLAATTE IP/BP STOCK
st t, But Quality is Fir
is Mus
NITRA MICANAZOLE AT T E.I.P. CITRA PIP. AT T E.I.P. /PIP.HEXA.I.P. Quan
KEMS RAW PHA
RMA

Following Raw Material Bulk Drugs Available From Ready Stock:
l Acriflavine
l Ac vated Carbon Powder
l Aluminium Hydroxide Paste
l Aluminium Sterate l Bees Wax
l Belladona Green Verdis Paste
l Bile Salt l Ca ne Citrate
l Calamine Powder l Calcium Carbonate
l Calcium D- Saccharate
l Calcium Hypophosphite
l Cassin Pro n Hydrolystae Powder 60%
l Cassine Pro n Hydrolysate Powder 80%
l Cellulose Acetate Pthalate
l Cerebro Pro n Powder
l Choline Chloride Powder 98%/60%/50%
l Choline Chloride Solu on 65%
l Collodion Flexable Sol.
l Crysobinum Powder
l Crystal Violet Powder Pure
l Dried Aluminium Hydroxide Gel
l Dry Yeast Powder
l Emulsifying Wax (Ionic/Non-Ionic)
l Extract Belladona Dry Powder
l Extract Belladona Green Veredis Paste
l Extract Liver (Paste / Powder)
l Extract Malt (Powder / Paste)
l Extract Stomach (Paste/ Powder)
l Extract Yeast (Paste / Powder)
l Gama Benzoin Hexa Chloride
l Gum Accacia l Gum Guar
l Gum Tragacanth l Iodoform
l Isolated Soya Pro ne Powder 90%
l Lanoline Anhydrous
l Light Kaoline l Magaldrate
l Magnesium Aluminium Silicate
l Magnesium Hydroxide
l Magnesium Sulphate
l Magnesium Trisilicate
l Malt Diastase l Merbromine Powder
l Oil Arachies l Oil Castor Bss
l Oil Linseed Refine l Oil Neem Refine
l Oil
OliPiI/P
l Pap
l Par l Par l Pec
l Pe
l Pro
flavine Hemisulphate l Propyl G
l Pro l Silv
o n Liquid (20% / 30% /60%)
er Sulphadiazine
l Sim
ethicon 100%
l Sim
l Soy
l Soy
l Soy l Soy
l Sug
l Tal
l T Tool
l Vit l Zin
Besides This We Can Also Supply All Kinds Of: EXTRACT HERBS, OLEROSINE, AROMATIC ESSENTIAL OILS, FOOD& PHARMA C L OXIDE, SUB - NITRATE, CITRATE, SUB GALLATE ETC.) /// CHLORIDE& BROMIDE SA LT T ( AMMONIUM.CALCIUM, SODIUM, POT ( ALUMINIUM, BARIUM, CALCIUM, ZINC, MAGNESIUM)
ethicon Emulsion 30%
a Lecthin Powder /Paste a Pro n Hydrolysate Powder 60 ya Pro n Hydrolysate Powder 80% ya Pro n Powder Capsula on Grad gar Pharma Grade l Sulphur Pow cum Powder l T TaannicAcid na ate amin K 3 Feed / Pharma c Acetate Pure
se allate % % de der E , Olive l Papain Ip / Pure ain Usp / Refine /5x/7x a Amino Benzoic Acid a Chloro Meta Cresol ne l Peptone - Gela n / Proteo ptone (Bactro/ Pharma)
L OLOUR./// BISMUTH SA LT T S ( CARBONAT ARA ASSIUM) /// MATELLIC STE ATTE

oducts Our Pr

l Benzyl Alcohol
l Benzyl Chloride
l Benzaldehyde
l Calcium Chloride-Powder
l Caustic Potash Flakes
l Caustic Soda Flakes
l Chloroform
l Hydrogen Peroxide-50%
l Methylene Dichloride
l Phosphoric Acid 85% Min
l Potassium Carbonate Granular/Powder

l Soda Ash

l Ammonium Bicarbonate Powder
l Dimethyl Formamide
l Sodium Nitrate
l Sodium Nitrite
l Trimethylamine

l Cyclohexane
l Cycloheanone

l Sodium Bicarbonate l ISO Propyl Alcohol
Cont
Acetone l Import
l Acetonitrile
l Bisphenol-A
l Chloroform
l Citric Acid
l Cyclohexane
l Cyclohexanone
l Diethylamine
l Dimethyl Formamide (DMF)
l Dimethyl Sulfoxide (DMSO)
l Diethylene Triamine
l Epichlorohydin
l Ethyl Chloro Formate
l Formamide
l FormicAcid
l Glycering
l Gum Rosin
l Hydrogen Peroxide 50%
l Hydroxylamine Sulphate
l L(+) Tartaric Acid
act Details:
r 1101, Bay View Tower,,Sector-11, Opp. D Ph: 022-6464 0085 / 9223434334 / 92
M l
Melamine
l M l M
l M
ethan Sulfonyl Chloride
ethyl Aceto Acetate
ethyl Ethyl Ketone
l l l l l l l l l l l S
Methyl Isobutyl Ketone
Methylene Dichloride
N.Propanol
Per Chloro Ehtylene
Phthalic Anhydro Maleic Anhydride
Propylene Glycol Tech
Purazine Anhydrous
Sodium Nitrite
Sodium Bicardonate
Sodium Metal
Sodium Nitrate
SodiumNitrate
l Sodium Tripoly Phosphate Tertiary Dutanol
l Sodium Gluconate
l Tetra Hydrofuran
l Titanium Dioxide Anatase/Rutile
l Triethylene Tetramine
z, CBD Belapur omino r, , Navi Mumbai-410 209 23433883lEmail: rasayan_India@yahoo.In
THE MAZADA PHARMA GUIDE 85

86 THE MAZADA PHARMA GUIDE

THE MAZADA PHARMA GUIDE 87

Speciality Chemicals
•Ammonium Benzene Sulfonate
•Anisole
•Benzene Sulfonic Acid
•Benzene Sulfonyl Chloride
•2 Benzoyl Benzoic Acid
•4 Chloro Benzophenone
•Diphenyl Sulfide
•Diphenyl Sulfone
•Methane Sulfonic Anhydride
•Methyl Benzene Sulfonate
•Methyl Para Toluene Sulfonate
•Ortho Toluene Sulfonamide
•Ortho Toluene Para Toluene
STRATECHEM (I) PVT. LTD.
Sulfonamide Mixture
•Para Chloro Benzene Sulfonamide
•Para Chloro Benzene Sulfonate (Sodium Salt)
•Para Chloro Benzene Sulfonyl Chloride
•Para Toluene Sulfonyl Chloride
•Phenyl Acetyl Chloride
•Sodium Benzene Sulfonate
•2 (Dimethylamino) Ethylbenzoate
•2 Benzoylbenzoicacid Metyl Ester
•2 Ethylanthraquinone
•4 Phenylbenzophenone
•4 (Dimethylamino) benzoic Acid
•2 Butoxyethyl Ester


•4 (Dimethylamino)
benzoic Acid Ethyl Ester
•2,2 Dimethoxy 1,2 diphenylethanone
•Phenylglyoxylicacid Methyl Ester
•4 Methyl Benzophenone
Thio Compounds
•Isopropyl Thiophenol
•4 Mercapto Phenol
•Para Chloro Thiophenol
•Para Thiocresol
•Thio Phenol


88 THE MAZADA PHARMA GUIDE
92, Venus, Altamount Road, Mumbai 400 026. • Tel.: +91 22 66627509 / + 91 22 66624572
info@stratechem.in • www.stratechem.in
• Email:









THE MAZADA PHARMA GUIDE 89




















90 THE MAZADA PHARMA GUIDE

THE MAZADA PHARMA GUIDE 91 TRICHOLINE
50%
65%
70% Solution
50%
1%
Pure
70% Solution
60% Feed Grade
TARTARIC ACID MAELIC ACID FUMARIC ACID
M/S. ALBA ORGANICS Plot No. N-171, M.I.D.C. Indl. Area. Tarapur, Boisar (W.Rly), Dist. Palghar, Pin: 401 506, Maharashtra, India. Mohan Desai: 9967025907 / 9372441051, Bapurao Kale 9890461096 Email: albasales171@gmail.com
CITRATE
&
&
– IHT CHOLINE DIHYDROGEN CITRATE
Solution – IHT CHOLINE BICARBONATE 50% Solution – IHT CHOLINE BITARTRATE COATED with
Silicon Dioxide – IHT CHOLINE SALICYLATE 50% Solution – IHT CHOLINE CHLORIDE
IHT CHOLINE CHLORIDE
– IHT CHOLINE CHLORIDE
– IHT
PRODUCTS

92


THE MAZADA PHARMA GUIDE 93



PRODUCT LIST
Name of productPharmacopeiaTherapeu c useName of productPharmacopeiaTherapeu c use
API (HUMAN) COMMERCIAL PRODUCTION
CITICOLINE SODIUMIP / USPNOOTROPIC
CITICOLINE BASEUSPNOOTROPIC
BUPROPION HYDROCHLORIDEUSPANTIDEPRESSANT
GRANISETRON HYDROCHLORIDEIP / BP / USPLOCAL ANAESTHETIC
MELOXICAMIP / BP / USP / EPANTI-INFLAMMATORY
PIROXICAMIP / BP / USP / EPANTI-INFLAMMATORY
PRILOCAINEIP / BP / EP / USPLOCAL ANAESTHETIC
PRILOCAINE HYDROCHLORIDEBP / EP / USPLOCAL ANAESTHETIC
LIDOCAINE HYDROCHLORIDE MONOHYDRATE IP / BP / USP / EPLOCAL ANAESTHETIC
LIDOCAINEIP / BP / USP / EP5-HT3 RECEPTOR ANTAGONISTS
ALBENDAZOLEIP / BP / USPANTHELMINTIC
ARTICAINE HYDROCHORIDEIP / BP / EPLOCAL ANAESTHETIC UNDER DEVELOPMENT
NAME OF PRODUCT CAS NO. END USE KETOPROFEN22071-15-4ANTIINFLAMATORY (NSAID) CELECOXIB169590-42-5ANTIINFLAMATORY (NSAID) BENFOTIAMINE22457-89-2VITAMIN B1
GLICLAZIDE21187-98-4HYPOGLYCAEMIC (ANTI-DIABETIC DRUG) BILASTINE202189-78-4ANTIHISTAMINES METHYLCOBALAMIN13422-55-4VITAMIN B12
RIVAROXABAN22457-89-2ANTICOAGULANT
API (VETERINARY) COMMERCIAL PRODUCTION FENBENDAZOLEIP/BP/VET/USP/EPANTHELMINTIC CLOSANTEL SODIUMIP/BP/VETANTHELMINTIC CLOSANTEL BASEIN-HOUSEANTHELMINTIC OXFENDAZOLEBP VET/EPBENZIMIDAZOLE ANTI-HELMINTIC TRICLABENDAZOLEBP VET/EPBENZIMIDAZOLE ANTI-HELMINTIC ALBENDAZOLEIP/BP/USPANTHELMINTIC
INTERMEDIATE - COMMERCIAL PRODUCTION
NAME OF PRODUCT CAS NO. END USE META CHLORO PROPIOPHENONE34841-35-5BUPROPION HCL 2-BROMO-3’CHLOROPROPIOPHENONE34911-51-8BUPROPION HCL
Corporate O ce: 303, Western Edge 1, Western Express Highway Magathane, Borivali (East), Mumbai 400 066 Maharashtra Tel: 22 40160260 /61/62/63/64
Works: Plot No. 411/1 & 412/2, L.I.C. Sector, Silvassa Road G.I.D.C. Vapi 396195 Dist, Valsad, Gujrat, India. Tel: 91 260 2453714/ 91 260 2453567 Mob: +91 8689897373 l Email: enquiry@cheminopharma.com Web: www.cheminopharma.com
94 THE MAZADA PHARMA GUIDE

THE MAZADA PHARMA GUIDE 95

KAMLESH ENTERPRISE
D/003, Vijay Park Iraniwadi, Kandivali west, Mumbai-400067 Rajesh Goradia- Mob: 9820019738/9223433306
Email:kamlesh_enterprise@yahoo.com / Rajeshgoradia@gmail.com
PRODUCT LIST
l Emulsifier 4.5(Alphox 100)
l Emulsifier 9.5(Alphox 200)
l Emulsifier 30(Alphox 500)
l Benzoic Acid 99% Tech Grade
l Butyl Cellosolve
l l Butyl Carbitol
l Castor Oil 40 (Castrox-200)
l Cetomacrogol 1000(Cetodet 500)
l l Ethyl Carbitol (Igtol 12016 E)
l Ethyl Cellosolve(Igsol 12026 E)
l Ethyl Cellosolve Acetate (Igace 6701 E)
l Methyl Cellosolve
l Maleic Anhydride
l Poly Ethylene Glycol (Peg 200)
l Poly Ethylene Glycol (Peg 400)
l Poly Ethylene Glycol (Peg 600)
l Poly Ethylene Glycol (Peg 4000)
l Poly Ethylene Glycol (Peg 6000)
l Poly Ethylene Glycol (Peg 1500)
l Polysorbate 80 (Sorbox -80 / Twin-80)
Ethoxylate
l l Propylene Glycol
l l Toluene (Bulk)
l Methyl Ethyl Ketone (Bulk)
l Butyl Acetate (Bulk)
l Ace c Acid (Bulk)
96 THE MAZADA PHARMA GUIDE
ABIRATERONEACETATE
ADAPALENE
ADENOSYLCOBALAMINE


ETHYNYLESTRADIOLIP/BP
ETIZOLAM
EVEROLIMUS
ADRENALINEBITARTRATEIP
ADRENOCHROMEMONOSEMICARBAZONEIP
ALFACALCIDOL
ALFUZOSIN
ALLYLESTRENOL
ALPHABETAARTEETHERIP
AMOROFLINE
ANASTROZOLE
ARTEETHER
ARTESUNATESTERILE
AZACYTIDINE
BECLOMETHASONEPROPIONATE
BEESWAX
BENIDIPINEHCL
BETAMETHASONEDIAPROPIONATE
BETAMETHASONESODIUMPHOSPHATEIP
BETAMETHASONEVALARATEBP
BIMATOPROST
BUSERELIN
BUTACONAZOLENITRATE
CABERGOLINE
CALCITRIOL
CARBOPROST
CASPOFUNGINACETATE
CETRIXONESODIUMSTERILE
CHOLECALCIFEROL(VITAMIND-3)
CICLOPIROXOLAMINE
CITICOLINSODIUMIP
CLARITHROMYCINIP/USP
CLENBUTEROLHCLBP/USP
CLINDAMYCINPHOSPHATEIP
CLINIDIPINE
CLOBETASONEPROPIONATE
CLOBETASONE-17-BUTYRATE
CO-ENZYMEQ10
COLCHICINE
CYNOCOBALAMIN(VITB-12)
DABIGATRAN
DANAZOL
D-BIOTINE
DEFLAZACORT
DEHYDROEPIANDROSTERONE(MICRONIZED)
DESMOPRESSINACETATE
DESOGESTREL
DEXAMETHASONESODIUMPHOSPHATE
DIAZOXIDE
DICYCLOMINEHCLIP
DILTIAZEM
DINOGEST
DOMPERIDONEBP
DROSPERINPNE
DUTASTERIDE
EBACAVIR
EBASTINBP
EBERCONAZOLE
EFINACNAZOLE
ENTACAVIR
ERLOTINIB
ESTRADIOLVALERATE
ETHISTERONE
FENTICONAZOLENITRATE
FINASTRIDEBP
FLUCLOXACILINMAGNESIUMBP
FLUOCINOLONEACETONIDE
FLUOROMETHALONEACETATE
FLUROMETHOLONE
FLUTICASONEPROPIONATE/FUROATE
FOLLICLESTIMULATINGHORMONE(FSH)
FOSFOMYICINSODIUM
FUSIDICACID
GEFITINIB
GRANISETRONHCL
HARDWAX&ALLWAX
HELOBETASOLBP/USP
HUMANGROWTHHORMONE(HGH)
HYDROCORTISONEACETATE
HYDROXOCOBALAMINACETATE
HYDROXYPROGESTERONECAPROATE
HYDROXYZINEHCLIP/USP
IMATINIB
INDAPAMIDE
IODOCHLOROHYDROXYQUINOLINEIP/BP
ISOCONAZOLENITRATE
ISOFLUPREDONEACETATE
ISOTRETINOIN
ITRACONAZOLEPELLETS44%&22%
IVABRADINE
IVERMECTINEIP
LATANOPROST
LEBETALOLHCLIP
LETROZOLE
LETROZOLE
LEVONORGESTRELIP/BP/USP
LEVOTHYROXINESODIUM
LIOTHYRONINESODIUM(T3)
LOPERAMIDEHCLUSP
LOTEPREDNOLEBONET
LULICONAZOLE
LUMEFANTRINE
MEDROXYPROGESTERONEACETATE
MEROPENAM
METHOTREXATEUSP
METHYALPREDANISOLONE
METHYLCOBALAMIN
METOPROLOLSUCCINATEIP
MICAFUGNINSODIUM
MICROCRYSTALLINEWAX
MIFEPRISTONE
MISOPROSTOLHPMC(1%)
MOMETASONEFUROATE
MUPIROCIN
NALOXONEHYDROCHLORIDE
NANDROLONEDECANOATE(DMFAVIALABLE)
NANDROLONEPHENYLPROPIONATE(DMF AVIALABLE)
NATURALPROGESTERONE(MICRONISE)
NEBIVOLOLHCL
NEPAFENAC
NORADRENALINEBITARTATE
NORETHISTERONEACETATE
NORETHISTERONEENANTHATE
NORETHISTRONEIP/BP
OCTREOTIDEACETATE
ONDANSETRONEHCL
ORLISTAT
OSELTAMIVIRPHOSPHATEIP
OXICONAZOLE
PANTOPRAZOLESODIUMSTERILE
PIMECRLIMUS
PIPRACILLINE+TAZOBACTAMSTERILE
POSACONAZOLE
PREDANISOLONESODIUMPHOSPHATEIP
PREGABALIN
PRILOCAINE
RAMIPRIL
SARTACONAZOLE
SERRATIOPEPTIDISEENTRICCOATED
SILODOSIN
SIROLIMUS
SITAGLIPTINPHOSPHATE
SOD.HYALURONATE(HYALURONICACID)
STANAZOLOL
SUCCINYLCHOLINECHLORIDE
SULBACTAMSODIUMSTERILE
TACROLIMUS
TAMSULOSINHCL
TARAZOCINE
TAZOBACTAMSODIUMSTERILE TERCONAZOLE
TERLIPRESSINACETATE
TESTESTERONEBP(ANDDEREVETIVE)
TESTESTERONECYPIONATE(DMFAVAILABLE) TETRAHYDROCURCUMIN THIOCOLCHICOSIDEIP TIBOLONE TIGECYCLINE TIOCONAZOLE TOBRAMYCINESULPHATE/STERILE TORSEMIDE TRAVOPROST TRENBOLONEACETATE TRETINOIN99% TRIAMCINOLONEACETONIDE(MICRONIZED) ULIPRISTALACETATE
URSODEOXYCHOLICACIDIP(UDCA) VALACYCLOVIR VANCOMYCINEHCLSTERILE VIGABATRIN VITAMINCCOATED/PLAINE VITAMINK1LIQUID(PHYTOMENADIONE) VITAMINK2(MK4)MENATETRENONE VITAMINK2-7(MK7)MENAQUINONE VOGLIBOSE VORICONAZOLE XYLOMETAZOLINE-NASALSPRAY ZINCBAITRACIN ZINCMONOMETHIONINE
THE MAZADA PHARMA GUIDE 97
***SELFIMPORT** ACYCLOVIRIP CLINDAMYCINHCL TRANEXAMICACID *AllAboveProductAsPerLatestPharmacopeia.*WeareofferingThirdPartyManufacturing. **PrintedProductsAreNotOfferedForCountriesWherePatentIsStillValidItIsTheEnquirer'sResponsibilityToCheckPatentSituationBeforeEnquiring HEADOFFICE: CHHANIJAKATNAKA.VADODARA-390002. (M)9377760444 (M)9099960444 BRANCHOFFICE: KANKHAL.HARIDWAR-249408UTTARAKHAND. (M) 7500960444 FACTORY: PLOT-C-228,GIDCESTATE,SAYKHA–DAHEJ-392140(GUJARAT)INDIA.(UNDERCONSTRUCTION) Email: Balajicorporation2012@gmail.com,salesbalajicorporation2012@gmail.com
www.balajicorporation.net

MEMBA CHEM INDUSTRIES PRIVATE LIMITED
19, M.J.Co-op.Hsg.Soc.Ltd., Ground Floor, 187, Princess Street, Mumbai - 400002. Tel.: 022 66312457 / 66313877-79 | Fax: 022-22061955 | Mob.: +91 9223391023
Email ID: info@membachem.com | Website: www.membachem.com
Manufacturer of Petrochemicals, Analy cal Reagents and Fine Chemicals
Industrial Chemicals
All types of Thinner
Ammonia Solution
Carbolic Acid Crystal/Liq.
Deodorized Hydrocarbons
Distilled / DM Water
Iodophor
LABSA
Liquid Soap
Petroleum Ethers
Phenyl Concentrate
Silicon Defoamer
Silicon Emulsion
Sodium Hypochlorite
Sulphonated Castor Oil
Analytical Reagents (Various Grades like LR/AR/HPLC/Customized)
Acetone
Acetonitrile
Benzene
Butyl Acetate
Chloroform
Diethyl Ether
Diisopropyl Ether
Dimethyl Formamide
Dimethyl Sulphoxide
Ethyl Acetate
Ethylene Dichloride
Formaldehyde 37%
Isopropyl Alcohol
Methanol
Methyl Ethyl Ketone
Methyl Isobutyl Ketone
Methylene Dichloride
Petroleum Ethers 40-60/60-80/80-100
N Butanol
N Methyl-2-Pyrrolidone
N Propranol
Ortho Xylene
Sodium Hypochlorite 4-6% / 10-12%
Tetrahydrofuran
Toluene
Trichloroethylene
Xylene & many more Solvents and Chemicals
Available in Small and Bulk Packs
We also undertake Contract Manufacturing and Custom Synthesis for Fine Chemicals and Bulk Chemicals
022-25908061 | Cell : 8655408992
Email : Jiyapharmchem@Gmail.Com
IMPORTER & STOCKIST
l 2 - ACETYL FURAN / COPPER IODIDE
l AMMONIUM THIOCYANATE 98% & 50%
l ANISOLE 99.5% / 4 - BROMO ANISOLE
l CHLORHEXIDINE BASE/GLUCONATE
l HEXAMETHYLENE DIAMINE (HMDA)
l HYDROBROMIC ACID ( HBR 48%)
l MBT/MBTS/ZMBT
l N - BUTANOL/ N - HEXANE
l N-PROPYLAMINE / N-PROPYL MERCAPTAN
l POTASSIUM CHLORIDE (KCL SALT 99%)
l SILICA GEL 60-120 & 100 - 200 MESH
l TRI FLUORO ACETIC ACID - SRF
l TETRA HYDRO FURAN ( THF) - NANYA
l TRI ETHYL / METHYL ORTHOFORMATE
Tel: 07977627972 / 022-22403437
Email: rikhil14@gmail.com & rikhil14@outlook.com
98 THE MAZADA PHARMA GUIDE
Dealing In Speclity Chemicals Dealers Of Surplus Chemicals We Can Buy Spent Sodium Bromide Spent Potassium By Products Bromide Calcium Bromide, Ammonium Bromide Lithimum Bromide Etc Bulk We Can Buy Surplus Chemicals & Recovered Solvents
25,1 St Floor Kapeesh Mall Mulund West 400 080 Tel :
Jiya Pharmachem
Product Offered POOJA ENTERPRISE
HRITIK CHEMICALS PVT. LTD.
Unit No. 1301-1304, 13th Floor, ‘B’ Wing, Dhanashree Heights, Bldg. No. 42, Azad Nagar 2, O . Veera Desai Road, Andheri (West), Mumbai- 400053
Tel: 022-67115900 | Email: pharma@hri kchemical.com; enquiry@hri kchemical.com
AVAILABLE BOTH IN TANKER’S & DRUM
l Acetic acid
l Acetone
l Acrylonitrile
l BAM
l Benzene
l Butyl Acetate
l N-Butanol/ ISOButanol
l Chloroform
l DEG
l DMA 40%
l EDC
l Ethyl Acetate
l Iso-Propyl Alcohol
l MDC
l MEG
l Methanol
l Ammonium persulphate
l Acetic Acid
l Acetophenone
l Acetonitrile
l Acetyl acetone (INT)
l Acetyl Chloride
l Acrylamide
l Acrylic Acid
l Acrylonitrile
l Adipic Acid
l Allyl Alcohol
l Allyl Chloride
l Aluminium Chloride
l Ammonium Acetate
l Amino ethyl ethanol amine
l Diethanol Amine
l Ammonium Persulphate
l Benzene
l Boric Acid
l Borax
l Benzoic Acid
l Benzyl Alcohol
l Benzylamine
l Bisphenol A
l Bromine
l 1 Bromo-5-chloropropane
l N-Bromosuccinimide (INT)
l N- Butanol
l N-Butyric ACID
l Tert-Butanol
l Butyl Acetate
l N-Butyl methacrylate
l Caproic Acid
l Carbon Black
l Carbon disulphide
l 5-Chloro 2 nitroAniline
l Dimethyl Sulphoxide
l 1,4-Dioxane
l Formic Acid
l Glycerine
l Glycine
l MIBK
l Mixed Xylene
l MMA 40%
l N-Propanol
l Ortho Xylene
l Phenol
l Styrene
l Toluene
l VAM
l Gamma Butyrolactone
l Glyoxal- 40 %
l N-Heptane
l Hexamine
l Hexylene Glycol
l Hydrobromic Acid
l Hydrogen peroxide
l Hydro Quinone
l 2-Hydroxyethyl Methacrylate
l Hydroxylamine Hydro Chloride
l Hydroxyl Amine Sulphate
l Imidazole
l Indium Sulphate
l Iodine
l Iso Butanol
l Iso Butyraldehyde
l Iso Butyroyl Chloride
l Iso Butyric Acid
l Iso phorone
l Iso Phoronediamine
l Iso Phthalic Acid
l Isopropyl Acetate
l Isopropyl Ether
l Maleic Anhydride
l Malonic Acid
l Malononitrile
l Mefenamic Acid
l Methactylic Acid
l Methane Sulphonic Acid
l Methanol
l Methyl Acetoacetate
l Methyl Acrylate
INTERMEDIATES & SPECIALITY CHEMICALS
l Anisole
l All Fire Retardant Chemicals
l All Picoline
l 2 Aminopyridine
l All Benzoate
l 4 Bromo Aniline
l Benzoylmetronidazole
l Bromo Chloro Propane
l Corrosionin Inhibitors
l 2 Chloro Acetonitrile
l 4 Cynopyridine
l Diphenyl Acetic acid
l 4 DMAP
l DMA HCL
l Ethyl Acetate HCL
l IPA HCL
l Para Hydroxy Benzaldehyde
l Lithium Aluminium Hydride
l Mem Chloride
l 3 Methyl Xanthine
l Methanolic HCL
ALL FOLLOWING COMPOUNDS
l All Bromine Compounds
l All chlorine Compounds
l All Corrosion Inhibitors
l All Acetophenone
Compound
l All Pyridine Derivatives
l All Water Treatment
Chemicals
l All Oil FieldChemicals
l Methyl Iso Butyl Ketone
l Methyl Methacrylate
l N-Methyl-2-Pyrrolidone
l 2-Methyltetra Hydrofuran
l Morpholine
l Neopentyl Glycol
l Nitromethane
l Oxalic Acid
l Poly Phosphoric Acid
l Para Tertiary Octyl Phenol
l Paraffin Liquid
l Paraformal Dehyde
l Phthalic Anhydride
l Pentaerythritol
l Perchloro Ethylene
l Phenol
l Phenyl Chloroformate
l Zinc Sulphate Monohydrate
l Caustic Soda Flakes
l Chloroacetyl chloride (INT)
l Caustic Potash Flakes
l Chloroform
l Chromic Acid
l Citric Acid
l Citric Acid monohydrate
l M-cresol
l O-cresol
l P-cresol
l Cyano Acetic Acid
l Cyclohexane
l Cyclohexanone
l Cyclohexyl Amine
l Dimethyl amino ethanol
l Diethyl Amine
l Diacetone Alcohol
l Dichloromethane
l Dicyandiamide
l Methyl Magnesium Chloride In THF
l 2 Methyl THF
l N-methyl piperazine
l N-propanol HCL
l 1,2,4- Triazole
l TEA HCL
l Tolyltriazole
l Diethylene Triamine Pentamethylene Phosphonic Acid
l All Polyacrylic Acid (PAA,Dispersant)
l All Mud Cake Cleaners
l All Amines
l All Quinoline Derivatives
l All ISO Phathalic Derivatives
l All Iodine &It’s Salts
l All Piperidones
l Dicyclohexylamine
l Ethyl Acrylate
l N,N-dicyclohexyl Carbodiimide
l N,N-diethylamine
l Diethylene glycol
l Diethylene Trimine
l Diethyl Ether
l Diethyl Malonate
l Diethyl Sulphate
l Methyl Cyano Acetate
l 1,3-Difluoro Benzene
l Diisopropylamine
l N,N-Dimethyl Acetamide
l Dimethyl Amine
l Dimethyl Carbonate
l N,N-dimethyl Formamide
l Dimethyl Malonate
l Phosphoric Acid
l Phosphorous Oxychloride
l Potassium Carbonate
l N-Propanol
l Propionic Acid
l Gluteraldehyde- 50 %
l N- Methyl Piperazine
l Propylene Glycol
l Pyridine
l Quinoline
l Resorcinol
l Sodium Metabisulphite
l Sodium Methoxide
l Sodium Nitrite
l Sodium Sulphate
l Sodium Thiocyanate
l Sorbic Acid
l Soda Bicarbonate
l Stearic Acid
l Styrene
(DTPMPA, DTPMP, DETPMPA)
l Polyamino Polyether Methylene Phosphonic Acid (PAPEMPA)
l Benzalkonium Chloride(BKC50% & BKC80%)
l Drilling Fluid Biocide
l Bactericides –Aldehyde/Amine/Nana
l All Piperazine Compounds
l All Phenol Based Compounds
l All Napthols
l All Eco-Friendly Defoamers
l All High Temperature Deflocculant
l Succinic Acid
l Sodium Persulphate
l DL-Tartaric Acid
l L-Tartaric Acid
l Tetra Butyl Ammonium bromide
l Tetrahydrofuran
l Thioacetic Acid
l Thionly Chloride
l Thiophenol
l Toluene Diisocyanate
l Titanium Dioxide All grede
l p-toluene Sulphonyl Chloride
l O-Toluic Acid
l P-Toluic Acid
l Tolyltriazole
l Tri-N-Butyl Amine
l Trichloroisocyanuric Acid
l Trietanol Amine
l Triethyl Amine Hydrochloride
l Triethyl Orthoformate
l Trimellitic Anhydride
l Trimethyl Amine
l Trimethyl Chlorosilane
l Trimethyl Orthoformate
l Trimethyl ortho acetate
l Triphosgene
l Ortho Chloro benzaldehyde
l Urea
l Vanadium Pentoxide
l m-Xylene
l O-Xylene
l Xylene Mixed
l D-Xylose
l Zinc Chloride
l Zinc Borate
ALL FOLLOWING FORMATES
l Ethyl Formate
l Methyl Formate
l Benzyl Chloro Formate
l Phenyl Chloro Formate
l Sodium Formate
l Ammonium Formate
WE ALSO SUPPLY ALL CHEMICAL & SOLVENT IN DRUMS AND TANKER
THE MAZADA PHARMA GUIDE 99
AVAILABLE BOTH IN DRUMS & BAG PACKING AVAILABLE REGULARLY FOLLOWING CHEMICAL & SOLVENTS



100 THE MAZADA PHARMA GUIDE
THE MAZADA PHARMA GUIDE 101

NOBLE CHEMICAL AGENCY
O ce: 17-8-187, Chowni Nade, Ali Baig, Hyderabad-500 023, Telangana, India.
We require all types of Spent Bromides
Specially , Spent Sodium Bromide
Spent Hydrobromic Acid
Spent Bromides Above 20%
Dis lled / Spent / Crude / Residual Solvent Mixed
Tri Butyl Tin Chloride
Spent Raney Nickel
Contact:
Naziya Sultana: +91 6309361417
Mohammed: +91 9121094090
noblechemicalagency@gmail.com sulphate916@gmail.com brominenoble12@gmail.com

AMITA CHEMICALS
Chemicals, Solvents, Drugs And Intermidiates
PRODUCTS
ACETONITRILE
BENZAYLDEHYDE
BUTYL CELLSOLE/CARBITOL
BENZOIC ACID
DI ETHYL OXYYLATE
DI METHYL FORMAMIDE
DI/TETRA/SODIUM EDTA
GLYCINE
GLYCERINE
L TARTARIC ACID
LITHIUM CARBONATE/HYDROXIDE
ISO BUTRAL DEHYDE
ISO PROPYL ALCOHOL
POTASSUM CARBONATE
POTASSIUM HYDROXIDE CC FLAKES
PROPYLENE GLYCO
SEMI CARBAZIDE HCL
SODIUM CYANATE
PEPPERMINT OIL
VETIVER ESSENTIAL OIL
D/103, Veena Sargam, Mahavir Nagar, Dahanukar Wadi, Kandivali West, Mumbai 400 067
Tel: 09820036922 | Email: neeltradingcompany@gmail.com
A-129,AntophillWarehousingComplex,VidyalankarCollege Road,Wadala(E),Mumbai-400037,India
Tel : +91-22-2416 1111 / 5555 Mob: +91-98332 31417
E mail: prime@primepharmachem.com
Web: www.primepharmachem.com
Acyclovir
AlphaLipoicAcid
AmikacinSulphate
AmoxycillinTrihydrate
AmpicillinSodium
Azithromycin
CaffeineAnhydrous
CalciumDPantothenate
Carisoprodol
CefiximeTrihydrateCompacted
CefoperazoneSodiumSterile
CeftriaxoneSodiumSterile
Chlorzoxazone
CiprofloxacinHCL
DexamethasoneSodium
DiclofenacPotassium
DiclofenacSodium
DoxycyclineHyclate
FolicAcid
GentamycinSulphate
Guaifenesin
Ivermectin
Ketoconazole
LevamisoleHCL
Levofloxacinhemihydrate
Methylcobalamin
MetamizoleSodium
Metronidazole
MetronidazoleBenzoate
Niacin
Niacinamide
NeomycinSulphate
Norfloxacin
Ofloxacin
Ornidazole
OxytetracyclineHcl
Nimesulide
Paracetamol
PantoprazoleSodium
Pregabalin
RabeprazoleSodium
Roxythromycin
StreptomycinSulphate
Sucralfate
SulbactamSodiumsterile
Sulphadiazine
Sulphadimidine
TapentadolHCL
Telmisartan
VitaminB1Hydrocholoride
VitaminB1Mononiotrate
VitaminB12
VitaminB6
VitaminCPlain
VitaminELiquid
Aspartame
Acesulfame K
Crospovidone XL-10
Ethyl Cellulose N20
Ethyl Cellulose N50
HPMC E5
HPMC E15
HPMC K4M
HPMC K100M
PVPK - 30
Sucralose
102 THE MAZADA PHARMA GUIDE
Aceclofenac
Domperidone
Stockists&Importers:APIs,Excipients&Chemicals OURPRODUCTLIST APIsEXCIPIENTS
A ARNISH LAABOR R A ATES S PVTT. L LTTD. .

v Ethamsylate Bp v Ebastine Bp v v Miconazole Nitate
v v Phenytion Sodium Ip v v Lorazepam v v Clonazepam
v v Melitracine v v Di Valporate Sodium 70-30 & 45-55 & Bp & Usp
v Sodium Valporate Ip & Bp v v Valporic Acid Ip & Bp
v v Mefenamic Acid Ip v v Co Enzyme Q1 ( Nutraceticals Grade )
v v Hydrocortisone Sodium Succinate
v v Orlisate Ih v v Pitofenone v v Chlorthalidone
v v Disulfiram v v Flupenazine Deconate v Flupentixol Hcl
v v Procyclodiane Hcl v v Trihexyphenydine Hcl Ip & Bp & Usp
v v Nicorandil v v Chlordiazepoxide
v v Clozapine v v Ferrous Ascorbate Dc Grade
v v Tolperisone v v Mirtrazapine v v Razitriptan
v v Sumatrptan v v Trypsin & Chemotrypsin v Pencreatine
v Rutin (Rutoside Trihydrate ) v v Valthamate Bromide
v v Fenpiverium Bromide v v Orphenidrine Citrate
SODIUM SALT
Address: 202, 2nd Floor, Modi House, Bajaj Cross Road, Kandivali (West), Mumbai-400 067. India Ph: +91-7208475595
Email: sales@arnishlaborates.com Web: www.arnishlaborates.com

v v Methyl Predinisolone Sodium Succinate & Base
v v Etizolam Bp v v Olmesartan v v Miconazole Nitrate Ip
v v Chlorpromazine Hcl Ip & Bp v v Peliperidone
v v Zolmitriptan v v Naratriptan Hcl v v Eletriptan Hydrobromide
v v Anastrazole v v Bromolian


THE MAZADA PHARMA GUIDE 103
NAME OF PRODUCT CAS NO CAPACITY STANDARD/ MT/ANNUM MINIMUM PACK ACID FUCSHIN SODIUM SALT 3244-88-0 2 5 Kgs ACRIDINE ORANGE BASE 494-38-2 3 1 Kgs ACRIFLAVIN HYDROCHLORIDE 8063-24-9 10 25 Kgs ALIZARINE COMPLEXONE 3952-78-1 1 1 Kgs AMMONIUM CERIC NITRATE AR 16774-21-3 50 25 Kgs AURIN (p-ROSALIC ACID) 603-45-2 5 5 Kgs AZUR – A 531-53-3 5 25 Kgs BLUE TETRAZOLIUM (BT) 1871-22-3 5 5 Kgs CALCON 2583-85-4 2 1 Kgs CHROMOTROPIC ACID DI-SODIUM 5808-22-0 5 25 Kgs
D-HYD. o-CRESOLPHTHLALEIN 596-27-0 2 10 Kgs
DICHLOROPHENOL INDOPHENOL 620-45-1 10 5 KGS
MALACHITE GREEN OXALATE 2437-29-8 100 25 kgs METHYLENE BLUE ZINC FREE 7220-79-3 100 25 Kgs METHYL RED FREE ACID 493-52-7 25-30 25 kgs MUREXIDE 3051-09-0 25 25 kgs NINHYDRIN 485-47-2 50 25 kgs THIOFLAVIN – T 2390-54-7 10 5 Kgs THYMOLPHTHALEIN 125-20-2 20 25 kgs
SALT
2:6
Unit No. 203, 2nd Floor, Blue Rose Industrial Area, Near Jaya Petrol Pump, Western Express Highway, Borivali (East), Mumbai-400 066.
READYSTOCK
ALPHA AMYLASE (1:2000) IP
BROMELAIN 2400 GDU
BROMELAIN 1200 GDU
D CHIRO INOSLTOL HCL/DASE
FOLIC ACID IP/BP/USP
FUNGAL ALPHA AMYLASE DIASTASE 1:2000 IP
FUNGAL DIASTASE 1:2000 IP
FUNGAL DIASTASE 1:5000 IP
HYALURONIC ACID
LACTIC ACID BACILLUS 150 BILLION CFU/GM
LACTIC ACID BACILLUS 300 BILLION CFU/GM
LACTIC ACID BACILLUS 6 BILLION
LACTIC ACID BACILLUS 6000 BILLION
LACTULOSE CONCENTRATE USP
LIGNOCAINE BASE USP
PANCERATIN (IP)
PEPSIN (1:3000. IP)
PAPAN IP
PROBIOTIC BLEND 1 TO 200 BILLION CFU
RUTOSIDE TRIHYDRATE
SERRATIOPEPTIDAS E/C
SERRATIOPEPTIDASE PLAIN POWDER
TRYPSIN
TRYPSIN CHYMOTRYPSIN MIX (6:1)
L- GLUTATHION REDUCED
JAKSONPHARMA
4,Gr,Flr,BhatruChhayaNiwas,83A,GokhaleRoad,OppChatwaniBaug,VileParle(east),Mumbai-400057
PiyushJ.kamdar: 9768311111/9322223592, HarshP.Kamdar: 9167646425
Landline: 022-26101753 OffMob: 83569-50980/42623
Email: jakson.pharma@gmail.com,jaksons_1960@yahoo.com




104 THE MAZADA PHARMA GUIDE





Aerosil
Albendazole
Artemether
Bees Wax

Tel: 022-28060590 Email: info@westernpharma.in,sales@westernpharma.in Website: www.westernpharma.in
Aluminum Hydroxide Paste


Add: 504,ParasBusinessCentre,CarterRoadno–1,Borivali(East),Mumbai–400066
ContactPerson:Mr.NimeshShah:+919820004271&+919320004271
Iso Propyl Alcohol
Lactose
Lumefantrine
Magnesium Hydroxide Paste
Maize Starch
Calcium Carbonate PPTD
Di Calcium Phosphate
Diclofenac Sodium
Guar Gum
Hard Paraffin Wax
Methylene Chloride
Microcrystalline Wax
Niacinamide
Sodium Starch Glycolate
Talc Purified

Chlorpheniramine Pellets
Diclofenac Pellets
Diltazem Hcl Pellets
Esomeprazole Pellets
Itraconazole Pellets
Lasoprazole Pellets
Omeprazole Pellets
Pantoprazole Pellets
Piroxicam Pellets
Rabeprazole Pellets
THE MAZADA PHARMA GUIDE 105 ProductsPellets
WehavealltypesofIndividualPellets,BlendedPellets, NutritionalPellets,NeutralPellets&anycombination aspercustomer’srequirement.




f{xà{ gÜtw|Çz
VÉÅÑtÇç
2nd floor, Diamond Building, Lohar Chawl, Pathak Wadi, Marine Lines, Mumbai, 400002 Ph.: 022-40048174 l Email: chromasheth@gmail.com / shethchroma@gmail.com.
Kalpesh Sheth : +91-9820715414, Rajesh Sheth : + 91-9821435228, Samyak Sheth : +91-9820715956
l ADENINE/ ADENINE SULFATE
l ADENOSINE
l ABSCISIS ACID
l 2,2 BIPYRIDE 99% AR
l 2 - THIOBARBITURIC ACID AR/ACS
l 2,4 Di nitro Phenyl Hydrazine (DNPH)
l BISMUTH ALL SALTS
l All BUFFER RANGES
l ALL NICKEL SALTS
l ALL MERCURY SALTS
l ALL LITHIUM SALTS
l ALL COBALT SALTS
l BIOTIN
l CARMINE 60% FOR MICROSOCOPY
l CHOLESTEROL 97%
l GALLIC ACID
l 6-BA
PRODUCTS
l GIBBERELIC ACID (GA 90%)
l CHLORAMINE T
l 1,5 DIPHENYL CARBAZIDE
l D – RAFFINOSE
l D - LACTOSE ANHY / MONO
l D – CELLOBIOSE AR/ACS
l D – MALTOSE ( Japan/China)
l ERICHROME BLACK T
l 1,10 PHENANTHROLINE MONO
l L – ARABINOSE
l LIGTH GREEN SF YELLOWISH
l LANTHANUM OXIDE / NITRATE / CHLORIDE
l HEAMATOXYLIN STAIN CERTIFIED
l HOLMIUM OXIDE 99.9 %
l MOLYBDEIUM
l METAVANADATE (AMMONIUM/SODIUM)
l VANADIUM PENTOXIDE / TRIOXIDE
l IODINE DERIVATIVES
l ORCINOL MONOHYDRATE
l ORCEIN
l POTASSIUM TELLURITE
l POTASSIUM / SODIUM IODIDE
l PYROGALLOL AR/ACS
l THIOACETAMIDE 99%
l SODIUM AZIDE
l SODIUM TETRAPHENYL BORATE AR/ACS
l SODIUM LAURYL SULFATE LR/AR/ACS
l SULPHANILAMIDE
l TANNIC ACID
l TETRAZOLIUM SALTS
l URIC ACID 99%
l ZINC OXIDE / SULPHATE / NITRATE
106 THE MAZADA PHARMA GUIDE
AN ISO CERTIFIED COMPANIES DIRECT IMPORTERS & SUPPLIERS , ALL PRODUCTS ALWAYS READY STOCK FOR SPECIAL PRICES ALWAYS CONTACT US Contact:Mr.BharatSheth +91-9869056097 +91-9821727511 BRONZECHEMENTERPRISE AntophillWarehousingComplex,NearBarkataliNaka,‘A’Wing, GalaNo.332,3rdFloor,Wadala(E),Mumbai-400037,India. Email:bronze.chem@gmail.com, bharat@hwatsichem.com IODINE 99.7%Min. MadeinChile/Japan. HavingfacilityandallLicenses,toHandle Hazardous,Explosive,PoisonChemicals, onthePortofSEZ–Kutch. iddMhhtFDAAd USFDAEIRR ACCREDITTAATTIONS , plot-06, T A-117, Silver Springs 1st Floorr, Taaloja MIDC, Opposite to T Taaloja MIDC office, Navi Mumbai-410208 A 5. IMPURITY PROFILING -MS/MS LC Y 4. DIRECT MASS B ICP-MS 3.ELEMENTTAALIMPURITIESBY -MS/MS LC Y XIC IMPURITIES B 2. GENOTO A AND NDBA) PA PA (NDMA/NDEA/NMBA/NEIPPAA/NDIPA/NMP -MS/MS LC Y 1. NITROSAMINES IMPURITIES B eceived and Maharashtra FDA Approved .nalandalabs.com ebsite: www W technical@nalandalab.com nalanda.labs@gmail.com pravin.shinde@nalandalab.com E-mail ID: Mob: +91-8779248435 / +91-9920186517 / +91-9870819674 aghunath Shinde Pratik R aghunath Shinde Pravin R ersons SERVICES Contact P USFDA EIR R

THE MAZADA PHARMA GUIDE 107


Produ
Hydroxy Progesterone
cts List
Caproate (HPC) - IP / USP
Progesterone (PGS) - IP / BP / EP / USP
Nandrolone Decanoate (ND) - IP / BP / EP / USP
Nandrolone Phenylpropionate (NPP) - IP / BP / USP
Norethisterone / Norethindrone (NET) - IP / BP / EP / US
T Teestosterone (TES) - BP / EP / USP
T Teestosterone Decanoate (TD) - BP / EP
T Teestosterone Phenylpropionate (TPP) – BP
T Teestosterone Propionate (TP) - IP / BP / EP / JP / USP
T Teestosterone Undecanoate (TUD) – IH



CR PHAR R MA A
Proprietor: Chintan Domadia
Mobile:- +91 9324211958, +91 9022445757
Email:- sales.crpharma@gmail.com | Website:- www.crpharma.co.in 511, 5th floor, Zest Business Space, M.G.Road, Ghatkopar (East), Mumbai-400077
HARIKA DRUGS REPRESENTATIVE
• PROCHLORPERAZINE MALEATE IP/BP/USP (PREMIUM SELLER)
• DOXYLAMINE SUCCINATE USP (PREMIUM SELLER)
• GLICLAZIDE IP/BP
• PROMETHAZINE HCL IP/BP/USP (PREMIUM SELLER)
• PROMETHAZINE THEOCLATE IP/BP (PREMIUM SELLER) • DIMENHYDRINATE BP/USP
• MECLIZINE HCL IP/BP • PROCHLORPERAZINE MESYLATE IP
OTHER PRODUCTS:-
• ETORICOXIB IP
• OXYCLOZANIDE BP VET
• LULICONAZOLE IP
• LINEZOLID IP
• VILDAGLIPTIN IP
• METHYLCOBALAMIN IP
• ALBENDAZOLE IP & USP (PLAIN)
• CLOPIDOGREL BISULPHATE IP
• LEVOCETIRIZINE HCL IP
• DOMPERIDONE IP
• AMBROXOL HCL IP
• RIFAXIMIN EP
• MONTELUKAST SODIUM IP
• BRIVARACETAM IHS
• MEFENAMIC ACID IP/BP
• CHLORZOXAZONE USP
• THIOCOLCHICOSIDE IP
• CEPHALEXIN MONOHYDRATE COMP. IP/BP/USP
• DICLOFENAC POTASSIUM BP
• EBERCONAZOLE NITRATE IP
• NIACINAMIDE IP
• ORPHENADRINE CITRATE BP/USP
• UDCA IP
*All Prices are Subject to final confirma on and availability of the stock at the me of order.
108 THE MAZADA PHARMA GUIDE
Jeetendra Kumar +91 63525 16121, +91 78784 2626
0
P

THE MAZADA PHARMA GUIDE 109 Caproic Acid (C-6) Caprylic Acid (C-8) Capric Acid (C-10) Lauric Acid (C-12) Myris c Acid (C-14) Palmi c Acid (C-16) Stearic Acid (C-18) Oleic Acid (C-18.1) Dis lled Coconut Fa y Acid Hydrogenated Palm Stearin Hydrogenated Technical Oil Hydrogenated Soya Oil AVAILABLE For Quality, Regular Supply & Compe ve Prices Contact: Sunil Goenka Siddharth International Green House, 2nd Floor, Green Street, Fort, Mumbai 400 023. Phone: 022-22662136 / 22663119 l Mobile: 9820026621 Email: sales@siddhint.com l Web: www.siddhint.com
REGULAR ADVERTISEMENT TARIFF Rate Per Insertion
Full Page 10,500/- 5,700/- 183mm x 250mm
Half Page 6,000/- 3,000/- 183mm x 120mm
1/3 Page 2,250/- 183mm x 78mm
1/4 Page 3,900/- 1,800/- 90mm x 120mm
1/6 Page ---- 1,125/- 91mm x 78mm
Premium Position (M/C
only)
Page 15,000/- 7,500/- 183mm x 250mm
Page 4,500/- 183mm x 120mm
1/3 Page 3,000/- 183mm x 78mm
1/4 Page ---- 2,250/- 90mm x 120mm
Visiting Card Size ( Bold Listing ) 1,500/- 90mm x 55mm
Premium Position (M/C
110 THE MAZADA PHARMA GUIDE
SIZE M/C B/W Dimensions
SIZE M/C B/W Dimensions
Full
Half
Front Cover 30,000/Front Inside Cover 22,500/Back Cover 30,000/Back Inside Cover 22,500/-
only) Front Cover 30,000/Front Inside Cover 22,500/Back Cover 30,000/Back Inside Cover 22,500/-
(Monthly) (Fortnightly)

THE MAZADA PHARMA GUIDE 111

112 THE MAZADA PHARMA GUIDE

THE MAZADA PHARMA GUIDE 113

114 THE MAZADA PHARMA GUIDE
SPECIAL FEATURE

PUBLISHER
Prakash Anjalekar
DIRECTORCORPORATE BUSINESS (GLOBAL)
Kiran Raheja +91 9821270907
NEWS UPDATE
DoE Workshop 2024: A Testament to the Power of Collaboration, education, and innovation
IRLAB to conduct a Phase I study of the drug candidate IRL757
4th Computer Software Assurance 2024! CSX
The Next Frontier in Drug Safety in India
DIRECTOR - SPECIAL PROJECTS Prashant Pradhan +91 9820858917
CEO Babu Sangle +91 9773223314
SUB EDITOR
Anurag More +91 8805308299
GENERAL MANAGER Zohra Rozani +91 9860066753
MANAGER - ADVERTISING JAGRUTI SHYAM DAS +91 9167827527
SHWETA SHARMA +91 8591440465
CUSTOMER SERVICE EXECUTIVE
Priyanka Phalke +91 8108049982
Kajal Pandey +91 8692923757
Manasvi Patil +91 9137303001
Vandana Bhalerao +91 9082184602
GRAPHIC DESIGNER
Jitendra Nate +91 8779345336
THE MAZADA PHARMA GUIDE 115 CONTENTS DPCO 144 ADVERTISER’S INDEX 159 115 Export Statistics 116 Chennai Chemical Prices 117 Delhi Chemical Prices 118 Mumbai Chemical Prices 119 Mumbai Drugs Prices 120 Hyderabad Drugs Prices PRODUCT WISE INDEX 161 HEAD OFFICE : Gala No.1A, Sharma Compound, Old Nagardas Road, Andheri (E), Mumbai- 400 069. Email : mazdapharmaguide@gmail.com Web : issuu.com/themazdapharmaguide Edited, Published and Printed By Prakash Anjalekar, Gala N. 1A, Sharma Compound, Old Nagardas Road, Andheri (E), Mumbai - 400 069. Maharashtra On Behalf of Owners Mazda Publications Flora & Pharma 116-117 Floreat Medica Pvt. Ltd. 118 FORMULATERS PRODUCT PROFILE
120, 122
bulk drugs 124, 126, 127, 128, 129
Pharma Ingredients Market 130 Nitrosamine
131
In recent years India has emerged as a powerhouse in the production of
Innovations in Indian Active
Advance Workshop 2024 A Comprehensive Post-Show Review
Advance
132 142 142
FORMULATERS PRODUCT PROFILE
Flora & Pharma
601, President House, Opp. C.N Vidhyalaya, Ambawadi, Ahmedabad-380006. • Tel : 26562164
Brand Name Unit Constituents (Per Unit)
Brand Name
Action (500+50)
Amolox DT (125+125)
Amoxid (500 mg)
Balance (50+325)
Calmef (0.5 mg)
Ciplora (500 mg)
Ciplora-TI (500+600)
Cyclol (20+500)
Digo (80 mg)
Digo MN (80+500)
Dinac (50+500)
Dinac MR (325+250+50)
Fcan (150 mg)
Type
Tablet "Paracetamol 500 mgCaffeine 50 mg"
Capsule "Amoxycillin 125 mgCloxacillin 125 mg"
Capsule Amoxycillin 500 mg
Tablet "Paracetamol 325 mgDiclofenac Potassium 50 mg"
Tablet Alprazolam 0.5 mg
Tablet Ciprofloxacin 500 mg
Tablet "Tinidazole 600 mgCiprofloxacin 500 mg"
Tablet "Paracetamol 500 mgDicyclomine (Dicycloverine) 20 mg"
Tablet Gliclazide 80 mg
Tablet "Gliclazide 80 mgMetformin 500 mg"
Tablet "Paracetamol 500 mgDiclofenac Potassium 50 mg"
Tablet "Chlorzoxazone 250 mgParacetamol 325 mgDiclofenac Potassium 50 mg"
Tablet Fluconazole 150 mg
Fcan (50 mg) Tablet Fluconazole 50 mg
Flogin
Capsule "Vit B12 1.0 mcgCalcium 75.0 mgVit A 2500 iuPotassium 0.1 mgPhosphorus 58.0
mgNicotinamide 10 mgMagnesium 3 mgCalcium Pantothenate 5
B2 1.5 mgVit B1 1 mgVit D3 200 iuGingseng Extract 42.5 mgVit E 5.0 iuVit C 50
mgManganese 0.5 mgZinc 10 mgFerrous Fumarate 30 mgFolic Acid (Vit B9) 0.15
mgCopper 0.5 mg"
Flon TI (200+600) Tablet "Ofloxacin 200 mgTinidazole 600 mg"
Florac (600 lacs)
Tablet Lacto Bacillus Sporegens 60 million Spores
Flotum P (2000+250) Injection "Tazobactam 250 mgPiperacillin 2000 mg"
Folate Tablet "Paracetamol 500 mgChlorpheniramine Maleate 2 mgCaffeine 30 mgPhenyl
Propionate 12.5 mg"
Haemron
Capsule "Folic Acid (Vit B9) 1. 5 mgFerrous Fumarate 300 mgVit B12 15 mcgVit C 75 mg"
Hicet DT (10 mg) (Flora) Tablet Cetirizine 10 mg
Ibuflam (400+325+30) Tablet "Caffeine 30 mgParacetamol 325 mgIbuprofen 400 mg"
Lexin (500 mg)
Capsule Cephalexin 500 mg
116 THE MAZADA PHARMA GUIDE
mgVit
mgVit
B6 1
FORMULATERS PRODUCT PROFILE
Flora & Pharma
601, President House, Opp. C.N Vidhyalaya, Ambawadi, Ahmedabad-380006. • Tel : 26562164
Brand Name Unit
Lexin DT (250 mg)
LS (30 mg)
LVC (500 mg)
Nimef (100 mg)
Nimef P (100+350)
Nimef TD (100+2)
Omef (20 mg)
Painflam (200+250+50)
Ron (150 mg)
Sharp (10 mg)
Sharp D (50+10)
Sharp N (100+15)
Sparef (200 mg)
Titan (500 mg)
Ulcep (40 mg)
Utinor (400 mg)
Utinor T (400+600)
Constituents (Per Unit)
Tablet Cephalexin 250 mg
Capsule Lansoprazole 30 mg
Tablet Levofloxacin 500 mg
Tablet Nimesulide 100 mg
Tablet "Paracetamol 350 mgNimesulide 100 mg"
Tablet "Tizanidine 2 mgNimesulide 100 mg"
Tablet Omeprazole 20 mg
Tablet "Ibuprofen 200 mgParacetamol 250 mgDiclofenac Potassium 50 mg"
Tablet Roxithromycin 150 mg
Tablet Serratiopeptidase 10 mg
Tablet "Serratiopeptidase 15 mgNimesulide 100 mg"
Tablet "Serratiopeptidase 15 mgNimesulide 100 mg"
Tablet Sparfloxacin 200 mg
Tablet Ethamsylate 500 mg
Tablet Pantoprazole Sodium Sesquihydrate 40 mg
Tablet Norfloxacin 400 mg
Tablet "Norfloxacin 400 mgTinidazole 600 mg"
SHREE CHEMICALS
Add: 4, Panchkroshi Industrial Estate, Shiv Vallabh Road, Sambhaji Nagar, Ashokvan, Near Datta Mandir, Dahisar (E), Mumbai - 400 068 Tele : 022-23817000 l Mob : 9969552555/9821280797 l Email: shreechemicals11@gmail.com
PRODUCT LIST :
v MAIZE STARCH IP/BP
v MAIZE STARCH BEST QUALITY (FOOD GRADE)
v MAIZE STARCH POWDER
v LIQUID GLUCOSE
v DEXTROSE ANHYDROUS IP
v DEXTROSE MONOHYDRATE POWDER
v GLUCOSE ANHYDROUS BP
v DEXTROSE MONOHYDRATE IP
v SORBITOL SOLUTION 70% IP
v MALTODEXTRIN POWDER
v PREGELATINIZED STARCH (PHARMA GRADE)
v MODIFIED STARCH (FOOD GRADE)
v WHITE DEXTRIN 151
v CARAMEL LIQUID
THE MAZADA PHARMA GUIDE 117
FORMULATERS PRODUCT PROFILE
Floreat Medica Pvt. Ltd.
No. 33/2805B, Malikayil, Vakkattu Road, Chakkaraparambu, Thammanam PO Cochin 682032
Tel : 2806966 • Fax : 0484-2803966
Brand Name Unit Constituents (Per
Alarrest Tablet Fexofenadine 120 mg
Alernorm Drop Olopatadine 0.1%
Calorate (740 mg)
Clevina (100 ML)
DE Spas
Dehale (0.65 %)
Dehale (0.9 %)
Tablet Olopatadine 0.1%
Lotion Lactic acid 1.2% w/v
Tablet "Dicyclomine (Dicycloverine) 20 mgParacetamol 325 mg"
Spray Calcium Orotate 740 mg
Spray Sodium Chloride 0.9 %
Dehale OM Drop Oxymetazoline 0.05 %
Dilomox CV (30 ml)
Doxoll (200 MG)
Syrup "Clavulanic Acid 28.5 mgAmoxicillin Trihydrate 200 mg"
Tablet Doxofylline 200 mg
Doxoll ML (400+10) Tablet "Montelukast 10 mgDoxofylline 400 mg"
Doxoll Plus (200+30)
Tablet "Doxofylline 200 mgAmbroxol Hydrochloride 30 mg"
Doxoll Plus (400+30) Tablet "Doxofylline 400 mgAmbroxol Hydrochloride 30 mg"
Doxoll TL (400+5)
Eminorm MD
Tablet "Doxycycline 400 mgTerbutaline Sulphate 5 mg"
Tablet Prochlorperazine 5 mg

118 THE MAZADA PHARMA GUIDE Address: 2/22, Babu Genu Road, 2nd Floor, O : Princess Street, Mumbai 400002 (India). Tel: 2201 9558. 2208 2806, 2208 2813, 2209 8845 Email: sales@earthchemical.in / admin@earthchemical.in Web: www.earthchemical.in C C hemical & Sc c i i e e nti i fi i c c Pvt t . Lttd. . 48 YEARS | SERVICE TO THE SCIENCE THERMO FISHER MERCK MILLIPORE S.D.FINE SISCO RESEARCH LABS PVT LTD MOLYCHEM AVRA SYNTRIERS SIGMA ALDRICH ALFA AESAR TCI LOBA FINAR / ACETO HONEYWELL OTTO BLD PHARMA
Unit)
ATTENTION ACTUAL USERS / TRADERS
We request you to send your inquiries by E-mail / Phone
Available regularly at Competitive prices from Authorized Distributors / Stock list FOR MORE DETAILS LOG ON TO www.ketanchemicals.com
SODIUM BENZOATE 99% - (BP/IP/USP) | BENZOIC ACID – (BP/IP/USP/Tech)
BENZYL BENZOATE – (BP/IP/USP/Tech)
Authorized distributors: M/s. MISA Finechem Pvt Ltd / Navyug Pharmachem Pvt Ltd
ZINC OXIDE (White seal 99.5% / Metal Grade 99.8% & 95% Feed Grade & Acti.Z grade)
Authorized distributors: M/s. Rubamin Ltd.
Available Japan / Lanxess also at Very Very Reasonable Price BUTYLATED HYDROXY TOLUENE (2,6-Ditertiary Butyl Para Cresol/BHT) (Original Intact Bags)
• Benzyl Alcohol Benzyl Chloride
• Benzaldehyde Thionyl Chloride Benzyl Benzoate
• BUTYLATED HYDROXY TOLUENE PARA CHLORO TOLUENE (PCT)
• ORTHO CHLORO TOLUENE (OCT)
Authorized stockiest : M/s. Laxness Group
• Benzyl Alcohol Benzyl Chloride Benzyl Acetate
Authorized stockiest : M/s. Waylon Pharmaceuticals
META PARA CRESOL (Mixed Cresol) – (Imported / Intact) (Sealed Packed Barrels)
ORTHO CRESOL - (Imported / Intact) | PARA CRESOL PURE 99% - (China / Atul) | META CRESOL PURE 99% - (Imported / Intact)
Transformer Oil – IS 335 Liquid Paraffin (Heavy & Light) (All Grades)
Authorized distributors: M/S. Apar Industries Ltd.

CONTACT: KETAN CHEMICAL CORPORATION
24,26, 27, 30, SWASTIK PLAZA, V.L. MEHTA ROAD, NEXT TO KALANIKETAN, J.V.P.D. SCHEME, MUMBAI 400 049 TEL. NO: 6148 4500 ( UPTO 30 LINES) l EMAIL: sales@ketanchemicals.com l WEB: www.ketanchemicals.com
Associate: Kalpana Enterprise & Jimit Chemicals

THE MAZADA PHARMA GUIDE 119
FEATURE
IN RECENT YEARS INDIA HAS EMERGED AS A POWERHOUSE IN THE PRODUCTION OF BULK DRUGS
Dr. Sanjay Agrawal
In the intricate web of healthcare, the pharmaceutical industry stands as a pivotal force, continuously evolving to meet the dynamic needs of global health. At the heart of this industry lie bulk drugs, the active pharmaceutical ingredients (APIs) that form the backbone of countless medications. In recent years, India has emerged as a powerhouse in the production of bulk drugs, driving innovation and reshaping the pharmaceutical landscape worldwide.
The Rise of India in Bulk Drug Production
India's journey in the pharmaceutical sector is nothing short of remarkable. From being heavily reliant on imports to becoming a major exporter of generic drugs, the nation has made significant strides. Central to this transformation is the robust production of bulk drugs. India's favorable regulatory environment, skilled workforce, and costeffective manufacturing processes have propelled its ascent in bulk drug production. The country boasts a vast network of pharmaceutical companies, ranging from small-scale enterprises to large multinational corporations, each contributing to the vibrant ecosystem.
Innovation at the Core
Innovation is the lifeblood of progress, and Indian pharmaceutical companies are embracing it wholeheartedly. Here are some key areas where innovations in bulk drug manufacturing are reshaping the industry:
Green Chemistry Initiatives
Sustainability is no longer a buzzword but a pressing necessity. Indian pharmaceutical companies are increasingly adopting green chemistry principles to minimize environmental impact. By employing eco-friendly synthesis routes and optimizing processes to reduce waste generation, these initiatives are not only

environmentally responsible but also economically viable in the long run.
Advanced Manufacturing Technologies
Technological advancements have revolutionized bulk drug manufacturing. Indian companies are investing in state-of-the-art equipment and automation technologies to enhance efficiency, consistency, and quality in production processes. From continuous manufacturing to process analytical technology (PAT), these innovations are streamlining operations and accelerating timeto-market for critical medications.
Research and Development (R&D) Investments Investments in R&D
are pivotal for driving innovation in the pharmaceutical sector. Indian companies are allocating substantial resources to research novel synthesis
(Continued on page 122)
For Your Requirement of Small (1,5,10 Kgs.) Packing
ALLANTOIN
C.M.C. SODIUM VISCOSITY 25 TO 4500
ETHYL CELLULOSE (ALL GRADES)
HYDROXY PROPYL METHYL CELLULOSE (ALL GRADES)
H.P.M.C. PHTHALATE
HYDROXY PROPYL CELLULOSE (ALL GRADES)
HYDROXY ETHYL CELLULOSE (ALL GRADES)
KOJIC ACID
CROSS POVIDONE CL / XL / XL10 / ULTRA
METHYL CELLULOSE (ALL GRADES)
P.V.P.K-17 / 25 / 30 / 90
TITANIUM DIOXIDE
VEE GUM
XANTHAN GUM
Diamond Building, 2nd Floor, Room No.:19, Lohar Chawl, Pathak Wadi, Mumbai 400 002 l Telefax:022-49636267
Mob: Mr. Ashok: 9820877743, 8104163737
Mr. Bharat: 9819845676
Mr. Yash: 9619497022, 8850374535
Email: toklabrothers@yahoo.com
120 THE MAZADA PHARMA GUIDE
AMERICAN ENTERPRISE
SPECIAL
UNI PHARMA A
(Dealers In Ac ve Pharmaceu cal Raw Material) Products

28, Lohar Chawl, Ground Floor, Mahim (West), Mumbai 400016 Contact: 022 24451832 /24457618/9820051832
E Mail: Unipharma81@Gmail.Com
l Ambroxol Hcl Ip
l Aceclofenac
l Alpha Lipoic Acid
l Ascorbic Acid
l Azithromycin
l Cefixime Trihydrate Compacted
l Ciprofloxacinhcl
l Diclofenac Potassium
l Diclofenac Sodium
l Doxycycline Hydrochloride
l Enrofloxacin
l Fusidic Acid
l Griseofulvin
l Isoxsuprine Hcl
l Levo Salbutomal Sulphate
l Lumifentrine
l Metronidazole
l Norfloxacin
l Ofloxacin
l Paracetamol
l Pvpk 30
l Salbutamol Sulphate
l Sodium Fusidate
l Teneligliptin Hydrobromide Hydrate
l Terbutaline Sulphate
l Ivermectine Ip/ Bp/ Vet
l Ribavirin
We Can Provide Any Item Other Than Above As Per Your Valuable Requirement






THE MAZADA PHARMA GUIDE 121
Helix
SPECIAL FEATURE
(Continued from page 120)
pathways, improve drug delivery systems, and enhance the therapeutic efficacy of bulk drugs. Collaborations with academic institutions and research organizations further bolster innovation, fostering a culture of scientific excellence and discovery.
Biosimilars and Complex Generics
Biosimilars and complex generics represent the next frontier in pharmaceutical innovation. Indian manufacturers are at the forefront of developing highquality, cost-effective alternatives to biologic drugs and complex generic formulations. By leveraging their expertise in biotechnology and chemistry, these companies are expanding access to essential treatments and driving down healthcare costs globally.
Personalized Medicine and Customized APIs
The era of personalized medicine is upon us, and Indian pharmaceutical companies are embracing this paradigm shift by developing customized APIs tailored to individual patient needs. By leveraging advances in genomics, proteomics, and data analytics, these companies are pioneering the development of personalized therapies that offer superior efficacy and safety profiles.
Quality Assurance and Compliance Standards
Ensuring product quality and regulatory compliance is paramount in the pharmaceutical industry. Indian manufacturers are implementing stringent quality assurance protocols and adhering to international

regulatory standards to maintain the highest levels of product quality and safety. Continuous monitoring, validation, and adherence to Good Manufacturing Practices (GMP) are integral to their operations, instilling confidence in the reliability and consistency of Indian bulk drugs.
Specialty Chemicals and Intermediates
In addition to APIs, Indian companies are expanding their portfolio to include specialty chemicals and intermediates used in drug synthesis. By vertically integrating their operations and diversifying their product offerings, these companies are enhancing their competitiveness and value proposition in the global pharmaceutical supply chain.
The production of specialty chemicals and intermediates also enables them to capture additional value and strengthen their position in niche therapeutic areas.
Digital Transformation and Industry 4.0
The digital revolution is reshaping industries worldwide, and the pharmaceutical sector is no exception. Indian companies are embracing digital transformation initiatives and
markets around the world, Indian pharmaceutical companies play a crucial role in improving healthcare affordability and accessibility. Furthermore, their contributions to drug discovery and development have the potential to address unmet medical needs and combat global health challenges.
leveraging Industry 4.0 technologies such as artificial intelligence, machine learning, and IoT to optimize manufacturing processes, improve product quality, and enhance supply chain efficiency. Real-time data analytics and predictive maintenance empower manufacturers to make datadriven decisions and proactively address operational challenges, driving productivity and competitiveness. Global Partnerships and Collaborations
Collaboration is key to driving innovation in the pharmaceutical industry. Indian companies are forging strategic partnerships and collaborations with global pharmaceutical giants, academic institutions, and research organizations to pool resources, share expertise, and accelerate the development of new drugs and therapies. These collaborations foster knowledge exchange, technology transfer, and joint R&D initiatives, catalyzing innovation and driving breakthrough discoveries.
Impact and Future Outlook
The impact of Indian innovations in bulk drug production extends far beyond national borders. By supplying high-quality APIs to
Looking ahead, the future of Indian bulk drug manufacturing appears promising. Continued investments in innovation, coupled with supportive government policies and strategic collaborations, will fuel further growth and propel the country to even greater heights in the pharmaceutical arena. As India continues to cement its position as a global leader in bulk drug production, the ripple effects of its innovations will be felt across the healthcare landscape, driving progress and transforming lives.
Conclusion
Innovations in Indian bulk drugs are fueling a transformative shift in the pharmaceutical industry, driving progress, and shaping the future of healthcare. From green chemistry initiatives to personalized medicine, Indian companies are at the forefront of innovation, leveraging technology, expertise, and collaboration to address global health challenges and improve patient outcomes. As they continue to push the boundaries of science and technology, the impact of their innovations will be felt far and wide, ushering in a new era of healthcare excellence and accessibility.
(The author is freelance pharmaceutical consultant)
122 THE MAZADA PHARMA GUIDE
EXPORT STATISTICS

Acetazolamide BP Jnpt Toronto 1.50 MT 5121196 51456.37 Ambroxol Hcl EP Hyderabad Callao 1.00 MT 4170797 62624.62 Amoxycillin Trihydrate BP Vizag Istanbul 3.00 MT 5373947 26896.7 Amoxycillin Trihydrate BP Vizag Apapa 2.00 MT 2642762 19840.54 Atenolol EP Jnpt Barcelona 2.00 MT 3715600 28000 Halquinol BP Bangalore Santos 12.00 MT 14331600 17932.43 Benzethonium Chloride USP Ahmedabad Singapore 2.50 MT 6230784 37422.07 D-Glucosamine Sulphate USP Jnpt Buenos 3.00 MT 3114216 15586.64 Dextrome Thorphan Hydrobromide USP Jnpt Jakarta 1.50 MT 7502829 75386.44 Dextrome Thorphan Hydrobromide USP Jnpt Philadelphia 3.00 MT 30830672 154889.07 Caffeine Anhydrous USP Jnpt New York 6.00 MT 8578080 21466.67 Calcium Glucoheptonate EP Chennai Ho Chi Minh 5.00 MT 330568 10039.34 Carisoprodol USP Hyderabad Santos 8.38 MT 16864830 24159.01 Cefadroxil Monohydrate USP Chennai Guatemala 1.00 MT 3829500 57500 Celecoxib USP Jnpt Alger 1.53 MT 3880183 37817.57 Cephalexin USP Jnpt Ho Chi Minh 1.00 MT 2627896 39457.96 Cephalexin BP Jnpt Ho Chi Minh 4.53 MT 11924010 39471.47 Chlorphenesin BP Jnpt Korea 4.00 MT 2519973 9459.31 Chlorphenesin BP Jnpt Felixstowe 5.40 MT 5604590 15583.93 Chlorphniramine Maleate BP Jnpt Shanghai 3.00 MT 2845249 14240.54 Cinnarizine EP Hyderabad Manzanillo 1.50 MT 3472328 34758.11 Ciprofloxacin HCL BP Jnpt Kuwait 2.00 MT 3164563 23757.96 Ciprofloxacin HCL EP Raxaul Birgunj 4.50 MT 5971500 20000 Ciprofloxacin HCL USP Jnpt Santos 1.20 MT 2504160 31333.33 Ciprofloxacin HCL USP Jnpt Santos 7.60 MT 14920583 26732.58 Citric Acid Anhydrous USP Ahmedabad New York 43.55 MT 2972568 1024.92 Cloxacillin Sodium BP Jnpt Mombasa 2.00 MT 18571410 21450 Dextromethorphan USP Chennai Felixstowe 0.25 MT 2909999 174774.77 Dextromethorphan USP Chennai New York 2.00 MT 23883971 179309.16 Dextromethorphan USP Chennai Toronto 0.50 MT 5469805 164258.41 Dicloxacillin Sodium USP Jnpt Callao 2.50 MT 4945265 29701.35 Divalproex Sodium Usp Jnpt Karachi 2.00 MT 5789199 43462.46 Divalproex Sodium Usp Chennai Barcelona 2.00 MT 5789199 43462.46 Allopurinol EP Jnpt Port Elizabe 6.00 MT 1278370 31991.59 Pyrantel Pamoate USP Jnpt Sydney 1.15 MT 2607890 34050 Efavirenz USP Jnpt Durban 15.00 MT 124072020 124196.25 Erythromycin Ethyl Succinate BP Jnpt Mombasa 1.13 MT 4195800 56000 Erythromycin Stearate BP Jnpt Mombasa 1.96 MT 4177152 32000 Erythromycin Stearate BP Jnpt Mombasa 1.25 MT 2580750 31000 Ethambutol Hydrochloride BP Jnpt Tanjung 4.00 MT 10743460 40328.23 Ethambutol Hydrochloride EP Jnpt Singapore 1.20 MT 3113537 38958.11 Ferrous Fumarate USP Jnpt Los Angeles 20.00 MT 2919400 2200 Ferrous Fumarate USP Jnpt Rotterdam 23.00 MT 3292438 2149.4 Ferrous Fumarate USP Jnpt Veracruz 23.00 MT 3681315 2401.2 Fluconazole USP Hyderabad Callao 0.45 MT 2989068 99735.29 Furosemide BP Jnpt Paranagua 1.60 MT 3436560 32250 Furosemide EP Hyderabad Gdynia 3.00 MT 6798682 33878.68 Furosemide EP Jnpt Manzanillo 13.04 MT 2993953 3448.8 THE MAZADA PHARMA GUIDE 123
PRODUCTS PORT SOURCE QTY.UNIT VALUE IN RS $/UNIT
PARACETAMOL IP / BP/ EP / USP FOLIC ACID IP / BP / EP / USP DOMPERIDONE MALEATE IP / BP ENELAPRIL MALEATE IP / BP GLIPIZIDE IP / BP FUROSIMIDE IP / BP. 205, Srish Plaza, Saki - Vihar Road, Powai, Mumbai 400072 Ph: +22 - 40151518 / 19 l Fax: +22 - 40151520 Email: pharma@sripharmacare.com Website: www.sripharmacare.com SRI PHARMACARE AVAILABLE PRODUCTS
SPECIAL FEATURE
INNOVATIONS IN INDIAN ACTIVE PHARMA INGREDIENTS MARKET
S. N. Jha
The impressive progress of India's API sector has captured the attention of many pharmaceutical industry enthusiasts, who closely follow market trends. The emergence of Indian companies as major contributors on the global stage for essential medicine production is particularly inspiring. These companies' commitment to adopting cutting-edge technologies and sustainable practices is further lauded. By investing in such advancements, not only is business growth driven, but the efficient and responsible manufacturing of medicines is also achieved, ultimately benefiting patients worldwide. The Indian Active Pharma Ingredients (API) market is experiencing a wave of innovation, driven by advancements in technology, regulatory reforms, and the pursuit of cost-effective solutions. As one of the


124 THE MAZADA PHARMA GUIDE SPECIAL FEATURE
the
of both domestic and international
leading players in the global pharmaceutical landscape, India's API industry is constantly evolving to meet
demands
markets.
Please contact : Flora Dyechem Flora Pharmachem Flora Home & Personal Care (International Marketing & Sourcing Agent for all kind of Raw Materials / Ingredients) One of our customer in Japan is looking for the following, Sustainable/Eco-friendly / Biomass/Natural Ingredients for Industrial use/Alternative Ingredients to Petroleum Products. Please offer if you can F - 028, E/2, Highway Park, Thakur Complex, Kandivali (E),, Mumbai - 400 101. INDIA. TEL : 0091 - 22 – 68066624 / 28546507 / 28547508 / 28546509 / 9152234933 E - MAIL : rm@floradye.com/ pc@floradye.com / floradyechem@gmail.com MOBILE : +91 98211 14190 • Website : www.floradye.com (Continued on page 126)
SPECIAL FEATURE
CHEMICALS

THE MAZADA PHARMA GUIDE 125 Name of Chemicals Pack (Kgs.) Price (Kgs.) Name of Chemicals Pack (Kgs.) Price (Kgs.)
Acid Slurry (Soft) 50 105.00 Alum – Ferric 50 15.00 Ammonium Bicarbonate 25 32.00 Ammonium Bifluoride (Sugar grade) 50 118.00 Ammonium Carbonate 50 55.00 Ammonium Chloride 50 18.00 Ammonium Nitrate 50 30.00 Ammonium Phosphate (Mono) 50 80.00 Ammonium Sulphate 50 32.00 Antimony Trioxide 50 775.00 Barium Chloride 50 58.00 Bleaching Powder (33% Cl) 25 25.00 Borax (Granular) 50 42.00 Boric Acid (Tech.) 50 82.00 Calcium Carbonate (Activated) 50 17.00 Calcium Carbonate (Precipitated) 50 17.00 Calcium Chloride 70% (Solid) 50 11.00 Calcium Chloride-Anhydrous 50 22.00 Camphor Oil 200 Litrs 135.00 Caustic Potash (Flakes) 50 74.00 Caustic Soda (Flakes) 50 34.00 Caustic Soda (Prills) 50 60.00 Chromic Acid (Flakes) 50 240.00 Chlorinated Xylenole 25 85.00 Copper Sulphate 50 148.00 Diammonium Phosphate 50 34.00 Dioctylmalite 180 82.00 Ferric Chloride (Anhydrous) 50 36.00 Ferric Chloride (Lumps) 50 32.00 Ferrous Sulphate – Crystals 50 14.00 Hydrochloric Acid Naked 6.00 Hydrogen Peroxide 50% 50 34.00 Hyflosupercell 22.7 66.00 Litharge 50 198.00 Lithopone (China) 25 92.00 Magnesium Carbonate (Indian) 50 55.00 Magnesium Sulphate 50 18.00 Mercury 34.5 6,200.00 Naphthalene Balls 50 110.00 Nickel Chloride 25 380.00 Phosphoric Acid (85% Tech) 50 70.00 Potassium Carbonate (Powder) 25 120.00 Potassium Carbonate (Granules) 25 76.00 Potassium Nitrate 50 72.00 Potassium Permanganate (Tech) 50 160.00 Potassium Permanganate (Pure) 50 200.00 Potassium Phosphate (Di) 50 148.00
50 48.00 Soda Ash Light 50 25.00 Sodium Bicarbonate 50 27.00 Sodium Bichromate 50 130.00
Bisulphite 50 36.00
Chlorite 50% (India) 50 265.00
Chlorite 80% (India) 50 290.00
Cyanide 50 650.00 Sodium Fluoride 50 128.00
Formate (Second sales) 50 42.00
Hexameta Phosphate 68% 50 92.00
Hydrosulphite (China) 50 125.00 Sodium Metabisulphite 50 34.00
Nitrate 50 44.00
Nitrite (China) 50 58.00 Sodium Silicate Naked 14.00
Sulphate (Anhydrous) 50 13.00 Sodium Sulphide 50-52% (Flakes) 50 28.00 Sodium Sulphide 58-60% (Flakes) 50 38.00 Sodium Sulphite 92% 50 48.00 Sodium Tripolyphosphate 50 65.00 Titanium Dioxide Anatase 25 170.00 Titanium Dioxide (Rutile – R-902) 25 285.00 Trisodium Phosphate 50 33.00 Zinc Chloride Powder (Tech.) 50 69.00 Zinc Oxide 50 195.00 Zinc Stearate 25 130.00 Zinc Sulphate (Tech.) 50 52.00 ORGANIC CHEMICALS Acetic Acid (Glacial) 35 57.00 Acetone 160 54.00 Benzene 195 Litrs 52.00 Benzyl Alcohol 200 115.00 Bisphenol-A (Russian) 25 170.00 n-Butanol 170 80.00 n-Butyl Acetate 165 92.00 Butyl Cellosolve 195 85.00 Camphor 25 790.00 Cellosolve (Ethyl) 195 110.00 Chloroform 300 52.00 Citric Acid (Anhy) 25 61.00 Citric Acid (Mono) 25 50.00 Cresote Oil 50 56.00 Cyclohexanone 190 115.00 D D Turpentine 200 Litrs 105.00 Diacetone Alcohol 195 88.00 Diethylene Glycol 230 58.00 Dimethyl Formamide 195 85.00 Dioctyl Phthalate 200 95.00 Di-Pentene 200 Litrs 115.00 EDTA Acid 25 225.00 EDTA Disodium 25 188.00 EDTA Tetrasodium 25 182.00 Ethyl Acetate 185 70.00 Ethylene Dichloride 200 64.00 Ethylene Glycol – Mono 230 58.00 Formaldehyde 65 24.00 Formic Acid 35 55.00 Glycerine – CP 250 50.00 Hexamine – Tech 50 78.00 n-Hexane 160 Litrs 58.00 Hydroquinone (Imported) 25 600.00 Isopropyl Alcohol 160 82.00 Isopropyl Alcohol (Refill) 160 70.00 Maleic Anhydride 25 82.00 Methyl Ethyl Ketone 166 110.00 Methyl Isobutyl Ketone 160 86.00 Methyl Isobutyl Ketone (Refill) 160 80.00 Methylene Dichloride 250 63.00 Methylene Dichloride (Refill) 250 55.00 Mineral Turpentine Oil 50 76.00 Monochloro Phenol 25 87.00 Nitrobenzene 200 85.00 Octanol (2-Ethyl hexanol) 160 100.00 Oleic Acid 50 85.00 Oxalic Acid (Punjab) 50 52.00 Paraffin Wax (White) 50 105.00 Paraformaldehyde 91% 25 66.00 Perchloroethylene 320 53.00 Phenyl Liquid 230 92.00 Phthalic anhydride 25 72.00 Pine Oil 22% 200 Litrs 140.00 Pine Oil 42% 200 Litrs 190.00 Poly Aluminium Chloride 25 36.00 Polyethylene Glycol 400 230 108.00 Polyethylene Glycol 600 230 110.00 Propylene Glycol 215 110.00 Red Lead 50 170.00 Renine 180 62.00 Rosin 17 85.00 Sodium Acetate 50 31.00 Sodium Benzoate 50 120.00 Sorbitol 250 47.00 Stearic Acid (Cosmetic) 50 78.00
INORGANIC
S.L.E.S
Sodium
Sodium
Sodium
Sodium
Sodium
Sodium
Sodium
Sodium
Sodium
Sodium
SPECIAL FEATURE
(Continued from page 124)
The Indian government's initiatives, such as the "Pharma Vision 2020" and "Make in India" campaign, further support the growth of the API industry. These initiatives aim to promote domestic manufacturing, encourage innovation, and enhance the global competitiveness of Indian pharmaceutical companies. India's significant contribution to global vaccine production is worth highlighting - 60 % of global vaccines are produced in India. India is a global leader in the supply of DPT, BCG, and Measles vaccines. We contribute up to 70 % of the WHO demand for Diphtheria, Tetanus, and Pertussis (DPT) and Bacillus Calmette–Guérin (BCG) vaccines and 90% of the WHO demand for the measles vaccine.
Vaccines typically contain one or more APIs, which are the active substances responsible for stimulating the body's immune response to a particular pathogen, such as a virus or bacteria. These APIs in vaccines can be live organisms, inactivated pathogens, recombinant proteins, viral vectors, or other types of antigenic substances. According to a report by the Indian Pharmaceutical Association (IPA), Indian pharmaceutical companies have significantly increased their spending on analytical research and development (R&D) in recent years, reflecting the industry's commitment to quality and innovation. “Powered by innovative drugs, the pharma industry can be worth $200 billion by 2030”, says Biocon chief Kiran Mazumdar-Shaw.
Continuous Manufacturing: Continuous manufacturing involves the uninterrupted flow of materials through various production stages, offering advantages such as improved efficiency, reduced production time, and better control over quality compared to traditional batch processes. Indian API manufacturers are adopting continuous flow reactors and integrated production lines to streamline operations and enhance process efficiency.
(Continued on page 127)
Acid
Beta Cyclo Dextrin
Citric Acid (Anhydrous/Monohydrate)
Filter Aids (Eq to Hyflo Super Cell)
Fumed Silica/Colloidal Silicon Dioxide
Iso Pthalic Acid
Isovaleraldehyde
Lithium Hydroxide Monohydrate
N Butyric Acid / Iso Butyric Acid
Propylene Carbonate
Propylene Glycol USP
Sodium Benzoate Powder
Sodium BoroHydride (Powder/Granular)
Sodium Citrate
Sucralose
Tetrahydrofuran
Thioglycolic Acid 80%
Xanthan Gum (80 Mesh & 200 Mesh)
: 1988)
ADD:101,LabhSarita,opp.ManekNagar,M.G.Rd,Kandivali(W),Mumbai-67.INDIA. TEL.NO.:0091-22-28072677/78/80/28020141
MOBILENO.:0091-9223433781,9821153754
E-MAIL:info@jaychemmarketing.com;sales@jaychemmarketing.com


126 THE MAZADA PHARMA GUIDE
Contact: JAY C HE M MA RKET ING (Estd
Amino
Benzoic
Acids
Regularly available at competative rates:
SPECIAL FEATURE
(Continued from page 126)
For example, companies like Divi's Laboratories and Laurus Labs have invested in continuous manufacturing facilities for APIs like ibuprofen and paracetamol, enabling them to produce high-quality products with minimal waste and resource consumption.
On April 25, 2024, Divi's Laboratories said it is planning to expand its capacity at its manufacturing facility with an estimated investment of up to Rs 700 crore.
In a recent development, Laurus Labs announced the implementation of novel continuous flow synthesis routes for the production of complex APIs and intermediates. By leveraging advanced flow chemistry techniques and in-line monitoring systems, the
company has achieved significant improvements in process efficiency, product quality, and environmental sustainability.
In recent months, several pharma multinational corporations (MNCs) have increasingly turned to Indian companies to expand market reach in the country’s pharmaceutical sector.
- Sanofi's partnerships with Dr Reddy's, Cipla, Emcure, AstraZeneca, and Mankind Pharma — teaming up for asthma medication distribution — are a few instances of this trend.
- Moreover, Sanofi recently signed a partnership with Dr Reddy’s to exclusively distribute and promote Sanofi’s vaccine brands across private markets in India.
- Through this partnership, Dr Reddy's gains access to Sanofi's vaccine portfolio, including brands like Hexaxim and Pentaxim.
Innovations in Indian Active Pharma Ingredients Market
High-Potency APIs (HPAPIs): High-potency APIs (HPAPIs) are compounds with potent pharmacological activity, often used in the production of targeted therapies for conditions like cancer and autoimmune diseases. Indian companies such as Hetero Labs and Suven Life Sciences have invested in specialized facilities for the production of HPAPIs, incorporating stringent containment measures and advanced engineering controls to ensure the safe handling and
manufacturing of these potent compounds. By expanding their HPAPI manufacturing capabilities, Indian companies are catering to the growing demand for targeted therapies worldwide, contributing to advancements in personalized medicine and precision healthcare.
Additionally, companies like Dr. Reddy's Laboratories and Glenmark Pharmaceuticals are leading the way in HPAPI manufacturing in India. Dr. Reddy's Laboratories has set up a dedicated unit for HPAPI production, concentrating on creating groundbreaking therapies for cancer and other serious illnesses. Similarly, Glenmark Pharmaceuticals has expanded its HPAPI
(Continued on page 128)

THE MAZADA PHARMA GUIDE 127
SPECIAL FEATURE
(Continued from page 127)
manufacturing abilities, using advanced synthesis methods and rigorous quality checks. Biocatalysis and Enzymatic Synthesis:Biocatalysis involves using enzymes or microorganisms as catalysts for chemical transformations, offering advantages such as high selectivity, mild reaction conditions, and reduced environmental impact compared to traditional chemical synthesis methods. Indian API manufacturers are leveraging biocatalytic processes for the sustainable and cost-effective production of key intermediates and APIs.
Biocon Biologics has developed advanced enzymatic synthesis techniques to produce specialty chemicals and pharmaceutical intermediates with high efficiency and precision.
Similarly, Syngene International has invested in biocatalysis research and development, enabling the company to offer custom synthesis solutions for complex molecules with superior stereochemical purity.
These innovations not only drive the development of novel drugs and biopharmaceuticals but also position Indian pharmaceutical companies at the forefront of sustainable and efficient API manufacturing. Peptide Synthesis:Peptides are short chains of amino acids with diverse therapeutic applications, including hormone replacement therapy, peptide-based vaccines, and targeted drug delivery systems.
Indian companies like Auro Peptides and GVK BIO

are investing in peptide synthesis technologies to meet the growing demand for peptide-based therapeutics. Advances in automated peptide synthesizers and purification methods enable the rapid and scalable production of peptides with precise sequences and desired functionalities.
Aurobindo Pharma, India's second-largest drug maker by revenue, has set its sights on becoming a $5 billion revenue company within the next 4 to 5 years. To fuel growth, the Hyderabad-based company will be making substantial investments in product development and clinical trials, to build a pipeline of complex and differentiated products encompassing biosimilars, vaccines, peptides, metered dose inhalers, and patches. By expanding their capabilities in peptide synthesis, Indian manufacturers are contributing to the development of innovative treatments for various diseases, including cancer, diabetes, and infectious diseases.

Nanotechnology:Nanotec hnology involves the manipulation of materials at the nanoscale to create new functionalities and applications. Indian API manufacturers are leveraging nanotechnology to develop nanoformulations and drug delivery systems that improve the efficacy and safety of pharmaceutical products.


Challenges:Many APIs face challenges related to poor solubility and bioavailability, which can limit their therapeutic efficacy. Nanotechnology offers solutions to overcome these challenges by formulating APIs into nano-sized particles. This increases the surface area available for drug absorption, leading to improved bioavailability and enhanced pharmacokinetic profiles.
For example, Sun Pharmaceutical Industries and Intas Pharmaceuticals are exploring nanotechnology-based formulations for cancer therapeutics, antimicrobial agents, and gene delivery vectors. Nanoparticles, liposomes, and polymeric micelles are used to encapsulate APIs, enhance their stability, and enable targeted delivery to specific tissues or cells, leading to improved treatment outcomes and reduced side effects. Chiral Chemistry:Chiral chemistry involves the synthesis of enantiomerically pure compounds, which are essential for many pharmaceuticals due to their biological activity and pharmacological effects. Indian companies employ asymmetric synthesis methods and chiral resolution techniques to produce chiral APIs with high stereochemical purity.
Benefit: Enantiomerically pure compounds, synthesized through chiral chemistry techniques, exhibit distinct biological activities and pharmacological effects compared to their racemic counterparts. This specificity allows pharmaceutical researchers to design drugs with enhanced therapeutic efficacy and reduced side effects, ultimately improving patient outcomes. For instance, Dr. Reddy's Laboratories and Dishman Carbogen Amcis specialize (Continued on page 129)
128 THE MAZADA PHARMA GUIDE
SPECIAL FEATURE
(Continued from page 128)
in chiral chemistry services, offering custom synthesis solutions for pharmaceuticals and fine chemicals. These innovations enable the development of safer and more effective drugs, addressing unmet medical needs and improving patient outcomes.
Divi's Laboratories has established itself as a leader in chiral chemistry, with a dedicated focus on asymmetric synthesis and chiral resolution techniques. The company's expertise in chiral API manufacturing enables it to produce enantiomerically pure compounds with high stereochemical purity. Divi's Laboratories collaborates with pharmaceutical companies worldwide to provide custom synthesis solutions for complex chiral molecules, contributing to the development of safer and more effective drugs.
Advanced Analytical Techniques: Accurate characterization and quality control of APIs are critical for ensuring product safety, efficacy, and regulatory compliance. Indian API manufacturers utilize stateof-the-art analytical techniques such as liquid chromatography-mass spectrometry (LC-MS), nuclear magnetic resonance (NMR) spectroscopy, and Xray diffraction (XRD) for comprehensive analysis and characterization of APIs.
Moreover, advanced analytical techniques support various stages of the pharmaceutical lifecycle, from drug discovery and development to manufacturing and quality control. During the research and development phase, these techniques aid in the
identification of lead compounds, optimization of synthetic routes, and assessment of pharmacokinetic properties. In manufacturing, they enable real-time monitoring of production processes, ensuring consistency and reproducibility of API batches. In quality control, they facilitate batch release testing, stability studies, and investigation of product deviations or failures.
Glenmark
Pharmaceuticals and Jubilant Life Sciences have well-equipped analytical laboratories compliant with international regulatory standards, enabling them to perform accurate identification, quantification, and characterization of API molecules and impurities. These advanced analytical capabilities ensure the quality and safety of API products, contributing to the overall success of drug development and manufacturing processes.
Green Chemistry and Sustainable Manufacturing: Green chemistry principles emphasize the design of chemical products and processes that reduce or eliminate the use and generation of hazardous substances, leading to improved environmental sustainability and resource efficiency. Indian API manufacturers are implementing green chemistry principles such as solvent-free reactions, biobased synthesis routes, and catalytic transformations to reduce environmental impact and enhance resource efficiency.
Aurobindo Pharma and Cadila Healthcare have adopted green chemistry
initiatives across their manufacturing facilities, reducing waste generation, energy consumption, and solvent usage. These sustainability efforts align with global environmental goals and regulatory requirements, demonstrating the industry's commitment to responsible and sustainable manufacturing practices. Biocon, one of India's leading biotechnology companies, has incorporated green chemistry practices in its manufacturing processes. The company utilizes biobased synthesis routes for the production of pharmaceutical intermediates and active ingredients. By leveraging biocatalysis and enzymatic synthesis, Biocon minimizes the use of hazardous chemicals and reduces environmental impact while ensuring the efficient production of highquality APIs.
Digitalization and Industry 4.0 Technologies: Digitalization and Industry 4.0 technologies involve the integration of advanced digital solutions such as automation, artificial intelligence (AI), and data analytics into manufacturing processes to improve efficiency, productivity, and quality. Indian API manufacturers are deploying digital solutions to optimize manufacturing operations and enhance process control.
Companies like Cipla leverage real-time monitoring and predictive maintenance systems to improve efficiency and productivity, reducing
downtime and production costs. These digital innovations enable companies to make datadriven decisions, optimize resource allocation, and enhance overall manufacturing performance, contributing to the competitiveness and sustainability of the Indian API industry. Another example - Dr. Reddy's Laboratories are deploying advanced digital solutions such as Internet of Things (IoT) devices and cloudbased manufacturing platforms. These technologies enable realtime monitoring of production processes, predictive maintenance, and data-driven decisionmaking. By embracing smart manufacturing, Indian API manufacturers enhance process transparency, agility, and responsiveness, ultimately driving competitiveness and sustainability in the industry.
As India continues to emerge as a key player in the global pharmaceutical landscape, driven by innovation and strategic collaborations, the future holds immense promise for the Indian API market. With a focus on quality, innovation, and sustainability, Indian companies are expected to make significant contributions to healthcare advancements worldwide, ultimately benefiting patients and society as a whole.
(The author is AVP and Principal Consultant, Fact.MR)
THE MAZADA PHARMA GUIDE 129
NITROSAMINE ADVANCE WORKSHOP 2024 A COMPREHENSIVE POST-SHOW REVIEW
Our bureau, Mumbai
Nitrosamine Advance Workshop 2024, conducted on May 9th and 10th at Radisson Blu Mumbai International Airport, has emerged as a watershed moment in the pharma industry boosting collaboration and innovation in the detection of the Nitrosamine landscape. Our workshop leaders and speakers brought their expertise in presence of over 70 delegates and the event offered an in depth exploration of nitrosamines, covering both updated regulatory guidelines and analytical understanding while also allowing participants to engage in practical discussions, case study-solving sessions, and hands-on learning Opportunities.
Day 1: Exploring Foundational Concepts and Regulatory Framework
The inaugural day of the event commenced with ceremonial lamp-lighting graced by eminent personalities such as Dr. BM Rao CEO QDots Associates, Mr. Igor Gorsky, Principal Consultant, ValSource, Mr. Chetananand Pathak, Senior Director Quality, Emcure Pharma, Dr. Aruna Khanolkar, Director QbD, Cipla, Ms. Guneet Kaur Hayer, Managing Director of Eminence Group.
Ms. Guneet Kaur Hayer, Founder and Managing Director of Eminence Group, delivered an inspiring welcome note, underscoring the significance of Nitrosamine and their key challenges and also welcomed attendees & workshop leaders to set the tone for the event. Workshop by Dr. BM Rao. Dr. BM Rao, CEO QDots Associates addressed participants on the overview and impact of Nitrosamine, their formation pathways and their significance keeping industry framework in mind. He also spoke about the global regulatory guidance from Health Canada on Nitrosamine impurities in medicines. He also gave the overview of WHO draft working document published in April 2024. Also, he discussed the set and evolving guidelines around Nitrosamine with updates from EMANitrosamine/NDSRIs (from Rev 16 to Rev

20). Dr Rao, also conducted a case study on regulatory compliance and real-world scenarios of regulations and responses to nitrosamine contamination incidents, highlighted the best practices and lessons.
Industry Presentation
Purushottam Sutar, Deputy ManagerPharma (LC, LCMS)& Consumables Market, Shimadzu Analytical India Pvt Ltd, spoke about Nitrosamine & NDSRI Challenges. He also highlighted the industry is facing the issue of NDSRIs with many being reported with increasing frequency. He also spoke about shimadzu’s Ultra-Fast Mass Spectrometry (UFMS) technologies LC-MS/MS, powered by Analytical Intelligence, offer a comprehensive solution for precisely quantifying trace amounts of these impurities in various pharmaceutical products.
Bringing Together Different Perspectives
Panel Discussion: Future Regulatory Trends on Nitrosamine Possibilities and Certainties
This session focused on the evolving regulatory landscape concerning nitrosamines, which are chemical compounds of concern due to their potential carcinogenic effects. The discussion focused on identifying future trends in regulation, assessing both the possibilities and certainties in regulatory approaches, and understanding the
implications for the pharmaceutical industry. This powerpack session was moderated by Mr. Chetananand Pathak, Senior Director, Emcure Pharma, Dr. BM Rao, CEO, QDOT Associates, Dr. D Vijaya Bharathi, VP of Analytical Solutions, Aragen Lifesciences, Mr. Shital Pathak, SVPAnalytical R&D, Glenmark Pharma, Mr. Prashant Holkar, APAC Commercial Quality Head, Sandoz.
Shimadzu Facility Tour
Our delegates got an opportunity to explore Shimadzu's Customer Support Centre for hands-on lab experience and cutting-edge insights that showcased their latest analytical technology & analytical game in specially designed Q& A Session. Day 2 : Exploring Analytical Concepts and techniques for Nitrosamine Detection
Workshop by Dr. Somenath Ganguly. Dr. Somenath Ganguly, AVP, Sun Pharma addressed participants with indepth exploration of analytical techniques and methods for detecting and quantifying nitrosamine compounds while keeping focus on latest advancements and best practices , and also discussed about considerations for method development, validation, and ongoing quality assurance. Dr. Ganguly also presented a case study on Data Interpretation (API Drug Formulation Relationship) and group activity based on method development for nitrosamine analysis & also offered guidance on managing and responding to regulatory queries.
(Continued on page 131)
130 THE MAZADA PHARMA GUIDE
NEWS
UPDATE
NEWS UPDATE
ADVANCE DOE WORKSHOP 2024: A TESTAMENT TO THE POWER OF COLLABORATION, EDUCATION, AND INNOVATION
Our bureau, Mumbai
An exclusive Advance DoE Workshop 2024 hosted by Eminence Business Media, concluded with resounding success, inspiring participants with valuable insights to enhance their experimental design and optimization skills in Mumbai.
Key Highlights:
Expert Sessions: The masterclass leader was renowned industry expert Mr. Igor Gorsky, Principal Consultant, ValSource delivered insightful sessions covering fundamentals of DoE to advanced techniques in process validation and product design. Other experts like Dr.Aruna Khanolkar, Director – QbD, Cipla, and Dr. Arani Chatterjee, Jt. President, Cadila Pharmaceuticals explored in detail Response Surface Methodologies and Fundamentals of Statistics.

of-the-art facility where they witnessed GCMS, LCMS, and Spectrometry innovations and hands-on experience of the latest analytical and molecule separation technology.
Discussions on recent trends and developments in Quality by Design (QbD) methodologies, and risk-based approaches offered valuable insights into the evolving landscape of pharmaceutical manufacturing and quality management.
Exclusive Shimadzu Facility Tour: All delegates visited Shimadzu's state-
(Continued from page 130)
Industry Presentation:
Dheeraj Handique, Manager – GC/GCMS Product Marketing for Shimadzu Analytical (India) Pvt. Ltd addressed Nitrosamine Challenges using Shimadzu GC-MS/MS with UFMS technology. He also spoke about the contamination in valsartan API from a Chinese manufacturer in July 2018 and how Shimadzu's Ultra-Fast Mass Spectrometry (UFMS) technologies GCMS/MS powered by Analytical Intelligence, offers comprehensive solution for precisely quantifying trace amounts of these impurities in various pharmaceutical components.
Interactive Workshops: Hands-on case studies and group exercises provided participants with practical experience in applying DoE principles to real-world scenarios. These interactive sessions fostered collaborative learning and problem-solving. Invaluable Networking: The workshop provided an excellent platform for networking and knowledge exchange among industry professionals, academia, and regulatory experts.
Participants had the opportunity to
Understanding Toxicity & amp; Risk Assessment Strategies.
Dr. Ashutosh Joshi, Principal Scientist, Dr. Reddy’s. This discussion delved into advanced detection methods, explores their toxicity mechanisms, navigates regulatory landscapes, and presents techniques for successful risk assessment and understanding the role of TD50 in toxicological evaluations and regulatory compliance.
Acknowledgments: Celebrating Partnerships and Collaborations
The success of the event was made possible by the unwavering support and
engage with peers, share experiences, and build valuable Connections. Practical Applications: From optimizing processes to maintaining consistency and ensuring product quality, the workshop emphasized practical applications of DoE techniques in various aspects of pharmaceutical production and quality assurance.
As we reflect on the success of the Advance DoE Workshop 2024, we look forward to seeing the impact of the knowledge and skills gained by participants in driving innovation, efficiency, and compliance in the pharma industry. With a commitment to continuous learning and improvement, we anticipate even greater achievements in the future.
collaboration of our esteemed partners Shimadu, Sciex and Pragvas & Media Partners for their invaluable contributions and commitment to advancing quality standards in the Pharma industry.
Conclusion: Inspiring Change and Driving Transformation
As the Nitrosamine Advance Workshop 2024 concluded, participants departed with a rejuvenated feeling of commitment and motivation. The event provided valuable talks, collaborations, and practical insights, paving the road for positive change and transformation in the pharma quality landscape.
THE MAZADA PHARMA GUIDE 131
NEWS UPDATE
IRLAB TO CONDUCT A PHASE I STUDY OF THE DRUG CANDIDATE IRL757
Our bureau, Mumbai
IRLAB Therapeutics AB, a company discovering and developing novel treatments for Parkinson’s disease, announced that the Swedish Medical Products Agency has approved the initiation of a Phase I clinical study of the drug candidate IRL757. IRL757 is being developed as a treatment to counteract apathy – a condition that impairs the quality of life for millions of people with Parkinson’s disease, Alzheimer’s disease and other CNS diseases. The Phase I study is fully financed by the world’s largest non-profit funder of Parkinson’s research, The Michael J. Fox Foundation for Parkinson’s Research. “Following the positive announcement from the Swedish Medical Products Agency, we now look forward to initiating the first clinical study of our drug candidate IRL757 shortly. The extensive research support granted by The Michael J. Fox Foundation for Parkinson's Research shows that world-leading
external assessors share our confidence in the potential of IRL757 to counteract apathy, which today has no treatment and affects millions of individuals with neurodegenerative diseases and their relatives", comments Joakim Tedroff, MD, PhD, Chief Medical Officer, IRLAB.
Individuals suffering from apathy are characterized by indifference and resignation, rarely reacting to what is happening in the environment. The condition often causes significant disability and affects a large proportion of people living with Parkinson's disease, Alzheimer's disease and other diseases related to the central nervous system. There are currently no drugs on the market to treat apathy. IRLAB's drug candidate IRL757 has shown positive effects in several preclinical models of cognitive function, including improved motivation. The effect is believed to be associated with the drug candidate's unique ability to counteract disruptions in the nerve signaling that occurs between the cerebral cortex and
deeper brain parts and which is considered to be the cause of the onset of apathy in several neurological diseases. The Phase I study consists of two parts and aims to document the safety, tolerability and pharmacokinetic properties of IRL757 in healthy subjects. In the first part of the study, single ascending doses of the drug candidate are administered (SAD) whereas the second part covers multiple ascending doses (MAD). In addition, the possible influence of concomitant food intake will be documented. The study is expected to be fully completed by the end of 2024 and top line results are expected to be presented in the first quarter of 2025. The Michael J. Fox Foundation for Parkinson's Research (MJFF) has awarded a grant of approximately SEK 20 million to conduct this first Phase I clinical trial of IRL757. MJFF is the world's largest non-profit funder of Parkinson's disease research and the organization's support of IRL757 provides a strong external validation of the project's potential.

132 THE MAZADA PHARMA GUIDE
NEWS UPDATE


THE MAZADA PHARMA GUIDE


S.A.I. PRODUCTS
W-54, PHASE II, M.I.D.C.AREA, DOMBIVLI (EAST) – 421 204. Mob: +91 9821142051 l Email: saiproducts@yahoo.co.in
PRODUCTS









CHEMICAL INTERMEDIATES
APPLICATIONS
i)Sodium Azide For Bulk Drug Intermediates, For Explosives & Agicultural Products
(Continued on page 122)
ii) Ethyl/Methyl Palmitate As Chemical Intermediate
iii)Ethyl/Methyl Oleate
AGRICULTURAL PRODUCTS
i) MFA (Triacontanol) Powder Plant Growth Promoter & Fomulation-2%, 1%, 0.1%, 0.05%
ii) Dipping Oil Fruit Drying Oil
iii) Biosuper Plant Growth Regulator
iv) SuperFresh For Fruits & Vegetables
v) Vegetable/Fruit Special
vi) Herbogaurd Soil Fumigator
BIO PRODUCTS
i)Sophorolipid-Biosurfactant Used in Paint Industries, Biological, Agricultural,Bio-Processing, Cosmetic, Soap,Detergent, Mining, Petroleum, Environmental, Food Industries.
POULTARY FEED ADDITIVE
i)EnhanSo Powder Additive for Poultary Feed
ii)EnhanSo Liquid
134 THE MAZADA PHARMA GUIDE














THE MAZADA PHARMA GUIDE 135

RIDDHI SIDDHI DYE CHEMMULTI DYES & CHEMICALS
SALES STOCK OF CHEMICAL & GENRAL SUPPLIES
Sales Ofice : F-317, Raghuleela Mega Mall, 1st Floor, Behind Poisar Depot, Kandvali (West), Mumbai - 400067. Off. Tel. : 49791386, Mob. : 9223259151/9223243338 • Email : info@riddhisiddhidyechem.com, multidyes26@gmail.com Web : www.riddhisiddhidyechem.com
• AMMONIUM CHLORIDE (TECHNICAL)
• ALLUMINIUM SULPHATE (NON FERRIC)
• AMMONIA ALUM LUMPS
• AMMONIUM SULPHATE (TECHNICAL)
• ALUM POWDER
• ACTIVATED CARBON (150 MB/280MB)
• CALCIUM CARBONATE (PPT)
• CALCIUM CHLORIDE (FUES) AARTI MAKE
• CALCIUM CHLORIDE (POWDER)
• DI AMMONIUM PHOSPHATE (TECH)
• DI SODIUM PHOSPHATE (CRYSTAL)
• FERROUS SULPHATE (CRYSTAL)

• FERROUS SULPHATE (DRIED)
• FERRIC ALUM SLAB / LUMPS
• HYDRATE LIME (80% - 90%)
• LIQUOR AMMONIA
• MAGNESIUM CHLORIDE FLAKES (JCW MAKE)
• MAGNESIUM CHLORIDE CRYSTAL
• MAGNESIUM SULPHATE
• MAGANESE SULPHATE
• RESIST SALT (30%)
• RESIST SALT (50%)
• RESIST SALT (80%)
• RESIST SALT (95%)


• SODIUM ACETATE
• SODIUM ACETATE (TRIHYDRATE)
• SODIUM THIOSULPHATE (ATULMAKE)
• SODIUM THIOSULPHATE (P) CRYSTAL
• SODIUM SULPHIDE FLAKES (YELLOW)
• SODIUM METASILICATE (5H20/9H20)
• SODIUM HEXA META PHOSPHATE (TECH)
• SODIUM META BI SULPHITE
• SULPHAMIC ACID
• POTTASIUM META BI SULPHITE
• POTASH ALUM






136 THE MAZADA PHARMA GUIDE

CORE PRODUCTS
l HYDROQUINONE (HQ)
l PROPIONIC ACID
l IODINE PRILLS
l BKC 50% AND 80%
l TERT BUTANOL (TBA)
Email : payalimpex0894@Gmail.Com Tel : 9223439470/9022329470 8830460091
l TERT BUTYLHYDROQUINONE (TBHQ)
l ALL TYPES OF AMMINO ACIDS
l ACETIC ACID
l BENZOIC ACID
l N- BUTYRIC ACID
l CITRIC ACID
l ISOBUTYRIC ACID
l LACTIC ACID
l OXALIC ACID
l PHOSPHORIC ACID
SOLVENTS
l CYCLOHEXANONE
l PROPYLENE GLYCOL (PG)
l NORMAL BUTANOL (NBA)
l METHYL ISOBUTYL KETONE (MIBK)
FOOD ANTIOXIDANTS
l BUTYLATED HYDROXYANISOLE (BHA)
l BUTYLATED HYDROXYTOLUENE (BHT)
SPECIALTY CHEMICALS
l CALCIUM PROPIONATE (CP)
l TOLYLTRIAZOLE (TTA)
l XANTHAN GUM
METALLIC SALTS
l COBALT OXIDE
l COBALT SULPHATE
l COPPER SULPHATE
l FERROUS SULPHATE
l MANGANESE SULPHATE
l POTASSIUM IODATE
l POTASSIUM IODIDE
l SODIUM SELENITE
l ZINC OXIDE
l ZINC SULPHATE
Regd Address: 101 Madhuram Apartment, Sainagar, Near 60 Feet Road, Vasai Road West, Palghar 401202.



THE MAZADA PHARMA GUIDE 137
Import | Export | Inden ng | Distribu on | Marke ng



Manufacturing unit: 68 - 69 G.I.D.C. Industrial Estate, Nandesari - 391340, Vadodara, Gujarat
Sales O ce: 5531, Bas Harphool Singh, Sadar Thana Road, Delhi-110006
Email: info@qualikems.com / salesindia@qualikems.com l Website: h ps://qualikems.com/
PRODUCT NAME
GRADE
1- BROMONAPHTHALENE LR
AMMONIUM PHOSPHATE (MONOBASIC) LR/AR
AMMONIUM PHOSPHATE (DIBASIC) LR/AR
AMMONIUM SULPHATE AR
BARIUM BROMIDE LR
BARIUM CARBONATE LR
BARIUM CHLORIDE LR/AR
BARIUM CHROMATE LR/AR
BARIUM NITRATE LR
BISMUTH CARBONATE LR
BISMUTH NITRATE PENTAHYDRATE LR/AR
BISMUTH OXYCHLORIDE LR
BISMUTH SUBGALLATE LR
BISMUTH SUBNITRATE LR/AR
BISMUTH SULPHATE LR
BORAX DECAHYDRATE AR
BORIC ACID AR
BUFFER CAPSULE 4 , 7,& 9.2 LR
CADMIUM CARBONATE LR
CADMIUM CHLORIDE MONOHYDRATE LR
CADMIUM IODIDE LR
CADMIUM NITRATE TETRAHYDRATE LR/AR
CADMIUM SULPHATE 8/3 HYDRATE LR/AR
CALCIUM ACETATE LR
COBALT CARBONATE LR
COBALT CHLORIDE HEXAHYDRATE LR/AR
COBALT NITRATE HEXAHYDRATE LR/AR/ACS
COPPER FLUORIDE LR
COPPER NITRATE LR/AR
COPPER OXIDE BLACK /RED LR
COPPER SULPHATE ANHYDROUS LR/AR
COPPER SULPHATE PENTAHYDATE LR/AR/ACS
DI POTASSIUM HYDROGEN O PHOSPHATE LR/AR
DI-SODIUM HYDROGEN-O-PHOSPHATE LR/AR ANHYDROUS
ESCHAKA MIXTURE AR
HYDROXYLAMINE HCL
IMMERSION OIL LR
LEAD BROMIDE LR
LEAD CARBONATE LR
LEAD CHLORIDE LR
LEAD IODIDE LR
LEAD NITRATE LR/AR
LEAD OXIDE YELLOW LR/AR
LEAD PEROXIDE LR/AR
LEAD SULPHATE LR/AR
MAGNESIUM CHLORIDE HEXAHYDRATE AR
MAGNESIUM SULPHATE ANHYDROUS LR/AR

PRODUCT NAME GRADE
MAGNESIUM SULPHATE HEPTAHYDRATE AR
MANGANESE CHLORIDE TETRAHYDRATE LR
META PHOSPHORIC ACID LR
METHANESULFONYL CHLORIDE
METHANESULFONIC ACID
N-1 NAPTHYL ETHYLENE DIAMINE DI HCL LR
NICKEL AMMONIUM SULPHATE LR/AR
HEXAHYDRATE
NICKEL CARBONATE LR
NICKEL PHOSPHATE LR
NICKEL SULPHATE HEPTAHYDRATE
NICKEL SULPHATE HEXAHYDRATE LR/AR
POTASSIUM BROMIDE LR/AR/ACS
POTASSIUM CHROMATE LR/AR
POTASSIUM DICHROMATE LR/AR
POTASSIUM DIHYDROGEN O-PHOSPHATE LR/AR
ANHY.
POTASSIUM FLUORIDE LR/AR
POTASSIUM HYDROGEN SULPHATE LR/AR/ACS
POTASSIUM HYDROXIDE PELLETS LR/AR/ACS
POTASSIUM NITRATE AR
SODIUM BISULPHATE LR/AR
SODIUM BROMIDE LR/AR/ACS
SODIUM COBALTINITRITE LR
SODIUM CARBONATE ANHYDROUS LR/AR/ACS
SODIUM CARBONATE MONOHYDRATE LR/AR/ACS
SODIUM DIHYROGEN ORTHOPHOSPHATE LR/AR
DIHYDRATE
SODIUM FLUORIDE LR/AR
SODIUM HYDROXIDE PELLETS LR/AR/ACS
SODIUM MOLYBDATE LR/AR
SODIUM NITRATE LR/AR
SODIUM NITRITE LR/AR
SODIUM SULPHATE LR
SODIUM THIOSULPHATE ANHYDROUS LR/AR
STARCH SOLUBLE (POTATO) LR
STRONTIUM BROMIDE LR
STRONTIUM CARBONATE LR
STRONTIUM CHLORIDE LR
STRONTIUM NITRATE LR
STRONTIUM SULPHATE LR
TETRA POTASSIUM PYROPHOSPHATE LR/AR
TETRA SODIUM PYROPHOSPHATE LR/AR
TIN METAL GRANULAR AR
UREA LR/AR
ZINC FLUORIDE LR
ZINC SULPHATE HEPTAHYDRATE LR/AR
ZINC SULPHITE LR
138 THE MAZADA PHARMA GUIDE
WE CAN ALSO GIVE PLANT AUDIT AND VQ SUPPORT.

THERAPEUTICS
ANTI CONVULASNT PREGABALIN IP
PHENYTOIN SODIUM / BASE
ANTI HISTAMINE LORATIDINE BP
DIPHENHYDRAMINE HCL
ANTI ASTHAMATIC AMBROXOL HCL IP
BROMHEXINE HCL IP
LEVOSALBUTAMOL SULPHATE IP
MONTELUKAST SODIUM
ANTI -BIOTIC METFORMIN HCL IP
Office : 7 Th Floor , Unit No 716, Highway Commercial Center Premises Co-Op Soc Ltd, I.B. Patel Road Goregaon (E), Mumbai - 400 063 Tel: 91-22-46051578, 9819811703 l Email: info@nakshapharma.com Web: www. Nakshapharma.com
AMOXICILLIN TRIHYDRATE COMPACTED / POWDER IP/ BP
CLOXACILLIN SODIUM COMPACTED / POWDER -IP/BP
DICLOXACILLIN SODIUM COMPACTED / POWDER -IP/ BP
CEFIXIME IP COMPACTED
CEFPODOXIME PROXETIL IP / USP
CEFUROXIME AXETIL IP / USP
ANTI CHOLELITHIC URSODEOXYCHOLIC ACID IP
ANTIDIARRHOEALS ORNIDAZOLE IP
ANTI EMETICS DOMPERIDONE IP
ANTI-FIBRINOLYTICS TRANEXAMIC ACID IP
ANTI-FUNGALS FLUCONAZOLE IP
ANTIHPERLIPIDEMIC ATORVASTATIN CALCIUM IP
ANTI-INFLAMMATORY DICLOFENAC SODIUM IP
DICLOFENAC POTASSIUM BP
NIMESLIDE BP
PIROXICAM BP
MELOXICAM BP
ANTI -ULCERATIVE PANTOPRAZOLE SODIUM SESQUIHYDRATE IP CARDIOPROTECTANT METRONIDAZOLE IP/ BP
CONSTIPATION / LAXATIVES SODIUM PICOSULPHATE
BISACODYL
DECONGESTANT PHENYLEPHRINE HCL IP IMMUNOSUPPRESSANTS TACROLIMUS USP
MACROLIDES AZITHROMYCIN IP STEROIDS DEFLAZACORT IH NUTRACEUTICALS
THE MAZADA PHARMA GUIDE 139
PRODUCT NAME
CATEGORY
EXCIEPIENTS XANTHAM GUM 200 MESH XANTHAM GUM TRANSPERANT
MECOBALAMIN IP THERAPEUTICS
PRODUCT NAME (( API ) NUTRAACEUUTTIICCAALS E E XC CIIE EPPI IEEN N T T S S VI I T TAAMIIN
ALPHA LIPOIC ACID
VITAMIN
CATEGORY




140 THE MAZADA PHARMA GUIDE

Corp.Office: GroundFloor,UshaBuilding,S.V.Road, NearNanavatiHospital,VileParle(West), Mumbai-400056,Maharashtra.
Tel:+91(022)26104647/25188195
Mobile:+91(0)9768456789/9768312345
Email:info@siddhambikaimpex.com

FreseniusKabiAustria isoneoftheleading lactulosesuppliers,with morethan40yearsof experienceinits productionand distribution.Wesupply lactuloseinliquidand crystallineform manufacturedattwo productionsitesinLinz, Austria,andinVicchio, Italy.
Formoreinformationon ourLactuloseproduct portfolioandservices, pleasecontactour IndianDistributor.
Regd.Office: ShriMuniSuvratComplex,F-209,2ndFloor,Phase-1,RehnalVillage, Bhiwandi–421302,Thane,Maharashtra.
THE MAZADA PHARMA GUIDE 141
AuthorisedDistributorof WorldsLargestProducerof Lactulose Concentrate67%USP FromFreseniusKabiAustria YouCanalsocontactusfor: 1)OpthalmicAPI 2)AntiCancerAPI 3)Excepients 4)Vitamins
4TH COMPUTER SOFTWARE ASSURANCE 2024! CSX
Our bureau, Mumbai
The Indian Pharma Industry faces a myriad of challenges when it comes to ensuring the quality and compliance of computer software used in manufacturing processes. With stringent regulatory requirements, evolving technologies, and the increasing complexity of software systems, industry professionals are constantly seeking solutions to navigate these challenges effectively.
The 4th Computer Software Assurance 2024: CSx- Define your Variable and Assure your Validation conference has been meticulously designed to provide a platform for industry stakeholders to come together and tackle these issues head-on. This program scheduled for June 20th – 21st, 2024 at Hotel Radisson Blu Mumbai International Airport. Eminence Business Media promises to deliver cutting-edge insights and strategies crucial for the pharma industry's digital transformation.
The program is tailored to offer insightful discussions, practical workshops, and real-world case studies that illuminate the complexities of software assurance and validation in the pharma sector.
The program is tailored to offer insightful discussions, practical workshops, and real-world case studies that illuminate the complexities of software assurance and validation in the pharma sector. Keynote address will spotlight the convergence of software assurance and validation, while panel discussions will delve into regulatory hurdles. As digital transformation revolutionizes every aspect of the pharma sector, robust software validation practices are emerging as the essential key for ensuring compliance,
efficiency, and innovation.
Mr. Ken Shitamoto, Executive Director of IT Quality and Compliance at Gilead Sciences and a member of the FDA-Industry CSA will join as Keynote Speaker at the event.
With detailed discussions on advanced CSA implementation strategies, augmented reality applications, navigating complex regulatory landscapes, and solving the GAMP conundrum with several handson case studies and activities, this platform will provide innovative solutions to present-day challengesand also explore future trends that will shape the industry.
Ready to Join the Future
of CSA?
Don't miss this opportunity to elevate your expertise and be part of a transformative event that promises to shape the future of software validation and assurance in the pharma industry. Let's define our variables and ensure our validations together!
THE NEXT FRONTIER IN DRUG SAFETY IN INDIA
Our bureau, Mumbai
Following the resounding success of the Drug Safety Symposium 2024 in Dubai, we are thrilled to announce the much-awaited India Chapter of the Drug Safety Symposium 2024 on June 27th and 28th, 2024 at Radisson Blu Mumbai International Airport. Set against the backdrop of India's vibrant pharma landscape, this symposium promises to be a gathering of industry pioneers, regulatory experts, and thought leaders, all dedicated to advancing drug safety practices and shaping the future of healthcare. The symposium aims to bring together leading experts, industry professionals and thought leaders in the field of pharmacovigilance to discuss the latest advancements, regulatory changes, and innovative solutions driving the pharmaceutical industry forward.
Exploring emerging trends and solutions for current challenges:
As the pharmaceutical industry continues to evolve, so do the challenges and opportunities in drug safety. The symposium will feature discussions on a wide range of topics, including pharmacovigilance regulations, advancements in signal detection, the role of artificial intelligence in drug safety, and more. Attendees will have the opportunity to gain valuable insights into emerging trends and innovative approaches to addressing drug safety challenges.
Building on the success of the Dubai Edition:
Building on the success of the Dubai edition, the Drug Safety Symposium 2024 - India Chapter aims to further expand its impact and reach. With an emphasis on knowledge exchange, networking, and collaboration, this event will bring together stakeholders from across the pharmaceutical ecosystem to drive meaningful change and advance the cause of patient safety.
Join Us in Shaping the Future of Drug Safety:
We invite you to join us at the Drug Safety Symposium 2024 - India Chapter and be a part of this transformative journey. Together, we can explore new horizons, overcome challenges, and pave the way for a safer and healthier future. Stay tuned for more updates and announcements as we embark on this exciting venture. See you at the symposium !
Event Highlights:
• Engaging sessions and presentations on current trends and future strategies in drug safety.
• Interactive case studies and group activities for practical learning.
• Networking opportunities with professionals from around the globe.
• Comprehensive discussions on integrating technology and improving patient safety.
142 THE MAZADA PHARMA GUIDE
NEWS
UPDATE

Contact: Dr. Mishra, Mob: 7021031455, (W) No.: 9833687021 Email ID: rahulenterpris@gmail.com
D
l Zinc Oxide
l Sodium Benzoate
l Citric Acid
l Titanium Dioxide
l Cedarwood Oil
l Menthol Cristal
l Guar Gum
l Stearic Acid
l Benzoic Acid
l Vepowder
Shree Sai Gajanan Apt. Bldg. No. A2, Flat No. 003, Dawadi, Dombivli (East)421203
THE MAZADA PHARMA GUIDE 143 B-81 , Roop Nagar, Industrial Area, LONI-201102, Distt. GHAZIABAD (U.P) Mob: 9810435979, 9312417547 E-mail : rajshichemical@yahoo.com Rajshi Chemical & Products Manufacturers of : Life Saving Drugs NIACINAMIDE IP / BP NIACIN IP /BP ISONIAZID IP / BP Intersted in one consultant for API New item in our plant.
R R AHUL ENTE
ES
Address:
E R R PRISE
Dealers in Cheemiicaall, Ph h armace e utiiccaal l & Sollve e ntts s Product List
All
Grade
l Caustic Soda (Flakes/Ash) l Sucralose
ANSHUL SPECIALTY MOLECULES PVT. LTD.
Email: kirtikhasia@anshulchemicals.com
Phone/Whatsapp: 9819484114
Product Name Grade
Solifenacin Succinate INH/EP
Doxofylline INH/IP/USP
Pirfenidone IP/EP/BP
Silodosin JP
Mirabegron USP/INH
Methyl Phenidate USP/EP
Rivaroxaban USP/EP
Flexcel Park, C wing, 2nd Floor.Near 24 Karat Mul plex, S V Road, Jogeshwari (West), Mumbai - 400102, Maharashtra State, India

GANDHI CHEMICALS
301, Purva Plaza CHS LTD., Shimpoli road, Opp. Adani Electricity, Borivali(W), Mumbai-92 Landline: 91-22-61276444/45 l Phone: 7208855010/11
Website : www.gandhichemicals.com l Email : mktg@gandhichemicals.com
Partner : Mr. Alpesh Doshi - 9223433838 | Mr. Alpesh Gandhi - 9223433034
All solvent available in bulk and drum packing
All other solvents and chemicals as per the need of customer

l Acetone
l l Acrylic Acid
l l Aerosil 200
l l Butyl Acetate
l l Di Methyl Formamide (DMF)
l l Ethyl acetate
l Glycerine
l l Iso propyl Alcohol (IPA)
l Methanol
l Methylene Chloride (MDC)
l l N-Butanol
l l N-Propanol
l l Propylene Glocol (PG)
l l Sorbitol
l l Toluene
ll Xylene




144 THE MAZADA PHARMA GUIDE
AUTHORIZED DDI I S T TR RIIBUTTOOR O OF SUNRAJ CHEMICAL CO. ChlorosulphonicAcid OleumAcid25%and65% NitricAcid72%and98% DiethylSulphate BenzeneSulphonicAcid ThionylChloride AvailableinsmallpackingandinBulk K.B.AchhraChambers,2ndFloor,BehindHariKirtan Darbar,Section17,Ulhasnagar–421003. Tel.: 0251–2707408,2731484 Mob.:9422686622/9096576500 Email: sunraajchem@yahoo.co.in
l Sodium Iodide
l Potassium Iodide
l Ammonium Iodide
l Copper Iodide
l Zinc Iodide
l Silver Iodide
l Calcium Iodate
l Potassium Iodate
Organic Iodine Derivatives
l Methyl Iodide
l Ethyl Iodide
l Iodopropane
l 2-Iodopropane
l Iodobenzene
l 2-Iodo Benzoic Acid
l 3-Iodo Benzoic Acid
l 4-Iodo Benzoic Acid
l 2-Iodoaninile
l 3-Iodoaninile
l 4-Iodoaninile
l Iodobutane
l Trimethyl Sulfoxonium Iodide
l 3,5 Diiodo salicylic Acid
l Di Iodo Methane
l Di Iodo Ethane
PRODUCT DETAILS
l Sodium Iodate
l Sodium Meta Par Iodate
l Potassium Meta Par Iodate
l Lithium Iodide Hydrate
l Nickel Iodide
l Lead Iodide
l Cadmium Iodide
Inorganic Bismuth Derivatives
l Bismuth Oxide
l Bismuth Citrate
l Bismuth Subsalicylate
l Bismuth Subgallate
l Bismuth Carbonate
l Bismuth Nitrate
l Bismuth Hydroxide
l Bismuth Subnitrate
l Bismuth Sulphate
l Bismuth Oxychloride
Inorganic Selenium Derivatives
l Sodium Selenite
l Sodium Selenate
l Thallium Iodide
l Antimony Iodide
l Hydroiodic Acid
l Calcium Iodide Hydrate
l Iodine Monochloride
l Iodic Acid
l Per-Iodic Acid
Inorganic Cobalt Derivatives
l Cobalt Nitrate (Hexahydrad)
l Cobalt Carbonate
l Cobalt Sulphate
l Cobalt Chloride
l Cobalt Acetate
Resolving Agent
l DPTDTA
l DPTLTA
l DBDTA
l DBLTA
Other Chemical Compound
l Zinc Pyrithione
l Allopurinol
l Fenofibrate
l Copper Oxychloride
Contact Details : Shriram R. Vishwakarma: 9422094384 / 9767510640
Suhas N. Sakalkar. 9870127965
Email ID : svgpharma.life@gmail.com
Office Address : 106, Haridarshan Building, Katrang Road, Khopoli, Dist- Raigad 410203
Corporate office Address : Plot No. G-6, Silver Spring, Unit No. A 128, Taloja, Navi Mumbai Pin 410208, Dist- Raigad, Maharashtra.
Site Address : Survey No. 48/3, 48/2, 49/1, 55A Village Honad, Tal Khalapur, Dist Raigad, Maharashtra 410203

ISO 9001:2015 CERTIFIED LABORATORY
State of the Art Advanced Instrumentation Centre for All Analytical Requirements GC-ALS, GC/MS, GC-HSS, ICP-OES, HPLC,GPC, IC, XRD, XRF, DSC, TGA, FTIR, CHNS, Particle size, Porosimetry, SEM, SEM-EDAX and Chemical Analysis
Services:
Purity of solvents by GLC and KF
Metal tes ng by ICP-OES up to ppb level
Anions and Ca ons by Ion
Chromatography up to 0.1 ppm
Molecular weight determina on by GPC
Purity by HPLC
FAME Analysis
Contact Us @ DR. KETAN MERCHANT
Email ID: saslab21@gmail.com , info@saslabindia.com
Mobile: 8850413449 / 9821291797 / 9821075247
Tel: 91-22-25000386 / 25000186 / 42150502
Website: www.saslabindia.com
Address: 305, 3rd Floor, Jhalawar Building, Patanwala compound, opposite Shreyas Talkies, LBS Marg, Ghatkopar-West-400086
THE MAZADA PHARMA GUIDE 145
PHARMA
PVT. LTD.
SVG
LIFESCIENCES



146 THE MAZADA PHARMA GUIDE MANUFACTURERS & EXPORTERS OF CASTOR OIL & ITS PRODUCTS CIN. L24100MH1992PLC066691 JAYANT AGRO-ORGANICS LIMITED Products Castor Oil – Pharmaceu cal Grades Hydrogenated Castor Oils Ethoxylated Castor Oils Castor Based Petrolatum Subs tute Regd. O ce : 701, Tower ‘A’ Peninsula Business Park, Senapa Bapat Marg, Lower Parel(W) Mumbai 400 013 India Tel.: +91 22 4027 1300 l Fax: +91 22 4027 1399 l l Email: info@jayantagro.com l l Website: www.jayantagro.com

Officeno:- 45,3rdFloor,PheerbhoyBuilding,Dawabazar,89,PrincessStreet,Mumbai-400002.
Tel.: 022-66379219 Mob.: ()09322211535/07977180631

Email: bshahandsons@gmail.com Website: www.shahandassociates.co.in
LIST OF ESSENTIAL OILS
Aleovera Gell / Powder
Ajwain Oil/Thyme Oil
Almond Oil Sweet / Bitter
Anise Oil
Basil Oil
Camphor
Castor Oil
Clove Oil
Clove (Rectified)
Citronella Oil
Cinnamon Oil
ENZYMES
Protease
Amylase
Glucoamylase
Alphagalactosidase
Lipase
Cellulase
Lactase
Invertase
FungalDiastaseIP
PepsinIP
BacterialAlphaAmylase
NeutralProtease
Pectinase
PancreatinIP
PapainIP
API
ValganciclovirUSP
Caraway Oil
Capsicum Oleoresin
Camphor Oil
Cardmom Oil
Cypress Oil
Cajiput Oil
Cumin Seed Oil
Cedarwood Oil
Davana Oil
Dill Oil
Eucalyptus Oil
Eucalyptol
VogliboseIP
Euginol
Fennel Seed Oil
Ginger Grass Oil
Geranium Oil
Garlic Oil
Iso Borneol Flakes
Jasmine Oil
Jojoba Oil
Juniper Berry Oil
Lime Oil
Lemon Oil
Lemon Grass Oil
CalciumFolinateIP/USP
OrmeloxifeneIP
CabergolineIP/USP
SerratiopeptidaseIP
Niacinamide
Tamsulosin
Adapalene
Lulicanazole
Nimusulide
Ibuprofen
Clotrimazole
VitaminE
VitaminA1.7
Bromhaxine
Ambroxol
FerrousAscorbate
CalciumPropionate
DiclofenacSodiumI.P
Acetylsalicylic Acid / Asprin
I.P. / B.P / USP
Beta Carotine 20 % and 30 %
Bromelain 2400 GDU
DHA 10 % And 20 %
Homosalate
Lutein Powder 10 %
Lycopene 6% 10 %
Methyl Paraben I.P.
Lavender Oil
Linseed Oil
Menthol
Methol Crystal
Nutmeg Oil
Neem Oil
Orange Oil
Olive Oil
Patchouli Oil
Pine Oil Lr.
Peppermint Oil
Palmrosa Oil
DiclofenacPotasiumI.P
SerratiopeptadiaseI.P
Encoated
VITAMINACTIVES
L-MethylfolateCalcium
VitaminK2[MK4]
DeltaTocotrienol
PyridoxineCyclicPhosphate
Pyridoxal-5-Phosphate
PyridoxaminediHydrochloride
CalciumFolinate
ANTIOXIDANTS/ NUTRACEUTICALS
Pyrroloquinolinequinone(PQQ)
EN-Q10(UbiquinolAcetate)
GrapeSeedExtract
GinsengExtract
Methyl Paraben Sodium I.P.
Methyl Salicylate I.P. / B.P. / USP
Octyl Salicylate
Papain 1:350 BPC
Papain Refined
Papain I.P.
Papain LG 200
Papain USP/NF
Papain USP 6300
Rose Oil
Rosemarry Oil
Sesame Oil
Spearmint Oil
Turpentine Oil
Turmuric Oil
Terpineol
Thymol Crystal
Tea Tree Oil
Vetivert Oil
Winter Green Oil
Wheat Germ Oil
GreenTeaExtract
GamaOryzanol
ResArgin
Pterostillbene
ResCu(BioavailableCurcumin)
PineBarkextract
Co-enzyme010
Resveratrol
Bilberryextract
MulberryExtract(1%DNJ)
AlphaGPC
s-Equol
y-GlutamylCysteine
ResArgin
PROBIOTICS
LactobacillusSpecies
BifidobacteriumSpecies
StreptococcusSpecies
Bacillusclausii
Saccharomycesboulardii
Papain USP (50000 USP/mg)
Papain x / 2x / 4x / 5x / 8x
Propyl Paraben I.P.
Propyl Paraben Sodium I.P.
Ruthoside
Salicylic Acid I.P. / B.P / USP
Sodium Salicylate I.P.
Trypsin BP / USP
Trypsin Chymotrypsin Mix (6:1)
THE MAZADA PHARMA GUIDE 147
CommittedforQualityServicesSince1957
GAURI ACIDS PVT. LTD.
Plot No. 32, New Chemical Zone, M.I.D.C. Taloja. Mobile: 9833086472, 8097280458
Email: gauriacids@yahoo.com
Manufacturer Of Cas No.
Meta Chloro Anisole (MCA)
2,7-Dichloro-alpha-[(dibutylamino)
methyl]-9H-fluorene-4-methanol
Lumefantrine
Tolfenamic Acid EP/BP
Diosmin EP/BP
IP/EP
Flavoxate Hydrochloride EP/BP 3717-88-2

CAN OFFER FOR IMPORT FROM RELIABLE SOURCES
FOLLOWING HIGH PURITY MATERIALS:
ALUMINA ACTIVATED ALUMINA ALUMINUM HYDROXIDE BOEHMITE PSEUDO-BOEHMITE SPECIALITY ALUMINA FOR FINE POLISHING ALUMINA PRODUCTS: GRANULES, PELLET, CRACKLE CRYSTAL, POLYCRYSTALLINE ACTIVATED ALUMINA BALL AMMONIUM ALUM
For your import, please contact: Mobile: +91-9820408556/ 9819880118
E-mail: contact@kailashmarke ng.co.in Web: h ps://www.kailashmarke ng.co.in





















148 THE MAZADA PHARMA GUIDE
2845-89-8
69759-61-1
82186-77-4
13710-19-5
13739-02-1
520-27-4 Diacerein



u AMOXAPINE
u LOXAPINE SUCCINATE
u AMISULPRIDE
u DABIGATRAN ETEXILATE
u SILODOSIN
u MONTELUKAST SODIUM
u FINASTERIDE
P P RODUCT LIST T
u LEVOSULPRIDE
u TENELIGLIPTIN
u TORSEMIDE
u PRAZIQUANTEL
u PRUCALOPRIDE SUCCINATE
u IRON SURCLOSE
u CILIDIPINE
u RABEPRAZOLE SODIUM
u RIFAXIMIN
u KETOPROFEN
u FEBANTEL
u OMEPRAZOLE POWDER
u BREXPIPRAZOLE
u CABERGOLINE
u FEBUXOSTAT
Contact : Agam Shah : +91 9920899117
Office Address: 502,Shree Radhe Empire, Chandavarkar Road, Borivali (West), Mumbai:- 400092. Tel +91 022-35593585 | Email: juanapharma@gmail.com | Web: www.juanapharma.com
THE MAZADA PHARMA GUIDE 149 Active
Pharmaceutical Ingredients (APIs) We provide best solutions in: APIs | Pellets | Excipients | Flavours | Fragrances

PRODUCTSMANUFACTUREDBYUS
SODIUM CHLORIDE I.P. / B.P. / U.S.P. / FOOD (ALL GRADE)
POTASSIUM CHLORIDE I.P. / B.P./ U.S.P. / PURE (ALL GRADE)
AMMONIUM CHLORIDE I.P. / B.P. / U.S.P. / PURE/TECHNICAL
DRIED FERROUS SULPHATE I.P. / B.P. / USP (FOR FEED ALSO AVAILABLE)
FERROUS SULPHATE HEPTAHYDRATE I.P. / B.P. / U.S.P /
COMMERCIAL QUALITY ALSO
DI-SODIUM HYDROGEN CITRATE I.P. / B.P. (FOR USE IN DIURETICS)
SODIUM CITRATE I.P.
NEWLYLAUNCHEDPRODUCTS
CITRIC ACID MONOHYDRATE I.P. CITRIC ACID ANHYDROUS I.P. MAGNESSIUM SULPHATE I.P. / B.P. SODIUM BI CARBONATE I.P. / B.P.
For Your Requirement Kindly Contact

PRAVINAPHARMA CHEMPRODUCTS
Factory: 1709, GIDC, Indl. Estate, Sarigam, Via Bhilad, Dist: Valsad, Gujrat – 396 155.
Corr. Add.: 803 Mohid Tower, Daman Road, Near Jayshree Cinema, Chala : Vapi – 396191 (Gujrat)
Cell: +90993 03555 / 93770 06330 Telefax: 0260 2462360 Email: info@ppcp.co.in
FoodColours,LakeColoursandPearlPigments Attn.:Pharmaceutical,Capsules,Tablets,Cosmetics&EdibleProductManufacturersandExporters
FASTGREENFCFLAKEFASTREDELAKEINDIGOCARMINELAKE PONCEAU4RLAKEQUINOLINEYELLOWLAKE TARTRAZINELAKESUNSETYELLOWFCFLAKE BLENDEDLAKESAPPLE/PEAGREEN/BLACK/BROWNLAKE IRONOXIDE(RED/YELLOW/BLACK/BROWN) AlsoavailableD&CColoursandD&CLakesLikeGreen5,6/Violet1,2/Yellow7,8/ Red4,6,7,17,19,21,22,27,28,30.33,36. AvailablePearlPigmentsinvariousshades

150 THE MAZADA PHARMA GUIDE
ManufacturingBestQualityBulkDrugs&Fine
ChemicalsSince30Years
DISTRIBUTORSHIP/DEALERSHIP/AGENCYINQUIRIESSOLICITED
ALLURAREDLAKEAMARANTHLAKEBRILLIANTBLUEFCFLAKE CARMOISINELAKECHOCOLATEBROWNHTLAKEERYTHROSINELAKE
D-14/5,TTCInd.Area,NearRecondaVillage,Turbhe,NaviMumbai-400705.INDIA
AnISO9001-2015,WHO-GMP,HACCP,KOSHER&HALALCertifiedCompany Manufacturers&ExportersofLakeColours&FoodColours
Ph.(+91)9323132280/9137179278 | Mobile-(+91)-7021673493,9323087138 E-mail:-colours@standardcon.com | web:www.standardcon.com
l
l
l
SOLVENTS
OTHERS PRODUCTS
l C CAASSTTOR R OI I L L
l PET TR R OL LIIU U M M JE ELLLLY Y
ll RRU UBBB BEER R O OIIL L

THE MAZADA PHARMA GUIDE 151 Manufacturer and supplier of Pharmacopoeia Impurity standard as per EP/USP/BP/IP/FP and all process related impurity. Custom synthesis project Isola on and iden fica on of unkonwn products or impuri es ALLMPUS LABORATORY PVT LTD Allmpus Laboratories Pvt Ltd 38, Solitaire Industrial Estate, Plot No.TS-1, Near Nandi Palace Hotel, MIDC-Phase 1, Dombivali (E),Mumbai, Maharashtra 421203 Contact: 7506256625 Email: Info@allmpus.com Website: www.allmpus.com H K ENTERPRISE 108 , SAI JYOT NEEPA CHS , JUNCTION OF S N ROAD & S L ROAD, MULUD WEST, MUMBAI- 80. l O ce NO : 022 2562 2600 / 2700 KIRTI SHAH : 9223 43 2600 l HARDIK SHAH : 9223 29 2600 l ANKIT SHAH : 9223 26 2600 Email id : hkenterprise1973@gmail.com (ESTD 1973) We are the regular STOKIEST of M/s V V F ( INDIA ) Ltd. OUR STRENGTH: FATTY ACID l STEARIC A ACI I D ( RE EGULAAR / RRU U BBER G GRAADE //43-445 % // 655% % // 90 % ) l G GLLYC CEER RIINE ( IP // BP // C CP // U USSP // BUULK // FSSSSAAI // IMPOR R T TE E D D )
l OL L E EIIC C A ACCI I D ( ( IIN N D DIIAAN N // IIM M P P OR R T TE E D D ) l l DIISSTTI I L L L L E E D D C COCCO F FAATTTTY Y A ACCI I D ( ( D D C CFFA A ) ) l l DIISSTTI I L L L LIIE E D D S SOYYA A F FAATTTTY Y A ACCI I D
l C CAAP P RIIC C A ACCI I D D l l C CAAP P R R Y YL LIIC C A ACCI I D D l l C CAAP P RIIC C C CAAP P R R Y YL LIIC C A ACCI I D D
l C CAAP P ROI I C C A ACCI I D D l l L L A AU U R RIIC C A ACCI I D D l l P PAAL L M M E E T TI I C A ACCI I D D
l M M Y YR RIISSTTI I C A ACCI I D D
l S L L E S S 700% % l l S O A AP P N O O D D L E E S FATTY ALCOHOL
l
l
l
l
l
C CE E TTO O S STTE E A ARRYYL L A ALLCCOOHOOL – CC 16618
l P P U U R R E LLAAU U R R Y YL L A AL L C COOH H O OL L –– C C 1 1 2
l LA AU U RY YL L M M Y YR RIISSTTYYL L A AL L C COOH H O OL L –– C 1 1 21 1 4 l l C CE E TTYYL L A AL L C COOH H O OL L –– C C 1 1 6
l
l
l S STTE E A AR R Y YL L A AL L C COOH H O OL L –– C 1 1 8 8
l BEHENY YL L A AL L C COOH H O OL L –– C 22
: ( BULK / DRUM )
l M M EE G l l D D EE G G l l M M II B B KK l l M M EE KK
l C CYYCCL L OHEEXAAN N O ONNE E
l C C Y YC CLLO OHHE E XAAN NEE
l A AC CEETTO ONNE E
l NN B BUUTTAANNOOL L l O OCCTTAANNOOL L l B BUUTTYYEEL L AACCEETTAATTE E l E ETTHHYYL L AACCEETTAATTE E l AACCEETTIIC C AACCIID D l I P AA l D DII--AACCEETTOONNE E
AACCEETTOONNIITTRRIIL L
TTOOLLUUEENNE E
M MEEHHAANNOOL L
: l S STTYYRREENNE E M MOONNOOMMEER R l V A M M l l BB A M M
l 2 2 EETTH H Y YL L HHE E X XYYL L AC C Y YL L ATTE E
l M M M M A l l M M A A
l AC CRRYYL LIIC C AC CIID D l l 2 2 HHE E M M A
l
l
l
l
l
l
l
l
MONOMERS
l
l
l
: l PHO OSSP P HO OR R IC C A ACCI I D D ( TTEECCH H // F FOOOOD D G GR R A AD D E ) ) l F FOOR R M M I I C A ACCI I D ( 8 85 5 % // 9 99 9 % % ) ) l M D C C l A ACCRRYYL L A AM M I I D D E l M D I l TT D I I l D P G l PR ROOP P YYL L ENE G GLLYYCCOOL L (TTEECCH H N N I I C CAAL L // U U S SP P ) l BENZYYL L A AL L C CO O H H O OLL l l S SO ODDI I U U M M G GLLU U C CO O N N A ATTE E l l EEP P O OXXY Y RRE E S SI I N N
l BBI I S SP P H HEEN N OLL A
l S SO ODDA A A ASSH H
l C C A AU U S STTI I C C S SO ODDA A FFL L A AK KEES
l
l
l
S
STTI
OTTTTAASSH H
A AK KEES S
AF FIIN N WAAX X
EEAAV
Y
QU UIIE E D D P PAAR R A AF FIIN N OI I L
l l C C A AU U S
I C C PPO
FFL L
l l PPE ERRA
l l H H
VY
LLI I
l LIIGGH H T T L LIIQU UIIE E D D P PAAR R A AF FIIN N OI I L L











152 THE MAZADA PHARMA GUIDE

ACECLOFENACI.P./B.P./E.P.CASNO.89796–99-6Anti-Inflammatory ALLOPURINOLI.P./B.P./E.P./U.S.P.CASNO.315–30-0UricAcidLoweringAgent ARMODAFINILINN/I.P.CASNO.112111–43–0AntiPsychotic BENFOTIAMINEINN/JPC/KPCASNO.22457–89–2Vitamin BENZOCAINEI.P./B.P./E.P./U.S.P.CASNO.94–09–7Anesthetic BUPROPIONHYDROCHLORIDEU.S.P..CASNO.31677–93–7Antidepressant CETIRIZINEDIHYDROCHLORIDEI.P./B.P./E.P.CASNO.83881–52–1AntiHistaminic CHOLINEFENOFIBRATEU.S.P.CASNO.856676–23-8AntiHyperlipoproteinemic DEFERASIROXINNCASNO.201530-41-8Ironchelator FENOFIBRATEI.P./B.P./E.P./U.S.P.CASNO.49562–28–9AntiHyperlipoproteinemic FENTICONAZOLENITRATEB.P./E.P.CASNO.73151-29-8Antifungal LEVOCETIRIZINEDIHYDROCHLORIDEINN/I.P./U.S.P.CASNO.130018–87–0AntiHistaminic MEFENAMICACIDI.P./B.P./E.P./U.S.P.CASNO.61-68-7NSAID MICONAZOLEE.P.CASNO.22916–47-8Antifungal MICONAZOLENITRATEIP./B.P./E.P./U.S.P.CASNO.22832–87–7Antifungal MODAFINILI.P./B.P./E.P./U.S.P.CASNO.68693–11–8AntiPsychotic PERAZINEDIMALONATECASNO.14777–25–4AntiPsychotic PROCHLORPERAZINEMALEATEI.P./B.P./E.P./U.S.P.CASNO.84–02–6AntiPsychotic SEVELAMERCARBONATEINNCASNO.845273–93–0AntiHyperphosphatemic SEVELAMERHYDROCHLORIDEINNCASNO.152751–57–0AntiHyperphosphatemic PRODUCTNAME

DESVENLAFAXINESUCCINATECASNO.386750-22-7Anti-Depressant FLUVOXAMINEMALEATECASNO.61718-82-9Anti-Depressant VENLAFAXINEHYDROCHLORIDECASNO.99300-78-4Anti-Depressant VILDAGLIPTINCASNO.274901-16Anti-Hyperglycemia
DAPOXETINECASNO.119356-77-3SSRI GLIMEPRIDECASNO.93479-97-1Anti-diabetic LOSARTANPOTASSIUMCASNO.124750–99-8Anti-Hypertensive

TOFISOPAMCASNO.22345-47-7Anxiolytic
PALONOSETRONCASNO.135729-62-3CiNV POSACONAZOLECASNO.171228-49-2Anti-Fungal PREGABALININN/I.P.CASNO.148553–50-8Anticonvulsant

INTERMEDIATEFORALLOPURINOL3-AMINO-4-PYRAZOLECARBOXAMIDEHEMISULFATECASNO.27511–79–1
INTERMEDIATESFORARMODAFINILMODAFINICACID[MODAFINILCARBOXYLATESULFONE]
CHEMICALNAME:-2-[(DiphenylMethyl)Sulfonyl]AceticAcidCASNO.101094-05–7
R-2-BENZHYDRYLSULFINYLACETICACIDCHEMICALNAME:-(-)2-[(DiphenylMethyl) Sulfinyl]AceticAcidCASNO.63574-24–0
ARMODAFINILCARBOXYLATEMETHYLESTER
CHEMICALNAME:-(-)2-[(DiphenylMethyl)Sulfinyl]AceticAcidMethylEster CASNO.63574-25–1
INTERMEDIATEFORBENFOTIAMINETHIAMINE-O-MONOPHOSPHATECASNO.10023-48-0
INTERMEDIATEFOR4-HYDROXYBENZYLALCOHOL
BISOPROLOLHEMIFUMARATECHEMICALNAME:-p-HydroxybenzylAlcoholCASNO.623-05–2
INTERMEDIATEFORBRIMONIDINE5-BROMO-N-(2-IMIDAZOLIN-2-YL)-6-QUINOXALINAMINECASNO.59803–98–4
INTERMEDIATEFORCETIRIZINEHCL4-CHLOROBENZHYDRYLPIPERAZINE[PARACHLOROBENZHYDRYLPIPERAZINE] CASNO.303–26–4
INTERMEDIATEFORDEFERASIROX4-HydrazinonebenzoicAcidCASNO.24589–77–3 2-(2-Hydroxyphenyl)-4H-1,3-benzoxazin-4-onCASNO.1218–69-5
INTERMEDIATEFORFENOFIBRATEFENOFIBRICACID-CHEMICALNAME:-2-[4-(4-CHLOROBENZOYL)PHENOXY]-2-METHYL PROPIONICACID-CASNO.42017–89-0
INTERMEDIATEFOR(-)-1-[4-(CHLOROPHENYL)PHENYLMETHYL]PIPERAZINE LEVOCETIRIZINEHCLCASNO.130018–88–1
INTERMEDIATEFORMICONAZOLE,1–(2,4-DICHLOROPHENYL)-2-(1H-IMIDAZOL-1-YL)ETHANOL TIOCONAZOLE,ENILCONAZOLE,CASNO.24155–42–8 ISOCONAZOLE,ECONAZOLE
INTERMEDIATEFORMODAFINILDIPHENYLMETHYLTHIOACETAMIDE/BENZHYDRYLTHIOACETAMIDE CASNO.68524-30-1
THE MAZADA PHARMA GUIDE 153
CASENO. GROUP

NDC DRUG & CHEMICAL CO.PVT.LTD.
C-401/402, RAMDEV COMMERCIAL CENTRE, DR.DALVI ROAD, NR BANK OF INDIA, KANDIVALI(W), MUMBAI 400 067
PHONE NO. 28625921 / 28625922 FAX.NO.28625923
EMAILID: hdshah2050@gmail.com / ndcpl2020@gmail.com / nimeshshah1966@gmail.com
l 2-Bromo-2-Nitro-1-3-Propanediol 99%
l Aceclofenac Ip
l Acesulfame Potassium Bp/Usp/Ep
l Acrypol (Carbomer)–934,940 & All Grades
l Acrypol 956 (Sani zer Grade)
l Acrypol Elt20
l Acrycoat L-100/S-100
l Acrysol K-140/K-150
l Azithromycin Ip
l Kyron T-314/T-114/T-134
l Adrenaline Bitartrate Ip
l Alpha Lipoic Acid
l Ambroxol Hcl Ip
l Ammonium Sulphate
l Benfo amine
l Benzocaine Ip.
l Benzoic Acid Ip - Ganesh
l Bronopol Ip/Bp (Niranjan/Surya)
l Cholecalciferol Ip
l Chlorpheniramine Maleate Bp
l Citric Acid Mono Ip – Sunil / Vasa
l Clotrimazole
l Copper Sulphate Pentahydrate
l Cyanocobalamine Ip
l Dapagliflozin Propanediol Monohydrate
l Deflazacort Ihs
l Dexamethasone Sodium Phosphate Ip
l Dextromethorphan Hydrobromide Ip
l Disodium Hydrogen Citrate Bp
l Dl Methionine Feed Grade

l Doxycycline Hyclate Ip
l Edta Disodium
l Edta Tetra Sodium
l Ferric Ammonium Citrate Ip
l Gamabenzene Hexachloride
l Guaifenesin Ip
l Hydrocor sone Acetate Ip/Ep
l Ivermec n Ip
l L-Glutamic Acid Bp
l L-Lysine Hcl Usp (Devendra Kir /Suprim
l Light Magnesium Carbonate Ip
l Loperamide Hcl Ip
l M.A.G.
l Magnesium Sulphate 7h2o
l Malic Acid
l Manganese Sulphate
l Methyl Cobalamine Ip
l Methyl Prednisoline Ep/Ip/Usp
l Neotame (Fcc/Usp)
l Niacinamide Ip
l Orthophenylphenol
l Ornidazole Bp
l Oxetacaine Bp
l Phenylephrine Hcl Ip
l Potassium Citrate Ip
l Potassium Iodide Ip
l Potassium Sorbate
l Povidone Iodine Ip
l Pvpk 30
l Pyridoxine Hydrochloride Ip
l Sodium Acetate Trihydrate
l Sodium Benzoate Bp-China
l Sodium Benzoate Ip-Ganesh
l Sodium Chloride Ip
l Sodium Citrate – Cambodia /Vasa/Sunil
l Sodium Gluconate
l Sodium Hydroxide Pellets
l Sodium Metabisulphite
l Sodium Sacharine Bp
l Sodium Selenite
l Sorbic Acid
l Sucralfate Usp (China)
l Sucralose Fcc/Usp/Nf
l Tannic Acid
l Thiamine Hydrochloride Ip
l Tolna ate Usp
l Triclosan
l Tricholine Citrate 65% Soln
l Vegarol 1618ta(Ceto Stearyl Alcohol
l Vitamin A Palmitate 1.7 Miu/G
l Vitamin C Coated
l Vitmamin C Plain (Ascorbic Acid)
l Vitamin D3 Stabilised 850ip Water Soluble
l Vitamin E Acetate Liquid
l Vitamin E Dry Powder 50% Pharma
l Xanthan Gum – Meihua (China)
l Xanthan Gum – Fufeng (China)
l Xanthan Gum (Transparent Grade)Austria
l Zinc Sulphate Heptahydrate
l Zinc Sulphate Monohydrate
154 THE MAZADA PHARMA GUIDE
LIST
HYDROQUINONE TRI BUTYL PHOSPHATE L ASPARTIC ACID SODIUM FORMATE ORTHO CHLORO BENZOIC ACID SUCRALOSE ASPARTAME GLYCERINE BENZOPHENONE Contact
Office
Email: sales@panchamrutchemicals.com
203, GANGOTRI, HARIDAS NAGAR, SHIMPOLI ROAD BORIVALI (WEST), MUMBAI - 400 092 PANCHAMRUT
PRODUCTS
OF PRODUCTS
Details : 9870795121 / 9825242122
No.: 7021778189 / 8591740139
/ info@panchamrutchemicals.com
CHEMICALS

A Company with Innovative Catalysts & Hydrogenation support, under one roof endless solutions .
Nickel and precious metal homogeneous and heterogeneous catalysts
Precious Metal Catalysts/Compounds (Palladium, Platinum, Ruthenium, Rhodium, Silver and Gold)
Precious Metal Catalysts support on Carbon, Calcium Carbonate, Barium Sulfate, alumina etc
Precious Metal salts
like Chloride, Sulfates , Nitrates, Acetate etc.


Cross Coupling , DPPF Catalyst ligands like ,Tetrakis(TPP), Bis (TPP), DBA F, , TCHP etc.
aney Nickel Catalyst (Active), Fixbed Nickel catalyst, Green and Black Nickel R
Regeneration, Recovery & Refining (Reprocessing of Used Catalysts.)
Catalysts Screening & Process Optimisation Nickel base Catalyst.
& SOLVVENTS
We are able to recover up to 99.5% of precious metal present in the spent catalysts, alloys & scraps.
Hydrogenation facility from gram scale to 5.0 KL, to reduce the customer's catalyst inventory.
The company has expertise in catalytic hydrogenation and the automates asai & T hydrogenation facility in V Taarapur from gram scale to tons scale on contract basis.
Plot No.54, Apple Industrial Hub, NH48, P
alghar 401208. asai, P VTaal.T
elhar Village, development. esearch & , Scale up, R process optimization, efficient technology transfer mance, for vices include: Catalyst Screening, Increased catalyst per Our Ser aney Nickel Catalyst eactivation of Spent R Oxide, etc. R
M:+919920124240/+919130062553/+917020265327
CrossCoupling CatalystligandslikeTTeetrakis(TPP)Bis(TPP)DBA DPPF / info@omkarlab.com
omkarlab@gmail.com / omkarlab15@gmail.com r. Email: jigar

ACRYLAMIDE
ACRYLAMIDE l MDC
CAUSTIC FLAKES
FORMIC ACID 85%
POTAASH FLAKES
PHOSPHORIC ACID 85%
V.PHARMACHEM
+91
Email: vpharmachem@yahoo.com
l 6-BA (6-Benzyl Adenine)
l Ammino Acid 80% Soya Base
l Atonik (Sodium Nitro Phenolate 98% T.C)
l Bronopol (2-Bromo-2Nitro-1,3-Propanediol)
l Citric Acid Mono
l DA6 (Diethyiamino Ethyl Hexanoate 98%)
l Dimethylformamide (D.M.F)
l Fulvic Acid 50%
l Indole 3 Acetic Acid
l Indole 3 Butyric Acid
l Lactose 200 Mesh
l L-cystine Hydrochloride Monohydrate
l L-Glutamic Acid
l Mono Sodium Glutamate
l NAA (Naphthalene Acetic Acid)
l NATCA (N-Acetyl-4Thiozolidine Caroxilic Acid)
l Nitrobenzene
l Nitrobenzene Emuilsifier Powder
l Polysorbate – 80
l Potasium Humate Flakes
l Seaweed Extract Powder
l Silicon Super Spreader T.C
l Uracil 98%
l Vitamin B9 (Folic Acid)
l Vitamin C Plain (Ascorbic Acid )
THE MAZADA PHARMA GUIDE 155
Add: B-402, Aman Akansha building, Dainik Shivner Marg, Gandhi Nagar, Worli, Mumbai 400018 Tel:
9820488537 / 022- 35751042
l Web:
www.vpharmachem.com
PRODUCT LIST: HYDROGEN PEROXIDE 50% ACETIC ACID 99%
CHEMICALS & SOLVENTS
l MDC
FORMIC ACID 85%
PHOSPHORIC ACID
GLYCERINE 99.5
D Dealers
HYDROGEN P YE CHEM Chemicals
EROXIDE 50% 3 . RAKESH SANGHVI | MOB: +91-92234 3261 Office: Unit No. 303, Gala Complex Premises Co., Op. Housing Society Ltd., DDU Marg, Mulund (W), Mumbai-400 080, Maharashtra, Inida. Phone: (0) 7208114530 l Email: ranjadyechem@gmail.com MR ACETIC
L CHEMICALS
CAUSTIC SODA FLAKES
COUSTIC POTASH FLAKES
85%
RAJAN
& Suppliers :
& Solvents
ACID 99%
T
COUSTIC
GLLY
YCERINE
PHARMA DPCO
S.O. 3722 (E) In exercise of the powers conferred by paragraphs 4, 6, 10, 11, 14, 15, 16, 17 and 18 of the Drugs (Prices Control) Order, 2013, read with S.O. 1394(E) dated the 30th May, 2013 and S.O. 701(E) dated 10th March, 2016 issued by the Government of India in the Ministry of Chemicals and Fertilizers, the National Pharmaceutical Pricing Authority (hereinafter referred as NPPA) hereby fixes the prices as specified in column (5) of the table herein below as ceiling price exclusive of goods and services tax applicable, if any, in respect of the Scheduled formulations specified in the corresponding entry in column (2) of the said Table with the dosage form & strength and unit specified respectively in the corresponding entries in columns (3) and (4) thereof:
Note:
(a) All manufacturers of scheduled formulations, selling the branded or generic or both the versions of scheduled formulations at a price higher than the ceiling price (plus goods and services tax as applicable) so fixed and notified by the Government, shall revise the prices of all such formulations downward not exceeding the ceiling price specified in column (5) in the above table plus goods and services tax as applicable, if any.
(b) All the existing manufacturers of above mentioned scheduled formulations having MRP lower than the ceiling price specified in column (5) in the above table plus goods and services tax as applicable, if any, shall continue to maintain the existing MRP in accordance with paragraph 13 (2) of the DPCO, 2013.
(c) The manufacturers may add goods and services tax only if they have paid actually or if it is
payable to the Government on the ceiling price mentioned in column (5) of the above said table.
(d) The ceiling price for a pack of the scheduled formulation shall be arrived at by the concerned manufacturer in accordance with the ceiling price specified in column (5) of the above table as per provisions contained in paragraph 11 of the Drugs (Prices Control) Order, 2013. The manufacturer shall issue a price list in Form–V from date of Notification as per paragraph 24 of the DPCO, 2013 to NPPA through IPDMS and submit a copy to State Drug Controller and dealers.
(e) As per para 24(4) of DPCO 2013, every retailer and dealer shall display price list and the supplementary price list, if any, as furnished by the manufacturer, on a conspicuous part of the premises where he carries on business in a manner so as to be easily accessible to
any person wishing to consult the same.
(f) Where an existing manufacturer of scheduled formulation with dosage or strength or both as specified in the above table launches a new drug as per paragraph 2 (u) of the DPCO, 2013 such existing manufacturer shall apply for prior price approval of such new drug to the NPPA in Form I as specified under Schedule-II of the DPCO, 2013.
(g) The manufacturers of above said scheduled formulations shall furnish quarterly return to the NPPA, in respect of production / import and sale of scheduled formulations in FormIII of Schedule-II of the DPCO, 2013 through IPDMS. Any manufacturer intending to discontinue production of above said scheduled formulation shall furnish information to the NPPA, in respect of discontinuation of production and / or import of scheduled formulation in Form-
IV of Schedule-II of the DPCO, 2013 at least six months prior to the intended date of discontinuation.
(h) The manufacturers not complying with the ceiling price and notes specified hereinabove shall be liable to deposit the overcharged amount along with interest thereon under the provisions of the Drugs (Prices Control) Order, 2013 read with Essential Commodities Act, 1955.
(i) Consequent to the issue of ceiling price of such formulation as specified in column (2) of the above table in this notification, the price order(s) fixing ceiling or retail price, if any, issued prior to the above said date of notification, stand(s) superseded.
PN/182/50/2017/F F. No. 8(50)/2017/D.P./NPPA-Div.-II
(BALJIT SINGH) Assistant Director
156 THE MAZADA PHARMA GUIDE
Sl. Name of the Strength Unit Ceiling No.Scheduled FormulationPrice (Rs.) 1. Oxaliplatin Injection 100mg (as licensed) Each Pack 4055.10 2. Acetylsalicylic acid Effervescent/ Dispersible/1 Tablet 0.1625 Enteric coated Tablet 100 mg 3. Japanese Encephalitis Vaccine 4mcg to 6mcg Each Pack 632.95 4. Japanese Encephalitis Vaccine up to 3mcg Each Pack 482.22 5. Measles Rubbela Vaccine Each Pack (0.5ml)80.22 6. Surfactant Suspension for intratracheal Per mg of Phospholipids 60.69 instillation (As liensed)in the pack For product list: Please visit us on www.adityamint.com Email: info@adityamint.com / adityamint07@gmail.com Contact: +91 8788521585 / 9970313727 / 9320208033 ADITYA MINT Address: F 63,First floor, The Zone Mall, Chandavarkar Road, Borivali West, Mumbai 400092. Factory: Dewa, Barabanki, U ar Pradesh. MENTHOL, THYMOL, CAMPHOR Lemongrass oil, Benzyl alcohol Essen al Oils, Herbal Oils, Carrier Oils and Fragrances
PHARMA DPCO
ORDER
S. O. 3723(E) In exercise of the powers conferred by paragraphs 4, 6, 10, 11, 14, 16, 17 and 18 of the Drugs (Prices Control) Order, 2013, read with S.O. 1394(E) dated the 30th May, 2013 and S.O. 701(E) dated 10th March, 2016 issued by the Government of India in the Ministry of Chemicals and Fertilizers, and in supersession of the Order of the Government of India in the Ministry of Chemicals and Fertilizers (National Pharmaceutical Pricing Authority) No. SO 2060(E) & S.O. 2061(E) dated 30th June, 2017 respectively in so far as it relates to formulation packs mentioned in the table below, except in respect of things done or omitted to be done before such supersession, the National Pharmaceutical Pricing Authority, hereby fixes the price as specified in column (5) of the table herein below as ceiling price exclusive of goods and services tax applicable, if any in respect of the Scheduled formulations specified in the corresponding entry in column (2) of the said Table with the dosage from & strength and unit specified respectively in the corresponding entries in columns (3) and (4) thereof:
Note:
(a) All manufacturers of scheduled formulations, selling the branded or generic or both the versions of scheduled formulations at a price higher than the ceiling price (plus goods and services tax as applicable) so fixed and notified by the Government, shall revise the prices of all such formulations downward not exceeding the ceiling price specified in column (5) in the above table plus goods and services tax as applicable, if any.
(b) All the existing manufacturers of above mentioned scheduled formulations having MRP lower than the ceiling price specified in column (5) in the above table plus goods and services tax as applicable, if any, shall continue to maintain the existing MRP in accordance with paragraph 13 (2) of the DPCO, 2013.
(c) The manufacturers may add goods and services tax only if they have
paid actually or if it is payable to the Government on the ceiling price mentioned in column (5) of the above said table.
(d) The ceiling price for a pack of the scheduled formulation shall be arrived at by the concerned manufacturer in accordance with the ceiling price specified in column (5) of the above table as per provisions contained in paragraph 11 of the Drugs (Prices Control) Order, 2013. The manufacturer shall issue a price list in Form–V from date of Notification as per paragraph 24 of the DPCO, 2013 to NPPA through IPDMS and submit a copy to State Drug Controller and dealers.
(e) As per para 24(4) of DPCO 2013, every retailer and dealer shall display price list and the supplementary price list, if any, as furnished by the manufacturer, on a conspicuous part of the premises where he carries on business in a manner so as to be
easily accessible to any person wishing to consult the same.
(f) Where an existing manufacturer of scheduled formulation with dosage or strength or both as specified in the above table launches a new drug as per paragraph 2 (u) of the DPCO, 2013 such existing manufacturer shall apply for prior price approval of such new drug to the NPPA in Form I as specified under Schedule-II of the DPCO, 2013.
(g) The manufacturers of above said scheduled formulations shall furnish quarterly return to the NPPA, in respect of production / import and sale of scheduled formulations in Form-III of Schedule-II of the DPCO, 2013 through IPDMS. Any manufacturer intending to discontinue production of above said scheduled formulation shall furnish information to the NPPA, in respect of discontinuation of production and /
Amizara Chemicals
Dealers in Chemicals & Solvent
l Ace c acid
l Adipic acid
l Acrylic acid
l Benzyl alcohol
l Chloroform
l Di propylene ghcol (DPG )
l Ethyl acetate
l Epichlorohytrine
l Epoxy resine
l Glycerine
l Hydrazine hydrate
l Iso propyl alcohol.
l Methylene chloride (MDC)
l Methane Sulphonic Acid(MSA)
l Hexamine
l Melamine
l Cyclohexanone
l MIBK
l EDA / DETA / TETA / TEPA
l Methyl ethl ketone (MEK )
l Triethanolamine 85% & 99 5
l Toluene
l Morpholine
l Bisphenol A
l Normal butanol (NBA)
l Perchloroethylene (PCE)
l Phosphoric acid
l Proplyene Glycol (PG)
l Sodium Metal
l Sodium Gluconate
or import of scheduled formulation in Form-IV of Schedule-II of the DPCO, 2013 at least six months prior to the intended date of discontinuation.
(h) The manufacturers not complying with the ceiling price and notes specified hereinabove shall be liable to deposit the overcharged amount along with interest thereon under the provisions of the Drugs (Prices Control) Order, 2013 read with Essential Commodities Act, 1955.
(i) Consequent to the issue of ceiling prices of such formulations as specified in column (2) of the above table in this notification, the price order(s) fixing ceiling or retail price, if any, issued prior to the above said date of notification, stand(s) superseded.
PN/182/50/2017/F F. No. 8(50)/2017/D.P./NPPA-Div.-II (BALJIT SINGH) Assistant Director
l Maleic Anhy
l ISO Phthalic
l Thiourea / Urea
l DMSO
l Diethanolamine
l Paraformaldehyde Acetonimie
l Acetonitrile
l Triethylamine
l THF
A-207 , Kedarnath CHS Ltd, Sudama Nagar, 60 Feet Road, Bhayander (W), Thane – 401 101 Mob: 9221044646 l O ce: 9702344646 l Email: amizarachemicals@gmail.com l Web: www.amizarachemicals.com
THE MAZADA PHARMA GUIDE 157
Sl. Name of the Strength Unit Ceiling No.Scheduled FormulationPrice (Rs.) 1. Sevoflurane Inhalation 1 ml 24.12 2. Acetylsalicylic acid Tablet 325mg 1 Tablet 0.50 3. Desferrioxamine Powder for Injection 500mg Each pack 145.91 4. Oxaliplatin Injection 50mg (as licensed)Each Pack 2303.01 5. Phytomenadione (Vitamin K1)Injection 10mg/ml 1 ML 43.45 6. Glutaraldehyde Solution 2% 1 ML 0.05868 7. Anti-D immunoglobulin Injection 300mcg Each Pack 1936.82 8. BCG vaccine Each Dose 4.32
Product

Ghanshyam Enclave, Laljipada, New Link Road, Kandivali (West), Mumbai- 400
Phone No.: 022 28680033 / 28680044
Contact Person Name: Mr. Alpesh Naik l Mobile: 9820952289 Email: alpesh@mkchemiepharmie.com l sales@mkchemiepharmie.com

158 THE MAZADA PHARMA GUIDE
615,
067
2-Methyl Resorcinol 99% (White Powder)


THE MAZADA PHARMA GUIDE 159
Pla

SKY CHEM
808/809, Ajitnath CHS Ltd., Neelkanth Enclave, LBS Marg, Opp. Shreyas Cinema, Ghatkopar West, Mumbai
Tel: 9820330512;9819765791l Email: ajaibros@gmail.com
Silver Diethyl Dithio
Rhodium Trichloride
Rhodium
Rhodium
Tetrakis (triphenylphosphine) palladium (O)
Bis (triphenylphosphine) palladium (II)
Iridium
Indium
Indium
Indium
Indium Oxide
Indium Sulphate
160 THE MAZADA PHARMA GUIDE
PRODUCT HSN CODE Ammonium Chloropla nate 28439000 Gold Chloride 12.5 % 28433000 Gold Chloride 25 % 28433000 Gold Chloride 50 % 28433000 Palladium powder 71102100
5% on Charcoal 38151210
5% on Asbestos 38151290
5% on Barium Sulphate 38151290
5% on Alumina 38151290
5% on Calcium Carbonate 38151290 Palladium 10% on Charcoal 38151210 Palladium 10% on Asbestos 38151290 Palladium 10% on Barium Sulphate 38151290 Palladium 10% on Alumina 38151290 Palladium 0.5% on Alumina Balls 38151290 Palladium 10% on Calcium Carbonate 38151900 Palladium Acetate 28439019 Palladium Bromide 28439019 Palladium Chloride 28439019 Palladium Nitrate 28439090 Palladium Oxide 28259090 Palladium Sulphate 28439019 5% Pla num on Charcoal 38151210 10% Pla num on Charcoal 38151210 Pla num Black powder 71101120 Pla num Chloride 40% Pt 28439019
Palladium
Palladium
Palladium
Palladium
Palladium
num Oxide Adams Catalyst (Hydrated) 28259090
Chloropla nate 28439019
Iodopla nate 28439019
28439019 PRODUCT HSN CODE Pla nous
28439090
Potassium
Potassium
Potassium Tetrachloropla nate
Chloride
71061000
28432900
28432900
28369990
28273990
28415090
Silver Powder (Approx. 200 mesh size)
Silver Acetate
Silver Bromide
Silver Carbonate
Silver Chloride
Silver Chromate
Carbonate 29302000
Iodide 28432900
Iodate 28299030
Nitrate LR
AR 28432100
Nitrite 28341090
Oxide 28259090
Sulphate LR 28432900
Sulphate AR 28432900
Sulphide 28309010
Nitrate
28439019
Silver
Silver
Silver
/
Silver
Silver
Silver
Silver
Silver
Silver
S cks
28439019
Ruthenium Trichloride
38220000
Ruthenium Red
28439019
5% on Alumina 38151200
5% on Carbon 71022990
28439019
28439019
28439019
Trichloride
81129200
Metal Ingots
28273990
Chloride
28342990
Nitrate
28259090
28332990
400 086.















304, 3rd Floo Mah or Head Office : EMCO r, , Western Edge -1, Western Ex harashtra, India. | Mob. : +91 98 inf y . L T ENGINEERING PV T. LTTD. press Highway, , Borivali (East) 206 84319 | Email : foo@airje


, Mumbai - 400066, etmill.com


THE MAZADA PHARMA GUIDE 161 R V OT R DRYER ACUUM
DOUBLE ARY A DRYER Y TR ACCUUMED A V
CONE
TORS REAC
501, Sanjar Enclave, Above Mahindra Showroom, Opp. Milap PVR, S. V. Road, Kandivli (W), Mumbai - 67. Tel: +91 22 4011 3538, 2865 1412, 4005 8604 | Email: sohyoglifesciences@gmail.com Dhruvil Parekh : +91 99304 61006, +91 9372073783
Product List
m ALPHA LIPOIC ACID USP
m m ASCORBIC ACID IP
m AZITHROMYCIN
m BIOTIN USP
m CLINDAMYCIN PHOSPHATE
m m DOXYCYCLINE HYCLATE IP
m m FENBENDAZOLE VET BP
m m LEVAMISOLE IP
m m METHYLPREDNISOLONE IP
m m NIACINAMIDE
m m PARACETAMOL IP
m m SODIUM ASCORBATE
m m SUCRALOSE
AUTHORISEDDEALER

27/29,Popatwadi,Kalbadevi,Mumbai-400002Tel/Fax:0091-22-22013581,22032275,22017040 Email:bjscientific@yahoo.com/Email:bjscientific@gmail.comWeb:www.bjscientific.com

HANNA




AXIVA SARTORIUS PALL

JAYANT TECHNOLAB SHANTI PILOT

OvenIncubatorFurnace


&SyringeFilters

VOLEX SONAR
FilterPapers,Plasticwares, MicrolitrePipettes,Tips



ELTEK EMTEK
MagneticStirrers





FilterPapers, MembrameFilterPapers, TestSieves&SieveShakers
LaboratoryGlasswares, Tubings,Rods,Microlitre Pipettes,BottleTopDispensers pH,ION,TDS,ConductivityMeters


BRAND EPPENDORF


LOVIBOND AQUALYTIC HACH
Comparators,CellsTurbidity/ Photometers

Anemometer, Ammemeter, SoundLevel Meter, LuxMeter, Digital Multimeter, TongTestersetc.

162 THE MAZADA PHARMA GUIDE
B.J.SCIENTIFICCO.
ATRUSTEDNAMEINLABORATORYGLASSWARE&SCIENTIFICINSTRUMENTS
DigitalViscometers
MechanicalAnalyticalBalances
BladeBushes,Beakers, MagneticNeedles Autoclave.ColonyCounteretc. TEMPO KUMAR PATHAK METALAB SHANTI METTLER SARTORIUS SHIMADZU WENSAR ACZET CONTECH EUTECH
BROOKFIELD FUNGILAB
MembraneFilterPapers
pHMeter,ConductivityMeter Tubings,Rods,Crucibles, Plates,Beakersetc.
REAGECON HAMILTON
TARSONS
POLYLAB ABDOS KASABLANKA
AXIVA
REMI
MERCK
HAMILTON
WHATMAN
MITUTOYO
DHONA
QUARTZ
TEFLON PTFE
AGILENT SGE
JAPAN
TAPSONS
SILICA SUPERFIT
ORION HACH TOSHNIWAL SYSTRONICS ELICO EI JRM ZEAL LEIMCO Plasticware PALL SARTORIUS MILLIPORE AXIVA EQUITRON METALAB Crucibles,Basins, Wires&Basket PLATINUM ElectronicBalance, Spectrophotometer RotaryEvaporators, TLCKitsetc. VernierCalipers, Gaugesetc. MicroliterSyringes Thermometers,Calibration CertificateforISO DigitalBurettes, MicroPipettes. LabStirrers,Centrifuges,
LUTRON FLUKE MECO
WE DEAL IN ALL KINDS OF API'S AND CAN MATCH CUSTOMERS REQUIREMENTS WITH COMPETITIVE PRICES
EUTECH
StandardBufferSolutions
















THE MAZADA PHARMA GUIDE 163

164 THE MAZADA PHARMA GUIDE Dev Pharmaceuticals IMPORTERS & DEALERS IN PHARMACEUTICAL RAW MATERIALS Ready Stock AZITHROMYCIN IP HYDROCHLOROTHIAZIDE IP – IPCA CYANOCOBALAMIN IP (VITAMIN B12) Shop No. 8, Gr. Floor, Shree Naman Plaza, Behind Namaha Hospital, S. V. Road, Kandivali- West, Mumbai – 400067. Tel: 022 40140356 l E-mail: devpharma@ymail.com Collodiol Flexible (Passing / Confirming / BP / USP / IP) Manufacturer of Chemical House, LBS Marg, Gokulnagar, Thane (W)-400601 Tel: +91 9223433889 | Email: infoglobeproducts@gmail.com GLOBE PRODUCTS Contact: SANGRAM INDUSTRIES Dist: Nashik, Maharashtra. Mob: 9324020888, 9322272080 Email: info.sangramindustries@gmail.com Your Requirement Of: • SALICYLIC ACID • SODIUM SALICYLATE METHYL SALICYLATE • SALICYLALDEHYDE 2-ETHOXY BENZOIC ACID Mr. Bhavin Patel 8469140555 chemlinkso @gmail.com IMPORT \ EXPORT DATA Any Chapter Rs.500 per month CHEMLINK SOFTWARE MUMBAI
NEHA PHARMA PVT. LTD.
(Since 1988)
Address: C/ 7, Yatin Mansion, Kalbadevi Road, Kalbadevi, Mumbai - 400002
Tel: +91 9930933530 l Mob: +91 9930933662 l Email: pratik.gandhi@nehapharma.com
v TRIPROLIDINE HCL
v SELEGILINE HCL
v MEFENAMIC ACID
v SODIUM LACTATE USP 60% SOLUTION
v LACTIC ACID
v COD LIVER OIL BP
v FISH LIPID OIL BP
v PITOFENONE HCL
v FENPIVIRIUM BROMIDE
Narcotics / Psychotropic Substances
v PSEUDOEPHEDRINE HCL
v EPHEDRINE HCL
v ALPRAZOLAM
v DIAZEPAM
v BUPRENORPHINE HCL
v TRAMADOL HCL
v PHENOBARBITAL BASE / SODIUM
v MEPROBAMATE

THE MAZADA PHARMA GUIDE 165

2, Geet Krishna, Navghar Road, Mulund - East, Mumbai - 81
Phone: 8425031410 / 9769681471
Email: ganesh@chemicalmatrix.co.in
Website: http://chemicalmatrix.co.in
PRODUCTS : APIS AND IMPURITIES
Anti Viral
Lipid Lowering Agent
Erectile Dysfunction
Psychostimulant
Anti Coagulants
Anti Asthmatic
Anti Inflammatory
CNS Drugs
Analgesic
Oncology
Anti Ulcer
Anti Epileptic
Dyslipidaemic
Arthritic
Anti Histamine
Anti Fungal




Laxatives / Pregnancy
Antiobsessional Drug
Anti-Gout
Antidepressant
Anti-Biotic
Antiulceratives
Veterinary Product
Anti Chloinergic
Antimalarials
Anti Retroviral
Anti Osteoporosis
Antidiabetic
Anti Emitic
Anti Parkinson
Nootropic
PRODUCT LIST
l Thioglycolic Acid 80%,99%
l 3-Mercaptopropionic Acid 99%
l Potassium Thioglycolate
l Monoethanolamine Thioglycolate
l Diammonium Dithiodiglycolate
l Pentaerythritol 3-Mercaptopropionate
l POLYTHIOLS
l Monothioglycerol 90,98,NF
l Thiodipropionic Acid
l 2-Sulfoethyl Methacrylate
l An oxidant for Polymers
l Ditridecyl Thiodipropionate
l Distearyl Thiodipropionate
l Dilauryl Thiodipropionate
166 THE MAZADA PHARMA GUIDE Mob.: 07498166675 / 08291142569 Email: swanenterprise@gmail.com For best prices, please contact: S S WAN ENNTE E RPRRISSE E
THE MAZADA PHARMA GUIDE 167
ARK CHEMICALS PRIVATE LIMITED
WACKER METROARK CHEMICALS P. LTD/ WACKER CHEMIE AG
Silicones:
1. Silicone Fluids – 10 Ctsk To 10 Lakh Ctsk
2. Geniosil Vinyl Silanes & Genioplast Polymer Addi ves
3. Silicone Greases
4. Silicone For Car Care & Personal Care
Silicone Defoamers/An foams For: 1. Paper And Pulp Industry (Pulpsil Series)
2. Low Foaming We ng Agent (Silfoam Series)
3. Etp And Other Low End Applica ons
4. Metal Working Industry
5. Powder And Liquid Defoamer For Detergent Industry
6. Tex le Applica on
7. Powder And Liquid Defoamer For Agro Industry
Silicone Emulsions:
1. Tyre And Dash Board Polish
2. Mould Release
A) For Rubber Footwear
B) For Eva Footwear
C) For Polyurethane Release
D) Alumininum Dia Cas ng Release
Paints, Coa ng & Construc on:
1. Silicone Resin For Heat Resistant Paints
2. Slip& Mar Addi ve For Solvent Based Paints
3. Hammertone Addi ve For Solvent Based Paints
4. Silicone Addi ve To Make Paints Water Repellent
5. Silicone Binder For Water Based Paints
6. Silicone Based Water Repellents For Natural Stones
7. Powder Based Silicone Water Repellents For Wall Pu y
CHEMIE INDIA PVT LTD. Polymer Dispersions For Adhesives
Binder For Lamina on Adhesives / Wood Adhesives
Binder For Paper Adhesives / Wood Adhesives
Binder For Wood Adhesives / Pvc To Mdf
Binder For Membrane Press Adhesives
CHEMICALS PVT.LTD.
Phosphonates
Polymers
OTHER PRODUCTS
(INDIA) LTD
Lauryl Alcohols
Cetyl Alcohols
Ceto Stearyl Alcohol (30:70/50:50/70:30)
Stearyl Alcohols
Ldma (For Manufacturing BKC)
Glycerine
Glycerine USP/BP/IP/CP/EP
Glycerine Ethoxylates

CLARIANT IGL SPECIALTY CHEMICALS PVT LTD
Ethoxylates
1. Nonyl Phenol Ethoxylates
2. Octyl Phenol Ethoxylates
3. Styrenated Phenol Ethoxylates
4. Tridecyl Alcohol Ethoxylates
5. Cetostearyl Alcohol Ethoxylates
6. Cetyl Alcohol Ethoxylates
7. Castor Oil Ethoxylates
8. Polyethylene Glycols
9. Oleyl Amine Ethoxylates
FUMED SILICA
A. Hydrophilic
1. Wacker HDK® N20
2. Wacker HDK® V15
B. Hydrophobic
1. Wacker HDK® H17
2. Wacker HDK® H18
3. Wacker HDK® H13L
4. Wacker HDK® H15
5. Wacker HDK® H2000

168 THE MAZADA PHARMA GUIDE CONTACT DETAILS: Mr.Anmol Wadhwa: Mobile No. 9819592146 Mail Id : anmol@arkchemicals.in
Agro Industry: 1. Silicone Spreader 2. Emulsifiers WACKER
1.
2.
4.
AQUAPHARM
2.
3.
1.
1.
2.
VVF
1.
2.
3.
4.
5.
Sles 28% & 70%
Perfume Solubilizer

















THE MAZADA PHARMA GUIDE 169
INdIAN PlATiNUM PVT. LTd.
Manufacturing & Exporting Superior Quality Prevous Metal Chemicals, Compounds of Rhodium, Gold, Silver, Palladium, Platinum, Iridium, Osmium, Ruthenium, Indium, Bismuth, Molybdenum Etc.
Silver Chemicals
SILVER
Silver Bars
Silver Nanoparticles
Silver Carbonate
Silver Acetate
Silver Chloride
Silver Chromate
Silver Oxide
Silver Sulphate
Silver Triflate
Silver Lactate
Silver Sufadiazine
Silver Trifluroacetic Acid
Silver Nitrite
Silver Nitrate AR / LR
Silver Sulfate
Silver Nitrate Crystal
Silver Iodide
Silver Bromide
Silver Iodate
Indium Compounds
l Indium Sulphate
l Indium Chloride
l Indium Phosphate
l Indium Nitrate
l Indium Oxide
Cerium Salts / Cerium Chloride / Lanthanum Salts
l Ammonium Cerium Sulphate
l Ammonium Cerium Nitrate
l Cerium Acetate
l Cerium Sulphate
l Cerium Hydrate
l Cerium Sulfate Hydrate
l Cerium Oxide
l Lanthanum Nitrate
l Lanthanum Chloride
l Lanthanum Phosphate
Bismuth Salts Compounds
l Bismuth Nitrate
l Bismuth Oxychloride
l Bismuth Carbonate
l Bismuth Citrate
l Sodium Bismuthate AR/LR
l Bismuth Sulphite
l Bismuth Subsalicylate
l Bismuth Oxide
Industrial Chemicals
l Styphnic Acid
l Phenyl Mercuric Acetate
l Peracetic Acid
l Lead Acetate
l Methyl Pyruvate
l Phosphotungstic Acid
l Acid Fuchsin
l Hexachloro Patinic Acid
l Picric Acid
l Resorcinol
l Lead Nitrate
l 5 Sulphosalicylic Acid
l Ethyl Pyruvate
l Pyruvic Acid
l Sodium Molybdate
l Sodium Tungstate
l Ammonium Molybdate
l Phosphomolybdic Acid
l Sodium Pyruvate
l Raney Nickel
Metal Powders
l Silver Metal Powder
l Moly Trioxide
l Gold Metal Powder
l Platinum Metal
l Rhodium Metal Powder
l Copper Metal Powder
Copper Salts
l Copper Sulphate
l Copper Nitrate
l Copper Acetate
l Copper Citrate
Regd. Off.: Unit No 103, Liberty, Sarojini Naidu Road, Vile Parle West, Mumbai - 400056 Tel: 9322395199, 26171279 Mob: 98920 63766 Email: indianplatinum@gmail.com Web: www.palladiumchemicals.com
170 THE MAZADA PHARMA GUIDE
ADVERTISERS INDEX
90 Elementos Pvt. Ltd.104Mumbai
AbhinandanSolvchem69Mumbai
Advance In Organics LLP128New Delhi
Aaditya Pharmachem29Mumbai
Aara Pharma150Mumbai
AD Pharmachem Pvt Ltd30 Aurangabad
Aditi Essentials51Mumbai Aditya Mint156Mumbai
AGR Enterprises43Mumbai
Ajmera Pharmasure Ltd.15Mumbai
Allmpus laboratory Pvt Ltd 151Thane American Enterprise120Mumbai
Avant Freight Systems Pvt. Ltd.61Mumbai Amit Hydrocolloids53Mumbai
Amita Chemicals102Mumbai Amizara Chemicals157Thane Amnem Back Inside Mumbai
Amrys IPR Services136Mumbai
Anshul Speciality Molecules144Mumbai
Apra Innovative Pvt. Ltd.19Mumbai
Arihant Enterprises81Mumbai
Arjun Beeswax Industries 169Vadodara
Arco Pharma126/164 Ahmedabad
ARK Chemical Pvt. Ltd.168Mumbai
Aril Pharmaceuticals06-07Mumbai
Arnish Laborates Pvt. Ltd.103Mumbai
AVI Scientific35Mumbai
Asia Labex - Bangladesh 52Dhaka
Asia Labex Gandhinagar 60Gujarat
Ashapura Intermediates119Vadodara
Ashwini Industries139Jalgaon
Asiel Chemipharma35Mumbai
Aster Biopharma LLP12Mumbai
Ayon Pharmachem168Mumbai
Azeocryst Organics Pvt. Ltd.75Mumbai
B.J. Scientific Co.162Mumbai
B.Pankaj & Co.84Mumbai
B. Shah & Sons 147 Mumbai
Balaji Corporation97Vadodara
Balaji Steroids and Hormones Pvt. Ltd. BackInside Flap MP
Bakul Aromatics And Chemicals103Mumbai
Biotech Solutions & Pharmaceuticals Ltd Front Inside Cover Mumbai Bombay Engineering Works148Mumbai
Bronze Chem Enterprise106Mumbai
Bombay Test House Pvt. Ltd.93 Navi Mumbai
CSV Pharmaceuticals India Pvt. Ltd. 137Noida Chemaroma Drug House 91Mumbai
Calyx Chemical & Pharmaceuticals23Navi Mumbai Chemical Matrix166Mumbai
Chemino Pharma Ltd94Mumbai
Chemizo Enterprises Ear Panel/166 Ahmedabad Chemkart163Mumbai Chemiman72Mumbai
Chemlink Software164Mumbai Chemstar Global Products LLP68Mumbai Cosmic Chemicals100Mumbai CR Pharma108Mumbai
Chroma Chemical Corporation106Mumbai Crystal Pharma76Mumbai
Dazzle Corporation88Mumbai
D M Pharma22Chennai
DPB Pharmaceuticals Ltd.Ear PanelMumbai Dev International158Gujarat Dev Pharmaceuticals164Mumbai Dhru Enterprises89Mumbai
Dipti Chemicals And Pharmaceuticals 37 Mira Road
Earth Chemical & Scientific Pvt. Ltd. 118Mumbai
Eewa Engineering Co. Pvt. Ltd. 11 Ahmedabad
Elite Chemicals89Gujarat
Enzyme Bioscience57Gujarat
Emco Engineering Pvt. Ltd.161Mumbai
Eklavya Biotech Pvt. Ltd.108Mumbai
Eskay Iodine Pvt. Ltd.04Mumbai
Espee Pharma Chem Pvt. Ltd.94 Ahmedabad
Filtromix Equipments LLP149Mumbai
Filtra Tech Solutions India Pvt. Ltd. 159Thane
Flora Dye Chem124Mumbai
GBL Chemicals Limited73Mumbai
G. M. Chemie Pvt. Ltd.143 Navi Mumbai
Gandhi Chemicals126Mumbai
Gauri Acids148Mumbai
Gnanlex Associates LLP169Mumbai
Gangotri Inorganic (P) Ltd.18 Ahmedabad
Global Merchants25 Navi Mumbai
Globe Products164Thane
H K Enterprise151Mumbai
HK Group76Mumbai
Hap Enterprise67Mumbai
Heni Drugs Pvt. Ltd. 49Thane
Helix Multichem121Mumbai
Hritik Chemicals Pvt. Ltd.99Mumbai
Ishwar Chemicals and Gases72Jalgaon
Indian Platinum Pvt. Ltd. Ear Panel/170 Mumbai
International Drug & Che.Co.165Mumbai
Iris Ingredients Front Flap Mumbai Jakson Pharma104Mumbai
Jay Chem Marketing126Mumbai
Jayant Agro-Organics Limited146Mumbai
Jaysum Biotech77Thane
Jyoti Global Plast Pvt. Ltd.30Mumbai
Jiya Pharmachem98Mumbai
JPC Air Handlers Engineering10Gujarat
Juana Pharma149Mumbai
J R Drugchem Pvt. Ltd. Back Inside Gujarat KMED International137Delhi
K. Sevantilal & Co. Back Cover Mumbai
Kailash Marketing Associates148Mumbai
Kamakhya Impex Front Inside Flap UP Kahan Pharmaceuticals08Vasai Kamlesh Enterprise96Mumbai Kanchan Rasayan34Mumbai Kems Raw Pharma85Mumbai Keshariya Corporation80 Mira Road Keshav Hichem Pvt. LTd.21Mumbai Kesar Control Systems 49 Ahmedabad Ketan Chemical Corporation119Mumbai Khushbu Dye Chem Pvt. Ltd.79Mumbai Khushboo Scientific 13Mumbai KIP Chemicals Pvt. Ltd.81Mumbai Kiran Traders42Mumbai Kronox Lab Sciences Limited218Gujarat Labh Ingredients 152Mumbai Laboratory Solutions India41Mumbai Luconic Chemicals103Mumbai M/s. Alba Organics91Palghar Maharshee Laboratories Pvt. Ltd.133Gujarat Mahaveer Chemicals Ear Panel Thane Malay Enterprise 167Vadodara Maruti Industries24Gujarat Maruti Pharma Chem84Mumbai Maruti Petrochem55Mumbai Medi Pharma Drug House27Mumbai Medisearch Lab( Bom) Pvt. Ltd. 94Mumbai Mehta Associates84Mumbai
Company name Pg NoCITY Company name Pg NoCITY THE MAZADA PHARMA GUIDE 171
ADVERTISERS INDEX
Company name Pg NoCITY Company name Pg NoCITY
Mehtech Engineering Pvt. Ltd.134Palghar
Memba Chem Industries Pvt. Ltd. 98Mumbai
Meru Chem Pvt. Ltd.96Mumbai
Mivon Chemicals28Thane
MK Chemie Pharmie158Mumbai
Modern Dairies Ltd.39 Chandigarh
Mody Chemi Pharma Pvt. Ltd. 47Mumbai
Naksha Pharma Nutraceutical Pvt. Ltd. 139Mumbai
Nalanda Research Laboratories106 Navi Mumbai
Nandlal Bankatlal Pvt. Ltd. Front Cover Mumbai
NDC Drug & Chemical Co.Pvt.Ltd. 154Mumbai Neha Enterprises121Mumbai
Neha Pharma Pvt. Ltd.165Mumbai
Nikeon Corporation 80 Mumbai
Nira Life Sciences Pvt. Ltd.25Gujarat
Nisha Chemicals71Mumbai
Nitco Watertech and Industrial Concepts 124Thane
Ngl Fine Chem Ltd. 105Mumbai
Noble Chemical Agency 102 Telangana
North India Pharma92Delhi
Nova Chemiie24Mumbai
Oceanic Laboratories Pvt. Ltd44Boisar
Om Laboratories26 Ahmedabad
Om Pharmaceutical Industries153 Palghar
Om Pharmachem Pvt. Ltd.81Thane
Om Pharma Chem48Mumbai
Omkar Lab155Vasai
Orex Pharma Pvt. Ltd.25Thane
Oxford Laboratory Chemicals140Palghar
P. G. Shah & Co.72Mumbai
Pacific Biochem Pvt. Ltd. 74Thane
Pacific Organics Pvt Limited16Thane
Panchamrut Chemicals154Mumbai
Panchsheel Organics Limited83Mumbai
Paras Chem (India)166Mumbai
Paresh Chemical Corporation78Mumbai
Parshwa Pharma Chem Pvt. Ltd.40Thane
Pari Chemicals135Mumbai
Payal Impex137Palghar
Padmavati Pharmachem 5Mumbai
Pharma Pro & Pack Expo 58Hyderabad
Pharmalabchem Expo54Pune
Pharma Machinery & Lab Equ.-Vadodara 64Gujarat
Pharma Machinery & Lab Equ.-Haridwar 62 Uttarakhand PharmaCupboard82Gujarat
Pharmazwinger Technologies159Thane
Pharma India Expo 66Hyderabad Pooja Enterprise98Mumbai
Powder Pack Chem127Mumbai
Pravina Pharma Chem Products 150Gujarat
Pravinchandra & Co.33Mumbai
Pramukh Pharmachem Pvt. Ltd.80Gujarat
Prime Pharmachem102Mumbai
Progress Life Sciences Pvt. Ltd. 29/Ear Panel Mumbai
Prudence Pharma Chem 81/Ear Pane Gujarat
PSG Drytech14Thane
Pyramid Technoplast Pvt. Ltd.45Mumbai
Qualikems Lifesciences Pvt. Ltd.138Gujarat Rahul Enterprises143Mumbai
Rajan Dye Chem155Mumbai
Rajshi Chemical & Products143 Ghaziabad Ram Enterprise76Mumbai
Raivat Impex Pvt. Ltd. 59Mumbai
Rare Pharma Pvt. Ltd.137Mumbai
Rasayan India 85 Navi Mumbai
Rajesh A. Shah82Mumbai
Rati Pushp Intermediates Pvt. Ltd.37U.P.
Regal Remedies Limited36Mumbai
Regent Chemicals41Mumbai Relic Chemicals 82Mumbai
Research-Lab Fine Chem Industries 86Mumbai
Reenold Enterprises 136Mumbai
Riddhi Siddhi Dye Chem136Mumbai
Rolence Pharma & chemicals 125Mumbai
Rosetta Life Care Private Limited 14Mumbai Recycling Solutions Pvt. Ltd.161Gujarat
Rumit Group Of Companies 78Mumbai
Ruskin Chemipharm3Mumbai
S.A.I. Products134Thane Sadhana Enterprises61Thane
Salvavidas Pharmaceuticals Pvt. Ltd. Ear PanelGujarat Sangram Industries164Mumbai
Sanjay Enterprises134Mumbai
SDA Product17Mumbai Sky Chem160Mumbai Shah TC32Delhi
Shagun Pharmaceuticals77Indore Shamrock Pharmachem38Mumbai Sheetal Chem101Mumbai
Shraddha Analytical Services145Mumbai Shree Chemicals117Mumbai Shreenath Chemicals90Boisar Shree Raj Chem84Mumbai Shreedhar Enterprise155Thane Shree Vallabh Chemicals48Gujarat
Shriya Pharma & Surgical42Mumbai Siddhambika Impex141Mumbai Siddharth International109Mumbai Siddhivinayak Pharma 160/Ear Panel Mumbai Sigma INC95Mumbai SML Limited140Mumbai Sohyog Lifesciences162Mumbai Sri Pharmacare123Mumbai Standardcon Pvt. Ltd.150 Navi Mumbai Stratechem (I) Pvt. Ltd.88Mumbai Sukha Chemical Industries41 Ankleshwar Sunraj Chemical co.144 Ulhasnagar Suprim Chemicals84Mumbai SVG Pharma Lifesciences Pvt. Ltd. 145 Navi Mumbai Swan Enterprise166Mumbai Synchrom Laboratory Pt Ltd146 Navi Mumbai Synthetic Molecules71Mumbai Syrohchem Laboratories Pvt. Ltd. Back FlapVasai Tivan Sciences Pvt. Ltd. Ear Panel/40 Gujarat Thana Acid & Chemical Co145Mumbai Topnotch Chemicals Pvt. Ltd. 23Navi Mumbai U.K. Vet Chem 65Mumbai Unipharma121Mumbai Unitrade Agencies70Mumbai Unimax Group20Mumbai Vcare Medicines59Mumbai V.Pharmachem155Mumbai V. Vora & Sons217Mumbai Varahi International26 Ahmedabad Vikram Aromatics144Mumbai Vinipul Inorganics Pvt. Ltd.09Mumbai Vinipul Chemicals Pvt. Ltd.31Mumbai Vita-min Probiotic135Palghar VM Life Science108Gujarat VIPchem Enterprises104Gujarat Western Pharma105Mumbai Yaksh Pharma 46Mumbai Yeve Chemicals Industries 74Telangana Yuvi Chemz148Vadodara Yukti Exim107Mumbai
172 THE MAZADA PHARMA GUIDE
PRODUCTS INDEX
(z)-1- Propenyl Magnesium Bromide
Azeocryst Organics Pvt. Ltd.75
(2 R 4S)- 5-(Biphenyl 4 Yl)-4-(Tert-Butoxycarbonyl Amino)
2-Methylpentanoic Acid Dipti Chemicals And Pharmaceuticals37
2-Ethoxy Benzoic Acid Sangram Industries164
2-Hexyl Ethyl Methyl Acrylate (HEMA)
AbhinandanSolvchem87
1–(2,4-Dichlorophenyl)-2-(1h-Imidazol-1-Yl)Ethanol Om Pharmaceutical Industries153
1-Octanol Abhinandan Solvchem69
1-Fluoronaphthalene KMED International144 10% Platinum On Charcoal Sky Chem160
1,2,3,-Benzotriazole (Needle/Flake)
Syrohchem Laboratories Pvt. Ltd.Back Flap
1,2 Dichloro Ethane (EDC) Yeve Chemicals Industries74
1,2-Dimethoxy Ethane (Monoglyme) Yeve Chemicals Industries74
1,3-dichloro acetone Yeve Chemicals Industries74
1,4-Dioxane Research-Lab Fine Chem Industries86 Yeve Chemicals Industries74
1-Bromo-3-Chloropropane Pacific Organics Pvt Limited16 100visc to 8000visc Amnem Back Inside Cover 222 Tri Fluoro Ethanol KMED International144
2-Acetyl Furan / Copper Iodide Pooja Enterprise98
2-(Chloromethyl)-4-Methyl Quinazoline Dipti Chemicals And Pharmaceuticals37
2,2-Dimethoxy propane Yeve Chemicals Industries74
2 Benzylpyridine Oceanic Laboratories Pvt. Ltd14
2-Bromo Butane Yeve Chemicals Industries74
2-Chloro-5-Bromo Benzoic Acid Dipti Chemicals And Pharmaceuticals37
2-Chloro 5-Iodo Benzoic Acid (CIBA) Eskay Iodine Pvt. Ltd.04
2-Chloro Thiophene Yeve Chemicals Industries74
2-Cyclohexene-1-One Dipti Chemicals And Pharmaceuticals37
2-Cyanoacetamide Pacific Organics Pvt Limited16
2-Ethyl Hexyl Acrylate Sigma INC95
2-Methoxy-4-Amino-5-Ethylsulphonyl Benzoic Acid Dipti Chemicals And Pharmaceuticals37
2-Methyl Resorcinol 107% (White Powder) MK Chemie Pharmie158
2-Methyl THF Yeve Chemicals Industries74
3-Methoxy-1-Propanol KMED International144
2-Sulfoethyl Methacrylate
Swan Enterprise166
2-Nitro Dimethylterephthalate (NMDA)
Syrohchem Laboratories Pvt. Ltd.Back Flap
2-Butanol
Abhinandan Solvchem69
2-Ethyl Hexyl Acryalte (2EHA)
Abhinandan Solvchem69
2-EthylHexyl Alcohol (Octanol)
Abhinandan Solvchem69
3-Methyl-4-Nitrobenzoic Acid
KMED International144
3,5-Diiodo Salicylic Acid
Eskay Iodine Pvt. Ltd.04
3,5-Dimethylpyridine
Sigma INC95
3-Amino-4-Pyrazolecarboxamide Hemisulfate
Om Pharmaceutical Industries153
3-Chloro Propionyl Chloride Yeve Chemicals Industries74
3-Mercaptopropionic Acid 107%
Swan Enterprise166
3 Methyl Xanthine
Dipti Chemicals And Pharmaceuticals37
3-Nitrobenzaldehyde
Syrohchem Laboratories Pvt. Ltd.Back Flap
4 Benzylpyridine
Oceanic Laboratories Pvt. Ltd44
4-Chloro Benzhydryl Piperazine [ Para Chloro Benzhydryl Piperazine ] Om Pharmaceutical Industries153
4-Chloro Benzophenon Yeve Chemicals Industries74
4 - Fluoro Phenyl Magnesium Bromide Azeocryst Organics Pvt. Ltd.75
4-Hydrazinone Benzoic Acid Om Pharmaceutical Industries153
4-Hydroxy Benzyl Alcohol Om Pharmaceutical Industries153
5% Platinum On Charcoal Sky Chem160
5-Bromo-N-(2-Imidazolin-2-Yl)-6-Quinoxalinamine Om Pharmaceutical Industries153
5 Calcium Salts Ruskin Chemipharm3
5-Iodo 2-Methyl Benzoic Acid (MIBA) Eskay Iodine Pvt. Ltd.04
5-Methylbenzotriazole
Syrohchem Laboratories Pvt. Ltd.Back Flap
5-Nitroisophthalic Acid (5-NIPA)
Syrohchem Laboratories Pvt. Ltd.Back Flap
6-BA (6-Benzyl Adenine) V.Pharmachem155
8-Bromo 3 Methyl Xanthine
Dipti Chemicals And Pharmaceuticals37
8-Bromo-3-Methyl-7-But-2-Ynyl Xanthine
Dipti Chemicals And Pharmaceuticals37
Abiratone Acetate
Dipti Chemicals And Pharmaceuticals37
Acebrophylline Inn
Om Pharmaceutical Industries153
Aceclofenac
Medi Pharma Drug House27
Ajmera Pharmasure Ltd.15
Prime Pharmachem102
Unipharma121
Ruskin Chemipharm3
Aceclofenac Ip
K. Patel International16
Acetic Acid
Yukti Exim107
Aceclofenac IP/BP/EP
Sadhana Enterprises61
Aceclofenac IP/BP/USP
Om Pharmaceutical Industries153
Acetione Yukti Exim107
Acesulfame K. Patel International16
Acesulfame
Nandlal Bankatlal Pvt. Ltd.Front Cover
Acesulfame K
Prime Pharmachem102
Acesulfame k FCCV
Nandlal Bankatlal Pvt. Ltd.Front Cover
Acetanilide
Sigma INC95
Acetic Acid
Amizara Chemicals157
Kamlesh Enterprise96
Payal Impex138
Acetic Acid Glacial
Research-Lab Fine Chem Industries86
Neha Enterprises121
Acetic Acid Methyl Ester
Om Pharmaceutical Industries153
Acetone
Research-Lab Fine Chem Industries86
Arihant Enterprises81
Memba Chem Industries Pvt. Ltd.90
Rasayan India85
AGR Enterprises43
Acetone HPLC
Sigma INC95
Acetonitrile
Research-Lab Fine Chem Industries86
Yeve Chemicals Industries74
Amizara Chemicals157
Yukti Exim107
Acetonitrile HPLC
Sigma INC95
Acetonitrile
Memba Chem Industries Pvt. Ltd.98
Rasayan India85
Acetyl Chloride
Yeve Chemicals Industries74
Acrylamide
Yukti Exim107
Acrylamide
Abhinandan Solvchem69
Acrylonitrile
Abhinandan Solvchem69
Ascorbic Acid
Abhinandan Solvchem69
Acotiamide
Biotech Solutions & Pharmaceuticals Ltd.Front Inside Cover
Acrylic Acid
Amizara Chemicals157
Yukti Exim107
AbhinandanSolvchem87
Activated Alumina
Kailash Marketing Associates148
Activated Alumina Ball
Kailash Marketing Associates148
Acyclovir
Medi Pharma Drug House27
Prime Pharmachem102
Adapalene
Biotech Solutions & Pharmaceuticals Ltd.Front Inside Cover
Adapalene BP Farma Fusion41
Adinosilcobalamin Farma Fusion41
Adipic Acid
Amizara Chemicals157
Yukti Exim107
Advanced Cooling Technology
K. Sevantilal & Co. Back Cover
AEEA (Amino Ethyl Ethanolamine)
Sigma INC95
Aemodafinil Inn/IP
Om Pharmaceutical Industries153
Albendazole Unipharma121
Medi Pharma Drug House27
K. Patel International16
P. G. Shah & Co.72
Hindustan Chemicals & Pharmaceuticals125
Albendazole Cp / Ip / USP
Sadhana Enterprises61
Albendazole IP/BP
Oceanic Laboratories Pvt. Ltd44
Albendazole Ip / USP / Micronised
Ajmera Pharmasure Ltd.15
Albendazole IP/USP Micronised
Om Pharmachem Pvt. Ltd.81
Albendazole Ip & Usp (Plain)
CR Pharma100
Albendazole Micronized
K. Patel International16
Alfa Aesar
Earth Chemical & Scientific Pvt. Ltd.118
Alfa Calcidol IP Farma Fusion41
All glycols
Arihant Enterprises81
All Steriods
Biotech Solutions & Pharmaceuticals Ltd.Front Inside Cover
All Types Of Ammino Acids
Payal Impex138
All types of Thinner
Memba Chem Industries Pvt. Ltd.98
Allantoin
American Enterprise120
Allium Satvum
Konark Herbals & Health CareFront Inside
Allopurinol Ip
Farma Fusion41
Allopurinol I. P. / B. P. / E. P. / U. S. P.
Om Pharmaceutical Industries153
Allura Red Lake Amaranth Lake
Standardcon Pvt. Ltd.150
Allyl Chloride
Neha Enterprises121
Allyl Magnesium Bromide / Chloride
Azeocryst Organics Pvt. Ltd.75
Allyestrenol
Farma Fusion41
Balaji CorporationEar Panel / 97
Aloe Vera Powder
Konark Herbals & Health CareFront Inside
Alpha Lipoic Acid Usp
Pharmachem29 K. Patel International16
Sohyog Lifesciences162
Nishchem International Pvt.
Associates148 Aluminium Chloride
Brothers118
Marketing Associates148
Ammonium Alum
Inorganics Pvt.Ltd.9
Kailash Marketing Associates148
Ammonium Bicarbonate (RCF)
Vora Brothers118
Ammonium Bicarbonate Powder
Rasayan India85
Ammonium Carbonate
Vinipul Inorganics Pvt.Ltd.9
Ammonium Cerium Nitrate
Indian Platinum Pvt. Ltd.170
Ammonium Chloride
Vinipul Inorganics Pvt.Ltd.9
Ammonium Chloride I.P. / B.P. / U.S.P. / Pure / Technical
Pravina Pharma Chem Products150
Ammonium Chloroplatinate
Research-Lab Fine Chem Industries86
Sky Chem160
Ammonium Ferrous Sulphate
Sigma INC95
Ammonium Formate
Vinipul Inorganics Pvt.Ltd.9
Ammonium Molybdate
Pacific Organics Pvt Limited16
Ammonium Oxalate
Vinipul Inorganics Pvt.Ltd.9
Ammonium Per Sulphate /Potassium Per Sulphate
Sigma INC95
Ammonium Sulphate
Vinipul Inorganics Pvt.Ltd.9
Vora Brothers118
Ammonium Thioglycolate
Synchrom Laboratory Pvt Ltd146
Ammonium Thiocyanate 98% & 50%
Pooja Enterprise98
Ambroxol Hcl IP
Sadhana Enterprises61
Amisulpiride
Biotech Solutions & Pharmaceuticals Ltd. Front Inside Cover
Amoxapine Juana Pharma149
Amoxapine Ip/Usp
Aster Biopharma LLP12
AmoxycillinTrihydrate
Prime Pharmachem102
Amoxycillin Sodium Sterile / Trihydrate Yaksh Pharma46
Amoxicillin Trihydrate IP/BP
K. Patel International16
Amoxycillin Trihydrate Ip(Compacted)
K. Patel International16
Amoxicillin Trihydrate Compacted / Powder Ip/ Bp
Naksha Pharma Nutraceutical Pvt. Ltd.140
Amphotericin
Amphotericin
Ruskin Chemipharm3
Amikacin Sulphate
Ruskin Chemipharm3
Ampicillin Sodium Sterile
Alpha
Sevantilal & Co.
Cover Unipharma121 Aster Biopharma LLP12 Alpha Lipoic Acid (Nutra Grade) Padmavati Pharmachem5
Ruskin Chemipharm3
Ambroxol
Ruskin Chemipharm3
Ruskin Chemipharm3
Ampicillin Sodium Prime Pharmachem102
Ampicillin Sodium Oral / Sterile Yaksh Pharma46
6Ampicillin Trihydrate IP/BP
K. Patel International16
Amrolofine Hcl
Farma Fusion41
Back Cover
Nikeon
80 Prime
Naksha
Cover
Lipoic Acid K. Sevantilal & Co.
Medi Pharma Drug House27
Corporation
Pharmachem102
Pharma Nutraceutical Pvt. Ltd.140 Nandlal Bankatlal Pvt. Ltd.Front
K.
Back
Aaditya
Ltd.20 Alpha Picoline Yeve Chemicals Industries74 Alpinia Galanga Konark Herbals & Health CareFront Inside Alum Purchase & Sales Exchange124 Alum Powder / Lumps Vora Brothers118 Alumina Kailash Marketing Associates148 Alumina Products: Granules, Pellet,
Purchase
Vora
Aluminum
Kailash
Aluminium
Ambroxol
Standardcon Pvt. Ltd.150 Ambroxol HCL IP CR Pharma100 Naksha Pharma Nutraceutical Pvt. Ltd.140 Amikacin Sulphate Nandlal Bankatlal Pvt. Ltd.Front Cover Prime Pharmachem102 Ruskin Chemipharm3 Amisulpiride Om laboratories
Juana
Amisulpride
Farma
Sadhana
Amisulpride
Om
Amitriptyline
Hap
Amitriptyline
Aster
LLP12 Amla Konark Herbals & Health CareFront Inside Amla Powder Konark Herbals & Health CareFront Inside Amlodipine Besylate Hap Enterprise74 Yaksh Pharma46 Ammonia Solution Memba Chem Industries Pvt. Ltd.98 Amlodipine Besylate Aster
Amoxapine Aster
Aster
Vinipul
Crackle Kailash Marketing
& Sales Exchange124 Aluminium Fluoride
Hydroxide
Nitrate Vora Brothers118 Cosmic Chemicals100
Hap Enterprise74 Amaranth Lake
26
Pharma149
IP
Fusion41
Enterprises61
Ip/bp/ph.eur/ihs
Laboratories26
Hcl
Enterprise74
HCL
Biopharma
Biopharma LLP12
Biopharma LLP12 Amoxicillin & Potassium Clavulanate sterile IP
Biopharma LLP12 Ammino Acid 80% Soya Base V.Pharmachem155 Ammonium Acetate
Part-1 (FP to 18) THE MAZADA PHARMA GUIDE 173
PRODUCTS INDEX
Diltiazem Hcl Ip
Sadhana Enterprises61
DL Methionine
Konark Herbals & Health CareFront Inside
Dl-Methionine Bp
K. Sevantilal & Co. Back Cover
Nikeon Corporation 80
Disodium EDTA
Vinipul Inorganics Pvt.Ltd.9
Distearyl Thiodipropionate
Swan Enterprise166
Distilled / DM Water
Memba Chem Industries Pvt. Ltd.98
Disulfiram IP/USP
Mavaveer Chemiclas3
Ditridecyl Thiodipropionate
Swan Enterprise166
Divalproex Sodium
Biotech Solutions & Pharmaceuticals Ltd. Front Inside Cover
Divalproex Sodium Ip/Usp
Aster Biopharma LLP12
Sadhana Enterprises61
Varahi International 26
Di Octyl Phthalate (dop)
Yukti Exim107
DEM
Abhinandan Solvchem69
DETA
Abhinandan Solvchem69
DMF
Arihant Enterprises81
DMSO
Medi Pharma Drug House27
Amizara Chemicals157
Yukti Exim107
DOM / DBM / DOA / DBP (Phthalates)
Sigma INC95
Domperidone
Farma Fusion41
Prime Pharmachem102
Domperidone BP
Sadhana Enterprises61
Domperidone Ip
CR Pharma108
Naksha Pharma Nutraceutical Pvt. Ltd.140
Domperidone IP/BP/USP
Biotech Solutions & Pharmaceuticals Ltd.Front Inside Cover
Domperidone Maleate Farma Fusion41
Domperidone Maleate Ip / Bp
Sri Pharmacare125
Dothiepin Hcl
Hap Enterprise74
Dothiepine HCL IP Nishchem International Pvt. Ltd.20
Doxapram HCL USP / EP
Nishchem International Pvt. Ltd.20
Doxycycline Hcl
Medi Pharma Drug House27
Doxycycline Hyclate
K. Sevantilal & Co. Back Cover
Doxycycline
Nandlal Bankatlal Pvt. Ltd.Front Cover
Doxycycline Hyclate
Ruskin Chemipharm3 Prime Pharmachem102
Doxycycline Hyclate Ip
Sohyog Lifesciences162
Doxycycline Hyclate IP/BP
Nishchem International Pvt. Ltd.20
Doxycycline Hydrochloride Unipharma121
Doxylamine succinate Hap Enterprise74
Doxylamine Succinate Usp CR Pharma108
Dried Ferrous Sulphate I.P. / B.P. / U.S.P.
Pravina Pharma Chem Products150
Drotavarine HCL
K. Patel International16
Dry Vitamin A Acetate
K. Sevantilal & Co. Back Cover
Dry Vitamin A Acetate 325 Cws/A
K. Sevantilal & Co. Back Cover
Dry Vitamin A Acetate 500 B
K. Sevantilal & Co. Back Cover
Dry Vitamin D3 100 Sd/S
K. Sevantilal & Co. Back Cover
Dry Vitamin E Acetate 50 %
K. Sevantilal & Co. Back Cover
Dry Vitamin K1 5% Sd
K. Sevantilal & Co. Back Cover
Dry Vitamin E
K. Sevantilal & Co. Back Cover
Dry Vitamin K15
K. Sevantilal & Co. Back Cover
Duloxetine Hcl Farma Fusion41
Duloxetine HCL IP/USP
Nishchem International Pvt. Ltd.20
Dutasteride
Sadhana Enterprises61
Dutasteride Ip Hap Enterprise74
Dutasteride Ip/Bp/Usp
Aster Biopharma LLP12
Dutasteride Usp / Ip Farma Fusion41
Dycylomine Hcl Ip
Sadhana Enterprises61
Eberconazole
Biotech Solutions & Pharmaceuticals Ltd.Front Inside Cover
Eberconazole Nitrate Farma Fusion41
Eberconazole Nitrate Ip
CR Pharma108
EDA / DETA / TETA / TEPA
Amizara Chemicals157
EDA Abhinandan Solvchem69
E-Polylysine
Abhinandan Solvchem69
EDC Arihant Enterprises81
Efinaconazole
P. G. Shah & Co.72
EMME Sigma INC95
Empagliflozin
Aster Biopharma LLP12
Emulsifiers
ARK Chemical Pvt. Ltd.168
Emulsifier 30(Alphox 500)
Kamlesh Enterprise96
Emulsifier 4.5(Alphox 100)
Kamlesh Enterprise96
Emulsifier 9.5(Alphox 200)
Kamlesh Enterprise96
Enelapril Maleate Ip / Bp
Sri Pharmacare125
Enoxaparin P. G. Shah & Co.72
Enramycin 8%
Jaysum Biotech77
Enrofloxacin
Unipharma121
Enzalutamide
Dipti Chemicals And Pharmaceuticals37
Epichlorohydrine
Rasayan India85
Amizara Chemicals157
Yukti Exim107
Epichloro Hydrine / Lithium Carbonate / Lithium Hydroxide / Lithium Aluminium Hydride
Sigma INC95
Eplerenone IP
Yaksh Pharma46
Epoxy Resin
Amizara Chemicals157
Erdosteine
Biotech Solutions & Pharmaceuticals Ltd.Front Inside Cover
Ergometrine Maleate USP/IP
Aaditya Pharmachem29
Ergotamine Tartrate USP/IP
Aaditya Pharmachem29
Erlotinib
Yaksh Pharma46
Erlotinib Hcl
Dipti Chemicals And Pharmaceuticals37
Erythromycin 10%
Jaysum Biotech77
Erythrosine Lake Standardcon Pvt. Ltd.150
Everolimus
Aster Biopharma LLP12
Es-Citalopram Oxalate IP / USP
Nishchem International Pvt. Ltd.20
Escitalopram
Biotech Solutions & Pharmaceuticals Ltd.Front Inside Cover
Escitalopram Oxalate
Hap Enterprise74
Escitalopram Oxalate Ip
Farma Fusion41
Esomeprazole + Domperidone
Biotech Solutions & Pharmaceuticals Ltd.Front Inside Cover
Esomeprazole + Levosulpiride
Biotech Solutions & Pharmaceuticals Ltd.Front Inside Cover
Esomeprazole EC Pellets
K. Patel International16
Esomeprazole Magnesium TRH
Farma Fusion41
Esomeprazole Magnesium Trihydrate
P. G. Shah & Co.72
Essential Oils
Aditya Mint156
Essential Oil Granuals
Jaysum Biotech77
Ethamsylate
Medi Pharma Drug House27
Ethanol 100% Premium Grade AR / HPCL / EP / BP / USP 500Ml
Laboratory Solutions India41
Ethanol 96% 500Ml
Laboratory Solutions India41
Ethanol AR 107.9% 500 Ml
Laboratory Solutions India41
Ethanol Emprove 500Ml
Laboratory Solutions India41
Ethanol For Molecular Biology 250Ml
Laboratory Solutions India41
Ethanol GR/ACS Emure 500 Ml
Laboratory Solutions India41
Ethanol Gradient Grade HPLC 500 Ml
Laboratory Solutions India41
Ethanol Spectroscopy Uvasol 500Ml
Laboratory Solutions India41
Ethanolamine Thioglycolate
Synchrom Laboratory Pvt Ltd146
Etizolam IP
Farma Fusion41
Etizolam Jp
Sadhana Enterprises61
Etodolac Ip
Farma Fusion41
Etoposide
Ruskin Chemipharm3
Etoricoxib Hindustan Chemicals & Pharmaceuticals125
Ethoxylated Castor Oils
Jayant Agro-Organics Limited158
Ethyl Acetate
Research-Lab Fine Chem Industries86
Memba Chem Industries Pvt. Ltd.98
Neha Enterprises121
Amizara Chemicals157
Yukti Exim107
Ethyl Acrylate
Yukti Exim107
AbhinandanSolvchem87
Ethyl Acetate (Satyam Somaiya/Laxmi/Gnfc)
Arihant Enterprises81
Ethyl Bromide
Yeve Chemicals Industries74
Ethyl Carbitol (Igtol 12016 E)
Kamlesh Enterprise96
Ethyl Cellosolve Acetate (Igace 6701 E)
Kamlesh Enterprise96
Ethyl Cellosolve Acetate
Yukti Exim107
Ethyl Cellosolve
Yukti Exim107
Ethyl Cellosolve(Igsol 12026 E)
Kamlesh Enterprise96
Ethyl Cellulose (All Grades)
American Enterprise120
Ethyl Cellulose N20
Prime Pharmachem102
Nishchem International Pvt. Ltd.20
Ethyl Cellulose N50
Prime Pharmachem102
Ethyl Cellulose USP All Grade
Iris IngredientsFront Flap
Ethyl Chloro Formate
Yeve Chemicals Industries74
Rasayan India85
Ethyl Cyano Acetate
Sigma INC95
Ethyl Format
Yeve Chemicals Industries74
Ethyl Glycol / Acetate
Sigma INC95
Ethyl Iodide
Eskay Iodine Pvt. Ltd.04
Ethyl Linalool
K. Sevantilal & Co. Back Cover
Ethyl Linalyl Acetate K. Sevantilal & Co. Back Cover
Ethyl Magnesium Bromide / Chloride
Azeocryst Organics Pvt. Ltd.75
Ethyl Oleate
Siddhivinayak Pharma Ear Panal
Ethyl Tri Phenyl Phosphonium Bromide
Pacific Organics Pvt Limited16
Ethylene Di Bromide
Pacific Organics Pvt Limited16
Ethylene Dichloride
Memba Chem Industries Pvt. Ltd.98
Ethylenediamine AR
Sigma INC95
Ethylenediamine Dihydroiodide (EDDI)
Eskay Iodine Pvt. Ltd.04
Etodolac
Yaksh Pharma46
Etroricoxib
Yaksh Pharma46
Etoricoxib IP Farma Fusion41
CR Pharma108
Nishchem International Pvt. Ltd.20
Evening Prom Rose Oil
Konark Herbals & Health CareFront Inside
Excepients
Siddhambika Impex 142
Famciclovir
Yaksh Pharma46
Faropenem Yaksh Pharma46
Biotech Solutions & Pharmaceuticals Ltd.Front Inside Cover
Faropenam Sodium Ip/Bp/Usp
Aster Biopharma LLP12
Fast Green Fcf Lake
Standardcon Pvt. Ltd.150
Fast Red E Lake Standardcon Pvt. Ltd.150
Febantel
Juana Pharma149
Fenbendazole P. G. Shah & Co.72
Hindustan Chemicals & Pharmaceuticals125
Fenbendazole BP VET
Ajmera Pharmasure Ltd.15
Sohyog Lifesciences162
Fenofibric Acid
Om Pharmaceutical Industries153
Febuxostat Hap Enterprise74 Juana Pharma149
Febuxostat IH Farma Fusion41
Fenofibrate Ip/ Micron Hap Enterprise74
Fenofibrate I.P./B.P./E.P./U.S.P.
Om Pharmaceutical Industries153
Fenticonazol Nitrate BP/EP
Om Pharmaceutical Industries153
Ferric Ammonium Sulphate Vora Brothers118
Ferric Chloride
Vinipul Inorganics Pvt.Ltd.9
Ferric Chloride (Anhydrous) AR/LR
Sigma INC95
Ferric Nitrate
Cosmic Chemicals100
Ferric Sulphate
Cosmic Chemicals92
Ferrous Ascorbate (Pwd/Dc Grade)
Hap Enterprise74
Ferrous Sulphate
Payal Impex138
Ferrous Sulphate Heptahydrate I.P. / B.P. / U.S.P.
Pravina Pharma Chem Products150
Ferrous Sulphide Sticks Sigma INC95
Fexofenadine
Yaksh Pharma46
Fexofenadine Hcl Hindustan Chemicals & Pharmaceuticals125
Aster Biopharma LLP12
Fluconazole
Aster Biopharma LLP12
P. G. Shah & Co.72
Finar / Aceto
Earth Chemical & Scientific Pvt. Ltd.118
Finasteride
Juana Pharma149
Finasteride Ip/Bp/Usp
Aster Biopharma LLP12
Om Laboratories26
Flavomycin / Bambermycin 4%, 8%
Jaysum Biotech77
Flavoxate HCL IP
Nishchem International Pvt. Ltd.20
Flibanserin Ihs
Om Laboratories26
Flucloxacillin Sodium Sterile Yaksh Pharma46
Fluconazole
K. Patel International16
P. G. Shah & Co.72
Hindustan Chemicals & Pharmaceuticals125
Fluconazole Ip
Naksha Pharma Nutraceutical Pvt. Ltd.140
Fluconazole
Ruskin Chemipharm3
Folic Acid
Ruskin Chemipharm3
Fluocinolone Acetonide Ip/Usp
Balaji Steroids and Hormones Pvt. Ltd.Back Inside Flap
Fluconazole IP/BP/USP
Biotech Solutions & Pharmaceuticals Ltd. Front Inside Cover
Hap Enterprise74
Sadhana Enterprises61
Yaksh Pharma46
Flunixin Meglumine
P. G. Shah & Co.72
Fluid Bed Dryers
Bombay Engineering Works 160
Flupentixol Di HCL BP
Nishchem International Pvt. Ltd.20
Fluphenazine Decanoate Bp/Usp
Aster Biopharma LLP12
Fluphentixol Hcl
Hap Enterprise74
Flupirtine Maleate
Biotech Solutions & Pharmaceuticals Ltd.Front Inside Cover
Fluorobenzene
Yeve Chemicals Industries74
Fluoroboric Acid 48% Aqueous
Sigma INC95
Fluorometholone Micronised USP
Aaditya Pharmachem29
Fluorometholone Acetate USP
THE MAZADA PHARMA GUIDE 177
PRODUCTS INDEX
Prime Pharmachem102
Levofloxacin IP
Nishchem International Pvt. Ltd.20
Levosalbutamol Sulphate
Farma Fusion41 Unipharma121
P. G. Shah & Co.72
Levosalbutamol Sulphate Ip
Sadhana Enterprises61
Naksha Pharma Nutraceutical Pvt. Ltd.140
Ariheet Pharmachem LLP5
Levosulpiride
Farma Fusion41
Biotech Solutions & Pharmaceuticals Ltd. Front Inside Cover
Juana Pharma149
Levosulpiride IP Sadhana Enterprises61
Levothyroxine Sodium
P. G. Shah & Co.72
Lignocaine / Lidocaine
Biotech Solutions & Pharmaceuticals Ltd.Front Inside Cover
Linagliptin DMF
Dipti Chemicals And Pharmaceuticals37
Lincomycin Hcl
Medi Pharma Drug House27
Linalool
K. Sevantilal & Co. Back Cover
Linalool
K. Sevantilal & Co. Back Cover
Lincomycin 11%
Jaysum Biotech77
Lincomycin Hydrochloride
Ruskin Chemipharm3
Linezolid
Hap Enterprise74
Linezolid Ip
CR Pharma108
Linseed Oil
Nishchem International Pvt. Ltd.20
Liquid Bromine
Pacific Organics Pvt Limited16
Liquid Soap Memba Chem Industries Pvt. Ltd.98
Lisinopril IP/USP
Pharma46
Lithium Bromide Powder
Pacific Organics Pvt Limited16
Lithium Bromide Solution 50% (Plain / Chromate base) Pacific Organics Pvt Limited16 Lithium Carbonate Pacific Organics Pvt Limited16 Ariheet Pharmachem LLP5 Lithium Carbonate IP
Lithium Chloride Powder
Pacific Organics Pvt Limited16
Lithium Chloride Solution 40% (Plain / Chromate base)
Pacific Organics Pvt Limited16
Lithium Hydroxide Monohydrate
Pacific Organics Pvt Limited16
Lithium Molybdate (Powder & Solution)
Pacific Organics Pvt Limited16
Lithium Nitrate
Pacific Organics Pvt Limited16
Lithium Sulphate
Pacific Organics Pvt Limited16
Lynalyl Acetate
K. Sevantilal & Co. Back Cover
Loba Earth Chemical & Scientific Pvt. Ltd.118
Lonalyl Acetate
K. Sevantilal & Co. Back Cover
Loratidine Bp
Naksha Pharma Nutraceutical Pvt. Ltd.140
Lornoxicam
Yaksh Pharma46
Hap Enterprise74
Lornoxicam Ih
Sadhana Enterprises61
Farma Fusion41
Lornoxicam IP/BP/USP
Biotech Solutions & Pharmaceuticals Ltd.Front Inside Cover
Losartan Potassium
Om Pharmaceutical Industries153
Ariheet Pharmachem LLP 5
Losartan Potassium Ip/Usp
Farma Fusion41
Losartan Pottassium IP/BP/USP
Yaksh Pharma46
Hap Enterprise74
Loxapine Succinate
Juana Pharma149
Loxapine Succinate Ip/Usp
Aster Biopharma LLP12
Loperamide
Aster Biopharma LLP12
Loratadine
Aster Biopharma LLP12
Losartan potassium
Aster Biopharma LLP12
Luliconazole
Farma Fusion41
Yaksh Pharma46
Hap Enterprise74
Biotech Solutions & Pharmaceuticals Ltd.Front Inside Cover
K. Patel International16
Luliconazole Ihs CR Pharma108
Luliconazole IP Nishchem International Pvt. Ltd.20
Lumifantrine Unipharma121
Lutein
K. Sevantilal & Co. Back Cover
Lycopene
K. Sevantilal & Co. Back Cover
Konark Herbals & Health CareFront Inside
M.E.K.
Arihant Enterprises81
Maduramycin 1%
Jaysum Biotech77
Magnesium Acetate
Vora Brothers118
Cosmic Chemicals100
Magnesium Stearate Eph-V
K. Sevantilal & Co. Back Cover
Magnesium Stearate Vegetable Hsep
K. Sevantilal & Co. Back Cover
Magnesium Carbonate
Vora Brothers118
Magnesium Chloride
Cosmic Chemicals100
Forbes PharmaceuticalsBack Flap Inside
Magnesium Nitrate
Vora Brothers118
Cosmic Chemicals100
Magnesium Oxide - Light (Ip)
Forbes PharmaceuticalsBack Flap Inside
Magnesium Oxide - Light (Usp)
Forbes PharmaceuticalsBack Flap Inside
Magnesium Stearate
Hap Enterprise74
Magnesium Sulphate
Vora Brothers118
Forbes PharmaceuticalsBack Flap Inside
Vinipul Inorganics Pvt.Ltd.9
Magnesium Sulphate I.P. / B.P.
Pravina Pharma Chem Products150
Magnesium Turning
Sigma INC95
Maleic Anhy
Amizara Chemicals157
Manganese(Mn)
SML Limited140
Manganese Acetate
Vora Brothers118
Cosmic Chemicals100
Mannitol
Nandlal Bankatlal Pvt. Ltd.Front Cover
Mannitol SD 200
Nandlal Bankatlal Pvt. Ltd.Front Cover
Manganese Carbonate
Vora Brothers118
Cosmic Chemicals100
Forbes PharmaceuticalsBack Flap Inside
Manganese Chloride
Vora Brothers118
Cosmic Chemicals100
Manganese Sulphate
Vinipul Inorganics Pvt.Ltd. 9
Payal Impex138
Manganese Sulphate (98%)
Forbes PharmaceuticalsBack Flap Inside
Mangiferin
Konark Herbals & Health CareFront Inside
Maleic Anhydride
Sigma INC95
Kamlesh Enterprise96
Malonic Acid
Yeve Chemicals Industries74
Maltodextrin
Maltose
Abhinandan Solvchem69
Malonic Acid / Malononitrile
Sigma INC95
Malto Dextrin Powder
Neha Enterprises121
MBT / MBTS / ZMBT
Pooja Enterprise98
MCC - JRS K. Patel International16
Mebendazole
Hindustan Chemicals & Pharmaceuticals125
Mebendazole IP/BP/USP
Oceanic Laboratories Pvt. Ltd44
Mesalamine / Measalazine-IP/BP/USP/EP
Oceanic Laboratories Pvt. Ltd.44
Mebeverine HCL SR
Biotech Solutions & Pharmaceuticals Ltd.Front Inside Cover
Mecobalamin Ip
Naksha Pharma Nutraceutical Pvt. Ltd.140
Mecobalamin IP / JP / USP
Nishchem International Pvt. Ltd.20
Medroxy Progesterone Acetate IP
Balaji CorporationEar Panel / 97
Meclizine Hcl Ip/Bp
CR Pharma108
Mefenamic Acid
Medi Pharma Drug House27
Ruskin Chemipharm3
Mesna
Ruskin Chemipharm3
Meropenam
Ruskin Chemipharm3
Mefenamic Acid IP / BP
Nishchem International Pvt. Ltd.20
Mefenamic Acid IP/BP/EP/USP Om Pharmaceutical Industries153
Melamine Rasayan India85
Amizara Chemicals157
KMED International144
Meallic Anhydride
Yukti Exim107
Melitracen HCL
Hap Enterprise74
Melitracin HCL IH
Nishchem International Pvt. Ltd.20
Meloxicam Bp
Naksha Pharma Nutraceutical Pvt. Ltd.140
Meloxicam Usp
Hap Enterprise74
Menthol
Aditya Mint156
Menthol Cristal
Rahul Enterprises131
Memantine Hcl
Sadhana Enterprises61
Merck Millipore
Earth Chemical & Scientific Pvt. Ltd.118
Mercuric Acetate
Research-Lab Fine Chem Industries86
Forbes PharmaceuticalsBack Flap Inside
Mercuric Ammonium Chloride
Research-Lab Fine Chem Industries86
Mercuric Bromide
Research-Lab Fine Chem Industries86
Mercuric Chloride
Research-Lab Fine Chem Industries86
Forbes PharmaceuticalsBack Flap Inside
Mercuric Iodide
Forbes PharmaceuticalsBack Flap Inside
Mercuric Nitrate
Research-Lab Fine Chem Industries86
Forbes PharmaceuticalsBack Flap Inside
Mercuric Oxide (Red)
Forbes PharmaceuticalsBack Flap Inside
Mercuric Oxide (Yellow)
Forbes PharmaceuticalsBack Flap Inside
Mercuric Oxide Red
Research-Lab Fine Chem Industries86
Mercuric Oxide Yellow
Research-Lab Fine Chem Industries86
Mercuric Sulphate
Research-Lab Fine Chem Industries86
Forbes PharmaceuticalsBack Flap Inside
Mercurous Chloride
Research-Lab Fine Chem Industries86
Mercurous Nitrate
Research-Lab Fine Chem Industries86
Forbes PharmaceuticalsBack Flap Inside
Meropenem
Yaksh Pharma46
Meropenam Buffered Sterile
Medi Pharma Drug House27
Meropenam
Aster Biopharma LLP12
Methotrexate
Aster Biopharma LLP12
Methylprednisolone sterile
Aster Biopharma LLP12
Metoprolol succinate
Aster Biopharma LLP12
Mesalamine
Hap Enterprise74
Mesalamine IP/BP
Oceanic Laboratories Pvt. Ltd44
Mesna Ruskin Chemipharm3
Metallic Salts
Payal Impex138
Metamizole Sodium
Prime Pharmachem102
Meta Amino Phenol
Yeve Chemicals Industries74
Meta Bromo Anisole
Pacific Organics Pvt Limited16
Meta Bromo Nitro Benzene
Pacific Organics Pvt Limited16
Metformin Hcl IP K. Patel International16
Naksha Pharma Nutraceutical Pvt. Ltd.140
Methacrylic Acid Sigma INC95
Methane Sulfonic Acid
Yeve Chemicals Industries74
Methane Sufonyl Chloride
Yeve Chemicals Industries74
Rasayan India85
Methane Sulphonic Acid
Amizara Chemicals157
Methanol
Research-Lab Fine Chem Industries86
Arihant Enterprises81
Memba Chem Industries Pvt. Ltd.98
Yukti Exim107
Methanol HPLC
Sigma INC95
Methyl Aceto Acetate
Rasayan India85
Methyl Acrylate
AbhinandanSolvchem69
Methyl Ketone
Yukti Exim107
Methyl Acrylic Acid
Yeve Chemicals Industries74
Methyl Cellosolve
Kamlesh Enterprise96
Methyl Cellulose (All Grades)
American Enterprise120
Methyl Cellulose USP 400/4000
Iris IngredientsFront Flap
Methyl cobalamine
Medi Pharma Drug House27
Biotech Solutions & Pharmaceuticals Ltd.Front Inside CoverPrime Pharmachem102
K. Patel International16
Methylcobalamine IP CR Pharma108
Om Pharmachem Pvt. Ltd.81
Methylcobalamine (Mecobalamine) Ip/Jp
Balaji Steroids and Hormones Pvt. Ltd.Back Inside Flap
Methlycobalamine Ip/Jp
Aster Biopharma LLP12
Methyl Cyanoacetate
Pacific Organics Pvt Limited16
Methyl Ergometrine
Maleate USP/IP
Aaditya Pharmachem29
Methyl Ethyl Ketone
Memba Chem Industries Pvt. Ltd.98
Rasayan India85
Amizara Chemicals157
Kamlesh Enterprise96
Yukti Exim107
Methyl Folate Calcium
Farma Fusion41
Methyl Glycol (Acetate)
Sigma INC95
Methyl Iodide
Eskay Iodine Pvt. Ltd.04
Methyl Iso Butyl Ketone (MIBK)
Memba Chem Industries Pvt. Ltd.98
Rasayan India85
Payal Impex138
Methyl Magnesium Bromide / Chloride
Azeocryst Organics Pvt. Ltd.75
Methyl Methacrylate
Sigma INC95
Methyl predni acetate
Hap Enterprise74
Methyl Prednisolone
Medi Pharma Drug House27
Methyl Prednisolone Ip
Farma Fusion41
Sohyog Lifesciences162
Metroidazole
K. Sevantilal & Co. Back Cover
MSG
Abhinandan Solvchem69
Prednisolone Sodium Phosphate Ip/Usp
Balaji Steroids and Hormones Pvt. Ltd.Back Inside Flap
Prednisolone Ip/Usp
Balaji Steroids and Hormones Pvt. Ltd.Back Inside Flap
Methlyprednisolone Ip/Usp
Aster Biopharma LLP12
Methylprednisolone Acetate Ip/Usp
Aster Biopharma LLP12
Methylprednisolone Ip/Usp
Balaji Steroids and Hormones Pvt. Ltd.Back Inside Flap
Methylene Chloride (MDC)
Amizara Chemicals157
Methylene Di Isocynate(mdi)
Yukti Exim107
Methylene Dichloride
Memba Chem Industries Pvt. Ltd.98
Rasayan India85
Metoprolol Succinate
Hap Enterprise74
Metoprolol Tartrate
Hap Enterprise74
Metronidazole
Medi Pharma Drug House27
Unipharma121
Nandlal Bankatlal Pvt. Ltd.Front Cover
Methylcobalamine
Ajmera Pharmasure Ltd.15
K. Sevantilal & Co. Back Cover
Metha Acid
Abhinandan Solvchem69
Methylcobalamin Ip
180 THE MAZADA PHARMA GUIDE
Yaksh
Varahi International 26
PRODUCTS INDEX
Payal Impex138
Normal Butanol
Yukti Exim107
Nortrityline HCL
Hap Enterprise74
Nutraceuticals
Medi Pharma Drug House27
Nystatin
Medi Pharma Drug House27
Ruskin Chemipharm3
Obeticholic Acid IH
Nishchem International Pvt. Ltd.20
Octyl Phenol Ethoxylates
ARK Chemical Pvt. Ltd.168
Octanol
Yukti Exim107
Octoic Acid
Abhinandan Solvchem69
OPDA
Abhinandan Solvchem69
Odour Control
K. Sevantilal & Co. Back Cover
Ofloxacin
Medi Pharma Drug House27
Om Pharmaceutical Industries153
Prime Pharmachem102 Unipharma121
Ruskin Chemipharm3
Ofloxacin Ip
Nishchem International Pvt. Ltd.20
Olanzapine
Biotech Solutions & Pharmaceuticals Ltd.Front Inside Cover
Olanzapine IP Farma Fusion41
Olanzapine IP/BP/USP Yaksh Pharma46
Olaparib
Dipti Chemicals And Pharmaceuticals37
Oleic Acid Lubolic 20 Grade
Sigma INC95
Oleic Acid Lubolic Economy Grade Sigma INC95
Oleyl Amine Ethoxylates
ARK Chemical Pvt. Ltd.168
Olmesartan
Biotech Solutions & Pharmaceuticals Ltd.Front Inside Cover
Medi Pharma Drug House27
K. Patel International16
Olmesartan Medoxomil
Hap Enterprise74
Olmesartan Medoxomil EP/BP/IP Yaksh Pharma46
Omeprazole EC Pellets
K. Patel International16
Omeprazole Magnisium Usp Farma Fusion41
Omperazole Pellets 7.5%, 8.5% Ip/Bp/Usp Aster Biopharma LLP12
Orphenadrine Citrate Bp/Usp
CR Pharma108
Omeprazole Powder Farma Fusion41
Juana Pharma149
Ondansetron HCl / Base IP
Nishchem International Pvt. Ltd.20
Ondensetron Hcl Ip
Sadhana Enterprises61
Farma Fusion41
Opthalmic API
Siddhambika Impex 142
Orange Powder
Konark Herbals & Health CareFront Inside
Orlistat Yaksh Pharma46
Ornidazole
Prime Pharmachem102
Ornidazole Ip
K. Patel International16
Nishchem International Pvt. Ltd.20
Naksha Pharma Nutraceutical Pvt. Ltd.140
Ornidazole IP/BP/USP
Medi Pharma Drug House27
Orphenadrine Citrate Ip/Bp CR Pharma108
Ortho Chloro Benzoic Acid
Panchamrut Chemicals166
Ortho Cyano Benzyl Bromide
Dipti Chemicals And Pharmaceuticals37
Ortho Nitro Chloro Benzene (ONCB)
Yeve Chemicals Industries74
Ortho Xylene
Memba Chem Industries Pvt. Ltd.98
Yukti Exim107
Orthophosphoric Acid 88% - Hipure
Sigma INC95
Otilonium Bromide IH
Nishchem International Pvt. Ltd.20
OTTO
Earth Chemical & Scientific Pvt. Ltd.118
Oxacillin sodium sterile Yaksh Pharma46
Oxalic Acid
Payal Impex138
Oxaliplatin
Ruskin Chemipharm3
Ofloxacin
Ruskin Chemipharm3
Ornidazole Ruskin Chemipharm3
Oxcarbazapine
Hindustan Chemicals & Pharmaceuticals125
Oxetacaine
Biotech Solutions & Pharmaceuticals Ltd.Front Inside Cover Farma Fusion41
Oxetacaine BP
Nishchem International Pvt. Ltd.20
Oxfendazole
P. G. Shah & Co.72
Oxiconazole Nitrate Farma Fusion41
Oxyclozanide
Yaksh Pharma46
Oxyclozanide Bp Vet CR Pharma108
Oxyquinoline Sulphate
Eskay Iodine Pvt. Ltd.04
Oxytetracycline
K. Sevantilal & Co. Back Cover
Nandlal Bankatlal Pvt. Ltd.Front Cover
Oxytetracycline 20%
Jaysum Biotech77
Oxytetracycline HCL
Medi Pharma Drug House27
Prime Pharmachem102
P-Toluenesulphonic Acid Monohydrate 98%
Sigma INC95
P.V.P.K-17 / 25 / 30 / 90
American Enterprise120
P.V.P. K90
Ariheet Pharmachem LLP5
Paclitaxel
Yaksh Pharma46
Palbociclib
Dipti Chemicals And Pharmaceuticals37
Palladium (O)
Research-Lab Fine Chem Industries86
Palladium 0.5% On Alumina Balls
Sky Chem160
Palladium 10% on Alumina
Indian Platinum Pvt. Ltd.170
Sky Chem160
Palladium 10% On Asbestos
Sky Chem160
Palladium 10% On Barium Sulphate
Sky Chem160
Palladium 10% On Calcium Carbonate
Sky Chem160
Palladium 10% On Charcoal
Sky Chem160
Palladium 5% On Alumina
Sky Chem160
Palladium 5% On Asbestos
Sky Chem160
Palladium 5% On Barium Sulphate
Sky Chem160
Palladium 5% On Calcium Carbonate
Sky Chem160
Palladium 5% on Charcoal
Indian Platinum Pvt. Ltd.170
Sky Chem160
Palladium Acetate
Research-Lab Fine Chem Industries86
Sky Chem160
Palladium Bromide
Research-Lab Fine Chem Industries86
Sky Chem160
Palladium Chloride
Research-Lab Fine Chem Industries86
Sky Chem160
Palladium Nitrate
Research-Lab Fine Chem Industries86
Sky Chem160
Palladium Oxide
Research-Lab Fine Chem Industries86
Sky Chem160
Palladium Powder
Sky Chem160
Palladium Sulphate
Research-Lab Fine Chem Industries86
Sky Chem160
Palonosetron
Om Pharmaceutical Industries153
Pantoprazole K. Patel International16
Pantoprazole + Domeperidone
Biotech Solutions & Pharmaceuticals Ltd.Front Inside Cover
Pantoprazole + Itopride
Biotech Solutions & Pharmaceuticals Ltd.Front Inside Cover
Pantoprazole + Levosulpiride
Biotech Solutions & Pharmaceuticals Ltd.Front Inside Cover
Pantoprazole Sodium sterile
Aster Biopharma LLP12
Pidotimod
Aster Biopharma LLP12
Pantoprazole Sodium
Farma Fusion41
Prime Pharmachem102
P. G. Shah & Co.72
Aster Biopharma LLP12
Pantaprazole Sodium IP
Yaksh Pharma46
Sadhana Enterprises61
Pantoprazole Sodium IP/USP
Nishchem International Pvt. Ltd.20
Pantoprazole Sodium Sesquihydrate Ip
Naksha Pharma Nutraceutical Pvt. Ltd.140
Paprika Powder
Konark Herbals & Health CareFront Inside
Paracetamol
Nikeon Corporation 80
Prime Pharmachem102 Unipharma121
Nandlal Bankatlal Pvt. Ltd.Front Cover
Paracetamol Ip/Bp
K. Sevantilal & Co. Back Cover
Paracetamol Ip K. Patel International16
Sohyog Lifesciences162
Paracetamol Ip / Bp / Ep / Usp
Sri Pharmacare125
Paracetamol IP/BP/USP
Ajmera Pharmasure Ltd.15
Para Nitro Chloro Benzene (PNCB)
Yeve Chemicals Industries74
Para Octyl Phenol
Sigma INC95
Para Xylene
Sigma INC95
Paraformaldehyde 91% / 96%
Sigma INC95
Yeve Chemicals Industries74
Paraformaldehyde Acetonimie
Amizara Chemicals157
Paroxetine
Biotech Solutions & Pharmaceuticals Ltd.Front Inside Cover
Paroxetine Hcl
Farma Fusion41
Pazopanib
Dipti Chemicals And Pharmaceuticals37
PCE
Arihant Enterprises81
Pearlising Agent Sles
JKW Chemicals Pvt. Ltd.157
PEG-200 / 400 / 600 / 4000 (Poly Ethylene Glycol)
Sigma INC95
Pg Tech/usp
Yukti Exim107
Penicillin G
Forbes PharmaceuticalsBack Flap Inside
Pentaerythritol
Sigma INC95
Pentaerythritol 3-Mercaptopropionate
Swan Enterprise166
Pepsin Ip.
Nikeon Corporation 80
Per Chloro Ehtylene
Rasayan India85
Amizara Chemicals157
Perchloroethylene (pce)
Yukti Exim107
Perazine Di Malonate
Om Pharmaceutical Industries153
Perchloric Acid 70% AR (For Diamond Industry)
Sigma INC95
Perchloro Ethylene
Sigma INC95
Perfume Solubilizer
ARK Chemical Pvt. Ltd.168
Periodic Acid 50% and 107%
Eskay Iodine Pvt. Ltd.04
Permethrin Liquid
Farma Fusion41
Petroleum Ethers
Memba Chem Industries Pvt. Ltd.98
Petroleum Ethers 40-60/60-80/80-100
Memba Chem Industries Pvt. Ltd.98
Petroleum Ether 400-600c
Research-Lab Fine Chem Industries86
Phenol
AGR Enterprises43
Phenyl Acetic Acid
Forbes PharmaceuticalsBack Flap Inside
Phenyl Concentrate
Memba Chem Industries Pvt. Ltd.98
Phenylbutazone
Biotech Solutions & Pharmaceuticals Ltd.Front Inside Cover
Phenylephrine Hcl Ip
Sadhana Enterprises61
Naksha Pharma Nutraceutical Pvt. Ltd.140
Phenyl Mercuric Acetate 98% Pharma
Grade Confirming To Usp
Research-Lab Fine Chem Industries86
Phenyl Mercuric Nitrate 107% Pharma
Grade Confirming To Bp
Research-Lab Fine Chem Industries86
Phenytoin Sodium / Base
Naksha Pharma Nutraceutical Pvt. Ltd.140
Phospho Tungstic Acid
Helix Multichem121
Phosphoric Acid Amizara Chemicals157 Payal Impex138
Abhinandan Solvchem69
Phosphoric Acid 85% Vinipul Inorganics Pvt.Ltd.9
Phospharic Acid Yukti Exim107
Phosphoric Acid 85% Min Rasayan India85
Phosphorus (P) SML Limited140
Phosphorous Acid Crystal Forbes PharmaceuticalsBack Flap Inside
Phosphorous Oxy Chloride
Forbes PharmaceuticalsBack Flap Inside
Phthalic Anhydro Maleic Anhydride
Rasayan India85
Phenyl Magnesium Bromide
Azeocryst Organics Pvt. Ltd. 75
Phenyl Magnesium Chloride
Azeocryst Organics Pvt. Ltd. 75
Phenylephrine HCL IP
Ariheet Pharmachem LLP 5
Picrorrhiza Kurroa
Konark Herbals & Health CareFront Inside
Pimecrolimus
Yaksh Pharma46
Pimozide Yaksh Pharma46
Pioglitazone
Biotech Solutions & Pharmaceuticals Ltd.Front Inside Cover
Pioglitazone HCI IP
Yaksh Pharma46
Farma Fusion41
Piperacillin + Tazobactum
Yaksh Pharma46
Piperidine
Sigma INC95
Yeve Chemicals Industries74
Piperidine Hydrochloride 107%
Sigma INC95
Piperzine Anhydrous Yeve Chemicals Industries74
Pippali
Konark Herbals & Health CareFront Inside
Pitavastatin calcium
Hap Enterprise74
Piracetam
Medi Pharma Drug House27
Farma Fusion41
Ruskin Chemipharm3
Piracetam EP Oceanic Laboratories Pvt. Ltd44
Piroxicam Bp Naksha Pharma Nutraceutical Pvt. Ltd.140
Platinous Chloride
Research-Lab Fine Chem Industries86
Sky Chem160
Platinum Black Powder
Sky Chem160
Platinum Chloride
Research-Lab Fine Chem Industries86
Platinum Chloride 40% Pt
Sky Chem160
Pthallic Anhydride Yukti Exim107
Platinum Oxide
Research-Lab Fine Chem Industries86
Platinum Oxide Adams Catalyst (Hydrated)
Sky Chem160
Poly Ethylene Glycol (Peg 1500)
Kamlesh Enterprise96
Poly Ethylene Glycol (Peg 200)
Kamlesh Enterprise96
Poly Ethylene Glycol (Peg 400)
Kamlesh Enterprise96
Poly Ethylene Glycol (Peg 4000)
Kamlesh Enterprise96
Poly Ethylene Glycol (Peg 600)
Kamlesh Enterprise96
Poly Ethylene Glycol (Peg 6000)
Kamlesh Enterprise96
Poly Ethylene Glycol (Peg)-200/400/1500/4000
JKW Chemicals Pvt. Ltd.157
Poly Phosphoric Acid 115%
KMED International144
Poly Maleic Acid
ARK Chemical Pvt. Ltd.168
Polyol Yukti Exim107
PolyacrylateComopolymer
ARK Chemical Pvt. Ltd.168
PolyacrylateHomopolymer
ARK Chemical Pvt. Ltd.168
Polyethylene Glycols
ARK Chemical Pvt. Ltd.168
Polymyxin B Sulphate
Medi Pharma Drug House27
Polymyxin B Sulphate Sterile
Ruskin Chemipharm3
Poly Sorbate - 80 USP
Iris IngredientsFront Flap
182 THE MAZADA PHARMA GUIDE
PRODUCTS INDEX
Polysorbate 60/80
Nikeon Corporation 80
Polysorbate(Tween)-20/60/80
JKW Chemicals Pvt. Ltd.157
Polysorbate – 80
V.Pharmachem155
Polysorbate 80 (Sorbox -80 / Twin-80) Ethoxylate
Kamlesh Enterprise96
Polythiols
Swan Enterprise166
Pomegranate Powder
Konark Herbals & Health CareFront Inside
Ponceau 4r Lake
Standardcon Pvt. Ltd.150
Pos Printer
Dhru Enterprises89
Posaconazole
Om Pharmaceutical Industries153
Potassium (K)
SML Limited140
Potassium Sorbate
Abhinandan Solvchem69
Potassium Acetate
Vinipul Inorganics Pvt.Ltd.9
Forbes PharmaceuticalsBack Flap Inside
Potassium Tert. Butanolate
Syrohchem Laboratories Pvt. Ltd.Back Flap
Forbes PharmaceuticalsBack Flap Inside
Potassium Bi Sulphate
Vora Brothers118
Potassium Bromate
Forbes PharmaceuticalsBack Flap Inside
Potassium Bromide
Eskay Iodine Pvt. Ltd.04
Forbes PharmaceuticalsBack Flap Inside
Potassium Bromide IR
Sigma INC95
Potassium Bromide (Ir Spectro)
Research-Lab Fine Chem Industries86
Potassium Carbonate Granular/Powder
Rasayan India85
Potassium Chloride
Vinipul Inorganics Pvt.Ltd.9
Vora Brothers118
Forbes PharmaceuticalsBack Flap Inside
Potassium Chloride (Kcl Salt 107%)
Pooja Enterprise98
Potassium Chloride I.P. / B.P./ U.S.P. / Pure
Pravina Pharma Chem Products150
Potassium Chloroplatinate
Research-Lab Fine Chem Industries86
Sky Chem160
Potassium Chromate
Sigma INC95
Potassium Clavulanate + Avicel IP & Syloid IP
Nishchem International Pvt. Ltd.20
Potassium Ethylate
Syrohchem Laboratories Pvt. td.Back Flap
Potassium Ethylate Solution
Syrohchem Laboratories Pvt. Ltd.Back Flap
Potassium Dichromate
Sigma INC95
Pottasium Humate Flakes
V.Pharmachem155
Potassium Hydroxyquinoline Silphate
Eskay Iodine Pvt. Ltd.04
Potassium Iodate
Forbes PharmaceuticalsBack Flap Inside
Potassium Iodate / Iodide
Eskay Iodine Pvt. Ltd.04
Payal Impex138
Potassium Iodide
Forbes PharmaceuticalsBack Flap Inside
Potassium Iodide – Stabilized
Eskay Iodine Pvt. Ltd.04
Potassium Iodo Bismuthate
Research-Lab Fine Chem Industries86
Potassium Iodoplatinate
Sky Chem160
Potassium Mercuric Iodide
Research-Lab Fine Chem Industries86
Potassium Metabisulphite
Sigma INC95
Potassium Metaperiodate
Eskay Iodine Pvt. Ltd.04
Potassium Nitrate
Cosmic Chemicals100
Forbes PharmaceuticalsBack Flap Inside
Potassium Nitrite
Forbes PharmaceuticalsBack Flap Inside
Potassium Tert. Amylate
Syrohchem Laboratories Pvt. Ltd.Back Flap
Potassium Oxalate
Vora Brothers118
Potassium Permanganate
Sigma INC95 Chemiman72
Potassium Permanganate Crystal
Forbes PharmaceuticalsBack Flap Inside
Potassium Permanganate Powder
Forbes PharmaceuticalsBack Flap Inside
Potassium Silicate
Vora Brothers118
Potassium Stannate
Helix Multichem121
Potassium Sulphate
Vinipul Inorganics Pvt.Ltd.9
Forbes PharmaceuticalsBack Flap Inside
Potassium Tetrachloroplatinate
Sky Chem160
Potassium Thioglycolate
Swan Enterprise166
Synchrom Laboratory Pvt Ltd146
Potassium Tripolyphosphate (Ktpp)
JKW Chemicals Pvt. Ltd.157
Povidone Iodine
Eskay Iodine Pvt. Ltd.04
Povidone Iodine 20%
Eskay Iodine Pvt. Ltd.04
Povidone Iodine IP/USP
Oceanic Laboratories Pvt. Ltd44
Powder Copolymer
ARK Chemical Pvt. Ltd.168
Prasugrel
Biotech Solutions & Pharmaceuticals Ltd.Front Inside Cover
Om Pharmaceutical Industries153
Prasugrel Hydrochloride
Hap Enterprise74
Propylene Carbonate
KMED International144
Praziquantel
Juana Pharma149
Prazosin
Yaksh Pharma46
Pramipexole Dihydrochloride Monohydrate Bp/usp
Om Laboratories26
Pre-Printed Labels
Dhru Enterprises89
Precious Metal
Himalaya & Metalchem Group Of Companies 160
Precious Metal Catalyst (METCTTM BRAND)
Himalaya & Metalchem Group Of Companies 160
Precious Metal Salts
Himalaya & Metalchem Group Of Companies 160
Prednisolone
Ajmera Pharmasure Ltd.15
Prednisolone Acetate
Ajmera Pharmasure Ltd.15
Pregabalin
Hap Enterprise74
Biotech Solutions & Pharmaceuticals Ltd. Front Inside CoverPrime Pharmachem102
Pregabalin IP
Sadhana Enterprises61
K. Patel International16
Om Pharmachem Pvt. Ltd.81
Naksha Pharma Nutraceutical Pvt. Ltd.140
Pregabalin Inn / I. P.
Om Pharmaceutical Industries153
Pregabalin + Methylcobalamine
Biotech Solutions & Pharmaceuticals Ltd.Front Inside Cover
Prednisolone
Medi Pharma Drug House27
Ajmera Pharmasure Ltd.15
Prednisolone Acetate
Hap Enterprise74
Procaine Benzylpenicillin Sterile
Ruskin Chemipharm3
Prochlorperazine Maleate IP/BP/EP/USP
Om Pharmaceutical Industries153
Prochlorperazine Maleate Ip/Bp/Usp
CR Pharma108
Prochlorperazine Mesylate Ip
CR Pharma108
Procyclidine Hcl Ip
Sadhana Enterprises61
Procyclidine Hcl Ip/bp/usp/ihs
Om Laboratories26
Progesterone Ip (Micronized)
Balaji CorporationEar Panel / 97
Progesterone
K. Sevantilal & Co. Back Cover
Progesterone Micronised IP
Nishchem International Pvt. Ltd.20
Progesterone Natural Micronised
Medi Pharma Drug House27
Propionic Acid
Payal Impex138
Yukti Exim107
Propionoldehyde
Yeve Chemicals Industries74
Propionyl Chloride
Yeve Chemicals Industries74
Propylene Glycol
K. Patel International16
Arihant Enterprises81
Neha Enterprises121
Amizara Chemicals157
Kamlesh Enterprise96
Payal Impex138
Propylene Glycol Tech
Rasayan India85
Propylene Glycol Tech / USP
Nikeon Corporation 80
Propylene Glycol Technical
Neha Enterprises121
Propyl Paraben
K. Sevantilal & Co.
Protein Hydrolysates
JKW Chemicals Pvt. Ltd.157
Proteins
K. Sevantilal & Co. Back Cover
JKW Chemicals Pvt. Ltd.157
Prucalopride Succinate
Juana Pharma149
Pseudo-Boehmite
Kailash Marketing Associates148
PTMEG 1000 / 2000
Sigma INC95
Prulifloxacin
Yaksh Pharma46
Punica Grantum
Konark Herbals & Health CareFront Inside
Purazine Anhydrous
Rasayan India85
PVPK25
K. Patel International16
PVPK
Nandlal Bankatlal Pvt. Ltd.Front Cover
PVPK 30
Nikeon Corporation 80
Prime Pharmachem102
Unipharma121
Pvpk 30
Ruskin Chemipharm3
PP Sweet - 200 (Eqv. To Neomalt)
Padmavati Pharmachem5
PP Sweet - 600 (Eqv. To Neosucralose)
Padmavati Pharmachem5
PP Sweet - Export (100 time sweeter), For Cold Drinks
Padmavati Pharmachem5
PP Sweet - NCD(100 time sweeter), For Hot Beverages
Padmavati Pharmachem5
Piracetam
Ruskin Chemipharm3
Paracetamol
Ruskin Chemipharm3
Pipracillin+tazobactam
Ruskin Chemipharm3
Polymixin B Sulphate Sterile
Ruskin Chemipharm3
Procaine Benzylpenicillin Sterile
Ruskin Chemipharm3
Pantaprazole
Ruskin Chemipharm3
Pvpk 30 Ip/Bp/Usp/Ep
Nikeon Corporation 80
PVP K30 (USP26/USP39)
K. Patel International16
PVP K-30 / PVPK-30 USP
Iris IngredientsFront Flap
Pvpk 30/90
AmnemBack Inside Cover
PVPK90
K. Patel International16
Ruskin Chemipharm3
Ariheet Pharmachem LLP5
PVPK - 90 USP
Iris IngredientsFront Flap
PVPK 90 USP26/43 AmnemBack Inside
Pyridine Yeve Chemicals Industries74
Pyridoxine
Nandlal Bankatlal Pvt. Ltd.Front Cover
Pyridoxine Hydrochloride (Vitamin B6)
K. Sevantilal & Co. Back Cover
Pyridine - 20
Forbes PharmaceuticalsBack Flap Inside
Pyridine-2-Carboxaldehyde 107%
Sigma INC95
Quinine Sulphate/Hcl/Dihcl
Hindustan Chemicals & Pharmaceuticals125
Quinoline Yellow Lake Standardcon Pvt. Ltd.150
Quercetin Konark Herbals & Health CareFront Inside
Quetiapine
Biotech Solutions & Pharmaceuticals Ltd.Front Inside Cover
Quetiapine Fumarate Ip Hap Enterprise74 Yaksh Pharma4
Farma Fusion41
Quinine Sulphate Yaksh Pharma46
R-2- Benzhydryl Sulfinyl Acetic Acid
Om Pharmaceutical Industries153
R 3 Boc- Aminopiperidine
Dipti Chemicals And Pharmaceuticals37
Robenidine 10%
Jaysum Biotech77
Rabeprazole
Biotech Solutions & Pharmaceuticals Ltd.Front Inside Cover
Rabeprazole + Domperidone
Biotech Solutions & Pharmaceuticals Ltd.Front Inside Cover
Rabeprazole + Itopride
Biotech Solutions & Pharmaceuticals Ltd.Front Inside Cover
Rabeprazole + Levosulpiride
Biotech Solutions & Pharmaceuticals Ltd.Front Inside Cover
Rabeprazole Sodium Farma Fusion41
Prime Pharmachem102
Juana Pharma149P. G. Shah & Co.64
Racecadotril
Hap Enterprise74 Farma Fusion41
Rafoxanide Yaksh Pharma46
Ramipril IP/BP Yaksh Pharma46
Raney Nickel Catalyst (HIMCTTM BRAND)
Himalaya & Metalchem Group Of Companies 160
Ranolazine INH Yaksh Pharma46
Redivivo Lycopene K. Sevantilal & Co.Back Inside
Refaximine
Hap Enterprise74 Yaksh Pharma46
Resveratrol Konark Herbals & Health CareFront Inside
Resvida K. Sevantilal & Co. Back Cover
Rhodium 5% On Alumina Sky Chem160 Rhodium 5% On Carbon Sky Chem160
Rhodium Trichloride Sky Chem160
Riboflavin Sodium Phosphate Ip Hap Enterprise74
Riboflavin Universal (Vitamin B2) K. Sevantilal & Co. Back Cover
Riboflavin Phosphate Sodium P. G. Shah & Co.72
Rifampicin
Medi Pharma Drug House27
Ruskin Chemipharm3
Rifampicin IP Nishchem International Pvt. Ltd.20
Rifampicin
Ruskin Chemipharm3
Ramipril
Ruskin Chemipharm3
Rocuronium Bromide
Ruskin Chemipharm3
Roxythromycin
Ruskin Chemipharm3
Rifaximin
Biotech Solutions & Pharmaceuticals Ltd.Front Inside Cover
Juana Pharma149
Rifaximin EP / BP
Nishchem International Pvt. Ltd.20
Risedronate Sodium
Biotech Solutions & Pharmaceuticals Ltd.Front Inside Cover
Risperidone
Biotech Solutions & Pharmaceuticals Ltd.Front Inside Cover
Farma Fusion41
Riviera Glasswares Scientific Instruments
Kiran Traders42
Rocuronium Bromide
Ruskin Chemipharm3
Rosuvastatin
Biotech Solutions & Pharmaceuticals Ltd.Front Inside Cover
Aster Biopharma LLP12
Rosuvatatin + Clopidogrel + Aspirin
Biotech Solutions & Pharmaceuticals Ltd.Front Inside Cover
Rosuvastatin Calcium
Hap Enterprise74
Yaksh Pharma46
Medi Pharma Drug House27
Rosuvastatin Calcium Ip
K. Patel International16
Roxarsone 20%
Jaysum Biotech77
Roxithromycin
Medi Pharma Drug House27
Prime Pharmachem102
Rovimix D3 - 500
K. Sevantilal & Co. Back Cover
Rovimix Stay - C K. Sevantilal & Co. Back Cover
Rupatadine Fumrate
Hap Enterprise74
Rupatadine Fumarate Ip
Farma Fusion41
Ruthenium Red
Sky Chem160
Ruthenium Trichloride
Sky Chem160
S-amlodipine besilate
Hap Enterprise74
S.D.Fine
Earth Chemical & Scientific Pvt. Ltd.118
Salbutamol Sulphate
Unipharma121
P. G. Shah & Co.72
THE MAZADA PHARMA GUIDE 183
Back Cover
PRODUCTS INDEX
Farma Fusion41
Torsemide USP
Yaksh Pharma46
Toluene Di Isocynate (toi)
Yukti Exim107
Torsemide IP/BP/USP
Biotech Solutions & Pharmaceuticals Ltd. Front Inside Cover
Triethylene Tetramine
Rasayan India85
Trifluperazine Hcl
Farma Fusion41
Trichloroethylene (tce)
Yukti Exim107
Triehylenetetramine (teta)
Yukti Exim107
Triethanolamine
Yukti Exim107
Trimethylamine
Rasayan India85
Trimethyl Silyl Iodide
Eskay Iodine Pvt. Ltd.04
Trimethyl Sulphoxonium Iodide
Eskay Iodine Pvt. Ltd.04
Trioxsalen Usp
Hap Enterprise74
TSPP-Fg
JKW Chemicals Pvt. Ltd.157
Tween 20/60/80
Abhinandan Solvchem69
Tulsi
Konark Herbals & Health CareFront Inside
Tungstic Acid
Helix Multichem 121
Forbes PharmaceuticalsBack Flap Inside
Tylosin Tartrate
Ruskin Chemipharm3
Tylosin Phosphate 10%
Jaysum Biotech77
TylvalosinTartarate 25%
Jaysum Biotech77
U.D.C.A
Medi Pharma Drug House27
Udca Ip
CR Pharma108
Uracil 98%
V.Pharmachem155
Udenafil Ip/ihs
Om Laboratories26
Ursodeoxicholic Acid Ip
Sadhana Enterprises50
Naksha Pharma Nutraceutical Pvt. Ltd.140
Usodeoxycholic Acid
Biotech Solutions & Pharmaceuticals Ltd.Front Inside Cover
Valporic Acid
Biotech Solutions & Pharmaceuticals Ltd.Front Inside Cover
Valproic Acid Ip
Varahi International 26
Sadhana Enterprises50
Valproic Acid Ip/Bp/Usp
Aster Biopharma LLP12
Valsartan
P. G. Shah & Co.72
Valsartan IP/USP
Salvavidas Pharmaceutical Pvt. Ltd.Ear Panel
Vardenafil Hcl Trihydrate Bp/usp/ph.eur /ihs
Om Laboratories26
Vanadium Pentoxide
Forbes PharmaceuticalsBack Flap Inside
Vancomycin
Ruskin Chemipharm3
Vitamin B 12
Ruskin Chemipharm3
Vitamin B 1 Mono/hcl
Ruskin Chemipharm3
Vitamin B 6
Ruskin Chemipharm3
Vancomycin HCL
Medi Pharma Drug House27
Vanillin
Sigma INC95
Abhinandan Solvchem69
Vinyl Acetate Monomer (VAM)
Abhinandan Solvchem69
Vardenafil
P. G. Shah & Co.72
Vee Gum
American Enterprise120
Veegum f Amnem Back Inside Cover
Veegum hv
AmnemBack Inside Cover
Veegum ultra
Amnem Back Inside Cover
Veg Collagen
Konark Herbals & Health CareFront Inside
Velpatasvir Co Povidine
Dipti Chemicals And Pharmaceuticals37
Venlafaxine Hydrochloride
Om Pharmaceutical Industries153
Ventoclax
Dipti Chemicals And Pharmaceuticals37
Vepowder
Rahul Enterprises131
Verapamil
Yaksh Pharma46
Vildagliptin
Om Pharmaceutical Industries153
Vildagliptin Ihs
CR Pharma108
Vinpocetine
Yaksh Pharma46
Vinyl Bromide Solution-1 M in THF
Sigma INC95
Vinyl Acetate Monomer
Yukti Exim107
Voriconazole
Aster Biopharma LLP12
Vortioxetine HBR
Aster Biopharma LLP12
Vinyl Magnesium Bromide / Chloride
Azeocryst Organics Pvt. Ltd.75
Viriniamycin 10%
Jaysum Biotech77
Vitamins
Siddhambika Impex 142
Vit A Acetate
Nandlal Bankatlal Pvt. Ltd.Front
Vit E 50% (Feed Grade)
Nandlal Bankatlal Pvt. Ltd.Front
Vitamin A Acetate Ip
Sadhana Enterprises50
Vitamin A Palmitate 1.7 (Bha/Bht)
K. Sevantilal & Co.
Vitamin A Palmitate 1.7 (Toco)
K. Sevantilal & Co.
Vitamin A Palmitate 250 Cws
K. Sevantilal & Co.
Vitamin B12 0.1% Ws
K. Sevantilal & Co.
Vitamin D-2
K. Sevantilal & Co.
Vitamin D3 Crystaline
K. Sevantilal & Co.
Vitamin K-1
Back Cover
Back Cover
Ip/ Jp/
Back Cover
K. Sevantilal & Co. Back Cover
Vit D2/D3
Nandlal Bankatlal Pvt. Ltd.Front Cover
Vitamin AD3
K. Sevantilal & Co.
Vitamin A Palmitate
K. Sevantilal & Co.
Vitamin A Palmitate 1.6 / 1.7
Nikeon Corporation
Vitamin AD-3 Powder Feed Grade
Back Cover
Ami Chem125
Vitamin B1 HCL
K. Sevantilal & Co. Back Cover
Medi Pharma Drug House27
Vitamin B1 Hydrocholoride
Prime Pharmachem102
Vitamin B1 Mononitrate
K. Sevantilal & Co.
Back Cover
Medi Pharma Drug House27
Prime Pharmachem102
Vitamin B12
K. Sevantilal & Co.
Back Cover
Medi Pharma Drug House27
Prime Pharmachem102
Vitamin B2
Medi Pharma Drug House27
Vitamin B6
K. Sevantilal & Co. Back Cover
Medi Pharma Drug House27
Prime Pharmachem102
Vitamin B9 (Folic Acid)
V.Pharmachem155
Vitamin C
Medi Pharma Drug House27
Vitamin C Coated
K. Sevantilal & Co.
Vitamin C Plain
K. Sevantilal & Co.
Back Cover
Back Cover
Prime Pharmachem102
Vitamin C Plain (Ascorbic Acid )
V.Pharmachem155
Vitamin D3
Medi Pharma Drug House27
Farma Fusion41
Vitamin E
K. Sevantilal & Co.
Back Cover
Vitamin E 50% Powder Feed Grade Ami Chem125
Vitamin E Acetate
K. Sevantilal & Co.
Cover Nikeon Corporation
Vitamin E Acetate 98 % Nandlal Bankatlal Pvt. Ltd.Front Cover
Vitamin E Acetate (Oily) Medi Pharma Drug House27 Vitamin E Acetate Liquid
Medi Pharma Drug House27
Zinc Bacitracin 10% Jaysum Biotech77
Zinc Carbonate Cosmic Chemicals100
Forbes PharmaceuticalsBack Flap Inside
Zinc Chloride
Vinipul Inorganics Pvt.Ltd.9
Zinc Chloride Anhydrous
Forbes PharmaceuticalsBack Flap Inside
Zinc Hydroxide - Zn(OH)2 SML Limited140
Zinc Nitrate Vora Brothers118 Cosmic Chemicals100
Zinc Oxide
Enterprises131
Impex138
Purchase & Sales Exchange124
Zinc Phosphate Vora Brothers118
Zinc Sulphate
Vinipul Inorganics Pvt.Ltd.9
Zinc Sulphate Cosmic Chemicals100
Impex138
Zinc Sulphate Heptahydrate
Forbes PharmaceuticalsBack Flap Inside
Zinc Sulphate mono Hap Enterprise74
Zinc Sulphate Monohydrate
Forbes PharmaceuticalsBack Flap Inside
Zinc Sulphate-Pharma Grade
Vinipul Inorganics Pvt.Ltd.9
Zinc Stearate
K. Sevantilal & Co. Back Cover
Zoledronic Acid Yaksh Pharma46 Nishchem International Pvt. Ltd.20
Zpto 50% Farma Fusion41
Gum USP
Chemipharm3 Abhinandan Solvchem69
Xanthan Gum Food
AmnemBack Inside Cover
Xylitol Powder Abhinandan Solvchem69
186 THE MAZADA PHARMA GUIDE
Cover
Cover
Back Cover
Back Cover
Back Cover
Back Cover
80
Back
80
Vitamin E Liquid Prime
Vitamin E Liquid
Farma
Vitamin
K. Sevantilal
Yaksh
Sadhana
Voglibose
Ihs Om Laboratories26 Wacker Hdk N20 (Aerosil) Nikeon Corporation 80 Warfarin Sodium Clathrate IP/BP/USP Oceanic Laboratories Pvt. Ltd44 Water (All Grades) Research-Lab Fine Chem Industries86 Water HPLC Sigma INC95 Whatman Filter Papers Kiran Traders42 Whey Protien Concentrate 80% Instant Nikeon Corporation 80 Wide Mouth Jars and Drums Rangoli Plastics Pvt. Ltd.18 Xanthan Gum Nikeon Corporation 80 American Enterprise120 Payal Impex138 Ruskin Chemipharm3 Xantham Gum 200 Mesh Naksha Pharma Nutraceutical Pvt. Ltd.140 Xanthan Gum / Xanthan Gum Transparent Iris IngredientsFront Flap Xanthan Gum Transparent Nikeon Corporation 80 Naksha Pharma Nutraceutical Pvt. Ltd.140 Xylene Research-Lab Fine Chem Industries86 Memba Chem Industries
Zeaxanthin K. Sevantilal
Co. Back Cover Zeolite Forbes PharmaceuticalsBack Flap Inside Zinc Acetate Vinipul Inorganics Pvt.Ltd.9 Vora Brothers118 Cosmic
Neha Enterprises121
Pharmachem102
Ip
Fusion41
K1
& Co.Back Cover
Pharma46
Enterprises50
Pvt. Ltd.98
&
Chemicals100 Zinc Bacitracin
Rahul
Payal
Payal
Xamthn
Amnem Back Inside Cover Xanthan Gum Amnem Back Inside Cover Ruskin
PRODUCTS INDEX
(-)Dip Chloride Chemaroma Drug House 91 (+)Chloro Phenyl Glycine Methyl Ester Tartarate Salt Asiel Chemipharma35 (+/-)-3-Carbamoylmethyl)-5-Methylhexanoicacid Asiel Chemipharma35 (2E)-4-(5Fluoro-2-Hydroxyphenyl)-4-Oxobut-2-Enoic Acid (NEBIVOLOLSTEP-I) Regal Remedies Limited36 2-(methyl Thio)acetamide (intermediate Of Nepafenac) Synchrom Laboratory Pvt Ltd146 2-amino-3-benzoyl Acetamide (intermediate Of Nepafenac) Synchrom Laboratory Pvt Ltd146 (3aR,4S,7R,7aS)-rel-Heahydro-4,7-methano-1H-isoindole-1,3(2H)dione Maruti Industries24 (D-(+)-Methyl-(2-Thienylethamino)2-Chlorophenyl)Acetate Hydrochloride Asiel Chemipharma35 (R)1-[1-(4-Chlorophenyl) Phenylmethyl]Piperazine Asiel Chemipharma35
2,4 Difluoro-1h-1,2,4, Traizole-1- Yi-Acetophenone (Dfta)
Orex Pharma Pvt. Ltd.25
2-Chloro Ethanol
Orex Pharma Pvt. Ltd.25
1-(2-Hydroxyethy) piperazine
Chemino Pharma Ltd94
1- Bromonaphthalene
Qualikems Lifesciences Pvt. Ltd.139
1-Chloro-1-Chloroacetyl Cyclopropane Krishna Solvechem Ltd.21
10Chloro-2-Methoxynaphthalene Inventys58
1,1-Cyclohexane Diacetic Acid
Ram Enterprise 76
131 Oil (All Grades)
Vikram Aromatics144
1,1-Cyclohexanediacetic Acid Mono Amide (CAM) Inventys58
1,1-Cyclohexanediacetic Acid (CDA) Inventys58
1,1’-Carbonyldiimidazole (CDI) Inventys58
1,2 Diphenoxyethane (DPE)
Heni Drugs Pvt. Ltd.49
1,2 Diphenylurea (DPU)
Heni Drugs Pvt. Ltd.49
100mm Printer
Advanced Industrial Micro Systems
8-Line Inkjet Printer
Advanced Industrial Micro Systems
1 Bromo Methyl 1,3 Dixolane
1,2-Di Fluoro Benzene
Regal Remedies Limited36
1,2,3, Benzotrizole (Granule)
Maruti Petrochem55
1,2,3, Benzotrizole (Needle) Maruti Petrochem55
1,2,3 Benzotriazole
1,4 - Butanediol
1,4 Di Bromo Benzene Krishna Solvechem Ltd.21
1,4-Di Fluoro Benzene Regal Remedies Limited36
1,5 Pentanediol Liquid Kip Chemicals Pvt. Ltd.81
1,6- Dibraomohexane
Mody Chemi Pharma Pvt. Ltd.
1,4 Dioxane Relic Chemicals
1,6-Hexanediol Kip Chemicals Pvt. Ltd.81
1-Octene Chemaroma Drug House 91 17a-Hydroxyprogesterone Unitrade Agencies70
2-phenyl-3, 3-bis 4-hydroxyphenyl) phthalimidine (PPPBP) Heni Drugs Pvt. Ltd.49
2-Amino -4-Phenyl Butane
90 Elementos Pvt. Ltd. 104
2 Amino 3,5 Di Bromo Benzyle Alcohol Pacific Biochem Private Limited82
2 Amio 3,5 Di Bromo Benzaldehyde Pacific Biochem Private Limited82
2 Butoxyethyl Ester
Stratechem (I) Pvt Ltd.88
2-Benzoyl Benzoic Acid
Stratechem (I) Pvt Ltd.88
2-Benzoylbenzoicacid Metyl Ester
Stratechem (I) Pvt Ltd.88
2-(Dimethylamino) Ethylbenzoate
Stratechem (I) Pvt Ltd.88
2,2-Dimethoxy-1,2-diphenylethanone
Stratechem (I) Pvt Ltd.88
2-Ethylanthraquinone
Stratechem (I) Pvt Ltd.88
2 Ethyl Hexyl Palmitate
Heni Drugs Pvt. Ltd.49
2 Ethyl Hexyl Oleate
Heni Drugs Pvt. Ltd.49
2 Ethyl Hexyl Stearate
Heni Drugs Pvt. Ltd.49
4- Methyl Benzophenone
Stratechem (I) Pvt Ltd.88
4-(Dimethylamino)-
Stratechem (I) Pvt Ltd.88
4-(Dimethylamino)-benzoic Acid
Stratechem (I) Pvt Ltd.88
4-Chloro Benzophenone
Stratechem (I) Pvt Ltd.88
4-Mercapto Phenol
Stratechem (I) Pvt Ltd.88
4-Phenylbenzophenone
Stratechem (I) Pvt Ltd.88
2 Amino 3,5 Di Bromo Benzoic Acid Methyl Ester
Pacific Biochem Private Limited82
2,4DichloroPhenol
Reenold Enterprises137
2 Ethyl Hexyl Bromide
Pacific Biochem Private Limited82
2 Phenyl Benzimidazole 5 Sulfonic Acid (PBSA) Rare Pharma Pvt. Ltd.148 2,4,6-tribromophenol Pacific Biochem Private Limited82 2-[(2S)-oxiran-2-ylmethyl]-1H-isoindole-1,3(2H)-dione Maruti Industries24 2-(2-Hydroxyphenyl)-4h-1, 3-Benzoxazin-4-One
Asiel Chemipharma35
2,2,4-Trichloro Acetophenone
Krishna Solvechem Ltd.21
2,2-Bipyride 99% Ar
Croma Chemical Corporation106
2-3-Dimercapto-1-Propanol
Croma Chemical Corporation106
2,3,4-Trihydroxybenzaldehyde Shamrock Pharmachem38
2/3/4-Fluoro Acetanilide
Regal Remedies Limited36
2/3/4-Fluoro Aniline
Regal Remedies Limited36
2/3/4-Fluoro Anisole
Regal Remedies Limited36
2/3/4-Fluoro Benzaldehyde
2/3/4-Fluoro Benzoic Acid
2/3/4-Fluoro Benzonitrile
2/3/4-Fluoro Benzoyl Chloride
2/3/4-Fluoro Benzyl Alcohol
2/3/4-Fluoro Benzyl Bromide
2/3/4-Fluoro Benzyl Chloride
2/3/4-Fluoro Benzylamine
Regal Remedies Limited36
2/3/4-Fluoro Bromobenzene
Regal Remedies Limited36
2/3/4-Fluoro Phenyl Acetic Acid
2/3/4-Fluoro Phenyl Acetonitrile
Regal Remedies Limited36
2/3/4-Fluoro Toluene
Regal Remedies Limited36
2,6 Diamino-4-chloro pyrimidine
Shamrock Pharmachem38
2,4-Dichloro 6 Aminophenol Krishna Solvechem Ltd.21
2,4-Dichloro 6 Nitrophenol Krishna Solvechem Ltd.21
2,4-Difluoro Aniline Regal Remedies Limited36
2,4-Difluoro Benzonitrile Regal Remedies Limited36
2,4-Difluoro Bromobenzene
Regal Remedies Limited36
2,4-Difluoro Nitrobezene
Regal Remedies Limited36
2,4-Difluorobenzyl Amine
Regal Remedies Limited36
2,4-Dinitro Fluorobenzene
Regal Remedies Limited36
2,5-Dichloro Thiophene
Zuhhad International
2- Acetyl Thiophene
Zuhhad International
2-Amino-4-methoxy-6-methyl-1,3,5-triazine (AMT)
Inventys58
2-Amino-5-Chlorobenzophenone
Croma Chemical Corporation106
2-Amino-5-Chlorobenzoic Acid (5CTA) Inventys58
2-Amino-5-methylthiophene-3-carbonitrile
Maruti Industries24
2-AminoBenzonitrile (2ABN) Inventys58
2 Benzylpyridine Oceanic Laboratories Pvt. Ltd.44
2- Bromo / 2- Chloro / 2 – Nitro / 2- Acetyl Thiophene
Kip Chemicals Pvt. Ltd.81
2-Bromo-3-Chloropropiophenone
Asiel Chemipharma35 Chemino Pharma Ltd94
2-Bromo-6-methoxynphthalene Inventys58
2-Bromo Thiophene
Zuhhad International 86
2-Butyl-4-Chloro-5-Formyl Imidazole (BCFI)
Synthetic Molecules71
2-Chloro Phenothiazine
Krishna Solvechem Ltd.21
2-chloro 1,3 Bis (Dimethylamino)-Tri Methinium Hexa Fluoro
Phosphate
Regal Remedies Limited36
2-Chloro-5-Bromo-4-Ethoxy Phenyl Methane
Krishna Solvechem Ltd.21
2-Chloro-5-Iodo Benzoic Acid
Krishna Solvechem Ltd.21
2-Chloro Di Phenyl Ether (CDPE) Inventys58
2-Chloro Thiophene
Zuhhad International 86
2-Chloro Thiophenol
Zuhhad International 86
2 Ethyl Hexanoic Acid (Octoic)
Nisha Chemicals71
2-Ethyl Hexanol / Phenol
Apra Enterprises19
Apra Innovative Pvt Ltd19
2 Ethyl Hexyl Acylate
H K Enterprise151
2 Ethyl Hexyl Acrylate (2EHA)
Nisha Chemicals71
2 Ethyl Hexyl Amine (2 EHA)
Krishna Solvechem Ltd.21
2-Ethylhexanoic Acid (2-EHA) / Octoic Acid
Chemstar Global Products LLP76
2-Ethylhexanol (2-EH) / Octanol
Chemstar Global Products LLP76
2 Hema H K Enterprise151
2-Hydroxy-4 Amino Benzoic Acid
Rare Pharma Pvt. Ltd.148
2 Hydroxy Propyl Beta Cyclodextrine
Croma Chemical Corporation106
2-Mercaptobenzimidazole
Krishna Solvechem Ltd.21
2-Mercapto Benzimidazole
Ram Enterprise 76
2-Methoxy-5-Sulfamoyl Methyl Benzoate
Maruti Industries24
2-Methyl Imidazole
Ram Enterprise 76
2-Methyl-10H-thieno [2,3-b][1,5] benzodiazepine-4-amine
Hydrochloride
Maruti Industries24
2-Methyl Resorcinol
Zuhhad International 86
2-Propyl-5-(1-hydroxy-1-methylethyl)-3H-Imidazole-4-Carboxylic acid ethyl ester
Synthetic Molecules71
2 Pyrrolidone
Kip Chemicals Pvt. Ltd.81
2-Thiobarbituric Acid Ar/Acs
Croma Chemical Corporation106
3'3”5'5” Tetrabromophenolphthalein
Heni Drugs Pvt. Ltd.49
3-in-1 UV VIS Khushboo Scientific13
3-Chloro-4-Fluoro Aniline
Regal Remedies Limited36
3,20-Dioxopregna-1,4,9(11)16-Tetraen-21-Yl,Acetate(3tr)
Unitrade Agencies70
3-(4-Chlorophenyl) Glutaric Acid
Synthetic Molecules71 (3'-Chloropropiophenone) Shamrock Pharmachem38
3,4-Diaminotoluene
Zuhhad International 86
3,4-Difluoro Aniline
Regal Remedies Limited36
3,4-Difluoro Benzonitrile
Regal Remedies Limited36
3,4-Difluoro Bromobenzene
Regal Remedies Limited36
3,4-Difluoro Nitrobezene
Regal Remedies Limited36
3,4-Dimethylpyrazole & Phosphate Salt (DMP) Inventys58
3,4-Di Hydro-2h Pyran Chemaroma Drug House91
3,5-Dichlorosalisaldehyde
Ram Enterprise 76
3,5-Difluoro Benzonitrile
Regal Remedies Limited36
3,5-Difluoro Bromobenzene
Regal Remedies Limited36
3,5 Dimethyl Benzoyl Chloride
Asiel Chemipharma35
3,7-Dimethyl-3,7-Dihydro-1H-Purine-2, 6-Dione
Synthetic Molecules71
3-Acetyl Benzotrifluride
Krishna Solvechem Ltd.21
3-Hydroxy Benzaldehyde
Orex Pharma Pvt. Ltd.25
3-Intro Phthalonitrile
Orex Pharma Pvt. Ltd.25
3-Nitro Benzaldehyde
Orex Pharma Pvt. Ltd.25
3-Nitro Phthalic Acid
Orex Pharma Pvt. Ltd.25
3-Bromo Aniline
Krishna Solvechem Ltd.21
3-Chloro-5,6-Dihydro-1-(4-Nitrophenyl)-2-(1h)-Pyridinone
Asiel Chemipharma35
3-Chloroaniline (MCA) Inventys58
3-Ethyl-4-methyl-3-pyrrolin-2-one (EMPO) Inventys58
3 Hydroxy Benzaldehyde
Rare Pharma Pvt. Ltd.148
3 Nitro Benzaldehyde
Rare Pharma Pvt. Ltd.148
4 Aminobenzaldehyde
Oceanic Laboratories Pvt. Ltd.44
4 Amino Benzoic Acid
Rare Pharma Pvt. Ltd.148
4-Bromo-3-Fluoro Aniline
Regal Remedies Limited36
4-(2-Chloroethyl)Morpholine
Orex Pharma Pvt. Ltd.25
4-(2-Hydroxyethyl) Morpholine
Orex Pharma Pvt. Ltd.25
4-(4-aminophenyl) morpholin-3-one
Maruti Industries24
4-4’Difluoro Benzophenone
Regal Remedies Limited36
4,7-Dichloroquinoline
Zuhhad International 86
4-Amino-6-Chlorobenzene-1,3-Disulfonamide
Krishna Solvechem Ltd.21
4-Amino Acetophenone 99%
Croma Chemical Corporation106
4-Amino Salicylic Acid (PAS) Inventys58
4 Benzylpyridine
Oceanic Laboratories Pvt. Ltd.44
4-Bromoanisole
Krishna Solvechem Ltd.21
4-Bromo Benzaldehyde
Pacific Biochem Private Limited 82
4-Bromomethyl-2-Cyanobiphenyl (Bromo OTBN)
AD Pharmachem Pvt Ltd 30
4-Bromophenylaceticacid
Asiel Chemipharma35
4-Chloro-1,8-Naphthalic Anhydride Ram Enterprise 76
4-Chloro-2-Aminophenol Krishna Solvechem Ltd.21
4-Chloro-4-Hydroxy Benzophenone Krishna Solvechem Ltd.21
Asiel Chemipharma35
4-Chloro Benzophenone
Stratechem (I) Pvt. Ltd. 88
4-Chloro Phenoxy Acetic Acid 99%
Ram Enterprise 76
4-Chlorothymol
Asiel Chemipharma35
4-Fluoro Acetophenone
Regal Remedies Limited36
4-Fluoro Aniline
Maruti Petrochem55
4-Fluoro Benzophenone
Regal Remedies Limited36
4-Fluoro-2Bromo Aniline
Regal Remedies Limited36
4-Hydroxy Cumarine Krishna Solvechem Ltd.21
4-Nitrobenzenesulfonyl Chloride
Asiel Chemipharma35
4-Nitrophthalonitrile Krishna Solvechem Ltd.21
5-(Difluoro Methoxy)-2-Mercapto Bezimidazole
THE MAZADA PHARMA GUIDE 187
25
25
(bmd) Pacific Biochem Private Limited 82
Di Bromo 2,2 Di Methoxy Propane Pacific Biochem Private Limited 82 1,3 Di Bromo Propane Pacific Biochem Private Limited 82 1,4 Di Bromo Butane Pacific Biochem Private Limited 82
Hexane
1,3
1,6 Di Bromo
Private Limited 82
Pacific Biochem
Relic Chemicals 82
Chemical Corporation 78
Paresh
47
82
86
86
2,6-Diaminotoluene Zuhhad International
86
Part-2 (19 to 170
PRODUCTS INDEX
Krishna Solvechem Ltd.21
5,5-Dithiobis-2-Nitrobenzoic Acid Ar
Croma Chemical Corporation106
5-5 Dimethyl Hydantoin & Derivatives
Kip Chemicals Pvt. Ltd.81
5 - Acetyl Salicylamide
Kip Chemicals Pvt. Ltd.81
5 - Bromo Indole / 5 - Cyano Indole
Kip Chemicals Pvt. Ltd.81
5-Chloro-8-Hydroxyquinoline
Krishna Solvechem Ltd.21
5-Chloro-4-Amino-2-1-3-Benzothuadizole
Synthetic Molecules71
5-Cyanophthalide
Synthetic Molecules71
5-Methyl 5-Phenyl Hydantion (MPH) Inventys58
5-Nitrosalicylicacid
Asiel Chemipharma35
60+ Protein Fish Meal Powder
SDA Product17
2Phenoxyethanol (cas:122-99-6)
Yuvi Chemz148
6a-Methyl 11 B,17a Dihydroxy-Y-1.4 Diene Pregna 3,20 Dione [P1]
Unitrade Agencies70
6-Benzyl Adenine (6-Ba)
Croma Chemical Corporation106
6-Fluoro-3,4-Dihydro-2H-Benzopyran-2-Carboxylic Acid (NEBIVOLOLSTEP-I)
Regal Remedies Limited 36
6-Fluoro-4-Oxo-3,4-Dihydro-2H-Chromane-2-Carboxylic Acid (NEBIVOLOLSTEP-II)
Regal Remedies Limited 36
80 : 20 - Pectin : Fiber
Labh ingredients152
9, 11b-Epoxide Triamcinolone (5tr)
Unitrade Agencies70
1,3-Dibromo-5,5-Dimethylhydantoin
Mody Chemi Pharma Pvt. Ltd. 47
1,3-Dibromopropane
Mody Chemi Pharma Pvt. Ltd. 47
1,3-Dichloro-5,5-Dimethylhydantoin
Mody Chemi Pharma Pvt. Ltd. 47
1,4-Dibromobutane
Mody Chemi Pharma Pvt. Ltd. 47
1,6-Dibromohexane
Mody Chemi Pharma Pvt. Ltd. 47
1, 4, Dioxane
Mivon Chemicals 28
1-Bromo-3-Chloropropane
Mody Chemi Pharma Pvt. Ltd. 47
2-Amino-3, 5-Di Bromo Benzaldehyde (ADBA)
Rolence Pharma & Chemicals127
2,2-Azobisisobutyronitrile
Mody Chemi Pharma Pvt. Ltd. 47
2-Bromobutane
Mody Chemi Pharma Pvt. Ltd. 47
3- (Trifluoromethyl ) Cinnamic Acid (for Cinacalcet)
Prudence Pharma Chem Ear panel / 81
3-4-Di Hydro-2h Pyran
Chemaroma Drug House 91
3- Carbamoylmethyl-5-methylhexanoic acid (CMH)
Rolence Pharma & Chemicals127
4-(2-aminoethyl)-benzenesufonamide [AEBS For Glipizide]
Prudence Pharma Chem Ear panel / 81
4-Bromo-2,2-Diphenylbutyronitrile
Mody Chemi Pharma Pvt. Ltd. 47
4 Di Methyl AminoPyridine (4DMAP)
Nisha Chemicals71
4 Hydroxy Pyridine 3 Sulfonic Acid of Torsemide
Prudence Pharma Chem Ear panel / 81
4-Hydrazinobenzoic Acid HCL of Deferasirox
Prudence Pharma Chem Ear panel / 81
5.5 Dimethyl hydantion
Mody Chemi Pharma Pvt. Ltd. 47
5 Sulphosalicylic Acid
Indian Platinum Pvt. Ltd.158
7-Ethyl Tryptophol
Synthetic Molecules71
8-Hydroxyquinoline
Reenold Enterprises137
8DM Unitrade Agencies70
Abiraterone
Panchsheel Organics Limited91
ANFD Bags
FiltraTech Solutions India Private Limited 147
Abiraterone Acetate
Balaji Corporation89
Abscisic Acid
Croma Chemical Corporation106
Acacia I.P / B.P (Gum Acacia )
Hritik Chemicals Pvt. Ltd.91
Acamprosate Calcium
Panchsheel Organics Limited91
Acamprosate Calcium Ip/Bp/Usp
Pramukh Pharmachem Pvt. Ltd.80
Acamprosate Calcium Ip/Bp/Usp
Pramukh Pharmachem Pvt. Ltd.80
Acebrophylline
DM Pharma22
Hap Enterprise67
NDC Drug & Chemical Co.Pvt.Ltd. 154
Shriya Pharma & Surgical42
Acebrophylline In-H
Aril Pharmaceuticals6/7
Acefylline Piperzine
Bakul Aromatics and Chemicals Pvt. Ltd.103
Aceclofenac
Parshwa Pharma Chem Pvt. Ltd.40
Nova Chemiie 24
Aara Pharma150
Hap Enterprise67
NDC Drug & Chemical Co.Pvt.Ltd. 154
Kahan Pharmaceuticals 08
Aceclofenac Granules 50%
YSK Laboratories Pvt. Ltd.56
Aceclofenac Ip
Kahan Pharmaceuticals 08
Malay Enterprise167
Aceclofenac IP/ BP
Hritik Chemicals Pvt. Ltd.91
Shriya Pharma & Surgical42
Aceclofenac Ip/Bp/Ep
DM Pharma22
Acefylline
DM Pharma22
Acesulfame K
Malay Enterprise167
Chemkart163
Advance in Organics LLP128
Acetaldehyde
Apra Enterprises19
Apra Innovative Pvt Ltd 19
Acetic Acid
Khushbu Dye Chem Pvt. Ltd.71
Paresh Chemical Corporation 78 Krishna Solvechem Ltd.21
H K Enterprise151
Paras Chem (India)166
Meru Chem Pvt. Ltd.105
Chemstar Global Products LLP76
Maruti Petrochem55 Gandhi Chemicals 144
Thana Acid & Chemical Co145
Acetic Acid 99%
Rajan Dye Chem155
Acetic Acid Glacial Keshariya Corporation80
Mivon Chemicals 28
Apra Enterprises19
Apra Innovative Pvt Ltd 19
Acetone
Meru Chem
Corporation80
Solvechem
Acetyl Amino Acids Chemkart163 Acetyl Bromide
Mody Chemi Pharma Pvt. Ltd.
Acid Fuchsin
Indian Platinum Pvt. Ltd.158
Acid Slurry Paras Chem (India)166
Acid Thickener
Kip Chemicals Pvt. Ltd.81 Dev International158
Acidifier
SDA Product17
Acotamide HCL hydrate
Vinworld Healthcare P. Ltd147
Acridine Orange
Oxford Laboratory Chemicals141
Acriflavine
Kems Raw Pharma93
Acrycoat (Eudragit Equivalent) international drug & chemical co.165
Acrylamide
Nisha Chemicals71
H K Enterprise151
Acrylamide L MDC
Rajan Dye Chem155
Acrylate Copolymer – Liquid / Powder (Thickener)
Kip Chemicals Pvt. Ltd.81
Acrylic Acid
Nisha Chemicals71
Paresh Chemical Corporation 78 Gandhi Chemicals 144
H K Enterprise151
Chemstar Global Products LLP76
Acrylonitrile
Nisha Chemicals71
Paresh Chemical Corporation 78
Acrypol 934/940/971G/980 (Carbopol Equivalent)
international drug & chemical co.165
Acrysol K-152/K-162/EL-135 international drug & chemical co.165
Acyclovir
Shamrock Pharmachem38
Acyclovir IP
Balaji Corporation89
Actidione / Cycloheximide
Croma Chemical Corporation106
Activated Carbon
Chemstar Global Products LLP76
Activated Carbon (150 Mb/280mb)
Riddhi Siddhi Dye Chem 137
Active Dry Yeast
Eklavya Biotech Pvt. Ltd.103
Activated Carbons (Calgon, USA)
Jay Chem Marketing128
Activated Carbon Powder Kems Raw Pharma93 Vipchem Enterprises
Pharma160
Corporation89 Zuhhad International
pharmachem
Chemical Corporation106
188 THE MAZADA PHARMA GUIDE
Pvt. Ltd.105 Keshariya Corporation80 Mivon Chemicals 28 Khushbu Dye Chem Pvt. Ltd.71 Misrimal Pukhraj122 Gandhi Chemicals 144 H K Enterprise151 Chemstar Global Products LLP76 Maruti Petrochem55 Apra Enterprises19 Aceto Cyno hydrine Mody Chemi Pharma Pvt. Ltd. 47 Acetone Cyanohydrin Mody Chemi Pharma Pvt. Ltd. 47 Kip Chemicals Pvt. Ltd.81 Aceclofenac Reenold Enterprises137 Acetonitrile Mivon Chemicals 28 Khushbu
Chem
Ltd.71 Krishna Solvechem Ltd.21 Inventys58 H K Enterprise151 Meru Chem
Ltd.105 Maruti Petrochem55 Apra Enterprises19 Apra Innovative Pvt Ltd19 Acetophenone Mivon Chemicals 28 Paresh Chemical
78 Acid
Keshariya
Aceclofenac Vinworld Healthcare
Chemaroma
91 Krishna
Dye
Pvt.
Pvt.
Corporation
Sullary
P. Ltd147 Acetyl Acetone
Drug House
Ltd.21
47
105
86 Aara
Ayon
168 Adenine Croma
Ademetionine
Butanedisulfonate Unitrade
Adenine Sulphate Croma
Adenosine Croma
Adenosine
Disodium Raivat Impex Pvt. Ltd.59 Adenosine Triphosphate (ATP) Chemkart163 Adenosyl Cobalamine Balaji Corporation89 Adipic Acid Mivon Chemicals 28 Paresh Chemical Corporation 78 Krishna Solvechem Ltd.21 Chemstar Global Products LLP76 Adipic Acid Relic Chemicals82 Biocides Relic Chemicals82 Adrenaline Bitatrate Balaji Corporation89 Adrenochrome Mono Semi Carbazone Ip Balaji Corporation89 Aeroperl® 300 Pharma Kanchan Rasayan 34 Aerosil Keshariya Corporation80 Western Pharma105 Aerosil® 200 Kanchan Rasayan 34 Aerosil® 200 Pharma Kanchan Rasayan 34 Aerosil® 200 V V Pharma Kanchan Rasayan 34 Aerosil® 300 Pharma Kanchan Rasayan 34 Aerosil® R 972 Pharma Kanchan Rasayan 34 Agri Commodities Bombay Test House Private Limited93 Agar Agar (For Microbiology ) Oxford Laboratory Chemicals141 Agarose Oxford Laboratory Chemicals141 Agmatine Sulfate Chemkart163 Air Jet Mill Emco Engineering Pvt. Ltd.161 Alanyl Glutamine Chemkart163 Albendazole Nova Chemiie 24 Western Pharma105 Parshwa Pharma Chem Pvt. Ltd.40 Aara Pharma150 NDC Drug & Chemical Co.Pvt.Ltd. 154 Orex Pharma Pvt. Ltd.25 Albendazole Cp / Ip Crystal Pharma76 Albendazole IP/ BP Hritik Chemicals Pvt. Ltd.91 Albendazole IP/BP/USP Chemino Pharma Ltd94 Albendazole Ip/Usp Kahan Pharmaceuticals 08 Albendazole USP Shamrock61 Albendazole USP Topnotch Chemicals Pvt. Ltd.23 Alcian Blue 8 Gx Oxford Laboratory Chemicals141 Aldehyde To Alcohol Amarjyot Chemical Limited 54 Alendronate Sodium / Acid Nova Chemiie 24 Alfa Calcidol North India Pharma92 Balaji Corporation89 Synthetic Molecules71 Alfodet L46 Kanchan Rasayan 34 Alfodet P46 Kanchan Rasayan 34 Alfodet XL46 Kanchan Rasayan 34 Alfuzosin Balaji Corporation89 Afoxolaner NGL Fine - Chem Limited105 Alginic Acid IP/ BP/ USP Amit Hydrocolloids53 Alginic Acid Labh ingredients152 Alkaline Protease SDA Product17 All Types Of Dry Powders Gautam Pharma Chem84 All Types Of Essential Oils Gautam Pharma Chem84 All Types Of Flavour / Colour / Waxes / Oils Siddhivinayak Pharma160 All Types Of Pharmaceutical Colours Supra / Lake Gautam Pharma Chem84 Allantoin Kip Chemicals Pvt. Ltd.81 Alogliptin Calyx Chemical & Pharmaceuticals Ltd.23 Allopurinol Hap Enterprise67 Nova Chemiie 24 Parshwa Pharma Chem Pvt. Ltd.40 Vinworld Healthcare P. Ltd147 NDC Drug & Chemical Co.Pvt.Ltd. 154 All type of Amino Acid international drug & chemical co.165 Aloe Butter CSV Pharmaceuticals India Pvt. Ltd.169 Anethole Oil CSV Pharmaceuticals India Pvt. Ltd.169 Ashwagandha Extract CSV Pharmaceuticals India Pvt. Ltd.169 Allopurinol IP/ BP Hritik Chemicals Pvt. Ltd.91 Alloxan Monohydrate Arnish Laborates Pvt. Ltd.103 Allura Red Lake Amaranth Lake Standardcon Pvt. Ltd.150 Allyl Bromide
Adapalene Siddhivinayak
Balaji
Pharma162
1,4 -
Agencies70
Chemical Corporation106
Chemical Corporation106
Triphosphate
PRODUCTS INDEX
Mody Chemi Pharma Pvt. Ltd. 47
Krishna Solvechem Ltd.21
Pacific Biochem Private Limited82
Alkyl Bromide
Pacific Biochem Private Limited82
Allyl Estrenol
Balaji Corporation89
Allyl Chloride
Rumit Group Of Companies78
Almond Oil
Global Merchants25
Aloe Vera Extract
Global Merchants25
Aloevera Gel
Gautam Pharma Chem84
Aloevera Powder
Gautam Pharma Chem84
Shree Raj Chem84
Alpha Amylase (1:2000) Ip
Jakson Pharma104
Alpha Pinene
Vikram Aromatics144
Alpha Beta Arteether
Nova Chemiie 24
DM Pharma22
Alpha Keto Analogue
international drug & chemical co.165
Alpha Beta Arteether Ip / Bp / Usp
Balaji Corporation89
Alpha-Galactosidase
Asiel Chemipharma35
Alpha Gpc
Raivat Impex Pvt. Ltd.59
Alpha Lipoic Acid
Malay Enterprise167
Aara Pharma150 Chemkart163
Raivat Impex Pvt. Ltd.59
Alpha Lipoic Acid Usp 28/30
Shriya Pharma & Surgical42
Alpha Methyl Styrene
Krishna Solvechem Ltd.21
Alpha Naphthol (AN) Inventys58
Alphacalcidol
Siddhivinayak Pharma160
Luconic Chemicals103
AlbendazolePlain/Microniosed
Reenold Enterprises137
Alphox 200 Maruti Petrochem55
Alphox Products Dev International158
Alprazolam
Neha Pharma Pvt. Ltd.165
Alprazolam Ip
Aril Pharmaceuticals6/7
Alum
Keshariya Corporation 80
Aluminum Chloride
Mody Chemi Pharma Pvt. Ltd. 47
Ashapura Intermediates 119
Aluminium Hydroxide Paste
Kems Raw Pharma93
Aluminium Hydroxide Paste IP / BP / USP
Gangotri Inorganic (P) Ltd.18
Aluminium Hydroxide Dried GelIp/bp/usp/ep/technical
Elite Chemicals89
Aluminum Hydroxide Paste
Western Pharma105
Aluminium Magnesium Silicate IP / BP / USP
Gangotri Inorganic (P) Ltd.18
Aluminium Potassium Sulphate (Potassium Alum)
Kronox Lab Sciences Limited218
Aluminium Sterate
Kems Raw Pharma93
Aluminium Sulphate
Kronox Lab Sciences Limited218
Alluminium Sulphate (Non Ferric)
Riddhi Siddhi Dye Chem137
Aluminum Ammonium Sulfate (Ammonium Alum)
Kronox Lab Sciences Limited 218
All types of Water Soluble Fertilizers
Chemizo Enterprise166
Alum Powder
Riddhi Siddhi Dye Chem137
Alpha Lipoic Acid
Dazzle Corporation88
Aripiprazole
Dazzle Corporation88
Atarvastatin Calcium
Dazzle Corporation88
Ambroxol
NDC Drug & Chemical Co.Pvt.Ltd. 154
Shriya Pharma & Surgical42
Ammonium Acetate
Advance in Organics LLP128
Ammonium thioglycolate
Synchrom Laboratory Pvt Ltd146
Ammonium Acetate
Vinipul Chemicals Pvt. Ltd.31
Ammonium Chloride
Vinipul Chemicals Pvt. Ltd.31
Ammonium Acetate
Advance in Organics LLP128
Ammonium Oxalate
Vinipul Chemicals Pvt. Ltd.31
Ammonium Sulphate
Vinipul Chemicals Pvt. Ltd.31
Ambroxol HCl - BP/USP
Progress Life Sciences Pvt. Ltd.29
Ambroxol Hcl
Nova Chemiie 24
Parshwa Pharma Chem Pvt. Ltd.40
DM Pharma22
Shamrock Pharmachem38
Ambroxol Hcl IP/BP
Hritik Chemicals Pvt. Ltd.91
Ambroxol Hcl IP/BP/USP
Malay Enterprise167
Amiodarone
Panchsheel Organics Limited91
Amino Acid
Powder Pack Chem 129
Shreenath Chemicals82
Aminophylline
Bakul Aromatics and Chemicals Pvt. Ltd.103
Ammoniated Mercury
Heni Drugs Pvt. Ltd.49
Amisulpiride International Drug & Chemical Co.165
Aril Pharmaceuticals6/7
Amisulpride Ip/Bp/Ep
Diligent Life Care38
Amitraz
Ngl Fine Chem Ltd. 105
Amitraz Ip/Bp/Ep
Diligent Life Care38
Amitriptyline
Luconic Chemicals103
NDC Drug & Chemical Co.Pvt.Ltd. 154
Amitriptyline Hcl Ip/Bp
Aril Pharmaceuticals6/7
Amitraz IP
Crystal Pharma76
Amlodipine
Maruti Industries24
Amlodipine Granules 1.8%, 3.33%
YSK Laboratories Pvt. Ltd.56
Ammonium Bromide Powder
Pacific Biochem Private Limited82
Amlodipine Besilate Ip
Kahan Pharmaceuticals 08
Amlodipine Base
Prudence Pharma Chem Ear Panel / 81
Amlodipine Besylate Nova Chemiie 24 NDC Drug & Chemical Co.Pvt.Ltd. 154
Amlodipine Besylate Ip/Bp
Prudence Pharma Chem Ear Panel / 81
Aril Pharmaceuticals6/7
Hritik Chemicals Pvt. Ltd.91
Ammonium Acetate
Kronox Lab Sciences Limited218
Ammonium Benzene Sulfonate
Stratechem (I) Pvt. Ltd. 88
Ammonia Alum Lumps
Ammonium Sulphate (Technical)
Riddhi Siddhi Dye Chem
Ammoniated Mercury
Heni Drugs Pvt. Ltd.49
Ammonium Bi Carbonate
Kronox Lab Sciences Limited218
Ammonium Bi Carbonate (ABC) Krishna Solvechem Ltd.21
Ammonium Bifluoride
Regal Remedies Limited36
Ammonium Bromide
Mody Chemi Pharma Pvt. Ltd. 47
Ammonium Carbonate
Kronox Lab Sciences Limited218
Ammonium Cerium Nitrate
Indian Platinum Pvt. Ltd.158
Ammonium Cerium Sulphate
Indian Platinum Pvt. Ltd.158
Ammonium Chloride Siddhivinayak Pharma160 Sheetal Chem
Ashapura Intermediates 119
Meru Chem Pvt. Ltd.105
Ashapura Intermediates119
Ammonium Chloride ACS
Rare Pharma Pvt. Ltd.148
Ammonium Chloride Ip/Bp/Pure
Pravina Pharma Chem Products150
Ammonium Chloroplatinate
Indian Platinum Pvt. Ltd.158
Ammonium Iodide SVG Pharma Lifesciences Pvt. Ltd.145
Ammonium Molybdate
Indian Platinum Pvt. Ltd.158
Kronox Lab Sciences Limited218
Anti-Histaminie
Calyx Chemical & Pharmaceuticals Ltd.23
Anti-Hypertensive
Calyx Chemical & Pharmaceuticals Ltd.23
Anti-Fungal
Calyx Chemical & Pharmaceuticals Ltd.23
Ammonium Phosphate
Kronox Lab Sciences Limited218
Ammonium Phosphate (Dibasic)
Qualikems Lifesciences Pvt. Ltd.139
AmmoniumThiocyanate
Reenold Enterprises137
Ammonium Phosphate (Monobasic)
Qualikems Lifesciences Pvt. Ltd.139
Ammonium Sulfate
Kronox Lab Sciences Limited218
Ammonium Sulphate
Regent Chemicals 41
Ashapura Intermediates 119
Misrimal Pukhraj122
Qualikems Lifesciences Pvt. Ltd.139
Ashapura Intermediates119
Ammonium Sulphate - Pure & Byproduct
Ashapura Intermediates119
Ammonium Molybdate
Yuvi Chemz148
Amoxycillin IP Malay Enterprise167
Amodiaquine Vinworld Healthcare P. Ltd147
Amorofline
Balaji Corporation89
Aara Pharma150
Amoxycillin Sodium
Espee Pharma Chem Pvt. Ltd.94
Amoxycillin Trihydrate Bp/Ip Comp
Shriya Pharma & Surgical42
Amoxicillin Trihyddate Compacted & Non Compacted
Unitrade Agencies70
Ammonium Chloride (Technical)
Riddhi Siddhi Dye Chem137
Ampicillin Sodium Oral / Sterile
Espee Pharma Chem Pvt. Ltd.94
Amoxicillin Sodium Sterile
Nova Chemiie 24
Ampicillin Plain/Comp/Sterile
Nova Chemiie
Ampicillin Trihyddate Compacted & Non Compacted
Unitrade Agencies70
Amprolium Chemstar Global Products LLP76
Amprolium Hcl Bp
Crystal Pharma76
Amylase
Asiel Chemipharma35
Amyris Oil
Aditi Essentials51
Analgesic Chemical Matrix166
Analytical Khushboo Scientific13
Aniline Oil
Thana Acid & Chemical Co145
Anastrazole
Balaji Corporation89
Anhydrous Hydrogen Chloride
Dev International158
Anidulafungin Balaji Corporation89
Animal Pancreatain(Ip/Bp/Usp)
Asiel Chemipharma35
Animal Food & Feed Bombay Test House Private Limited93
Anisole
Stratechem (I) Pvt. Ltd. 88 Chemstar Global Products LLP76
Anthranitic Acid Dev International158
Anthrone Lr/ Ar Oxford Laboratory Chemicals141 Anti Asthmatic
THE MAZADA PHARMA GUIDE 189
101
24
Chemical
Anti Chloinergic Chemical
Anti Coagulants Chemical
Anti Emitic Chemical
Anti Epileptic Chemical
Anti Fungal Chemical Matrix166 Anti Histamine Chemical Matrix166 Anti Inflammatory Chemical
Anti Osteoporosis Chemical
Anti-Ozone Softener Kip Chemicals Pvt. Ltd.81 Anti Parkinson Chemical Matrix166 Anti Retroviral Chemical Matrix166 Anti Ulcer Chemical Matrix166 Anti Viral Chemical Matrix166 Anti-Biotic Chemical Matrix166 Antidepressant Chemical Matrix166 Antidiabetic Chemical Matrix166 Anti-Gout Chemical Matrix166 Antifouling Agents Krishna Antioxidants Pvt. Ltd.87 Antimalarials Chemical Matrix166 Antimony Iodide SVG Pharma Lifesciences Pvt. Ltd.145 Antiobsessional Drug Chemical Matrix166 Antiulceratives Chemical Matrix166 Antioxidants/Stabilizers Krishna Antioxidants Pvt. Ltd.87 Antistatic Agent Krishna Antioxidants Pvt. Ltd.87 Anti-Malarial Calyx Chemical & Pharmaceuticals Ltd.23 Anti-Retroviral Calyx Chemical & Pharmaceuticals Ltd.23 Anti-Tubercular Calyx Chemical & Pharmaceuticals Ltd.23 Anyddrous Aluminium Chloride Dev International158 Atomoxetine HCL Tivan Sciences Pvt. Ltd.40 AOS Liquid Kanchan Rasayan 34 AOS Needle Kanchan Rasayan 34 AOS Paste Kanchan Rasayan 34 AOS Powder Kanchan Rasayan 34 APG- Alkyl Polyglucoside Kip Chemicals Pvt. Ltd.81 Aprepitant Pellets Panchsheel Organics Limited91 Aquaculture Fish Meal SDA Product17 ARA 10% Chemkart163 Arachis Oil Siddhivinayak Pharma 160 Arbutin & Creatinine North India Pharma92 Argan Oil Global Merchants25 Aripiprazole Jay Chem Marketing128 Aril Pharmaceuticals6/7 Hap Enterprise67 NDC Drug & Chemical Co.Pvt.Ltd. 154 Arteether Balaji Corporation89 Artemether Panchsheel Organics Limited91 Nova Chemiie 24 Hap Enterprise67 Vinworld Healthcare P. Ltd147 Aara Pharma150 DM Pharma22 NDC Drug & Chemical Co.Pvt.Ltd. 154 Artemether IP/BP/USP Espee Pharma Chem Pvt. Ltd.94 Western Pharma105 Artemether IP/PHI - Anti Material Topnotch Chemicals Pvt. Ltd.23 Aromatic Bromide / Intermediate Pacific Biochem Private Limited82 Artemether INT Ph. / USP
Matrix166
Matrix166
Matrix166
Matrix166
Matrix166
Matrix166
Matrix166
PRODUCTS INDEX
Malay Enterprise167
Artesunate
Espee Pharma Chem Pvt. Ltd.94
Nova Chemiie 24
Aara Pharma150
DM Pharma22
Artesunate Sterile
Balaji Corporation89
Arthritic Chemical Matrix166
Articaine Hydrochloride IP/BP/USP/EP
Chemino Pharma Ltd94
Articaine HCl
Shamrock Pharmachem38
Ascorbic Acid
Keshariya Corporation80
Krishna Solvechem Ltd.21
Ascorbic Acid (Vitamin C)
Raivat Impex Pvt. Ltd.59
Ascorbic Acid Ip/Bp/Ep/Usp DM Pharma22
Ascorbic Acid (Vit C ) Plain / Coated
Dev International158
Ascorbyl Palmitate (AP)
Chemstar Global Products LLP76
Ashwagandha Extract
Global Merchants25
Asphaltene Dispersants
Krishna Antioxidants Pvt. Ltd.87
Aspartame FCC/USP
Malay Enterprise167
Aspartame Advance in Organics LLP128
Aspartame
Aara Pharma150 Chemkart163
Astaxanthin 10% Chemkart163
Astaxanthin 10% Powder
North India Pharma92
Ascorbic Acid BP/EP/USP Chemizo Enterprise166
Atenolol
Vinworld Healthcare P. Ltd147
Atenolol Ip/Bp
Aril Pharmaceuticals6/7
Atomoxetane Hcl
Parshwa Pharma Chem Pvt. Ltd.40
Tivan Sciences Pvt. Ltd.40
Atorvastatin Calcium
NDC Drug & Chemical Co.Pvt.Ltd. 154
Atorvastatin
Maharshee Laboratories Pvt. Ltd. 133
Atrovastatin Calcium Ip
Shriya Pharma & Surgical42
Atorvastatin Calcium IP/BP
Hritik Chemicals Pvt. Ltd.91
Atorvastatin Calcium Ip/Usp
Aril Pharmaceuticals6/7
Atorvastatin Calcium Crystalline Ip/Bp/Ep/Usp
DM Pharma22
Atovaquone
Ngl Fine Chem Ltd. 105
Atropine Sulphate
Aril Pharmaceuticals6/7
Atropine Sulphate Ip
Aril Pharmaceuticals6/7
Attapulgites (IP / BP / USP Eq.)
Suraiya Private Ltd.93
Avobenzone
Siddhivinayak Pharma160
Ayurvedic Products
Gautam Pharma Chem84
Auto Bottle Labeling
Advanced Industrial Micro Systems 25
Azaamine Unitrade Agencies70
Azacytidine Balaji Corporation89
Azathioprine
Panchsheel Organics Limited91
Azithromycin Amine
Unimax Group 20
Azithromycin
Kahan Pharmaceuticals 08
Azelnidine
Vinworld Healthcare P. Ltd147
Azilsartan international drug & chemical co.165
Azithromycin
Vinworld Healthcare P. Ltd147
Rumit Group Of Companies78
Azithromycin Dihydrate
Unimax Group 20
Azithromycin Dihydrate (Taste Masked Powder)
Unimax Group 20
Azithromycin IP Dev Pharmaceuticals 164
Azithromycin IP/BP
Hritik Chemicals Pvt. Ltd.91
Azithromycin Ip/Ep/Usp
Shriya Pharma & Surgical42
Azithromycin IP / USP Malay Enterprise167
Azithromycin Dihydrate
Nova Chemiie 24
Azithromycin Monohydrate
Unimax Group 20
Azithromycin Trihydrate
Unitrade Agencies70
Azithromycin premix for suspension
Unimax Group 20
Azur A & B
Oxford Laboratory Chemicals141
B. H. A / B. H. T Crystal Pharma76
B. K. C (Sol.)
Crystal Pharma76
B.H.A
Siddhivinayak Pharma160
B.H.T
Siddhivinayak Pharma160
B A M H K Enterprise151
Bacillus Clausii 200B Spores/g
90 Elementos Pvt. Ltd. 104
Bacillus Coagulans 200B Spores/g
90 Elementos Pvt. Ltd. 104
Bacteriological Incubator Kesar Control Systems49
Bacillus Linchemiformis Feed Grade
Rosetta Life Care Private Limited14
Bacillus Substilis Feed Grade
Rosetta Life Care Private Limited14
Bacillus Species 200B Cfu/g
90 Elementos Pvt. Ltd. 104
Baclofen
Panchsheel Organics Limited91
NDC Drug & Chemical Co.Pvt.Ltd. 154
Dazzle Corporation88
Benzocaine Dazzle Corporation88
Baclofen Ip
Aril Pharmaceuticals6/7
Shriya Pharma & Surgical42
Barbituric Acid
Arnish Laborates Pvt. Ltd.103
Barium Bromide
Qualikems Lifesciences Pvt. Ltd.139
Barium Carbonate ACS
Rare Pharma Pvt. Ltd.148
Barium Carbonate
Qualikems Lifesciences Pvt. Ltd.139
Barium Chloride
Qualikems Lifesciences Pvt. Ltd.139
Barium Chromate
Qualikems Lifesciences Pvt. Ltd.139
Bakery Enzyme
Enzyme Bioscience57
Barium Nitrate
Qualikems Lifesciences Pvt. Ltd.139
Basic Fuchsin
Oxford Laboratory Chemicals141
BCAA 2:1:1/4:1:1/8:1:1/3:2:1
Chemkart163
BCDMH- Bromo Chloro Dimethyl Hydantoin Powder
Kip Chemicals Pvt. Ltd.81
Bees Wax
Malay Enterprise167
Beclomethasone Di Propionate
Nova Chemiie
Beclomethasone Di Propionate Ip Hiten Pharma Chem152
Beclomethasone Dipropionate IP/ BP/USP
Hritik Chemicals Pvt. Ltd.91
Beclomethasone Ip Kahan Pharmaceuticals
Beclomethasone Propionate
Balaji Corporation89
Bees Wax Western Pharma105
Balaji Corporation89
Flora Dye Chem
Kems Raw Pharma93
Behentrimonium Chloride 93% pellet form
Kip Chemicals Pvt. Ltd.81
Behenyl Alcohol – C 22 H K Enterprise151
Belachwin
Dev International158
Belladona Green Verdis Paste
Kems Raw Pharma93
Benedipine HCL International drug & chemical co.165
Balaji Corporation89
Nova Chemiie
Benfotiamine
Vinworld Healthcare P. Ltd147
Drug & Chemical Co.Pvt.Ltd.
Chemino Pharma Ltd94 Shamrock Pharmachem38
Reenold Enterprises137
Bellow FBDB (Bohle)
FiltraTech Solutions India Private Limited
Benfotiamine IH
Nira Life Sciences Pvt. Ltd.25
DM Pharma22
Benfotiamine IHS
Hritik Chemicals Pvt. Ltd.91
Beclomethasone Dipropionate Unimax Group
Rumit Group Of Companies78
Pinene Vikram Aromatics144 Beta-3 Adrenergic Agonist
Chemical & Pharmaceuticals Ltd.23 Betamethasone Dipropionate
Group
Rumit Group Of Companies78 Betamethasone Rumit Group Of Companies78
Benfothiamine Malay Enterprise167
Chem
IP/ BP
Chemicals Pvt. Ltd.91
Powder
Pharma Chem84 SDA Product17 Benzalkonium Chloride 50% Kanchan Rasayan
Chemicals102
Chem Pvt. Ltd.105
International158 Benzalkonium Chloride 50% & 80% Chemizo Enterprise166 Benethonium Chloride (BTC) Inventys58
Benzocaine
Benzalkonium Chloride 50-80% soln.
Chemz148
Benzethonium Chloride (Eq.USP/EP gr.) Yuvi Chemz148
Benzophenone (oxybenzone )
Chemical Corporation
Chemstar Global Products LLP76 Kronox Lab Sciences Limited218
Benzoic Acid Ip
Siddhivinayak Pharma160
Phenyl Ethyl Amine Synthetic Molecules71
Product17
HCL Tivan Sciences Pvt. Ltd.40
Beta Carotene Powder/oil CSV Pharmaceuticals India Pvt. Ltd.169
Black Pepper Oleoresins
CSV Pharmaceuticals India Pvt. Ltd.169
Boswellia Serrata Akba
CSV Pharmaceuticals India Pvt. Ltd.169
Bromelain (Pineapple)
CSV Pharmaceuticals India Pvt. Ltd.169
Betahistine Di Hcl Ip
Shriya Pharma & Surgical42
Beta Naphthol (BN) Inventys58
Beta Nicotinamide Adenine Dinucleotide
Croma Chemical Corporation106
Beta Nicotinamide Mononucleotide (NMN)
Raivat Impex Pvt. Ltd.59
Beta-Nicotinamide Mononuclotide (NMN) Chemkart163
Betahistine Di Hcl Ip
Aril Pharmaceuticals6/7
Betahistin Di Hcl IP/ BP Hritik Chemicals Pvt. Ltd.91
Betain Anhydrous (Feed Grade 105%)
Crystal Pharma76
Betaine Anhydrous
Raivat Impex Pvt. Ltd.59
Betaine HCL Chemkart163
Betain Hcl Usp Crystal Pharma76
Bempedoic Acid Tivan Sciences Pvt. Ltd.40
Betamethsone
Unitrade Agencies70
Rumit Group Of Companies78
Betamethasone Plain
Vinworld Healthcare P. Ltd147
Betamethasone Di Propionate
190 THE MAZADA PHARMA GUIDE
24
08
126
24
154
NDC
147
20
Beta
Unimax
20
Calyx
Sheetal
101 Bentonite
34
34 Benzayldehyde
Dev
Benzene Mivon
28 Khushbu
Maruti Petrochem55 Benzene Seleninic Anhydride Zuhhad International 86 Benzene Sulfonic Acid Stratechem (I) Pvt. Ltd. 88 Benzene Sulphonic Acid Sunraj Chemical co.144 Benzene Sulfonyl Chloride Stratechem (I) Pvt. Ltd. 88 Benzil Alchol
Benzoate
Bentonite
Hritik
Bentonite
Gautam
Benzalkonium Chloride 80% Kanchan Rasayan
Amita
Meru
Chemicals
Dye Chem Pvt. Ltd.71
Siddhivinayak Pharma160 Benzil
Siddhivinayak Pharma160 Benzoate
NDC Drug & Chemical Co.Pvt.Ltd. 154 Shamrock Pharmachem38
Yuvi
Amita
Nova
24
Siddhivinayak Pharma160 Benzoic Acid
Chemicals102 Ketan Chemical Corporation119
Chemiie
Paresh
78
Jay
Gbl
Gbl
Benzoic
Gbl
Benzoic
BP Hritik Chemicals Pvt. Ltd.91 Benzophenone Hydrazone Chemaroma Drug House 91 Benzotriazole Chemstar Global Products LLP76 Benzoyl Chloride 99% + Purity Meru Chem Pvt. Ltd.105 Benzyl Acetate Ketan Chemical Corporation119 Benzyl Salicylate Rare Pharma Pvt. Ltd.148 Benzyl Acetate / Alcohol / Chloride Meru Chem Pvt. Ltd.105 Benzyl Alcohol Ketan Chemical Corporation119 Mivon Chemicals 28 H K Enterprise151 Dev International158 Maruti Petrochem55 Benzyl Benzoate Ketan Chemical Corporation119 Dev International158 Chemaroma Drug House 91 Benzonitirle Chemaroma Drug House 91 Benzophenone Hydrazone Chemaroma Drug House 91 Benzyl Bromide Mody Chemi Pharma Pvt. Ltd. 47 Benzyl Chloride Ketan Chemical Corporation119 Dev International158 Benzalkonium chloride – BKC 50% & 80% Kip Chemicals Pvt. Ltd.81 Benzal dehyde Mivon Chemicals 28 Benzophenone 3 & 4 Kip Chemicals Pvt. Ltd.81 Benzoyl chloride Mivon Chemicals 28 Benzoic Acid Mivon Chemicals 28 Benzyl Cyanide Mody Chemi Pharma Pvt. Ltd. 47 Benzyl Isoeugenol Chemstar Global Products LLP76 Bepotastine Besilate Sheetal Chem 101 Beta Alanine Chemkart163 Beta Alanine Raivat
Beta
Beta
Crystal
North
Beta
Jay
Beta
Beta
SDA
Betahistine
NDC Drug
Betahistine
Chem Marketing128 Benzoate Plasticizer For Specialty Uses
Chemical Limited73 Benzoic Acid I.P. (Bp / Usp / Food Grade)
Chemical Limited73
Acid Tech (Commercial Grade)
Chemical Limited73
Acid IP/
Impex Pvt. Ltd.59
Carotene 10% Chemkart163
Caroten 10,20,30%
Pharma76
India Pharma92
Cyclo Dextrin
Chem Marketing128
Glucanase
Di Hcl
& Chemical Co.Pvt.Ltd. 154
PRODUCTS INDEX
Balaji Corporation89
Nova Chemiie 24
Kahan Pharmaceuticals 08
Betamethasone Di Propionate Ip
Hiten Pharma Chem152
Betamethasone Dipropionate IP/BP/ USP
Hritik Chemicals Pvt. Ltd.91
Betamethasone Plain Ip
Hiten Pharma Chem152
Betamethasone Salts
Aara Pharma150
Betamethasone Sodium Phosphate
Balaji Corporation89
Vinworld Healthcare P. Ltd147
Nova Chemiie 24
Hritik Chemicals Pvt. Ltd.91
Unimax Group 20
Rumit Group Of Companies78
Betamethasone Valerate
Nova Chemiie 24
Unimax Group 20
Rumit Group Of Companies78
Betamethasone Valerate IP/BP/USP
Balaji Corporation89
Hritik Chemicals Pvt. Ltd.91
Betasterol
Panchsheel Organics Limited91
BHA / BHT
Malay Enterprise167
Nisha Chemicals71
Bhel Kuta Mix Dry Fish
SDA Product17
Bicalutamide
Panchsheel Organics Limited91
Bifnozole Bp/Ep
DM Pharma22
Bilastine Vinworld Healthcare P. Ltd147
Chemino Pharma Ltd94
Bilberry Extract North India Pharma92
Bile Salt Kems Raw Pharma93
Bile Extrac Powder
Eklavya Biotech Pvt. Ltd.103
Bilirubin
Oxford Laboratory Chemicals141
Bifonazole
Maharshee Laboratories Pvt. Ltd. 133
Bilirubin 106% Miniumum
Croma Chemical Corporation106
Bimatoprost
Balaji Corporation89
Aara Pharma150
Brinzolamide
Bakul Aromatics and Chemicals Pvt. Ltd.103
Binding Agents
Krishna Antioxidants Pvt. Ltd.87
Bio Chemicals Powder Pack Chem 129
Bio –yucca Ethoxyquin
U.K. Vet Chem65
Biological Buffers
Oxford Laboratory Chemicals141
Biosuper
S.A.I. Products132
Bismuth Nitrate Pentahydrate
Heni Drugs Pvt. Ltd.49
Bismuth Subgallate BP/EP/USP
Bismuth Subsalicylate BP/EP/USP
Bismuth Subnitrate USP/BPC 73
Heni Drugs Pvt. Ltd.49
Biotin
Malay Enterprise167 Chemkart163
NDC Drug & Chemical Co.Pvt.Ltd. 154
Biotin 2% (Feed Grade)
Crystal Pharma76
Biotin USP
Aara Pharma150
Bismuth Citrate USP
Heni Drugs Pvt. Ltd.49
Biowin Dev International158
Biperiden Hcl
Jay Chem Marketing128
Biphenyl
Zuhhad International 86
Bisacodyl
Nova Chemiie 24
Bismuth Citrate-USP
Heni Drugs Pvt. Ltd.49
Bisacodyl Propanolol
Espee Pharma Chem Pvt. Ltd.94
Bismuth All Salts
Croma Chemical Corporation106
Bismuth Carbonate
Qualikems Lifesciences Pvt. Ltd.139
Bismuth Citrate
Kronox Lab Sciences Limited218
Bismuth Nitrate
Indian Platinum Pvt. Ltd.158
Bismuth Nitrate Pentahydrate
Qualikems Lifesciences Pvt. Ltd.139
Bismuth Oxide
Indian Platinum Pvt. Ltd.158
Heni Drugs Pvt. Ltd.49
Bismuth Oxychloride
Indian Platinum Pvt. Ltd.158
Qualikems Lifesciences Pvt. Ltd.139
Heni Drugs Pvt. Ltd.49
Bismuth Subcarbonate
Kronox Lab Sciences Limited218
Bismuth Subgallate
Qualikems Lifesciences Pvt. Ltd.139
Bismuth Subgallate-BP,EP,USP
Heni Drugs Pvt. Ltd.49
Bismuth Subnitrate
Kronox Lab Sciences Limited218
Qualikems Lifesciences Pvt. Ltd.139
Bismuth Subnitrate-BP,USP
Heni Drugs Pvt. Ltd.49
Bismuth Subsalicylate
Indian Platinum Pvt. Ltd.158
Bismuth Subsalicylate-BP,EP,USP
Heni Drugs Pvt. Ltd.49
Bismuth Sulphate
Qualikems Lifesciences Pvt. Ltd.139
Bismuth Sulphite
Elementos Pvt. Ltd.
Bisphenol-A
Nisha Chemicals71
Paresh Chemical Corporation
H K Enterprise151 Relic Chemicals82
BIS Tri T Butylphosphine Pd Indian Platinum Pvt. Ltd.158 Bis Triphenyl Phosphine Pdo Indian Platinum Pvt. Ltd.158
BKC
Peroxide
Blended Lakes Apple / Pea Green / Black / Brown Lake Standardcon Pvt. Ltd.150 Blending Filtromix Equipments LLP149
Agents
Antioxidants Pvt. Ltd.87 Blower Plastic Fabricators59 Bmd (Bacitracin Methylene)10% Crystal Pharma76
Boldenone Undecylenate
Panchsheel Organics Limited91
Bone Meal SDA Product17
Bonnet FBDB
Solutions India Private Limited
Borax – Penta / Deca – Imported
Ashapura Intermediates 119
Borax Decahydrate
Qualikems Lifesciences Pvt. Ltd.139
Borex Sodium Borate
Kronox Lab Sciences Limited218
Boric Acid
Ashapura Intermediates 119
Misrimal Pukhraj122
Qualikems Lifesciences Pvt. Ltd.139
Kronox Lab Sciences Limited218
Boric Acid - INDIAN MAKE
Ashapura Intermediates119
Boron Amino Acid Chelate
Eklavya Biotech Pvt. Ltd.103
Boron Citrate
Labh ingredients152
Bovine Collagen
Eklavya Biotech Pvt. Ltd.103
Brain Heart Infusion Powder
Eklavya Biotech Pvt. Ltd.103
Boric Acid IP
Arco Pharma126/164
Boric Acid IP/ BP
Hritik Chemicals Pvt. Ltd.91
Boron – 10.5% & 20%
Ashapura Intermediates
Boron Tri Fluoride in Acetic Acid
Regal Remedies Limited36
Boron Trifluoridein Acetic Acid/Ether/THF
Regal Remedies Limited36
Boron Tri Fluoride in Ether
Regal Remedies Limited36
Bosentan Monohydrate
Nova Chemiie 24
Boswellia Extract
Global Merchants25
Bovine Colostrum Powder
North India Pharma92
BOD Avi Scientific (India)168
BOD Incubator
Kesar Control Systems49
Bottle Filling
Advanced Industrial Micro Systems 25
Brilliant Blue Fcf Lake
Standardcon Pvt. Ltd.150
Brivaracetam
Unimax Group
Broken Rice
SDA Product17
Bromelain Nova Chemiie
Bromofenac Sodium Reenold Enterprises137
Bromelain 2800 Gdu North India Pharma92
Brimonidine Tartrate
Aara Pharma150
Bromhexine HCl- IP/BP/USP
Progress Life Sciences Pvt. Ltd.29
Bromelain
Asiel Chemipharma35
Bromelain 1200 Gdu Jakson Pharma104
Bromelain 2400 Gdu Jakson Pharma104
Bromo Benzene
Mody Chemi Pharma Pvt. Ltd. 47 Pacific Biochem
Bromhexine Hcl
Biochem Private Limited82
Bromoform
Biochem Private
THE MAZADA PHARMA GUIDE 191
Indian
Bisoprolol
Panchsheel Organics Limited91 Nova
24 Ayon
168 Bifidobacterium
90
104
Platinum Pvt. Ltd.158
Fumarate
Chemiie
pharmachem
Species 200B Cfu/g
78
50% Kanchan Rasayan 34 Bkc - 50% Mivon Chemicals 28 BKC 50% / 80% Meru Chem Pvt. Ltd.105 BKC 80% Kanchan Rasayan 34 Black Current
North India Pharma92 Black
Black
Global
Black Rise Extract North India Pharma92 Global Merchants25 Bleaching Earth Vipchem Enterprises 105 Bleaching Agents Krishna Antioxidants Pvt. Ltd.87 Bleaching Powder Keshariya
Ashapura
119 Paras
Extarct
Seed Oil Kamakhya ImpexFlap
Pepper Extract 103 %
Merchants25
Corporation80
Intermediates
Chem (India)166 Benzoyl
HK Group76
Blocking
Krishna
147
FiltraTech
119
20
24
Private Limited 82
Parshwa
DM
NDC Drug
Chemical Co.Pvt.Ltd. 154 Orex
Pharma Chem Pvt. Ltd.40
Pharma22
&
Pharma Pvt. Ltd.25
Pacific
Bromination Reaction
Pacific
Limited82
Hcl Ip Hap Enterprise67 Bromhexine HCL IP/BP Hritik Chemicals Pvt. Ltd.91
Pharma & Surgical42
Intermediate Pacific Biochem Private
Benzene Krishna Solvechem
Bronopol SDA Product17 Bronopol IP Siddhivinayak Pharma160 Buddhawood Oil Aditi Essentials51 Budesonide DM Pharma22 Hritik Chemicals Pvt. Ltd.91 Buffer Capsule 4,7,& 9.2 Qualikems Lifesciences Pvt. Ltd.139 Buffered Lactic Acid Nisha Chemicals71 Buffers Full Range Croma Chemical Corporation106 Bulyraldehyde Kip Chemicals Pvt. Ltd.81 Bupivacaine HCl Shamrock Pharmachem38 Buparvaquone Ngl Fine Chem Ltd. 105 Buprenorphine HCL Neha Pharma Pvt. Ltd.165 Panchsheel Organics Limited91 Bupropion Hcl Nova Chemiie 24 Maharshee Laboratories Pvt. Ltd. 133 Bupropion Hydrochloride USP Chemino Pharma Ltd94 Buserelin Balaji Corporation89 Bushes, Beakers, Magnetic Needles B.J. Scientific Co. 162 Buster Packing Advanced Industrial Micro Systems 25 Butaconazole Nitrate Balaji Corporation89 Butaphosphan Ngl Fine Chem Ltd. 105 Butyl Acetate Mivon Chemicals 28 Khushbu Dye Chem Pvt. Ltd.71 Gandhi Chemicals 144 H K Enterprise151 Maruti Petrochem55 Apra Enterprises19 Butyl Acetate / Alcohol Meru Chem Pvt. Ltd.105 Butyl Acetate Intact Nisha Chemicals71 Butyl Acrylate Paresh Chemical Corporation 78 Butyl Acrylate Monomer (BAM) Apra Enterprises19 Apra Innovative Pvt Ltd 1919 Butyl Amines Krishna Solvechem Ltd.21 Butyl Carbitol Mivon Chemicals 28 Khushbu Dye Chem Pvt. Ltd.71 Nisha Chemicals71 Paresh Chemical Corporation 78 Butyl Carbitol Acetate Paresh Chemical Corporation 78 Butyl Cellosolve Mivon Chemicals 28 Khushbu Dye Chem Pvt. Ltd.71 Paresh Chemical Corporation 78 Butyl Cellosolve / Ethyl Cellosolve Apra Enterprises19 Apra Innovative Pvt Ltd 19 Butyl Cellosolve Acetate Paresh Chemical Corporation 78 Apra Innovative Pvt Ltd 19 Butyl Cellsole/Carbitol Amita Chemicals102 Butyl Di Glycol Acetate Ketan Chemical Corporation119 Apra Enterprises19 Butyl Paraben Dev International158 Butalated Hydroxy Toulene Relic Chemicals82 Butyl Methoxy Dibenzoyl Methane Siddhivinayak Pharma160 Butylated Hydroxy Anisole Nisha Chemicals71 Chemstar Global Products LLP76 Dev International158 Kronox Lab Sciences Limited218 Butylated Hydroxy Toluene Nisha Chemicals71 Ketan Chemical Corporation119 Chemstar Global Products
Dev International158 Kronox Lab Sciences
Krishna Antioxidants
Global
Shree
Caffeine Bakul
Cabergoline Balaji
C. T.
15%
Crystal
Cadmium Carbonate Qualikems Lifesciences
Qualikems
Bromhexine
Shriya
Bromohexine
Limited82 Bromo
Ltd.21
LLP76
Limited218 Butylated Octylated Diphenylamine
Pvt. Ltd.87 Chemstar
Products LLP76 C-16-18 Ethoxylate
Vallabh Chemical48
Aromatics and Chemicals Pvt. Ltd.103
Corporation89
C
(Granular)+
Pharma76
Pvt. Ltd.139 Cadmium Chloride Monohydrate
Lifesciences Pvt. Ltd.139
PRODUCTS INDEX
Cadmium Iodide
SVG Pharma Lifesciences Pvt. Ltd.145
Qualikems Lifesciences Pvt. Ltd.139
Cadmium Nitrate Tetrahydrate
Qualikems Lifesciences Pvt. Ltd.139
Cadmium Sulphate 8/3 Hydrate
Qualikems Lifesciences Pvt. Ltd.139
Caffeine Anhydrous
Nova Chemiie 24
Caffine Citrate
Kems Raw Pharma93
Calamine
Kronox Lab Sciences Limited218
Cariprazine HCL
Tivan Sciences Pvt. Ltd.40
Calamine IP
Hritik Chemicals Pvt. Ltd.91
Calamine Powder
Kems Raw Pharma93
Cetamicragoal 1000 - IHS
Arjun Beeswax Industries169
Cetostearyl Alcohol - IP / BP / USP / EP
Arjun Beeswax Industries169
Cocoa Butter - UPS
Arjun Beeswax Industries169
Calcidol
Siddhivinayak Pharma160
Calcipotriol Anhydrous Synthetic Molecules71
Calcipotriol Monohydrate Synthetic Molecules71
Calcitriol
North India Pharma92
Shree Raj Chem76
Balaji Corporation89
Synthetic Molecules71
NDC Drug & Chemical Co.Pvt.Ltd. 154
Calcium Acetate
Qualikems Lifesciences Pvt. Ltd.139
Kronox Lab Sciences Limited218
Calcium thioglycolate trihydrate
Synchrom Laboratory Pvt Ltd146
Calcium Acetate
Advance in Organics LLP128
Calcium D Pantothenate
Raivat Impex Pvt. Ltd.59
Calcium Hypophosphited-biotin
U.K. Vet Chem65
Calcium Acetate
Eklavya Biotech Pvt. Ltd.103
Calcium Carbonate
HK Group76
Calcium Hypophosphited-biotin
U.K. Vet Chem65
Calcium Acetate (Ep / Bp/ Usp)
Kronox Lab Sciences Limited218
Calcium Aspartate
North India Pharma92
Calcium Alginate
Calcium Citrate Malate
Calcium CMC
Calcium CMC
Labh ingredients152
Calcium Bromide
Mody Chemi Pharma Pvt. Ltd. 47
Krishna Solvechem Ltd.21
Calcium Butyrate
Eklavya Biotech Pvt. Ltd.103
Calcium Bis Glycinate
Navnidh Pharma lab84
Calcium Carbonate
Western Pharma105
DM Pharma22
Sheetal Chem 101
SDA Product17
Kems Raw Pharma93
Keshariya Corporation80
Kronox Lab Sciences Limited218
Vipchem Enterprises 105
Calcium Carbonate / Chloride / Sulphate
Meru Chem Pvt. Ltd.105
Calcium Carbonate Activated / Coated
Gangotri Inorganic (P) Ltd.18
Calcium Carbonate IP/ BP
Hritik Chemicals Pvt. Ltd.91
Calcium Carbonate (Ppt)
Riddhi Siddhi Dye Chem 137
Calcium Carbonate Natural / Calcite
Gangotri Inorganic (P) Ltd.18
Calcium Carbonate Oyster
Gangotri Inorganic (P) Ltd.18
Calcium Carbonate Precipited IP / BP / USP / EP / JP / FCC
Gangotri Inorganic (P) Ltd.18
Calcium Carbonate Precipited Ultra Pure
Kronox Lab Sciences Limited218
Calcium Carbonate PPT I.P./B.P./U.S.P.
Elite Chemicals89
Calcium Carbonate (Oyester Shell)
Shree Raj Chem76
Vinworld Healthcare P. Ltd147
Calcium Carbonate Precipitated / Oyster Shell
Gautam Pharma Chem84
Calcium Chloride
SDA Product17
Misrimal Pukhraj122
Calcium Chloride (Prills / Powder)
Pari Chemicals136
Calcium Amino Acid Chelate
Eklavya Biotech Pvt. Ltd.103
Calciumcarbonate Havy/Light
Reenold Enterprises137
Calcium Chloride – All Grades
Ashapura Intermediates 119
Calcium Chloride - Prills, Powder & Lumps
Ashapura Intermediates119
Calcium Chloride Anhydrous Pure
Kronox Lab Sciences Limited218
Calcium Chloride Dihydrate
Kronox Lab Sciences Limited218
Calcium Chloride Group
Dev International158
Calcium Chloride Powder
Dev International158
Riddhi Siddhi Dye Chem 137
Calcium Chloride (Fues) Aarti Make
Riddhi Siddhi Dye Chem 137
Calcium Chloride Special Grade (Bromide Free)
Kronox Lab Sciences Limited218
Calcium Citrate
Kronox Lab Sciences Limited218
Advance in Organics LLP128
Calcium Citrate Malate
North India Pharma92
Advance in Organics LLP128
Calcium CMC IP/ BP / USP / EP
Amit Hydrocolloids53
Calcium D Panthoernate
Dev International158
Calcium-d-penthenoate (Feed Grade)
Gautam Pharma Chem84
Calcium D Pantothenate (CDP)
Malay Enterprise167
Calcium D Pantothenate (Vitamin B5) Chemkart163
Calcium D Pantothenate Ip/Usp
Crystal Pharma76
Calcium-D-Saccharate
Zuhhad International 86
Kems Raw Pharma93
Calcium Dobesilate Ep
North India Pharma92
Calcium Fluoride
Regal Remedies Limited36
Calcium Gluconate
Kronox Lab Sciences Limited218
Calcium Gluconate BP/USP
Vinworld Healthcare P. Ltd147
Calcium Gluconate I.P/ Technical
Keshav Hichem Pvt. Ltd.
Citric Acid Monohydrate / Anhydrous
Keshav Hichem Pvt. Ltd.
Citric Acid Monohydrate / Anhydrous IP / BP
Arco Pharma126/164
HK Group76
Citric Acid Mono / Anydrous
Om Pharma Chem48
Citric Acid - Mono / Anhydrous
Ashapura Intermediates119
Calcium Hydroxide BP/ USP
Hritik Chemicals Pvt. Ltd.91
Calcium Hydroxide B.P./U.S.P. / E.P / J.P
Elite Chemicals89
Calcium Hydroxide BP / USP / EP / JP / FCC
Gangotri Inorganic (P) Ltd.18
Calcium Hypophosphite
Kems Raw Pharma93
Kronox Lab Sciences Limited218
Calcium Iodate
SVG Pharma Lifesciences Pvt. Ltd.145
Calcium Iodide
DM Pharma22
Calcium Iodide Hydrate
SVG Pharma Lifesciences Pvt. Ltd.145
Calcium-L-Glutamate
Ram Enterprise 76
Calcium Lactate
Siddhivinayak Pharma160
Nisha Chemicals71
DM Pharma22
Kronox Lab Sciences Limited218
Calcium Lysinate
Navnidh Pharma lab84
Calcium Orotate
North India Pharma92
Calcium Oxide IP/BP
Hritik Chemicals Pvt. Ltd.91
Calcium Oxide USP / JP / FCC
Gangotri Inorganic (P) Ltd.18
Calcium Peroxide
Crystal Pharma76
Calcium Phosphate Di Basic Anhydrous
Kronox Lab Sciences Limited218
Calcium Phosphate Di Basic Dihydrate
Kronox Lab Sciences Limited218
Calcium Phosphate Tribasic
Kronox Lab Sciences Limited218
Calcium Propionate
Crystal Pharma76
SDA Product17
Meru Chem Pvt. Ltd.105
Calcium Propionate
Eklavya Biotech Pvt. Ltd.103
Calcium Propionate (CP) - Feed Grade
Chemstar Global Products LLP76
Calcium Salts
Shreenath Chemicals82
Calcium Silicate
Kanchan Rasayan 34
Calcium Sulphate
SDA Product17
Kronox Lab Sciences Limited218
Calcium Thiogluconate
Vinworld Healthcare P. Ltd147
Calendula Extract
Global Merchants25
Calendula Oil
Kamakhya ImpexFlap
Camphor Usp/Bp
Siddhivinayak Pharma160
Canagliflozin – INH
Progress Life Sciences Pvt. Ltd.29
Candelilla Wax
Flora Dye Chem 126
Canthaxanthin North India Pharma92
CAPB
Kanchan Rasayan 34
Capric Acid
Siddharth International101
H K Enterprise151
Capric Caprylic Acid
H K Enterprise151
Caprylic Acid And Albendazole
U.K. Vet Chem 65
Caproic Acid
Siddharth Internationa137
H K Enterprise151
Caprolactam
Chemizo Enterprise166
Caprylic Acid
Siddharth International101
H K Enterprise151
Capsaicin Powder
DM Pharma22
Caprylic Capric Triglyceride Oil (CCTG/Mct Oil/GTCC)
Heni Drugs Pvt. Ltd.49
Capsicum Oleoresin 8% Liquid North India Pharma92
Capsicum Oleoresin
CSV Pharmaceuticals India Pvt. Ltd.169
Cardamom Oleoresin
CSV Pharmaceuticals India Pvt. Ltd.169
Castor Oil
CSV Pharmaceuticals India Pvt. Ltd.169
Caramel IP
Hritik Chemicals Pvt. Ltd.91
Carrageenan Gum
Advance in Organics LLP128
Caroverine international drug & chemical co.165
Caramel Liquid Shree Chemicals117
Carmine
Oxford Laboratory Chemicals141
Carbamezapine Aara Pharma150
Carbamazepine Ip/Bp/Ep/Usp DM Pharma22
Carbamazepine IP/IH/BP/EP/USP
90 Elementos Pvt. Ltd. 104
Carbamazepine - IP/BP/USP/EP Oceanic Laboratories Pvt. Ltd.44
Carbamide Peroxide Kronox Lab Sciences Limited218
Carbidopa international drug & chemical co.165
Carbidopa Ip
Shriya Pharma & Surgical42
Carbomer 940/971 P All Grade Dev International158
Carbomers Series – Rheology Modifier
Kip Chemicals Pvt. Ltd.81
Carbon Teltrachloride Dev International158
Carbonyl Iron (Tab. /Susp. Grade) North India Pharma92
Carboprost Balaji Corporation89
Carboxymethyl Cysteine (Carbocisteine) Panchsheel Organics Limited91
Carboxymethyl Guar Gum Labh ingredients152
Caustic Soda / Caustic Potash
192 THE MAZADA PHARMA GUIDE
21
21
Nova
Croma
Carmoisine
Carnauba
Flora
126 Carnauba Wax Substitute / ( Lip Formula) Flora Dye Chem 126 Candelilla Wax - USP Arjun Beeswax Industries169 Carnauba Wax - IP/BP / USP / EP Arjun Beeswax Industries169 Carprofen NGL Fine - Chem Limited105 Castor Oil Ethoxylate Shree Vallabh Chemical48 Ceresin Wax - IHS Arjun Beeswax Industries169 Carnosine Chemkart163 Carvedilol NDC Drug & Chemical Co.Pvt.Ltd. 154 Caryophyllene Chemstar Global Products LLP76 Caryophyllene Acetate Chemstar Global Products LLP76 Caspofungin Acetate Balaji Corporation89 Cassin Protin Hydrolystae Powder 60% Kems Raw Pharma93 Cassine Protin Hydrolysate Powder 80% Kems Raw Pharma93 Castor Meal SDA Product17 Castor Oil
Hydrogenated Castor Oil Dev International158 Castor Wax Flora Dye Chem 126 Casein Modern Dairies39 Casein Eklavya Biotech Pvt. Ltd.103 Casein Peptone Eklavya Biotech
Calcium Citrate USP J R Drugchem Pvt.
Inside Cover Catechol Chemstar Global Products LLP76 Caustic Potash Mivon Chemicals 28 Khushbu Dye Chem Pvt. Ltd.71 Caustic Potash Flakes Keshariya Corporation80 Mivon Chemicals 28 Malay Enterprise167 H K Enterprise151 Rajan Dye
Dev
Potash
Meru
Group Dev
Carica Papaya Leaf Dry Extract 40% DM Pharma22 Carisoprodol
Chemiie 24 Carmine 60% Dye Content
Chemical Corporation106
Lake Standardcon Pvt. Ltd.150
Wax IP,BP, Prime Yellow
Dye Chem
/
Pvt. Ltd.103
Ltd.Back
Chem155
International158 Caustic
Flakes / Pellets
Chem Pvt. Ltd.105 Caustic Potash
International158
Dev
Dev
Caustic Potash Lye
International158 Caustic Soda
International158
Misrimal
Maruti
Caustic Soda Flakes Keshariya Corporation80 Mivon Chemicals 28 Malay
H K
Paras
Dev
Khushbu
Pukhraj122 Caustic Soda / Potash Flakes
Petrochem55
Enterprise167
Enterprise151
Chem (India)166
International158 Rajan Dye Chem155 Caustic Soda Flakes (Bag)
Dye Chem Pvt. Ltd.71 Caustic Soda Flakes / Prills / Pellets
PRODUCTS INDEX
Meru Chem Pvt. Ltd.105
Caustic Soda Group
Dev International158
Caustic Soda Lye
Dev International158
Caustic Soda Prills
Dev International158
Causticising & Mercerising Agents
Krishna Antioxidants Pvt. Ltd.87
CDEA
Kanchan Rasayan 34
CDT-Phosphate Of Etoricoxib
Prudence Pharma Chem Ear Panel / 81
Ceatomacrogol Emulsifying Wax BP
Flora Dye Chem 126
Cedarwood Oil
Aditi Essentials51
Cefaclor
Vinworld Healthcare P. Ltd147
Cefaclor USP (Powder/ Compacted)
Vinworld Healthcare P. Ltd147
Cefadroxil
Vinworld Healthcare P. Ltd147
Cefadroxil BP/USP/IP (Powder / Compacted)
Vinworld Healthcare P. Ltd147
Cefalexin Compacted Cefadroxil
Nova Chemiie 24
Cefaperazone Sodium Sterile
Nova Chemiie 24
Cefdinir
Vinworld Healthcare P. Ltd147
Cefepime Hcl IP/BP/USP
Espee Pharma Chem Pvt. Ltd.94
Cefexime Trihydrate
Vinworld Healthcare P. Ltd147
Cefixime IP / USP
Malay Enterprise167
Cefixime Trihydrate Compacted
Nova Chemiie 24
Cefixime Trihydrate Compacted IP/ USP
Hritik Chemicals Pvt. Ltd.91
Cefixime Trihydrate Ip (Compacted)
Shriya Pharma & Surgical42
Cefixime Trihydrate IP/BP/USP
Espee Pharma Chem Pvt. Ltd.94
Cefprodoxime Proxetil
Nova Chemiie 24
Cefuroxime Axetil
NDC Drug & Chemical Co.Pvt.Ltd. 154
Vinworld Healthcare P. Ltd147
Cefuroxime Axetil Amorphous
DM Pharma22
Cefuroxime Axetil Amorphous Ip
Shriya Pharma & Surgical42
Cefuroxime Axetil IP
Malay Enterprise167
Cefpirome Sulphate
Espee Pharma Chem Pvt. Ltd.94
Cefpodoxime Proxetil
Espee Pharma Chem Pvt. Ltd.94
Cefpodoxime Proxetil Compacted IP/BP/USP
Hritik Chemicals Pvt. Ltd.91
Cefpodoxime Proxetil IP
Malay Enterprise167
Cefpodoxime Proxitel (Micro/ Compacted)
Vinworld Healthcare P. Ltd147
Ceftazidime Sodium Sterile
Espee Pharma Chem Pvt. Ltd.94
Ceftriaxone Sodium IP/USP
Vinworld Healthcare P. Ltd147
Ceftriaxone Sodium Sterile
Espee Pharma Chem Pvt. Ltd.94
Nova Chemiie 24
Vinworld Healthcare P. Ltd147
Ceftriaxone Sodium Sterile Usp/Ip
Shriya Pharma & Surgical42
Cefuroxime Amorphous Axetil IP/BP
Hritik Chemicals Pvt. Ltd.91
Cetyl Alcohol - IP / BP / USP / EP
Arjun Beeswax Industries169
Cefuroxime Axetil
Espee Pharma Chem Pvt. Ltd.94
Celecoxib
Prudence Pharma Chem Ear Panel / 81
Nova Chemiie 24
DM Pharma22
NDC Drug & Chemical Co.Pvt.Ltd. 154
Chemino Pharma Ltd94
Cellulase
SDA Product17
Asiel Chemipharma35
Cellulose Acetate Bp/Ep/Usp
G. M. Chemie Pvt. Ltd.143
Cellulose Acetate Pthalate
Kems Raw Pharma93
Cellulose Acetate Phthalate (Ip/Bp/Usp/Ep/Jp)
G. M. Chemie Pvt. Ltd.143
Cellulose Acetate Trimellitate
G. M. Chemie Pvt. Ltd.143
Cement, Concrete & Building Materials
Bombay Test House Private Limited93
Cephalexin
Vinworld Healthcare P. Ltd147
Unitrade Agencies70
Cephalexin (Plain / Compacted) IP/BP
Vinworld Healthcare P. Ltd147
Ceracin Wax
Flora Dye Chem 126
Cereal Maize
SDA Product17
Cerebro Protin Powder
Kems Raw Pharma93
Ceresene Wax
Flora Dye Chem 126
Ceresine Ozokerite Wax
Flora Dye Chem 126
Cerium Hydrate
Cerium
Platinum Pvt. Ltd.158
Laboratories Pvt.
Alchol
Chloride (Quaternary)
Chemz148
Trimethyl Ammonium Chloride Yuvi Chemz148
Cetosteryl Alcohol / Cetyl Alchohol
International158
Stearyl Alcohol – C 1618
Cetyl Alcohol – C 16 H K Enterprise151
Cetyl Bromide Krishna Solvechem Ltd.21
Pacific Biochem Private Limited 82
Cetyl Chloride Krishna Solvechem Ltd.21
Cetylpyrinium Chloride (CPC) Yuvi Chemz148 Cetyl Esters Wax
For Cosmetic Ind
Chemicals For Feed Ind. Powder Pack Chem129
Chemicals & Solvents
Rajan Dye Chem155
Chemical & Water Storage Tanks
Plastic Fabricators59
Chemical Powder Sanjay Enterprises143 Chickpeas SDA Product17 Chinese Tree Wax
Dye Chem
Chloramine - T
Crystal Pharma76
Chlor Pheniramine Maleate Ip/ Bp/ Usp
Siddhivinayak Pharma160
Chromium Picolinate - IP/USP
Oceanic Laboratories Pvt. Ltd.44
Chromium Polynicotinate
Oceanic Laboratories Pvt. Ltd.44
Chlomipramine Hcl NDC Drug & Chemical Co.Pvt.Ltd. 154
Chloranilic Acid
Arnish Laborates Pvt. Ltd.103
Chlordizepoxide Ip Aril Pharmaceuticals6/7
Chlorhexidine Base.
Zuhhad International 86
Chlorhexidine Gluconate 20%
Zuhhad International 86
Chlorinated Paraffin Dev International158
Chlorine Dev International158
Clobazam
Calyx Chemical & Pharmaceuticals Ltd.23
Chlorpheniramine Maleate NDC Drug & Chemical Co.Pvt.Ltd.154
Pheniramine Maleate-IP/BP/USP/EP
Oceanic Laboratories Pvt. Ltd.44
Chlorpromazine Hcl Ip/Bp
Aril Pharmaceuticals6/7
Chloramphenicol Powder Bp
Crystal Pharma76
Chlordizepoxide
Luconic Chemicals103
Chlorella Powder
North India Pharma92
Chloro Acetyl Chloride
Krishna Solvechem Ltd.21
Chloro Benzenes Krishna Solvechem Ltd.21
Chloroacetyl Chloride Krishna Solvechem Ltd.21
Choloform Gandhi Chemicals 144
Chloroauric Acid
Indian Platinum Pvt. Ltd.158
Chlorobutanol Hemihydrate
Progress Life Sciences Pvt. Ltd.29
Chloramphenicol Palmitate I.P. / B.P. / U.S.P.
Rati Pushp Intermediates Pvt. Ltd.37
Choline Salts
Shreenath Chemicals82
Chlorodiazepoxide
Panchsheel Organics Limited91
Chloroform Mivon Chemicals 28
Khushbu Dye Chem Pvt. Ltd.71
Chemstar Global Products LLP76 Dev International158
Maruti Petrochem55
Chloromethane Group Dev International158
Chloroquine Phosphate
Parshwa Pharma Chem Pvt. Ltd.40
Chlorosulphonic Acid Sunraj Chemical co.144
Chlorthalidone Ip Aril Pharmaceuticals6/7
Chloramine T Trihydrate Arnish Laborates Pvt. Ltd.103
Chlorpheniramine Maleate DM Pharma22
Chlorpheniramine Maleate / DEX CPM
Siddhivinayak Pharma160
Chlorpheniramine Pellets Western Pharma105
Chlortetracycline 15% SDA Product17
Chlorzoxazone Espee Pharma Chem Pvt. Ltd.94 Nova Chemiie 24 Parshwa Pharma Chem Pvt. Ltd.40 DM Pharma22 Reenold Enterprises137
Chlorzoxazone Ip Kahan Pharmaceuticals 08
Chlorzoxazone
(Vitamin D-3 ) Balaji Corporation89
Cholesterol Oxford Laboratory Chemicals141
Cholesterol Usp Grade
Croma Chemical Corporation106
Choline Bicarbonate 50% Solution – IHT M/S. Alba Organics.91
Cholin Bitartarate Chemkart163
Choline Bitartrate Coated with 1% Silicon Dioxide – IHT M/S. Alba Organics.91
Choline Chloride ( feed ) / pharma Siddhivinayak Pharma160
Choline Chloride 50%Corn Base SDA Product17
Choline Chloride 50%Silica Base SDA Product17
Choline Chloride 60%Cereal Base
SDA Product17
Choline Chloride 60%Corn Base SDA Product17
Choline Chloride 60% Feed Grade – IHT M/S. Alba Organics.91
Choline Chloride 60%Liquid
SDA Product17
Choline Chloride 78%Liquid
SDA Product17
Choline Chloride 78% Solution – IHT
M/S. Alba Organics.91
Choline Chloride 91%Liquid
SDA Product17
Chloro, 2-Nitro Diphenyl Amine
Topnotch Chemicals Pvt. Ltd.23
Choline Chloride 91/90/60 Liquid For Oil Driling SDA Product17
Choline Chloride 105-106%Pure
SDA Product17
Choline Chloride Powder 106%/60%/50%
Kems Raw Pharma93
Choline Chloride Pure IHT
M/S. Alba Organics.91
Choline Chloride Pure / 58%
Crystal Pharma76
Choline Bitartrate USP/FCC4
Ayon pharmachem168
Choline Chloride Solution and 106% Powder
Ayon pharmachem168
Choline Salicylate
Ayon pharmachem168
Choline Bicarbonate
Ayon pharmachem168
Chlorphenesin
Maharshee Laboratories Pvt. Ltd. 133
Chlorpheniramine Maleate IP/BP/EP/USP
Maharshee Laboratories Pvt. Ltd. 133
Choline Chloride Solution 65%
Kems Raw Pharma93
Choline Dihydrogen Citrate 50% Solution – IHT
M/S. Alba Organics.91
Chondroitin Sodium
NDC Drug & Chemical Co.Pvt.Ltd. 154
Chondroitin Sulphate Sodium
Raivat Impex Pvt. Ltd.59
Chondroitin Sulfate
Panchsheel Organics Limited91
Chrome Black T Indian Platinum Pvt. Ltd.158
Chromium Amino Acid Chelate
Eklavya Biotech Pvt. Ltd.103
Chromic acid
Keshariya Corporation80
Chromium Picolinate
Kronox Lab Sciences Limited218
Chymotrypsin
Nova Chemiie 24
Asiel Chemipharma35
Cissus Quardrangularis Extract
CSV Pharmaceuticals India Pvt. Ltd.169
Ciclopirox Olamine
Balaji Corporation89
THE MAZADA PHARMA GUIDE 193
Indian
Oxide Indian Platinum Pvt. Ltd.158 Cerium Sulfate Hydrate Indian Platinum Pvt. Ltd.158 Cerium Sulphate Indian Platinum Pvt. Ltd.158 Cetane Improvers Krishna Antioxidants Pvt. Ltd.87 Ceteareth-20 Kanchan Rasayan 34 Ceteareth-25 Kanchan Rasayan 34 Cetearyl Alcohol & Ceteareth 20 Kanchan Rasayan 34 Cetearyl Alcohol & Polysorbate 60 Kanchan Rasayan 34 Cetearyl Alcohol & Sodium Alkyl Sulphate Kanchan Rasayan 34 Cetilistat Nova Chemiie 24 Cetomacrogol 1000 Kanchan Rasayan 34 Cetrimide (Equivalent-USP-NF Gr.) Yuvi Chemz148 Cetostearyl Alcohol Kanchan Rasayan 34 Centrifuges
Limited 147
Vinworld
Progress
Maharshee
Ltd. 133 Cetirizine Di Hcl NDC Drug & Chemical Co.Pvt.Ltd. 154 Kahan Pharmaceuticals 08 Cetirizine Di Hcl IP siddhivinayak pharma 160 Cetirizine Di HCL IP/BP Hritik
Pvt. Ltd.91 Cetirizine
Nova
24 Cetostryl
Siddhivinayak
Cetrimonium
Yuvi
FiltraTech Solutions India Private
Cetrimide
Healthcare P. Ltd147 Cetrixone Sodium Sterile Balaji Corporation89 Cetirizine
Life Sciences Pvt. Ltd.29 Cetirizine Dihydrochloride IP/BP/EP/USP
Chemicals
Dihydrochloride
Chemiie
Pharma160
Cetyl
Dev
H K
Cetyl Alcohol Kanchan Rasayan 34 Ashapura Drugs 21 Mivon
28
Ceto
Enterprise151
Chemicals
NF Flora Dye Chem 126 Cetyl
Kanchan Rasayan 34 Chamomile Extract Global Merchants25 Chamomile Oil Kamakhya ImpexFlap Cheese Coating Waxes Flora Dye Chem 126 Chemicals
Powder
129
Palmitate
Pack Chem
126
Flora
IP/BP Hritik Chemicals Pvt.
Chlorination Reaction Pacific Biochem Private Limited 82 Chlorzoxazone USP Vinworld Healthcare
Shriya
Chocolate
Standardcon
Cholecalciferol
Ltd.91
P. Ltd147
Pharma & Surgical42
Brown Ht Lake
Pvt. Ltd.150
PRODUCTS INDEX
Cilostazol
Dazzle Corporation88
Cinitapride Hydrogen Tartrate
Dazzle Corporation88
Cilnidipine IH
International Drug & Chemical Co.165
Cilnidipine
Aril Pharmaceuticals6/7
DM Pharma22
Nova Chemiie 24
Cinnamic Aldehyde
Chemaroma Drug House 91
Cilostazol
Aril Pharmaceuticals6/7
Cimetidine
Vinworld Healthcare P. Ltd147
Cinitapride Hydrogen Tartrate
Sheetal Chem 101
Cinnamic Acid
Chemaroma Drug House 105
Cinnamon Bark Oil
Aditi Essentials51
Cinnamon Leaf Oil
Aditi Essentials51
Cinnamyl Chloride
Asiel Chemipharma35
Cinnarazine Bp
Sheetal Chem 101
Cinnarazine Ip
Kahan Pharmaceuticals 08
Cinnarizine IP/BP/USP
Aril Pharmaceuticals6/7
Ciprofloxacin
Vinworld Healthcare P. Ltd147
Ciprofioxacin Granules 88.45%
YSK Laboratories Pvt. Ltd.56
Clopidogrel Granules 60%
YSK Laboratories Pvt. Ltd.56
Ciprofloxacin Base/ Lactate
Vinworld Healthcare P. Ltd147
Ciprofloxacin Hcl
Parshwa Pharma Chem Pvt. Ltd.40
Rumit Group Of Companies78
Ciprofloxacin HCL IP/BP
Hritik Chemicals Pvt. Ltd.91
Ciprofloxacin IP / USP
Malay Enterprise167
Ciprofloxacin HCL IP / USP
Vinworld Healthcare P. Ltd147
Ciprofloxacin Hcl IP/BP/USP
Sheetal Chem 101
Crystal Pharma76
Aril Pharmaceuticals6/7
Ciprofloxacin Salts
Nova Chemiie 24
Citalopram
Vinworld Healthcare P. Ltd147
Citalopram Hbr Ip 6/7
Aril Pharmaceuticals6/7
Citalopram IP/BP/USP
Jay Chem Marketing128
Citicoline Sheetal Chem101
Citicoline Sodium
Vinworld Healthcare P. Ltd147
Balaji Corporation89
Aril Pharmaceuticals6/7
Nova Chemiie 24
DM Pharma22
Citicolin Sodium Ip
Kahan Pharmaceuticals 08
Shriya Pharma & Surgical42
Citicoline Sodium IP/USP
Chemino Pharma Ltd94
Cis Bromo Benzoate (c.b.b)
Pacific Biochem Private Limited82
Cis-Propenyl Phosphonic Acid
Rare Pharma Pvt. Ltd.148
Citric Acid
Krishna Solvechem Ltd.21
Misrimal Pukhraj122
Citric Acid Anhydrous/Monohydrate
Pravina Pharma Chem Products150
Jay Chem Marketing128
Chemstar Global Products LLP76
Kronox Lab Sciences Limited218
Citric Acid (Bag)
Khushbu Dye Chem Pvt. Ltd.71
Citric Acid Bp/Usp
Crystal Pharma76
Citric Acid Anhydrous
Malay Enterprise167
Citric Acid Mono
Malay Enterprise167
Citric Acid Mono / Anhydrous
Meru Chem Pvt. Ltd.105
Pravina Pharma Chem Products150
Mivon Chemicals 28
Navnidh Pharma lab84
Ashapura Intermediates 119
Maruti Petrochem55
Citric Acid Monohydrate Dev Pharmaceuticals 164
Citronella Oil (Java Ceylon)
Aditi Essentials51
Cinnamic Acid
Mivon Chemicals 28
Citrus Fiber
Citrus Fiber
Labh ingredients152
Clarithromycin
Nova Chemiie 24
Aril Pharmaceuticals6/7
Unimax Group 20
Rumit Group Of Companies78
Clopidogrel Hydrogen Sulphate
Unimax Group 20
Clarithromycin Ip/Usp
Balaji Corporation89
Clarithromycin IP
Malay Enterprise167
Clarithromycin IP/ BP
Hritik Chemicals Pvt. Ltd.91
Clenbuterol Hcl Bp/Usp Balaji Corporation89
Clidinium Bromide Usp
Aril Pharmaceuticals6/7
Clindamycin HCL
Balaji Corporation89
Clindamycin HCL/ Phosphate IP/ BP
Hritik Chemicals Pvt. Ltd.91
Clindamycin Phosphate
DM Pharma22
Unimax Group 20
Clindamycin Phosphate /HCl
Malay Enterprise167
Clindamycin Phosphate Ip / Bp / Usp
Balaji Corporation89
Clinidipine
Balaji Corporation89
NDC Drug & Chemical Co.Pvt.Ltd. 154
Clinidium Bromide Usp
Aril Pharmaceuticals6/7
Clobazam Ip
Aril Pharmaceuticals6/7
Clobetasole
Parshwa Pharma Chem Pvt. Ltd.40
Clobetasol Propionate
Nova Chemiie 24
NDC Drug & Chemical Co.Pvt.Ltd. 154 Rumit Group Of Companies78
Clobetasol Propionate BP/ USP
Hritik Chemicals Pvt. Ltd.91
Clobetasole Propionate Ip/Usp
Kahan Pharmaceuticals 08
Clobetasone-17-Butyrate
Balaji Corporation89
Clobetasone Propionate
Balaji Corporation89 DM Pharma22
Clobetasone Butyrate BP Hritik Chemicals Pvt. Ltd.91
Clobetasone Butyrate Ip Hiten Pharma Chem152
Clobetasone Propionate Ip/Usp Hiten Pharma Chem152
Clomiphen Citrate
Drug & Chemical Co.Pvt.Ltd.
Clomiphene Citrate IP/BP/USP
Aril Pharmaceuticals6/7
Clomipramine Hcl Ip/Bp Aril Pharmaceuticals6/7
Clonazepam Luconic Chemicals103
Clopidogrel Jay Chem Marketing128 Color Developer 2-3-4 Yuvi Chemz148 Clopidogrel Bisulfate
Pharmaceuticals6/7
Clopidogrel Bi Sulphate IP/BP/USP Aril Pharmaceuticals6/7
Clopidogrel Bi Sulphate Ip
Ip
Ngl Fine Chem Ltd.
Chloramphenicol I.P.
Rati Pushp Intermediates Pvt. Ltd.37
Closental Base
Sheetal Chem101
Chemino Pharma Ltd94
Closantel Sodium / Base
Crystal Pharma76
Closantel Sodium IP/BP VET
Chemino Pharma Ltd94
Clotrimazole
Unitrade Agencies70
Luconic Chemicals103
Panchsheel Organics Limited91
Parshwa Pharma Chem Pvt. Ltd.40
Drug & Chemical Co.Pvt.Ltd.
Shamrock Pharmachem38
Clotrimazole Bp/Ep/Usp
DM Pharma22
Clotrimazole IP
Aara Pharma150
Clotrimazole IP/BP
Mehta Associates84
Hritik Chemicals Pvt. Ltd.91
Clotrimazole IP/BP/USP
Malay Enterprise167
Chlorzxazone Usp
Rolence Pharma & Chemicals127
Cloud Point Glycols
Krishna Antioxidants Pvt. Ltd.87
Clove Oil (Bud)
Chemstar Global Products LLP76
Clove Oil (Leaf)
Chemstar Global Products LLP76
Clove Oil
CSV Pharmaceuticals India Pvt. Ltd.169
Vikram Aromatics144
Clopidogrel Bisulfate
Dazzle Corporation88
Clotrimazole
Dazzle Corporation88
Coated Vitamin C
Cobalt Sulphate
Labh ingredients152
Cone Premixes (LA-CONE)
Labh ingredients152
Corn / Potato Starch
Labh ingredients152
Croscarmellose Sodium
Croscarmellose Sodium
Labh ingredients152
Cocoa Butter
CSV Pharmaceuticals India Pvt. Ltd.169
Cocoa Butter Ultra Refined
CSV Pharmaceuticals India Pvt. Ltd.169
Collagen Powder Bovine/marine/Vegan
CSV Pharmaceuticals India Pvt. Ltd.169
Cloxacillin Plain/Comp/Sterile
Nova Chemiie 24
Cloxacillin Sodium IP
Malay Enterprise167
Cloxacillin Sodium Sterile/Oral
Espee Pharma Chem Pvt. Ltd.94
Clozapine Aril Pharmaceuticals6/7
Clozapine Ip
Thana Acid & Chemical Co145
Conductivity Meter Khushboo Scientific13
Cone-Plate PTD 103 Khushboo Scientific13
Copper Carbonate Kronox Lab Sciences Limited218 Cupric Chloride Kronox Lab Sciences Limited218 Copper Citrate Indian Platinum Pvt. Ltd.158
Copper Fluoride
Qualikems Lifesciences Pvt. Ltd.139
Copper Nitrate
Qualikems Lifesciences Pvt. Ltd.139
Copper Oxide Black /Red
Qualikems Lifesciences Pvt. Ltd.139
Copper Sulphate
Indian Platinum Pvt. Ltd.158
SDA Product17
Chemstar Global Products LLP76
Copper Sulphate - Crystal & Powder
Ashapura Intermediates119
Copper Sulphate Anhydrous
Qualikems Lifesciences Pvt. Ltd.139
Copper Sulphate Pentahydate
Qualikems Lifesciences Pvt. Ltd.139
Coenzyme Q.10
North India Pharma92
international drug & chemical co.165
Chemkart163
Colchicine
Balaji Corporation89
Colistin Sulphate Usp / 10%
Crystal Pharma76
Collagen Peptide
North India Pharma92
Collidal Silicon Dioxide (Eq Aerosil)
Siddhivinayak Pharma160
Colour Erythrosin/brillant Blue/ponceau 4r
Siddhivinayak Pharma160
Colour Quinoline Yellow/sunset Yellow / tartrazine
Siddhivinayak Pharma160
Coal Combustion Catalyst
Relic Chemicals82
Coal & Coke
Bombay Test House Private Limited93
Comparators, Cells Turbidity / Photometers
B.J. Scientific Co. 162
Complex (Mchc)
North India Pharma92
Compressed Hydrogen Gas
Dev International158
Coning Oil
194 THE MAZADA PHARMA GUIDE
NDC
154
Aril
Clofazamine Maharshee Laboratories Pvt. Ltd. 133 Clotrimazole IP/BP/USP Maharshee Laboratories Pvt. Ltd. 133 Clopidogrel Bisulphate Nova Chemiie 24 NDC Drug & Chemical Co.Pvt.Ltd. 154
Kahan
08 Clopidogrel
Sheetal Chem 101 Clopidol
Pure Crystal
Clorsulon
105
Pharmaceuticals
Bp Vet
Pharma76
NDC
154
Aril Pharmaceuticals6/7 CM 1000 Kanchan Rasayan 34 Regent Chemicals 41 CMEA Kanchan Rasayan 34 CNS Drugs Chemical Matrix166 Co-Enzyme Q10 International Drug & Chemical Co.165 Balaji Corporation89 Global Merchants25 Co Enzyme Q 10 Nutraceuticals Grade Luconic Chemicals103 Cod Liver Oil BP Neha Pharma Pvt. Ltd.165 Cobalt Acetate Indian Platinum Pvt. Ltd.158 Cobalt Amino Acid Chelate Eklavya Biotech Pvt. Ltd.103 Cobalt Carbonate Qualikems Lifesciences Pvt. Ltd.139 Cobalt Chloride Indian Platinum Pvt. Ltd.158 HK Group76 Cobalt Chloride Hexahydrate Qualikems Lifesciences Pvt. Ltd.139 Cobalt Nitrate Hexahydrate Qualikems Lifesciences Pvt. Ltd.139 Cobalt Sulfate (CoSo4) Indian Platinum Pvt. Ltd.158 Cobalt Sulphate SDA Product17 Chemstar Global Products LLP76 Cobalt Sulphate / Chloride Meru Chem Pvt. Ltd.105 Cocamidopropyl Betaine Kanchan Rasayan 34 Cocktail Enzymes SDA Product17 Coco Diethanolamide Kanchan Rasayan 34 Coco Monoethanolamide Kanchan Rasayan 34 Coconut Oil Krishna Solvechem Ltd.21 Coconut Wax Flora Dye Chem 126 Cocopit Powder SDA Product17 Colchicine Ip/Bp/Usp Croma Chemical Corporation106 Cold Chamber Kesar Control Systems49 Cold Flow Improvers Krishna Antioxidants Pvt. Ltd.87 Collodion Flexable Sol. Kems Raw Pharma93 Colloidal Silicon Dioxide Kanchan Rasayan 34 Nova Chemiie 24 Colours – Food Malay Enterprise167 Colours - Pharma Malay Enterprise167 Copper Acetate Indian Platinum Pvt. Ltd.158 Kronox Lab Sciences Limited218 Copper Amino Acid Chelate Eklavya Biotech Pvt. Ltd.103 Concentrated Nitric Acid 98% (CNA)
PRODUCTS INDEX
Krishna Antioxidants Pvt. Ltd.87
Contract & Agreement Drafting
Gnanlex Associates LLP169
Copyrights - Filing - Prosecution & Litigation
Gnanlex Associates LLP169
Conjugated Estrogen
Hritik Chemicals Pvt. Ltd.91
Conjugated Linoleic Acid (CLA 60%) Chemkart163
Copper Carbonate
North India Pharma92
Copper Gluconate USP
Vinworld Healthcare P. Ltd147
Copper Iodide
SVG Pharma Lifesciences Pvt. Ltd.145
Copper Iodide / Sulphate
HK Group76
Copper Iodide / Sulphate
HK Group76
Copper Sulphate
Misrimal Pukhraj122
Core Products
Dev International158
Corn (Yelloow Maize)
SDA Product17
Corn Flour
SDA Product17
Corn Oil
Krishna Solvechem Ltd.21
Corrosion Inhibitors
Krishna Antioxidants Pvt. Ltd.87
Cosmetic Cream Base W/A/S
Flora Dye Chem 126
Cream Of Tartarate - (potassiumbi Tartarate)
HK Group76
Compact Coulometric
Khushboo Scientific13
Compact Volumetric
Khushboo Scientific13
Cottonseed Meal
SDA Product17
Cranberry Extract
North India Pharma92
Global Merchants25
Creatine Citrate Chemkart163
Creatine HCL Chemkart163
Creatine Malate Chemkart163
Creatine Monohydrate Chemkart163
Global Merchants25
Creatine Monohydrate 200mesh / 80 Mesh
Raivat Impex Pvt. Ltd.59
Creatine Nitrate Chemkart163
Cremophor Rh 40 (Croda)
Hiten Pharma Chem152
Croscarmellose Sodium IP/BP/USP (101/102/112)
Croscarmellose Sodium IP/BP/USP
J R Drugchem Pvt. Ltd. Back Inside
Cover
Croscarmellose Sodium IP / BP / USP / EP
Amit Hydrocolloids53
Cross Carmellous Sodium Siddhivinayak Pharma160
Cross Carmallose Sodium IP/ BP/ USP
International Drug & Chemical Co.165
Hiten Pharma Chem152
Cross Carmilose Sodium Parshwa Pharma Chem Pvt. Ltd.40
Cross Coupling Catalyst ligands
Omkar Lab155
Cross Povidone
Malay Enterprise167
Cross Fold Paper Folding
Advanced Industrial Micro Systems 25
Cross povidone Exci Gen Cross Carmellose Sodium Gautam Pharma Chem84
Crucibles,Basins, Wires & Basket
B.J. Scientific Co.162
Crude Glycerine 80% / Refined Glycerine
Meru Chem Pvt. Ltd.105
Crysobinum Powder
Kems Raw Pharma93
Crystal Violet (Gentian Violet )
Oxford Laboratory Chemicals141
Crystal Violet Powder Pure Kems Raw Pharma93
Cucumber Extract
Global Merchants25
Culture Media
Powder Pack Chem129
Cumin Oleoresin
CSV Pharmaceuticals India Pvt. Ltd.169
Curcumin Extract
CSV Pharmaceuticals India Pvt. Ltd.169
Cuprous Bromide
Pacific Biochem Private Limited82
Cupric Sulfate Anhydrous
Kronox Lab Sciences Limited218
Cupric Sulfate Pentahydrate
Kronox Lab Sciences Limited218
Cuprous Bromide
Mody Chemi Pharma Pvt. Ltd. 47
Cuprous Cyanide
Ram Enterprise 76
Curcumin Extract 103%
Global Merchants25
Cyanoacetic acid 78%, 106%
Zuhhad International 86
Cyanocobalamin (Vitamin B12)
Unitrade Agencies70
Cyclobenzaprine Hcl
NDC Drug & Chemical Co.Pvt.Ltd. 154
Cyclohexane
Mivon Chemicals 28
Nisha Chemicals71
Krishna Solvechem Ltd.21
H K Enterprise151
Chemstar Global Products LLP76
Maruti Petrochem55
Apra Enterprises19
Apra Innovative Pvt Ltd 19 Cyclohexanol Nisha Chemicals71
Petrochem55
Khushbu Dye Chem Pvt. Ltd.71
Nisha Chemicals71
Ketan Chemical Corporation119
H K Enterprise151
Chemstar Global Products LLP76
Apra Enterprises19
Cyclohexonone / Cyclohexane
Meru Chem Pvt. Ltd.105
Cyclohexyl Bromide
Krishna Solvechem Ltd.21
Cyclopentanone
Shamrock Pharmachem38
Cyclopentyl Bromide Krishna Solvechem Ltd.21
Cyproheptadine
NDC Drug & Chemical Co.Pvt.Ltd. 154
Cycloserine
DM Pharma22
Cynocobalamin ( Vit B -12 )
Balaji Corporation89
Cyplosporine
Vinworld Healthcare P. Ltd147
Cyproheptadine Hcl Ip
Aril Pharmaceuticals6/7
Cyproheptidine
Luconic Chemicals103
Cyproterone Acetate
Panchsheel Organics Limited91
Hritik Chemicals Pvt. Ltd.91
Cyromazine 1% Feed Grade
Rosetta Life Care Private Limited14
Cyromazine 2% Feed Grade
Rosetta Life Care Private Limited14
Cyromazine Pure
Rosetta Life Care Private Limited14
D/DL Amino Acid Chemkart163
D3 Stabilised
Siddhivinayak Pharma160
D5
Unitrade Agencies70
DB11
Unitrade Agencies70
D-Bioteen Usp/Ep
Shriya Pharma & Surgical42
D Biotin
Raivat Impex Pvt. Ltd.59
D-Biotin
Balaji Corporation89
NDC Drug & Chemical Co.Pvt.Ltd. 154
Dev International158 Global Merchants25
D-Cellobiose Acs/Ar
Croma Chemical Corporation106
D Lauryl Sulfo Succinate Kanchan Rasayan
D - Mannose North India Pharma92
D- Panthanol
Dev International158
D-Serine
Ram Enterprise 76
D Tartaric Acid
Maruti Petrochem55
D-Threo-Ritalinic Acid
Maruti Industries24
D Chiro Inosltol Hcl/Dase
Jakson Pharma104
D. O. T 106% Pure Crystal Pharma76
D.C.P
Siddhivinayak Pharma160
D.H.A North India Pharma92
Siddhivinayak Pharma160 Dha 40%
Raivat Impex Pvt. Ltd.59
De Oil Rice Bran
SDA Product17 DEG
Khushbu Dye Chem Pvt. Ltd.71
Paresh Chemical Corporation 78
H K Enterprise151
Maruti Petrochem55 DEP
Khushbu Dye Chem Pvt. Ltd.71
Maruti Petrochem55
D E G H K Enterprise151
Dabigatran Balaji Corporation89 Danazol Balaji Corporation89
Data Logger
Avi Scientific (India)56
Danazole Ip/Usp DM Pharma22
Dapagliflozin Sheetal Chem 101
Kahan Pharmaceuticals 08
Dapoxetine Luconic Chemicals103
Dapoxetine Hcl Nova Chemiie 24
NDC Drug & Chemical Co.Pvt.Ltd. 154
Dapoxetin Hcl I.H.S./Ip Kahan Pharmaceuticals 08
DBU
Krishna Solvechem Ltd.21
Decanenitrile (DCN) Inventys58
Decanol Krishna Solvechem Ltd.21
Decalin
Chemaroma Drug House 91
Dectyl Bromide
Krishna Solvechem Ltd.21
Deflazacort
Kesar Control Systems49
Defoamers
Relic Chemicals82
Deflazacort IP/BP/USP
North India Pharma92
Deep Freezer
Kesar Control Systems49
Deflazacort Ip/In-H
Deflazacort IP/ BP Hritik Chemicals Pvt. Ltd.91 Dehumidifier
Tivan Sciences Pvt. Ltd.40
Deflocculates/Thinners
Krishna Antioxidants Pvt. Ltd.87
Defoamers
Krishna Antioxidants Pvt. Ltd.87
Dehydroepiandrosterone (Dhea) North India Pharma92
Dehydroepiandrosterone Micro Balaji Corporation89
Demulsifier Concentrates
Krishna Antioxidants Pvt. Ltd.87
Denatonium Benzoate
Panchsheel Organics Limited91 Dev International158
Deoilers
Krishna Antioxidants Pvt. Ltd.87
Derivarivatives Group Dev International158
Desagestrel
DM Pharma22
Designs - Filing - Prosecution & Litigation
Gnanlex Associates LLP169
Desloratadine
DM Pharma22
NDC Drug & Chemical Co.Pvt.Ltd. 154
Desloratadine Ep/Usp Aril Pharmaceuticals6/7
Desmopressin Acetate Balaji Corporation89
Desogestrel Balaji Corporation89
Panchsheel Organics Limited91
DM Pharma22
Hritik Chemicals Pvt. Ltd.91
Desonide Hritik Chemicals Pvt. Ltd.91
Desvenlaflexime
Luconic Chemicals103
Desvenlafaxine Panchsheel Organics Limited91 Desoximethasone
& Chemical Co.Pvt.Ltd. 154
Aids
Antioxidants Pvt. Ltd.87 Detergent Enzyme Enzyme Bioscience57 Dex Ketoprofen international drug & chemical co.165
Dex Mono / Anhy Keshariya Corporation80
Chlorpheniramine
Hydrobromide (DMR)
Enterprise167 Dextromethorphan Hydrobromide (DMR HBR) IP/BP
Dextrose
/ anhydrous
THE MAZADA PHARMA GUIDE 195
Cyclohexanone
Mivon Chemicals 28 Maruti
34
Balaji
Panchsheel
Nova Chemiie 24 Parshwa
Aara
DM Pharma22 NDC Drug
Chemical Co.Pvt.Ltd. 154 Shriya
Unimax
Corporation89
Organics Limited91
Pharma Chem Pvt. Ltd.40
Pharma150
&
Pharma & Surgical42
Group 20
Kahan
08 Deflazacort
Aril
Deferasirox Tivan Sciences
Deferiperone Tivan
Doxofylline
Pharmaceuticals
In-H
Pharmaceuticals6/7
Pvt. Ltd.40
Sciences Pvt. Ltd.40
Unimax
Desvenlafaxine Succinate In-H Aril Pharmaceuticals6/7 DETA/TETA ( Delamine) Maruti
Dewaxing
Group 20 Rumit Group Of Companies78 Desvenlafaxine Succinate Hap Enterprise67 NDC Drug
Petrochem55
Krishna
Sheetal
Sheetal Chem101 Dex Rabeprazole Ip Sheetal Chem 101 Kahan Pharmaceuticals 08 Dex Rabeprazole Sodium Ip Aril Pharmaceuticals6/7 Dexamethsone Unitrade Agencies70 Vinworld Healthcare P. Ltd147
Base
Sodium Rumit
Dexamethasone
Hiten Pharma
Dexamethasone Plain Vinworld Healthcare P.
Dexamethasone Plain / Sodium NDC Drug & Chemical Co.Pvt.Ltd. 154 Dexamethasone Sodium
Hiten Pharma Chem152 Dexamethasone Sodium Phosphate Ip/Bp/Usp Kahan Pharmaceuticals 08 Dexamethasone Sodium Phosphate Balaji Corporation89 Vinworld Healthcare P. Ltd147 Nova Chemiie 24 Unimax Group 20 Dextromethorphan Vinworld Healthcare P. Ltd147 Dextromethorphan Hydrobomide NDC Drug & Chemical Co.Pvt.Ltd. 154 Dextrometharphon Hbr Ip/Bp Kahan Pharmaceuticals 08
Malay
Hritik
Dextromethorphan HBR Nova Chemiie 24 DM Pharma22 Reenold Enterprises137
DM
DM
Dex
Maleate Siddhivinayak Pharma160 Dexlansoprazole
Chem 101 Dex Lansoprazole Pellets Sheetal Chem101 Dex Rabeprazole Pellets
Dexa
/ Dexa
Group Of Companies78
Ip/Usp
Chem152
Ltd147
Ip/Usp
Dextromethorphane
Chemicals Pvt. Ltd.91
Dextromethorphan Hbr Ip Aril Pharmaceuticals6/7 Dextropoxyphene Hydrochloride
Pharma22 Dextropropoxyphene Napsylate
Pharma22
Dextrose Anhydrous Ip Shree Chemicals117
mono
PRODUCTS INDEX
Mivon Chemicals 28
Dextrose Monohydrate
SDA Product17
Dextrose Monohydrate/Anhydrous
Reenold Enterprises137
Dextrose Monohydrate Ip
Shree Chemicals117
Dextrose Monohydrate Powder
Shree Chemicals117
Deferiprone
Maharshee Laboratories Pvt. Ltd. 133
Dexchlorpheniramine Maleate IP / BP / USP
Maharshee Laboratories Pvt. Ltd. 133
Dexrabeprazole Sodium Dazzle Corporation88
Dexketoprofen
Maharshee Laboratories Pvt. Ltd. 133
Dl Tartaric Acid
HK Group76
DHA 10%
Chemkart163
Di-Acetone
Khushbu Dye Chem Pvt. Ltd.71
H K Enterprise151
Dl - Serine
Croma Chemical Corporation106
Diacerein
NDC Drug & Chemical Co.Pvt.Ltd. 154
Diacerin Ip
Kahan Pharmaceuticals 08
Diastase
Asiel Chemipharma35
Diaveridine HCL In-house Grade
Rosetta Life Care Private Limited14
Diazepam
Neha Pharma Pvt. Ltd.165
Di-Ammonium Phosphate
Advance in Organics LLP128
Di-calcium Phosphate IP / BP / Feed [ Anhydrous /Dihydrate ]
Arco Pharma126/164
Diclazuril 0.5% Feed Grade
Rosetta Life Care Private Limited14
Diclofenac Diethalamine
Aara Pharma150
Diclofenac Diethylamine
NDC Drug & Chemical Co.Pvt.Ltd. 154
Diclofenac Pellets Western Pharma105
Diclofenac Potassium
Parshwa Pharma Chem Pvt. Ltd.40
Aara Pharma150
NDC Drug & Chemical Co.Pvt.Ltd. 154
Diclofenac Potassium / Sodium IP/BP
Hritik Chemicals Pvt. Ltd.91
Diclofenac Potassium Bp
Kahan Pharmaceuticals 08
Diclofenac Resinate
DM Pharma22
Diclofenac Salts
Nova Chemiie 24
Diclofenac Sodium Western Pharma40
Parshwa Pharma Chem Pvt. Ltd.40
NDC Drug & Chemical Co.Pvt.Ltd. 154
Reenold Enterprises137
Diclofenac Sodium Ip/Bp
Kahan Pharmaceuticals 08
Aara Pharma150
Diethylene Glycol
Relic Chemicals82
Diltazem Hcl Pellets
Western Pharma105
Dibucain Bp/Usp/Jp International Drug & Chemical Co.165
Di Calcium Phosphate
Western Pharma105
Keshariya Corporation80
SDA Product17
Di Calcium Phosphate (Dihydrate / Anhydrous)
Pari Chemicals136
Di Acetone
Mivon Chemicals 28
Di Acetone Alcohol
Krishna Solvechem Ltd.21
Apra Enterprises19
Di Ammonium Phosphate
Keshariya Corporation80
SDA Product17
Di Ammonium Phosphate (Tech)
Riddhi Siddhi Dye Chem137
Diazoxide
Balaji Corporation89
Diazepam Bp
Aril Pharmaceuticals6/7
Dibenzo[b,f][1,4] Thiazepine-11(10H)-one
Maruti Industries24
Di Butyl Phthalate (DBP)
Mivon Chemicals 28
Diacerin
Sheetal Chem 101
Dibucaine
international drug & chemical co.165
Diacerein Ip / Ep
Pravinchandra & Co.13
D'Limonene
Vikram Aromatics144
Di-Bromo-5-Methy 5-Phenyl Hydation (DBH) Inventys58
Di Bromo Alkane
Pacific Biochem Private Limited 82
DiCalcium Phosphate (DCP)
Malay Enterprise167
Di Calcium Phosphate (Anhydrous) IP / BP / USP
Gangotri Inorganic (P) Ltd.18
Di Calcium Phosphate (Dihydrate) IP / BP / USP
Gangotri Inorganic (P) Ltd.18
Di Calcium Phosphate (Dihydrate)
Vinworld Healthcare P. Ltd147
Di calcium Phosphate Food / Feed Grade
Gangotri Inorganic (P) Ltd.18
Dichloromethane
Kanchan Rasayan 34
Dicyclohexyl Ketone (DCHK)
Shamrock Pharmachem38
Diclofenac Sodium / Pottasium
Vinworld Healthcare P. Ltd147
Diclofenac Sodium IP/BP/USP
Malay Enterprise167
Malay Enterprise167
Dicloxacillin Sodium Sterile
Nova Chemiie
Dicofenac Daenol
DM Pharma22
Dicofenac Deithylamine Bp
DM Pharma22
Dicofenac Epolamine
DM Pharma22
Dicofenac Free Acid
DM Pharma22
DiCycloPentadiene
Nisha Chemicals71
Dicyclomine Hcl Nova Chemiie
Parshwa Pharma Chem Pvt. Ltd.40
Synthetic Molecules71
Dicyclomine Hcl Ip
Aril Pharmaceuticals6/7
Kahan Pharmaceuticals
Dicyclomine Hcl Ip/Bp
Shriya Pharma & Surgical42
Dicloxacillin Sodium
Dazzle Corporation88
Dipentene
Vikram Aromatics144
Doxofylline
Dazzle Corporation88
D-Chiro Inositol
Raivat Impex Pvt. Ltd.59
Diboc (Di-tert-butyl dicarbonate)
Maruti Petrochem55
Dienogest
Panchsheel Organics Limited91
Hritik Chemicals Pvt. Ltd.91
Dye Chem Pvt.
Di Ethyl Amine (DEA)
Solvechem Ltd.21 Di Ehtylene Glycol
Chemicals
Ethyl Ether Meru Chem Pvt. Ltd.105
Ethylene Glycol (DEG )
Diethylene Glycol Dibenzoate (Degdb)
Gbl Chemical Limited73
Dipropylene Glycol Dibenzoate (Dpgdb)
Gbl Chemical Limited73
Ethylene Tri Amines (DETA)
Solvechem Ltd.21
Ethyl Oxyylate
Chemicals102
Ethyl Pthalate (DEP)
Chemicals
Di Ethyl Pyro Carbonate
Kip Chemicals Pvt. Ltd.81
Sulphate
Chemical co.144
Chem Pvt. Ltd.105
Calcium Phosphate (Dihydrate/Anhydrous)
in Organics LLP128
Carbamazine Citrate
Chemiie
Diethyl Carbamazine Citrate IP
Associates84
(Deta)
Artemesinin
Dihydro Eugenol
Global Products LLP76
Dihydroartemisinin
Pharma22
Iso Propyl Amine
Potassium Phosphate Vinipul Chemicals Pvt. Ltd.31 Di Potassium Phosphate
in Organics LLP128 Di Iso Propyl Ether
Mivon Chemicals
Meru Chem Pvt. Ltd.105
Maruti Petrochem55
Enterprises19
Innovative Pvt Ltd
Iso Propyl Ether (DIPE)
Chemicals71
Methyl Acetamide
Mivon Chemicals
Krishna Solvechem Ltd.21
Apra Enterprises19
Apra Innovative Pvt Ltd
Distearyl dimethyl ammonium chloride
Yuvi Chemz148
Di Methyl Amine (DMA)
Krishna Solvechem Ltd.21
Di Methyl Amine HCL
Krishna Solvechem Ltd.21 Di Methyl Aniline Mivon Chemicals
Methyle Carbonate (Dmc)
Solvechem Ltd.21
Methyl Formamide (DMF)
Chemicals
Ketan Chemical Corporation119
Chemicals71
Paresh Chemical Corporation
Solvechem Ltd.21 Amita Chemicals102
Chemicals
Meru Chem Pvt. Ltd.105
Chemstar Global Products LLP76 Maruti Petrochem55 Apra Enterprises19 D Mannose
Raivat Impex Pvt. Ltd.59
Diosmin
Raivat Impex Pvt. Ltd.59
Dimethyl Hydroquinone (DMHQ)
Chemstar Global Products LLP76
Dimethyl di(hydrogenated Tallow) ammonium chloride
Yuvi Chemz148
Yuvi Chemz148
Diethylene Glycol Dibenzoate (Degdb)
Gbl Chemical Limited73
Dipropylene Glycol Dibenzoate (Dpgdb)
Gbl Chemical Limited73
Dipotassium Phosphate
Pari Chemicals136
Di Methyl Sulfoxide Krishna Solvechem Ltd.21
Di Methyl Sulphoxide (DMSO) Mivon Chemicals 28 Nisha Chemicals71
Chemstar Global Products LLP76
Enterprises19 Dimethyl-L-Tartrate
Enterprise 76
Sulfoxide Paresh Chemical Corporation 78
DIPE
Khushbu Dye Chem Pvt. Ltd.71 DIPEA (N,N-Diisopropylethylamine)
Petrochem55 Diphenhydramine Hydrochloride
Dye Chem Pvt. Ltd.71
Dye Chem Pvt. Ltd.71
Qualikems Lifesciences Pvt. Ltd.139 Di Propylene Glycol (Dpg) Fr / Tech. Keshav Hichem Pvt. Ltd. 21
Di Propylene Glycol (Dpg) Fr / Tech.
Malay Enterprise167
Nisha Chemicals71
Di Ethyl Glycol
Apra Innovative Pvt Ltd19
Di-Sodium Hydrogen-O-Phosphate
Qualikems Lifesciences Pvt. Ltd.139
Di-Sodium Phosphate Anhydrous
Advance in Organics LLP128
Di Sodium Hydrogen Ortho Phosphate
Gautam Pharma Chem84
Di Sodium Di Pyro Phosphate
Advance in Organics LLP128
Di Sodium Phosphate
Krishna Solvechem Ltd.21
Di Valporate
Luconic Chemicals103
Di Valproex Sodium Nova Chemiie 24
Di Valproex Sodium IP/ USP
Hritik Chemicals Pvt. Ltd.91
Luconic Chemicals103
Dibromo Ester
Mody Chemi Pharma Pvt. Ltd. 47
Diclazuryl (Fg) 0.5/1% Crystal Pharma76
Dicyclomine Hcl IP/BP/USP
Espee Pharma Chem Pvt. Ltd.94
Balaji Corporation89
Difloxacin
Panchsheel Organics Limited91
Diflucortolone Valerate
Unimax Group 20
Difluoro Methyl Sulfoxyl Chloride
Krishna Solvechem Ltd.21
Digital Burettes, Micro Pipettes.
B.J. Scientific Co. 162
Digital Thermometer
Avi Scientific (India)168
Diisodecyl Phenyl Phosphite (Ddpp)
Krishna Antioxidants Pvt. Ltd.87
Diltiazem
Balaji Corporation89
Diltiazem Hcl
Panchsheel Organics Limited91
Diltiazem Hcl -Sr 44%, 54%, 60%, 65% Pellets
Panchsheel Organics Limited91
Diloxanide Furoate
Nova Chemiie
Diluted Nitro Glycerine [10%] Usp
24
Aril Pharmaceuticals6/7
Diluted-Isosorbide-5 Mononitrate [40/50/80%] Ip/Bp
Aril Pharmaceuticals6/7
Dimenhydrinate
Nova Chemiie 24
Di Methyl Carbonate
Nisha Chemicals71
Dimethylamino Propylamine (DMAPA)
Krishna Solvechem Ltd.21
Diminazene Diaceturate
Panchsheel Organics Limited91
Ngl Fine Chem Ltd. 105
Diminazene Aceturate (Diminazene Diaceturate)
NGL Fine - Chem Limited105
Dinogest
Balaji Corporation89
DIPA
Krishna Solvechem Ltd.21
DIPEA Krishna Solvechem Ltd.21
Diphenyl Isodecyl Phosphite (Dpdp)
Krishna Antioxidants Pvt. Ltd.87
Diphenyl Isooctyl Phosphite (Dpiop)
Krishna Antioxidants Pvt. Ltd.87
Diphenyl Methane
Mody Chemi Pharma Pvt. Ltd. 47
Di Phenyl Methane Bromide
Pacific Biochem Private Limited82
Diphenyl Octyl Phosphite (Dpop)
Krishna Antioxidants Pvt. Ltd.87
Diphenyl Phosphite (Dpp)
Krishna Antioxidants Pvt. Ltd.87
Diclofenac Potassium IP/ BP/USP
Dimezone-S(4hydx-4M.-1ph.-3pyrazolidone)
196 THE MAZADA PHARMA GUIDE
24
24
08
Di
Mivon Chemicals 28 Diethanolamine Paresh Chemical Corporation 78 Di Ethyl Amine Mivon Chemicals 28 Khushbu
Ltd.71
Gandhi
144 Di
Di
Mivon Chemicals 28
Ethanolamine
Krishna
Krishna
Di
Amita
Di
Mivon
28
Di
Sunraj
Meru
Di
Advance
Nova
24
Mehta
Diethylenetriamine
Mivon Chemicals 28 Dihydro
Nova
24
Diethyl
Diethyl
Chemiie
Chemstar
DM
Di
Mivon
28 Di
Advance
Chemicals
28
Apra
Nisha
Apra
19 Di
Di
28
19
28
Di
Mivon
28
Di
Krishna
Nisha
78
144
Krishna
Gandhi
Apra
Ram
Dimethyl
Maruti
Maharshee Laboratories Pvt. Ltd. 133 Disulfiram Maharshee Laboratories Pvt. Ltd. 133 Diphenyl
Stratechem
Diphenyl
DMF Khushbu
DMSO Khushbu
Maruti
DM Pharma22 Diphenhydramine HCL IP/BP/EP/USP
Sulfone
(I) Pvt. Ltd. 88
Sulfone Stratechem (I) Pvt Ltd.88 Dl-Methionine F.G.99% SDA Product17
Petrochem55 Dione [Diketone] of CELECOXIB Prudence Pharma Chem Ear Panel / 81 Diosmin Raivat Impex Pvt. Ltd.59 Di Potassium Hydrogen O Phosphate
PRODUCTS INDEX
Diphenyl Tri Isodecyl Phosphite (Dptdp)
Krishna Antioxidants Pvt. Ltd.87
Diphenhydramine Hcl/Base
Nova Chemiie 24
Diphenylacetonitrile
Mody Chemi Pharma Pvt. Ltd. 47
Diphosphite (Dpedp)
Krishna Antioxidants Pvt. Ltd.87
Dipping Oil
S.A.I. Products132
Di Magnesium Phosphate
Pari Chemicals136
Dipropylene Glycol
Relic Chemicals82
Di-Sodium Hydrogen Citrate Bp
Pravina Pharma Chem Products150
Navnidh Pharma Lab84
Di Sodium Phosphate (Crystal)
Riddhi Siddhi Dye Chem 137
Disulfiram Ip/Usp
Mahaveer ChemicalsEar Panel
Dispersing Agents
Krishna Antioxidants Pvt. Ltd.87
Disproportionated Rosin Coagulants
Krishna Antioxidants Pvt. Ltd.87
Disteraryl Pentaerythritol
Krishna Antioxidants Pvt. Ltd.87
Disodium Phosphate
Pari Chemicals136
Distearyl dimethyl ammonium chloride
Yuvi Chemz148
Distilled / Spent / Crude / Residual Solvent Mixed
Noble Chemical Agency 92
Distilled Coco Fatty Acid (Dcfa)
H K Enterprise151
Distilled Coconut Fatty Acid
Siddharth International101
Distilled Coconut Fatty Acid Regular
Kanchan Rasayan 34
Distillied Soya Fatty Acid
H K Enterprise151
Disufiram
North India Pharma92
Panchsheel Organics Limited91
Divalproex Sodium
Siddhivinayak Pharma160
Vinworld Healthcare P. Ltd147
Dl - Calcium Pantothenate
Crystal Pharma76
Dl - Methionine 99% (Fg)
Crystal Pharma76
Dl - Tetramisole Hcl Bp/Usp
Crystal Pharma76
Dl-Methionine Bp
Suprim Chemicals76
DL-Serine Hydrazide HCl
Shamrock Pharmachem38
DMDM Hydantoin
Kip Chemicals Pvt. Ltd.81
DMF
Malay Enterprise167
Apra Enterprises19
Dmr
Parshwa Pharma Chem Pvt. Ltd.40
Do Decanol
Krishna Solvechem Ltd.21
Dobutamine
Panchsheel Organics Limited91
Docosahexanoic Acid (Dha) Veg Powder
Panchsheel Organics Limited91
Dofetilide
Jay Chem Marketing128
Dolomite Powder
SDA Product17
Dolutegravir
Jay Chem Marketing140
Dopamine Hydrochloride
Panchsheel Organics Limited91
Domperidon
Parshwa Pharma Chem Pvt. Ltd.40
Domeperidone Ip/Bp
Kahan Pharmaceuticals 08
Balaji Corporation89
Aril Pharmaceuticals6/7
Sheetal Chem 101
Malay Enterprise167
Domperidone Maleate
Aril Pharmaceuticals6/7
Domperidone
Reenold Enterprises137
Dorzolamide Hcl
Bakul Aromatics and Chemicals Pvt. Ltd.103
Domperidone Pellets
Sheetal Chem 101
Dorzolamde
Aara Pharma150
Dothiapine
Luconic Chemicals103
Dothiepin Hcl
Aril Pharmaceuticals6/7
NDC Drug & Chemical Co.Pvt.Ltd. 154
Dothiepin Hc Xl
Hap Enterprise67
Dothiepine Hcl Ip/Bp/Ep
Aril Pharmaceuticals6/7
Doxepin Hcl
Hap Enterprise67
NDC Drug & Chemical Co.Pvt.Ltd. 154
Doxofylline IP
Aril Pharmaceuticals6/7
Doxophylline
Nova Chemiie 24
DM Pharma22
Doxycycline
Unitrade Agencies70
Doxycycline Hcl Bp/Usp
Crystal Pharma76
Doxylamine Succinate
Aril Pharmaceuticals6/7
Luconic Chemicals103
Hap Enterprise67
NDC Drug & Chemical Co.Pvt.Ltd. 154
Dried Alluminium Hydroxide Gel
Espee Pharma Chem Pvt. Ltd.94
Kems Raw Pharma93
Dried Aluminium Hydroxide Gel IP / BP / USP
Gangotri Inorganic (P) Ltd.18
Dried Calcium Sulphate B.P.
Hritik Chemicals Pvt. Ltd.91
Dried Ferrous Sulphate
Pravina Pharma Chem Products150
Drug Intermediates
Shreenath Chemicals82
Drospirenone
Panchsheel Organics Limited91
Balaji Corporation89
DM Pharma22
Hritik Chemicals Pvt. Ltd.91
Drotavarine
Aril Pharmaceuticals6/7
Drotaverine HCI
Aril Pharmaceuticals6/7
Parshwa Pharma Chem Pvt. Ltd.40
Shamrock Pharmachem38
Drotaverine HCL IP/ BP
Hritik Chemicals Pvt. Ltd.91
Dry Jawla Fish
SDA Product17
Dry Yeast Feed Grade
Rosetta Life Care Private Limited14
Dry Yeast Powder
Kems Raw Pharma93
Drying / Vacuum Drying
Filtromix Equipments LLP
Croma Chemical Corporation106
Ducting
Plastic Fabricators59
Duloxetine
Vinworld Healthcare P. Ltd147
Duloxetine Hcl Ip/Bp/Usp Pramukh Pharmachem Pvt. Ltd.80
Hcl
Drug & Chemical
Duloxetine Hcl In-H Aril Pharmaceuticals6/7 Duloxetine Hydrochloride
Chemiie
Dusatinib (onco)
Healthcare P. Ltd147
Organics Limited91
Corporation89
Chemiie
Pharma150
Dutasteride Ip Hap Enterprise67
Dutasteride Ir Pellets (0.25% / 0.50%)
Kahan Pharmaceuticals
Dutasteride & Finastride
North India Pharma92
Dust Collection Bags
FiltraTech Solutions India Private Limited
Dutasteride + Tamsulosin Pellets
Panchsheel Organics Limited91
Dye & Stains
Powder Pack Chem129
Dyes, Acids and Solvents
Bombay Test House Private Limited93
Dye Fixing Agent
Krishna Antioxidants Pvt. Ltd.87
Dyslipidaemic Chemical Matrix166
Doxofylline
Bakul Aromatics and Chemicals Pvt. Ltd.103
D Xylose
Raivat Impex Pvt. Ltd.59
Econazole Nitrate IP/BP/EP/USP
Maharshee Laboratories Pvt. Ltd.
Eucalyptol
Vikram Aromatics144
Easy KFV
Khushboo Scientific13
Easy Pro
Khushboo Scientific13
Ebacavir
Balaji Corporation89
Ebastine
Hap Enterprise67
NDC Drug & Chemical Co.Pvt.Ltd.
Ebastine IP/BP/USP
Luconic Chemicals103
Balaji Corporation89
Ebastine Ep Aril Pharmaceuticals6/7
Eberconazole
Balaji Corporation89
Aara Pharma150
Edaravone
Balaji Corporation89
Tivan Sciences Pvt. Ltd.40
Edaravone Ih/Jp
Pramukh Pharmachem Pvt. Ltd.80
EDC Maruti Petrochem55
EDTA Salts
Shreenath Chemicals82
Edetate Calcium Disodium
Kronox Lab Sciences Limited218
Edetate Disodium Dihydrate
Kronox Lab Sciences Limited218
Edta Di Sodium Salt Dev International158
Edta Pure Acid Dev International158
Edta Tetra Sodium Salt Dev International158
Efaverinz
Balaji Corporation89
Jay Chem Marketing128
Efinacnazole
Corporation89
Chemiie 24 Parshwa Pharma Chem Pvt. Ltd.40 Enrofloxacin Base
Pharma76
Base Vet
Group Of Companies78 Enzymes With Probiotics SDA Product17 EOA 103 –Engine Oill Additive
Enterprise155
Epa (Eicosapentaenoic Acid) Veg Source
North India Pharma92
EPA 10% Chemkart163
Empagliflozin Bakul Aromatics and Chemicals Pvt. Ltd.103
Eperisone Hcl NDC Drug & Chemical Co.Pvt.Ltd.
Dye Chem Pvt. Ltd.71
Corporation119
Corporation89
Enterprise166
Molecules71
THE MAZADA PHARMA GUIDE 197
149
DTT
NDC
Co.Pvt.Ltd. 154
24
Duloxetin
Nova
Balaji
Vinworld
Nova
24
DM
Hritik Chemicals
Ltd.91 NDC Drug & Chemical Co.Pvt.Ltd. 154 Unimax Group 20 Rumit
Companies78
Vinworld
Dutasteride Panchsheel
Healthcare P. Ltd147
Aara
Pharma22
Pvt.
Group Of
08
147
133
154
Balaji
EGDS Kanchan Rasayan 34 EGMS Kanchan Rasayan 34 Eicosapentaenoic Acid (Epa) Powder Panchsheel
North
Electronic Balance, Spectrophotometer B.J. Scientific Co. 162 Empagliflozin Sheetal Chem 101 Empty Hard Gelatin Capsule Espee Pharma Chem Pvt. Ltd.94 Emtricitabine Jay Chem
DM
Organics Limited91 Elderberry Extract
India Pharma92
Marketing128
Pharma22 Emulsifire 2.5/6/9.5/10/20 Mol Meru Chem Pvt. Ltd.105
Dev
For Oil Based Mud Krishna Antioxidants Pvt. Ltd.87 Emulsifying Ointment BP Flora Dye Chem 126 Emulsifying Wax Siddhivinayak Pharma160 Aarbee International30 Flora Dye Chem 126 Emulsifying Wax – Non Ionic Flora Dye Chem 126 Emulsifying Wax (Ionic/Non-Ionic) Kems Raw Pharma93 Emuollient Esters Aarbee International30 EnhanSo Liquid S.A.I.
S.A.I.
Entacavir Balaji
Aril
Enoxaparin
Vinworld
Unitrade
Enrofloxacin
Crystal
Emulsifier All Grade
International158 Emulsifiers
Products132 EnhanSo Powder
Products132
Corporation89 Enalapril Maleate
Pharmaceuticals6/7
Sodium
Healthcare P. Ltd147
Agencies70
Nova
Enrofloxacin
Rumit
Shreedhar
Ephedrine
Neha Pharma
Eperisone Hcl Maharshee Laboratories Pvt. Ltd. 133 Erdosteine Maharshee Laboratories
133 Epichlorohydrin Khushbu
Paresh
Meru
Maruti
Epichlohydrine Ketan
Epoxy Resin H K Enterprise151 Relic Chemicals82 Erythritol Advance in Organics LLP140 Raivat Impex Pvt. Ltd.59 Erectile Dysfunction Chemical Matrix166 Erythromycin Unimax Group 20 Erichrome Black T Croma Chemical Corporation106 Eriochrome Black T Indian Platinum Pvt. Ltd.158 Eriochrome Black T Oxford Laboratory Chemicals141 Eriochrome Cyanine R Oxford Laboratory Chemicals141 Erlotinib Balaji Corporation89 Erythromycin Phosphate Unimax Group 20 Erlotinib Hydrochloride (onco) Vinworld Healthcare P. Ltd147 Erythromycin 11-12 cyclic carbonate Unimax Group 20 Erythrosine Lake Standardcon Pvt. Ltd.150 Erythromycin Estolate Unimax Group 20 Erythromycin Ethyl Succinate Unimax Group 20 Erythromycin Vinworld Healthcare P. Ltd147 Erythromycin Estolate Nova Chemiie 24 Erythromycin Ethyl Succinate Nova Chemiie 24 Erythromycin Dihydrate Unimax Group 20 Erythromycin Stearate Nova Chemiie 24 Parshwa Pharma Chem Pvt. Ltd.40 Unimax Group 20 Erythromycin Stearate IP Malay Enterprise167 Erythromycin Stearate / Estolate IP/BP/USP Unitrade Agencies70 Erythromycin Propionate Unimax Group 20 Erythromycin Thiocyanate Unitrade Agencies70 Erythromycin Lactobionate Unimax Group 20 Eschaka Mixture
154
HCL
Pvt. Ltd.165
Pvt. Ltd.
Chemical Corporation 78
Chem Pvt. Ltd.105
Petrochem55
Chemical
Epinephrine Bitatrate Balaji
Evening Primrose Oil Chemizo
Eperisone Synthetic
PRODUCTS INDEX
Qualikems Lifesciences Pvt. Ltd.139
Escitalopram Oxalate
Vinworld Healthcare P. Ltd147
Escitalopram Oxalate Ip
NDC Drug & Chemical Co.Pvt.Ltd. 154
Shriya Pharma & Surgical42
Erythromycin Oxime Base
Unimax Group 20
Escitalopram Oxalate IP/BP/USP
Aril Pharmaceuticals6/7
Esomeprazole 40 Mg Ec + Domeperidone
30 Mg Sr
Kahan Pharmaceuticals 08
Esomeprazole 40 MG + Levosulpiride Pellets 30 MG
Kahan Pharmaceuticals 08
Esomeprazole Magnesium
Sheetal Chem 101
NDC Drug & Chemical Co.Pvt.Ltd. 154
Dazzle Corporation88
Erdosteine
Dazzle Corporation88
Esomeprazole Magnesium Ip/Usp
Kahan Pharmaceuticals 08
Esomeprazole Magneisum (EC) & Domperidone (SR) Pellets
Sheetal Chem101
Esomeprazole Magneslum Trihydrate Pellets Sheetal Chem101
Esomeprazole Magnesium Trihydrate Sheetal Chem 101
Esomeprazole Pellets Western Pharma105
Esomeprazole Mg. Trihydrate
Nova Chemiie 24
Esemoprazole (Mag.Trihydrate) Pellets
Panchsheel Organics Limited91
Esomeprazole Sodium Sterile
Nova Chemiie 24
Esomeprazole Sodium Sterile (Lyophilized)
Nova Chemiie 24
Essential Amino Acid Blend (EAA) Chemkart163
Essential Oils
Aditi Essentials51
Ester Quat Fabric Softener
Kip Chemicals Pvt. Ltd.81
Estradiol/ Estradiol
Hritik Chemicals Pvt. Ltd.91
Estradiol Valerate
Balaji Corporation89
Hritik Chemicals Pvt. Ltd.91
Estradiol / Valerate / Benzoate / Phenyl Propionate
Panchsheel Organics Limited91
Etamsylate IP/BP
Hritik Chemicals Pvt. Ltd.91
Ethambutol BP/EP/USP/IP Vinworld Healthcare P. Ltd147
Ethamsylate IP/BP/USP
Luconic Chemicals103
Aril Pharmaceuticals6/7
Ethidium Bromide Ar Oxford Laboratory Chemicals141
Ethinyl Estradiol
Panchsheel Organics Limited91
Hritik Chemicals Pvt. Ltd.91
Ethisterone
Balaji Corporation89
Ethopabate Bp Crystal Pharma76
Ethoxy Propanol
Maruti Petrochem55
Ethoxylate Series – Powder/ Liquid Kip Chemicals Pvt. Ltd.81
Ethoxylated Fatty Alcohols
Aarbee International30
Ethoxylated Glyceryl Esters
Aarbee International30
Ethoxylated Sorbitan Esters / Polysorbates
Aarbee International30
Ethoxyquine
Crystal Pharma76
Ethyl / Methyl Chloroformate
Meru Chem Pvt. Ltd.105
Ethyl/Methyl Oleate
S.A.I. Products132
Ethyl/Methyl Palmitate
S.A.I. Products132
Ethyl 1-(4-Methoxyphenyl)-7-Oxo-6-(4-(2-Oxopiperidin-1Yl)Phenyl)4,5,6,7-Tetrahydro-1h-Pyrazolo[3,4-C]Pyridine-3Carboxyalate
Asiel Chemipharma35
Ethyl 2-Chloroacetoacetate
Asiel Chemipharma35
Ethyl Acetate
Mivon Chemicals 28
Khushbu Dye Chem Pvt. Ltd.71
Paresh Chemical Corporation 78
Misrimal Pukhraj122
Gandhi Chemicals 144
H K Enterprise151
Meru Chem Pvt. Ltd.105
Chemstar Global Products LLP76
Maruti Petrochem55
Apra Enterprises19
Apra Innovative Pvt Ltd 19
Thana Acid & Chemical Co145
Relic Chemicals82
Ethyl Aceto Acetate
Meru Chem Pvt. Ltd.105
Ethyl Acrylate (EA)
Nisha Chemicals71
Ethyl Acrylate Monomer
Apra Enterprises19
Apra Innovative Pvt Ltd 19
Ethyl Alcohol
Apra Enterprises19
Apra Innovative Pvt Ltd 19
Ethyl Benzene
Maruti Petrochem55
Ethyl (ethoxy methylene) cyano acetate
Shamrock Pharmachem38
Ethyl Bromide
Mody Chemi Pharma Pvt. Ltd. 47
Pacific Biochem Private Limited
82
Ethyl Butyl / Methyl / Phenyl Acetate
Meru Chem Pvt. Ltd.105
Ethyl Butyl / Methyl / Phenyl Carbitol
Meru Chem Pvt. Ltd.105
Ethyl Butyl / Methyl / Phenyl Cellosove
Meru Chem Pvt. Ltd.105
Ethyl Butyl / Methyl / Phenyl Glycol
Meru Chem Pvt. Ltd.105
Ethyl Carbitol (IG)
Nisha Chemicals71
Ethyl Carbitol
Paresh Chemical Corporation 78
Ethyl Cellulose
Siddhivinayak Pharma160
Ethyl Cellosolve
Mivon Chemicals 28
Paresh Chemical Corporation 78
Maruti Petrochem55
Ethyl Cellosolve Acetate
Paresh Chemical Corporation 78
Krishna Solvechem Ltd.21
Ethylene Di Bromide (1,2 Di Bromo Ethane)
Pacific Biochem Private Limited82
Ethyl Hexyl Palmitate
Kanchan Rasayan
Ethyl Oleate
Siddhivinayak Pharma160
Ethyl Oleate - IP/BP/USP
Progress Life Sciences Pvt. Ltd.29
Ethyl Oleate-IP,BP/EP,USP
Heni Drugs Pvt. Ltd.49
Ethyl Pyruvate
Indian Platinum Pvt. Ltd.158
Ethyl Tri Phenyl Phosphonium Bromide (ETPPBr)
AD Pharmachem Pvt Ltd
Ethylene Di Bromide
Krishna Solvechem Ltd.21
Ethylene Diamine (EDA)
Krishna Solvechem Ltd.21 Mivon Chemicals
Ethylene Dibromide
Mody Chemi Pharma Pvt. Ltd.
Ethylene Dichloride (EDC)
Apra Enterprises19
Apra Innovative Pvt Ltd19
Ethylene Glycol Di Stearate
Kanchan Rasayan
Ethylene Glycol Distearate (EGDS)
Dev International158
Ethylene Glycol Mono Methyl Ether (Methyl Glycol)
Nisha Chemicals71
Ethylene Glycol Mono Stearate
Kanchan Rasayan
Ethylene Glycol Monostearate (EGMS)
Dev International158
Ethynyl Estradiol Ip/Bp
Balaji Corporation89
Emulsifying Wax (Stearyl Alcohol and Centeareth-20)
Arjun Beeswax Industries169
Emulsifying Wax An Ionic - IP / BP
Arjun Beeswax Industries169
Emulsifying Wax Non-Ionic - BP / USP
Arjun Beeswax Industries169
Etizolam
Luconic Chemicals103
Balaji Corporation89
Aara Pharma150
Etizolam Jp
Aril Pharmaceuticals6/7
Etodolac
Jay Chem Marketing128
NDC Drug & Chemical Co.Pvt.Ltd. 154
Etodolac Ip
Shriya Pharma & Surgical42
Synthetic Molecules71
Etodolac IP/ BP
Hritik Chemicals Pvt. Ltd.99
Etodolac Ip/Usp
Aril Pharmaceuticals6/7
Etofylline
DM Pharma22
Etofenamate Ih/Ep
Pramukh Pharmachem Pvt. Ltd.80
Etoricoxib Prudence Pharma Chem Ear Panel / 81
Nova Chemiie 24
Jay Chem Marketing128
Maruti Industries24
NDC Drug & Chemical Co.Pvt.Ltd. 154
Etoricoxib Ip
Kahan Pharmaceuticals 08
Shriya Pharma & Surgical42
Etoricoxib IP/BP
Hritik Chemicals Pvt. Ltd.99
Eucalyptol
Chemstar Global Products LLP76
Eucalyptus Oil
Global Merchants25
CSV Pharmaceuticals India Pvt. Ltd.169
Vikram Aromatics144
Eucalyptus Oil (All grades)
Vikram Aromatics144
Eudragit (Rs-Rl 103)
Croma Chemical Corporation106
Eugenol
Vikram Aromatics144
Everolimus
Balaji Corporation89
Exemestane
Panchsheel Organics Limited91
Extract Belladona Dry Powder
Kems Raw Pharma93
Extract Belladona Green Veredis Paste
Kems Raw Pharma93
Extract Liver (Paste / Powder)
Kems Raw Pharma93
Extract Malt (Powder / Paste)
Kems Raw Pharma93
Extract Stomach (Paste/ Powder)
Kems Raw Pharma93
Extract Yeast (Paste / Powder)
Kems Raw Pharma93
Extreme Pressure Lubricants
Krishna Antioxidants Pvt. Ltd.87
Famotidine
Panchsheel Organics Limited91
Pharma150
Ferric Ammonium Citrate
Kronox Lab Sciences Limited218
Fertilizers & Soil
Bombay Test House Private Limited93
Ferric Chloride Anhydrous
Sukha Chemical Industries41
Meru Chem Pvt. Ltd.105
Ashapura Intermediates119
Ferrous Ascorbate
Panchsheel Organics Limited91
Parshwa Pharma Chem Pvt. Ltd.40
Ferrous Sulphate Dried Powder
Ascorbate Dc Grade
Pharma Chem Pvt. Ltd.40
Chemiie 24
Ferrous Ascorbate Plain /DC GRADE IP/BP
Hritik Chemicals Pvt. Ltd.99
Ferrous Ascorbate Plain & Dc Ip
Hiten Pharma Chem152
Ferrous bis glycinate
B.Pankaj & Co.84
Ferric Carboxy Maltose
Synthetic Molecules71
Ferric Chloride Anhydrous
Ashapura Intermediates 119
Ferric Chloride Hexahydrate
Sukha Chemical Industries41
Synthetic Molecules71
Ferric Chloride Liquid
Sukha Chemical Industries41
Ferrocence PdCL
Indian Platinum Pvt. Ltd.158
Ferrous Ascorbate / DC Grade
North India Pharma92
Ferrous Fumarate
Kronox Lab Sciences Limited218
HK Group76
Ferrous Fumarate IP/BP/USP/FCC
Ajmera Pharmasure Ltd.15
Ferrous Gluconate BP/USP
Vinworld Healthcare P. Ltd147
Ferrous Glycine Sulphate
Vinworld Healthcare P. Ltd147
Ferric Salts
Shreenath Chemicals82
Ferrous Sulfate Heptahydrate
Kronox Lab Sciences Limited218
Ferrous Sulphate
Ashapura Intermediates 119
Misrimal Pukhraj122
Chemstar Global Products LLP76
Ferrous Sulphate (Crysal/Powder)
SDA Product17
Meru Chem Pvt. Ltd.105
Ferrous Sulphate Dried
Kronox Lab Sciences Limited218
Fexofenadine
Hap Enterprise67
NDC Drug & Chemical Co.Pvt.Ltd. 154
198 THE MAZADA PHARMA GUIDE
34
30
28
47
34
34
Fabric Seal C (Fire Reardants) Relic Chemicals82 Fabric Seal N (Fire Reardants) Relic Chemicals 82 Fabric Seal S (Fire Reardants) Relic Chemicals 82 F.O.S North
India Pharma92 Famotidine
IP/BP/USP Sheetal Chem 101 Faropenem Sodium Shriya Pharma & Surgical42 Fast Green Fcf Lake Standardcon Pvt. Ltd.150 Fast Red E Lake Standardcon Pvt. Ltd.150 Febantal Crystal Pharma76 Nova Chemiie 24 Hap Enterprise67 NDC Drug & Chemical Co.Pvt.Ltd. 154 Febendazole BP/Vet Crystal Pharma76 Kahan Pharmaceuticals 08 Topnotch Chemicals Pvt. Ltd.23 Febantel Dazzle Corporation88 Febuxostat Dazzle Corporation88 Feed Enzyme Enzyme Bioscience57 Fenbendazole IP/BP/USP Nova Chemiie 24 Fenugreek Oil Kamakhya ImpexFlap Frankincense Oil Kamakhya ImpexFlap Fenbendazole Orex Pharma Pvt. Ltd.25 Fenbendazole Reenold Enterprises137 NGL Fine - Chem Limited105 Fenbendazole IP/BP VET /USP/ EP Chemino Pharma Ltd94 Feboxostate Ngl Fine Chem Ltd. 105 Febuxostat Prudence Pharma Chem Ear Panel / 81 Nova Chemiie 24 NDC Drug & Chemical Co.Pvt.Ltd. 154 Febuxostat IP Sheetal Chem 101 Febuxostat Ip/In-H Kahan Pharmaceuticals 08 Febuxostat In-H Aril Pharmaceuticals6/7 Feldspar Sheetal Chem 101 Fenofibrate Nova Chemiie 24 DM Pharma22 Fenofibrate Micronize Sheetal Chem 101 Fenofibrate / Micronised NDC Drug & Chemical Co.Pvt.Ltd. 154 Fenpiverinium Bromide Rumit Group Of Companies78 Tivan Sciences Pvt. Ltd.40 Fenpiverinium Bromide INH Maharshee Laboratories Pvt. Ltd. 133 Fenticonazole Maharshee Laboratories Pvt. Ltd. 133 Fenpiverinum Bromide Luconic Chemicals103 Fenticonazole Nitrate Balaji
Aara
Corporation89
HK
Parshwa
Group76 Ferrous
Nova
PRODUCTS INDEX
Kahan Pharmaceuticals 08
Fexofenadine Granules 48%
YSK Laboratories Pvt. Ltd.56
Fexofenadine HCL-IP/BP/USP/EP
Oceanic Laboratories Pvt. Ltd.44
Fexofenadine- IP/BP/USP
Progress Life Sciences Pvt. Ltd.29
Fexofenadine Hcl IP/ BP
Hritik Chemicals Pvt. Ltd.99
Fexofenadine Hcl Usp
Sheetal Chem 101
Fexofenadine Hcl Ip/Usp
Aril Pharmaceuticals6/7
Fibre Protecting Agents
Krishna Antioxidants Pvt. Ltd.87
Ferric Alum Slab / Lumps
Riddhi Siddhi Dye Chem 137
Field Stain A
Oxford Laboratory Chemicals141
Field Stain B
Oxford Laboratory Chemicals141
Filter Aids (Eq to Hyflo Super Cell)
Jay Chem Marketing128
Filter Papers
B.J. Scientific Co. 162
Filter Bags/Sleeves
FiltraTech Solutions India Private Limited 147
Fish Bone Powder
Eklavya Biotech Pvt. Ltd.103
Fine Chemicals
Shreenath Chemicals82
Filter Presses
FiltraTech Solutions India Private Limited 147
Flitromix Equipmrnts Llp
Filtromix Equipments LLP 149
Finasteride Nova Chemiie 24
Hritik Chemicals Pvt. Ltd.99
Unimax Group 20
Finasteride BP Balaji Corporation89 Fish Lipid Oil BP Neha Pharma Pvt. Ltd.165
Fish Collagen (Marine Collagen)
Eklavya Biotech Pvt. Ltd.103
Fish Manure
SDA Product17 Fish Oil SDA Product17 Flavoxate Ip
Pharmaceuticals6/7
Oil
Merchants25
Gum
ingredients152
North India Pharma92
Flucinole Acetonide
Shree Raj Chem76
Flufenamic Acid Ih
Pramukh Pharmachem Pvt. Ltd.80
Fluocinolone Acetonide
Hritik Chemicals Pvt. Ltd.99 DM Pharma22
Flucinolone Acetonide Ip/Bp
Kahan Pharmaceuticals 08
Flucinolone Salts
Nova Chemiie 24
Flucloxacilin Magnesium Bp
Balaji Corporation89
Flucloxacillin Sodium Sterile
Nova Chemiie 24
Fluconasone Propionate
DM Pharma22
Fluconazole
NDC Drug & Chemical Co.Pvt.Ltd. 154
Nova Chemiie 24
Parshwa Pharma Chem Pvt. Ltd.40
DM Pharma22
Dazzle Corporation88
Fluconazole IP/BP
Hritik Chemicals Pvt. Ltd.99
Fluconazole IP/BP/USP
Aril Pharmaceuticals6/7
Fluconazole IP / USP
Malay Enterprise167
Kahan Pharmaceuticals 08
Fluconazole-Usp/Ip
Hap Enterprise67
Flunerazine
Luconic Chemicals103
Flunarizine
Hap Enterprise67
NDC Drug & Chemical Co.Pvt.Ltd. 154
Flunarizine Di Hcl Bp
Aril Pharmaceuticals6/7
Flunixine Meglumine
Crystal Pharma76
Fluocinolone Acetonide
Balaji Corporation89
Fluoro Benzene
Regal Remedies Limited36
Fluoromethalone
Balaji Corporation89
Fluoromethalone Acetate
Balaji Corporation89
Fluid Bed Dryer Bag
FiltraTech Solutions India Private Limited 147
Fluorspar Dev International158
Fluoro Benzene
Regal Remedies Limited36
Fluoxetine Hcl
Aril Pharmaceuticals6/7
Fluoxetine Hcl IP/BP/USP
Aril Pharmaceuticals6/7
Fluazuron
NGL Fine - Chem Limited105
Fluphenazine Deconate
Luconic Chemicals103
Flupentixol
Luconic Chemicals103
Fluralaner
NGL Fine - Chem Limited105
Flupentixol Hcl
Hap Enterprise67
NDC Drug & Chemical Co.Pvt.Ltd. 154
Fulvic Acid
Chemizo Enterprise166
Flunixin Meglumine
NGL Fine - Chem Limited105
Flupentixol Di Hcl Bp
Aril Pharmaceuticals6/7
Flupirtine Maleate
Vinworld Healthcare P. Ltd147
Maruti Industries24
Flupiritine Maleate I.H.S.
Kahan Pharmaceuticals 08
Flutamide
Panchsheel Organics Limited91
Fluticasone Furoate Ip
Hiten Pharma Chem152
Fluticasone Propionate
Nova Chemiie 24
Hritik Chemicals Pvt. Ltd.99
Unimax Group 20
Fluticasone Propionate / Furoate
Balaji Corporation89
Fluticasone Propionate Ip
Hiten Pharma Chem152
Fluvoxamine Maleate Bp
Aril Pharmaceuticals6/7
Food Products
Bombay Test House Private Limited93
FOA 103 P – Multifunctional Petrol Fuel Additive
Shreedhar Enterprise155
FOA 103 Y –Odor Remover For Purolysis Oil
Shreedhar Enterprise155
FOA 103®- Multifunctional Fuel Oil Additive (Fo, Ldo. Hsd. Lshs Etc )
Shreedhar Enterprise155
FOA 100d7®- Multifunctional Diesel Fuel Additive
Shreedhar Enterprise155
Fosfomycin Sodium Tivan Sciences Pvt. Ltd.40
Fosfomycin Trometamol
Tivan Sciences Pvt. Ltd.40
Fofomycin international drug & chemical co.165
Folic Acid
Parshwa Pharma Chem Pvt. Ltd.40
NDC Drug & Chemical Co.Pvt.Ltd. 154
Dev International158
Chemizo Enterprise166
U.K. Vet Chem65
Folic Acid Food Grade
Raivat Impex Pvt. Ltd.59
Folic Acid IP
Malay Enterprise167
Food Enzyme
Enzyme Bioscience57
Folic Acid IP/ BP
Hritik Chemicals Pvt. Ltd.99
Folic Acid IP/BP/USP
Shree Raj Chem84
Crystal Pharma77
Nova Chemiie 24
Jakson Pharma104
Folic Acid Ip / Nutra
DM Pharma22
Follicle Stimulating Hormone (Fsh)
Balaji Corporation89
Formamide
Mivon Chemicals 28
Nisha Chemicals71
Meru Chem Pvt. Ltd.105
Formaldehyde
Misrimal Pukhraj122
Formaldehyde 37%
Ketan Chemical Corporation119
Khushbu Dye Chem Pvt. Ltd.71
Meru Chem Pvt. Ltd.105
Formamidine Acetate
Asiel Chemipharma35
Formic Acid
Keshariya Corporation80
Krishna Solvechem Ltd.21
SDA Product17
Ashapura Intermediates 119
Apra Enterprises19
Apra Innovative Pvt Ltd19
Formic Acid (93 % / 99 %)
H K Enterprise151
Nisha Chemicals71
Krishna Solvechem Ltd.21
Meru Chem Pvt. Ltd.105
Chemstar Global Products LLP76
Maruti Petrochem55
Formic Acid 93%
Khushbu Dye Chem Pvt. Ltd.71
Rajan Dye Chem155
Formic Acid 85%
Thana Acid & Chemical Co145
Formic Acid 99%-Finland
Mivon Chemicals28
Chemaroma Drug House 91
Formalin / Formaldehyde 37, 38%
Crystal Pharma76
Fosfomyicin Sodium
Balaji Corporation89
FRP Pultruded Grating
Plastic Fabricators59
FRP Ladders
Plastic Fabricators59
FRP Pultruded Sections Plastic Fabricators59
FRP LINING
Plastic Fabricators59
Fructo Oligo Saccharide liq, and powder
Advance in Organics LLP128
Fructose Crystalline/Fine Powder
Advance in Organics LLP128
Frusemide IP / BP
Arco Pharma126/164
Friedle Craft Reaction
Pacific Biochem Private Limited82
Fully Refined Paraffin Wax (Granule (Pellets) & Slab)
Ketan Chemical Corporation119
Fumaric Acid
Kronox Lab Sciences Limited218
HK Group76
Fumed Silica ( Eq to Colloidal Silicon Dioxide)
Jay Chem Marketing128
Fungal Alpha Amylase Diastase 1:2000 Ip
Jakson Pharma104
Fungal Diastase 1:2000 Ip
Jakson Pharma104
Fungal Diastase 1:5000 Ip
Pharmaceuticals6/7 Gamithromycin
Calyx Chemical & Pharmaceuticals Ltd.23
Gama Benzoin Hexa Chloride Kems Raw Pharma93 Gamma Aminobutyric Acid (GABA) Chemkart163
Gamma Amino Butyric Acid
Raivat Impex Pvt. Ltd.59
Butyrolactone
Chemicals Pvt. Ltd.81
Linolenic Acid (Gla Powder)
Acid (Gla) Powder
Organics Limited91
Antioxidants Pvt. Ltd.87
Gatifloxacine
Panchsheel Organics Limited91
Gatifloxacin Sesquihydrate Nova Chemiie 24
Oil Kamakhya ImpexFlap
Garcinia Cambogia Extract CSV Pharmaceuticals India Pvt. Ltd.169
Gefitinib
Balaji Corporation89
Gelatin
Siddhivinayak Pharma 160
Gelatine Peptone
Eklavya Biotech Pvt. Ltd.103
Gentamycin Sulphate
Unitrade Agencies70
Shree Raj Chem84
Gentamycine Sulphate Bp/Usp
Pharma76 Gention Violet / Crystal Violet
Pharma Chem84
Oil (Indian, Chinese , Egyptian)
Essentials51
ingredients152
Pharma22 Gestodene
Chemicals Pvt. Ltd.99
Gfl Products Dev International158
Ghrp6 Balaji Corporation89
Ganciclovir
Aromatics and Chemicals Pvt. Ltd. 103
THE MAZADA PHARMA GUIDE 199
Aril
Flaxseed
Global
Flaxseed
Labh
Flourometholone
Jakson Pharma104 Furaltadone Hcl Crystal Pharma76 Furazolidone Bp/Usp Crystal Pharma76 Furosemide Nova Chemiie 24 NDC Drug & Chemical Co.Pvt.Ltd. 154 Furosemide IP Siddhivinayak Pharma 160 Hap Enterprise67 Fusidic Acid Balaji Corporation89 Aril Pharmaceuticals6/7 NDC Drug & Chemical Co.Pvt.Ltd. 154 Hydrate Lime (80% - 90%) Riddhi Siddhi Dye Chem 137 G.H. 17 Misrimal Pukhraj122 Gabapentin Vinworld Healthcare P. Ltd147 Hap Enterprise67 NDC Drug & Chemical Co.Pvt.Ltd. 154 Unimax Group 20 Kahan Pharmaceuticals 08 Gabapentin Hcl Ip / Usp Sheetal Chem 101 Gabapentin Ip/Ep/Usp DM
Gabapentine
Pharma22
Ip/Usp Aril
Gamma
Kip
Gamma
North
Gammalinolenic
Panchsheel
Gasoline Krishna
India Pharma92
Garlic
Crystal
Aditi
Gellan
Labh
Gautam
Geranium
Gum
Gestidene DM
Hritik
Gibberelic
Croma Chemical Corporation106 Ginamide Kanchan Rasayan 34 Ginger Extract CSV
Pvt. Ltd.169 Ginger Grass Oil CSV Pharmaceuticals India Pvt. Ltd.169 Ginger Oleoresin CSV Pharmaceuticals India Pvt. Ltd.169 Gliclazite-IP/BP Oceanic Laboratories Pvt. Ltd.44 Gliclazite-IP/BP/USP/EP Oceanic Laboratories Pvt.
Ginkgo Biloba Extract North India Pharma92 Ginkgo Biloba Extract Raivat Impex Pvt.
Ginkgo Biloba Extract 24 % Global Merchants25 Ginocel 165 Kanchan Rasayan 34 Ginodet BKC 50% Kanchan Rasayan 34 Ginodet BKC 80% Kanchan Rasayan 34 Ginodet DLSS Kanchan Rasayan 34 Ginol 1214 Kanchan Rasayan 34 Ginol 16 Kanchan Rasayan 34 Ginol 1618 50:50 Ginol 1214 (Lauryl Myristyl Alcohol) Ginol 1618 TA (IP/BP) / 50:50 Kanchan Rasayan 34 Ginol 1618 TA Kanchan Rasayan 34 Ginol 18 Kanchan Rasayan 34 Ginol EW 6820 Non Ionic Kanchan Rasayan 34 Ginol EW 68S Anionic Kanchan Rasayan 34 Ginomol PEG-7 GC Kanchan Rasayan 34 Ginonic CSA 20
Bakul
Acid (Ga 90%)
Pharmaceuticals India
Ltd.44
Ltd.59
PRODUCTS INDEX
Glycerine Ip / Usp
Petrochem55
Glycine Powder Global Merchants25
Glycerine - IP / BP / USP / EP
Arjun Beeswax Industries169
Glycogen Ar/Acs Croma Chemical Corporation106
Thermometer
Avi Scientific (India)168
Glass & Ink Bombay Test House Private Limited93
Glycolic Acid
Asiel Chemipharma35
Chemicals71
Acid -50%
Chemicals Pvt. Ltd.81
Monostearate- IP / EP
Beeswax Industries169
Monostearate SE-BP
Beeswax Industries169
Gbl Chemical Limited73
H2S Scavenger
Krishna Antioxidants Pvt. Ltd.87
H2S Scavanger
Relic Chemicals82
H.P.M.C
Exci Gen 117
Siddhivinayak Pharma160
HPMC-K-100M
Malay Enterprise167
HPMC E-15
Malay Enterprise167
HPMC E-5
Malay Enterprise167
H.P.M.C P
Siddhivinayak Pharma160
Haiti For Vetiver Oil
Aditi Essentials51
Hand Inkjet Printer
Advanced
Merchants25 Ginseng Extract 4% / 20%
Raivat Impex Pvt. Ltd.59
Ginseng Extract & Powder
North India Pharma92
Panchsheel Organics Limited91
Ginseng Extract Powder / Ginseng Powder
Gautam Pharma Chem84
Siddhivinayak Pharma 160
Glibenclamide
Nova Chemiie 24
Glibenclamide [Glyburide]
Prudence Pharma Chem Ear Panel / 81
Glibemclamide BP/EP Vinworld Healthcare P. Ltd147
Gliclazide
NDC Drug & Chemical Co.Pvt.Ltd. 154 DM Pharma22
Aril Pharmaceuticals6/7 Vinworld Healthcare P. Ltd147
Chemino Pharma Ltd94
Gliclazide SR Granules 48%
YSK Laboratories Pvt. Ltd.56
Gliclazide Bp/Ip
Shriya Pharma & Surgical42
Glimepride
Panchsheel Organics Limited91
Prudence Pharma Chem Ear Panel / 81
Espee Pharma Chem Pvt. Ltd.94
Nova Chemiie 24
Aril Pharmaceuticals6/7
Parshwa Pharma Chem Pvt. Ltd.40
Aara Pharma150
DM Pharma22
NDC Drug & Chemical Co.Pvt.Ltd. 154
Glimepiride - EP/USP Progress Life Sciences Pvt. Ltd.29
Glimepiride IP/BP/EP/USP
90 Elementos Pvt. Ltd. 104
Glimepride IP/BP
Hritik Chemicals Pvt. Ltd.99
Glimipride IP/BP/USP
international drug & chemical co.165
Kahan Pharmaceuticals 08
Glipizide IP/BP/USP international drug & chemical co.165
Aril Pharmaceuticals6/7
Glipizide-IP/BP/USP/EP
Oceanic Laboratories Pvt. Ltd.44
Glucono Delta Lactone
Regent Chemicals 41
Zuhhad International 86
Glucosamine Hcl
Nova Chemiie 24
Glucosamine HCL
Raivat Impex Pvt. Ltd.59
Glucosamine Sulphate Potassium Chloride Nova Chemiie 24
Raivat Impex Pvt. Ltd.59
Glucose Anhydrous Bp
Shree Chemicals117
Glutaraldehyde Maruti Petrochem55
Glutaraldehyde-50%
Kip Chemicals Pvt. Ltd.81
Gluteraldehyde 50% Sol Crystal Pharma76
Glutathione Chemkart163
Glycine Nisha Chemicals71 Chemkart163
Glycine Usp / Technical Raivat Impex Pvt. Ltd.59
Glycerine Siddhivinayak Pharma160 Khushbu Dye Chem Pvt. Ltd.71 Parshwa Pharma Chem Pvt. Ltd.40 Gandhi Chemicals 144 Dev International158
Glycerine 99.5
Rajan Dye Chem155
Glycerine ( Ip / Bp / Cp / Usp / Bulk / Fssai / Imported ) H K Enterprise151
Glyceryl Mono Stearate (SE-NSE) Yuvi Chemz148
Moisture Analyzer (He53, HE73 , Hc103)
III Chloride Hydrate
Platinum Pvt. Ltd.158
& Silver Assaying & Hallmarking
Test House Private Limited93
Chloride
Platinum Pvt. Ltd.158
Gold Chloride (24% And 49% )
Oxford Laboratory Chemicals141
Gold Metal Powder
Indian Platinum Pvt. Ltd.158
Granisetron Hcl
Panchsheel Organics Limited91
Balaji Corporation89
Granisetron Hydrochloride IP/BP/USP
Chemino Pharma Ltd94
Grape Seed Extract
North India Pharma92
Global Merchants25
CSV Pharmaceuticals India Pvt. Ltd.169
Grape Seed Extract
Raivat Impex Pvt. Ltd.59
Grapefruit Wax Flora Dye Chem
Green Tea Extract Global Merchants25
CSV Pharmaceuticals India Pvt. Ltd.169
Raivat Impex Pvt. Ltd.59
Green Tea Extract 103%
North India Pharma92
Grisofulvin
Parshwa Pharma Chem Pvt. Ltd.40
Ground Lime Stone USP
Hritik Chemicals Pvt. Ltd.99
Grignard Reaction
Pacific Biochem Private Limited
82
Groundnut Meal
SDA Product17
Grubbs Catalysts
Indian Platinum Pvt. Ltd.158
Guaifenesin
DM Pharma22
Vinworld Healthcare P. Ltd147
Guaifenesin Ip
Kahan Pharmaceuticals 08
Guaifensin IP/BP
Hritik Chemicals Pvt. Ltd.99
Guainphesin (Gg Ether)
Shree Raj Chem84
Guar Acacia IP / BP / USP / EP
Amit Hydrocolloids53
Guar Gum
Labh ingredients152
Gum Acacia
Gum Carrageenan
Gum Tragacanth
Labh ingredients152
Guar B.P.
Hritik Chemicals Pvt. Ltd.99
Guar Gum
Siddhivinayak Pharma160
Western Pharma105
Guar Gum
Advance in Organics LLP128
Guar Gum IP
Hritik Chemicals Pvt. Ltd.99
Guar Gum IP / BP / USP / EP
Amit Hydrocolloids53
Guar Hydroxyl Trimonium Chloride (GHTC)
Dev International158
Guggul Extract 2.5%
Global Merchants25
Gum Acacia
Kems Raw Pharma93
Gum Guar
Kems Raw Pharma93
Gum Tragacanth
Kems Raw Pharma93
Gum Xanthan IP / BP / USP / EP
Amit Hydrocolloids53
Guaifenisin IP / USP
Vinworld Healthcare P. Ltd147
Gurujan Balsam Oil
Aditi Essentials51
Gylcine IP
Arco Pharma126/164
Glycrine
Om Pharma Chem48
Glyceryl Tribenzoate
international drug & chemical co.165
Health Supplements/ Nutraceuticals Chemkart163
Heavy / Light Liquid Paraffin IP/ BP Hritik Chemicals Pvt. Ltd.99
Heavy Magnesium Oxide Arco Pharma126/164 HEDP 60%
Petrochem55 HEC Labh ingredients152 HCL Tanker Load..& More... Yuvi Chemz148
Hclthiosemicarbazide
Orex Pharma Pvt. Ltd.25
Hesperidin 90%
Raivat Impex Pvt. Ltd.59
Helobetasol Bp/Usp
Balaji Corporation89
Hematoxylin Stain Certified
Oxford Laboratory Chemicals141
Hemp Seed Oil
Kamakhya ImpexFlap
Hemihydrate
Hritik Chemicals Pvt. Ltd.99
Hesperidin 90%
Raivat Impex Pvt. Ltd.59
Heparin Sodium
Unitrade Agencies70
Vinworld Healthcare P. Ltd147
Heparin Sodium (Bovin / Porcine)
Vinworld Healthcare P. Ltd147
Heptane
Krishna Solvechem Ltd.21
Hexachloro Patinic Acid
Indian Platinum Pvt. Ltd.158
Hexa Chloro Acetone
Rare Pharma Pvt. Ltd.148
Hexafluorophosphoric Acid
Regal Remedies Limited36
Hexahydrate
Qualikems Lifesciences Pvt. Ltd.139
Hexyl Salicylate
Rare Pharma Pvt. Ltd.148
Hexa Methyl DiSilazane (HMDS)
Nisha Chemicals71
Hexamine
Nisha Chemicals71
Paresh Chemical Corporation 78
Hexamine 99%
Ketan Chemical Corporation119
Hexane
Krishna Solvechem Ltd.21
Hibiscus Extract
Global Merchants25
Hippuric Acid
Synthetic Molecules71
High Oleic Sunflower Oil (HOSO)
Krishna Solvechem Ltd.21
High Methoxyl Pectin (/Apple)
Labh ingredients152
HPMC
Labh ingredients152
Hyflow Filter Aid
Vipchem Enterprises 105
HMB-Calcium Chemkart163
Homidium Chloride
Ngl Fine Chem Ltd. 105
Homatropine Hydrobromide
Aril Pharmaceuticals6/7
200 THE MAZADA PHARMA GUIDE
Kanchan Rasayan 34 Ginonic CSA 25 Kanchan Rasayan 34 Ginonic L 247 Kanchan Rasayan 34 Ginonic S 2 Kanchan Rasayan 34 Ginonic S 20 Kanchan Rasayan 34 Ginonic S 21 Kanchan Rasayan 34 Ginopol 24N Kanchan Rasayan 34 Ginopol 24P Kanchan Rasayan 34 Ginopol L24 Kanchan Rasayan 34 Ginopol P24 Kanchan Rasayan 34 Ginoquat 7 Kanchan Rasayan 34 Ginoquat HPC Kanchan Rasayan 34 Ginowax Kanchan Rasayan 34 Ginseng
Global
Extract 4%
Glycerine BP Kanchan Rasayan 34 Glycerine CP Kanchan Rasayan 34 Ashapura Drugs 21 Mivon Chemicals 28 Glycerine CP / IP / USP Malay Enterprise167 Glycerine EP Kanchan Rasayan 34 Glycerine Food Kanchan Rasayan 34 Glycerine IP Kanchan Rasayan 34 Glycerol Mono Stearate Kanchan Rasayan 34
Stearate & PEG-103 Stearate
34
Shree
Glycerine
Kanchan
34 Maruti
Glyceryl Esters Aarbee International30 Glyceryl
Kanchan Rasayan
Raj Chem84
USP
Rasayan
Glass
Glyoxal
Nisha
Arjun
40%
Glyoxylic
Kip
Glyceryl
Arjun
Glyceryl
Godrej P 10 Kanchan Rasayan 34 Godrej P 150 Kanchan Rasayan 34 Godrej P 25 Kanchan Rasayan 34 Godrej P 5 Kanchan Rasayan 34 Godrej
L24 230 Kanchan Rasayan 34 Godrej SLES P24 270 Kanchan Rasayan 34 Gold
Indian
Gold
Bombay
Gold
SLES
Indian
126
Industrial Micro Systems 25 Halobetasole
DM
Hritik
Halquinol
Orex
Halobetasole
Kahan
08
Aril
Hand Laser Advanced Industrial Micro Systems
Hand Gloves
Safety
Sanjay
Halquinol BP 80,
Reenold
Halquinol
Topnotch
Halquinol
Orex Pharma
Hard
Wax Western
Hard
Arjun
Hardwax
Balaji Corporation89 HBR 33% in Acetic Acid Krishna Solvechem Ltd.21 Hbr In Acetic Acid 33% Pacific Biochem Private Limited 82 HBR In Acetic Acid 33 % Mody Chemi Pharma Pvt. Ltd. 47 Hbr In Acetic Acid 35% Mody Chemi Pharma Pvt. Ltd. 47 Herbal Extracts
Propionate
Pharma22
Chemicals Pvt. Ltd.99
106 %
Pharma Pvt. Ltd.25
Propionate Usp
Pharmaceuticals
Halogen
Khushboo Scientific13 Haloperidole Ip/Ep
Pharmaceuticals6/7
25
& Other
Items
Enterprises143 Halquinol Feed Grade 60% Rosetta Life Care Private Limited14
60%, 24%&12.5%
Enterprises137
60% / 106%
Chemicals Pvt. Ltd.23
60%
Pvt. Ltd.25
Paraffin
Pharma105
Paraffin Wax - IP / BP / USP / EP
Beeswax Industries169
& All Wax
Maruti
PRODUCTS INDEX
Homogeneous Precious Metal Catalyst For Cross-Coupling
Reaction
Omkar Lab155
Homogenising
Filtromix Equipments LLP 149
Honey Pure Natural - IHS
Arjun Beeswax Industries169
Hpmc All Grade
Dev International158
HTHP Fluid Loss Reducing Additives
Krishna Antioxidants Pvt. Ltd.87
Human Growth Hormone (Hgh)
Balaji Corporation89
Humic Acid
SDA Product17
Humidity (Stability) Chamber
Kesar Control Systems49
Husil 200 (Colloidal Silicon Dioxide)
Keshav Hichem Pvt. Ltd.21
Hyaluronic Acid
Jakson Pharma104 Chemkart163
Hyflow Supercell
Keshariya Corporation80
Hydrated Lime
SDA Product17
Misrimal Pukhraj122
Hydrazine Hydrate 103%
Nisha Chemicals71
Hydrazine Hydrate 64%
Mody Chemi Pharma Pvt. Ltd. 47
Hydrazine Hydrate 80%
Krishna Solvechem Ltd.21
Hydraulic & Gear Oils
Krishna Antioxidants Pvt. Ltd.87
Hydrobromic Acid
Mody Chemi Pharma Pvt. Ltd. 47
Hydrobromic Acid 48%
Meru Chem Pvt. Ltd.105
Pacific Biochem Private Limited82
Hydroxylamine Hydrochloride
Chemizo Enterprise166
Hydroxylamine Sulphate >99%
Chemizo Enterprise166
Hydroxylamine Sulphate
Chemizo Enterprise166
Hydrochloric Acid
Dev International158
Hydrocholorothiazide Ep/Usp
DM Pharma22
Hydrochlorothiazide IP – IPCA
Dev Pharmaceuticals 164
Hydrochlorothiazide HCl
Shamrock Pharmachem38
Hydrochlorothiazide IP/BP/USP
Aril Pharmaceuticals6/7
Hydrocortisone Acetate
Panchsheel Organics Limited91
Balaji Corporation89
Panchsheel Organics Limited91
Rumit Group Of Companies78
Hydrocortisone Acitate Ip
Hiten Pharma Chem152
Hydrocortisone Salts
Nova Chemiie 24
Aara Pharma150
Hydrocortisone Sodium Succinate
Vinworld Healthcare P. Ltd147
Hydrogen Gas
Dev International158
Hydrogen Hydrate 80% - 103%
Mivon Chemicals
Hydrogen Peroxide
28
Krishna Solvechem Ltd.21
Paras Chem (India)166
Dev International158
Hydrogen Peroxide - 35%/ 50%
Meru Chem Pvt. Ltd.105
Hydrogen Peroxide 50%
Khushbu Dye Chem Pvt. Ltd.71
Mivon Chemicals 28
Rajan Dye Chem155
Hydrogen Phosphate
Pari Chemicals136
Hydrogenated Palm Stearin
Siddharth International101
Hydrogenated Castor Oil Ethoxylate
Shree Vallabh Chemical48
Hydrogenated Soya Oil
Siddharth International101
Hydrogenated Technical Oil
Siddharth International101
Hydrogenated Vegetable Oil (HVO)
Krishna Solvechem Ltd.21
Hydrogenation Job-Work
Omkar Lab155
Hydroiodic Acid
SVG Pharma Lifesciences Pvt. Ltd.145
Hydroquinone
Meru Chem Pvt. Ltd.105
Chemstar Global Products LLP76
Hydroquinone Usp
Panchsheel Organics Limited91
Hydroxychloroquine Sul.
Aril Pharmaceuticals6/7
Hydroxocobalamin
DM Pharma22
Hydroxocobalamin Acetate
DM Pharma22
Balaji Corporation89
Hydroxocobalamin Chloride
DM Pharma22
Hydroquinone
Relic Chemicals82
Hydroxocobalamin Sulphate
DM Pharma22
Hydroxychloroquine
Zuhhad International 86
Hydroxycobalamin
Pravinchandra & Co.13
Hydroxylamine Hcl
Qualikems Lifesciences Pvt. Ltd.139
Synthetic Molecules71
Hydroxylamine-O-Sulphonic Acid
Ram Enterprise 76
Zuhhad International 86
Hydroxylamine Sulfate
Khushbu Dye Chem Pvt. Ltd.71
Hydroxylamine Sulfate (HAS)
Nisha Chemicals71
Hydroxylamine Sulphate
Krishna Solvechem Ltd.21
Hydroxy Novaldiamine
Zuhhad International 86
Hydroxy Progesterone Caproate
Balaji Corporation89
Panchsheel Organics Limited91
Hydroxy Progesterone Caproate (HPC) - IP / USP
VM Life Science108
Hydroxypropyl Beta Cyclodextrin HPBCD
Vinworld Healthcare P. Ltd147
Hydroxy Propyl Methylene Cellulose (Hpmc)
(K-15M Premium Dow USA 25KG Drum)
Mivon Chemicals 28
Hydroxyurea
Vinworld Healthcare P. Ltd147
Hydroxyzine HCL
Panchsheel Organics Limited91
Vinworld Healthcare P. Ltd147
Aril Pharmaceuticals6/7
NDC Drug & Chemical Co.Pvt.Ltd. 154
Hydroxyzine Hcl Ip
Hap Enterprise67
Hydrochloric Acid (HCL)
Thana Acid & Chemical Co145
Hydroxyzine Hcl Ip/Usp
Balaji Corporation89
Hypromellose Acetate Succinate (Hpmcas) Usp
G. M. Chemie Pvt. Ltd.143
Hypromellose Phthalate (Ip/Bp/Usp/Ep/Jp)
G. M. Chemie Pvt. Ltd.143
Hyoscine Butyl Bromide
Vinworld Healthcare P. Ltd147
Hyoscine Butyl Bromide IP / BP
Malay Enterprise167
I.P.A
Shree Raj Chem84
Siddhivinayak Pharma160
Parshwa Pharma Chem Pvt. Ltd.40
Misrimal Pukhraj122
H K Enterprise151
Maruti Petrochem55
Ibuprofen
Aara Pharma150
Vinworld Healthcare P. Ltd147
NDC Drug & Chemical
Reenold Enterprises137 Ibuprofen Ip/Bp
Pharma22 Ibuprofen IP/BP/USP
Pharmaceuticals76/7Malay
Ip
Mesylate
Drug & Chemical
Imipramine Hcl Ip/Bp Aril Pharmaceuticals6/7
Imipramine Hydrochloride
Panchsheel Organics Limited91
Immersion Oil
Qualikems Lifesciences Pvt. Ltd.139 Oxford Laboratory Chemicals141
Imino Ether
Unimax Group
Infringement Analysis
Gnanlex Associates LLP169
IP Audit
Gnanlex Associates LLP169
IP Audit & IP Portfolio Creation and Maintenance
Gnanlex Associates LLP169
IP Due Diligence
Gnanlex Associates LLP169
IP Licensing & Technology Transfer
Gnanlex Associates LLP169
Inactive Yeast
Eklavya Biotech Pvt. Ltd.103
Indapamide Balaji Corporation89
Indapamide IP Siddhivinayak Pharma160
Indapamide Usp
Aril Pharmaceuticals6/7
international drug & chemical co.165
Indigo Carmine Lake
Standardcon Pvt. Ltd.150
Indion-204/234/214/244/254/294/414/454 In-H
Aril Pharmaceuticals6/7
Indium nitrate
Indian Platinum Pvt. Ltd.158
Indium Oxide
Indian Platinum Pvt. Ltd.158
Industrial Filter Fabrics
Sanjay Enterprises143
Industrial & Fine Chemicals
Bombay Test House Private Limited93
Industrial Oils and Lubricants
Bombay Test House Private Limited93
Indium phosphate
Indian Platinum Pvt. Ltd.158
Indium Sulphate
Indian Platinum Pvt. Ltd.158
Indole-3-Acetic Acid
Krishna Solvechem Ltd.21
Indomethacin
Panchsheel Organics Limited91
Hap Enterprise67
Indometacin
NDC Drug & Chemical Co.Pvt.Ltd. 154
Indomethacin -Tr -28% Pellets
Panchsheel Organics Limited91
Indomethacin BP
Siddhivinayak Pharma160
Industrial Salt
SDA Product17
Inositol International drug & chemical co.165
Inositol / Myo-Inositol
Raivat Impex Pvt. Ltd.59
Inositol (Vitamin B8) Chemkart163 Itermediate
THE MAZADA PHARMA GUIDE 201
Co.Pvt.Ltd. 154
Aril
Enterprise 167 Illzole
Kahan
08 Ilaprazole Sheetal Chem 101 lloperidone Vinworld Healthcare
Imatinib
Vinworld Healthcare P.
Imeglimin Sheetal Chem 101 Imidocarb Dipropionate Ngl Fine Chem Ltd. 105 Imipramine
NDC
Co.Pvt.Ltd. 154
DM
Pharmaceuticals
P. Ltd147
Ltd147
Hcl
20
Rolence Pharma
Inositol
Crystal
Inorganic Bromide Pacific Biochem Private Limited 82 Iodic Acid SVG Pharma Lifesciences Pvt.
Iodic Acid ACS Heni Drugs Pvt. Ltd.49 Iodine Amino Acid Chelate Eklavya Biotech Pvt. Ltd.103 Iodine Pentoxide Heni Drugs Pvt. Ltd.49 Iodine 99.7% Min. Bronze Chem Enterprise106 Iodine / Povidon Iodine HK Group76 Iodine Crystal Ip Crystal Pharma76 Iodine Monobromide Oxford Laboratory Chemicals141 Iodine Monochloride SVG Pharma Lifesciences Pvt. Ltd.145 Iodised Salt SDA Product17 Iodochlorohydroxyquinoline Ip/Bp Balaji Corporation89 Iodoform Kems Raw Pharma93 IPA Kanchan Rasayan 34 Stratechem (I) Pvt. Ltd. 88 IPA BP Kanchan Rasayan 34 IPA IP Kanchan Rasayan 34 IPA USP Kanchan Rasayan 34 Irbesartan Luconic Chemicals103 Nova Chemiie 24 Irbesartan Usp Kahan Pharmaceuticals 08 Iridium Chloride Indian Platinum Pvt. Ltd.158 Iron Amino Acid Chelate Eklavya Biotech Pvt. Ltd.103 Iron (Iii) PolyMaltose international drug & chemical co.165 Iron Oxide (Red / Yellow / Black / Brown ) Standardcon Pvt. Ltd.150 Iron Protein Succinylate international drug & chemical co.165 Iron Pairing Reagents Powder Pack Chem129 Ironiiihydroxy Poly. Aril Pharmaceuticals6/7 Iron Iii Polymaltos 34% In-H Aril Pharmaceuticals6/7 Iron Powder Electrolytic / Reduction Gangotri Inorganic (P) Ltd.18 Iron Sorbitol DM Pharma22 Iron Sucrose Nova Chemiie 24 Progress Life Sciences Pvt. Ltd.29 Hap Enterprise67 NDC Drug & Chemical Co.Pvt.Ltd. 154 Iron Sucrose Complex Nova Chemiie 24 Iron Oxide Red / Yellow / Black Siddhivinayak Pharma160 Isatoic Anhydride Inventys58 Isometamidium NGL Fine - Chem Limited105 Iso Ambrettolide Krishna Solvechem Ltd.21 Iso Amyl Bromide Mody Chemi Pharma Pvt. Ltd. 47 Iso Butanol Mivon Chemicals 28 Khushbu Dye Chem Pvt. Ltd.71 Paresh Chemical Corporation 78 Krishna Solvechem Ltd.21 Meru Chem Pvt. Ltd.105 Iso Butraldehyde Amita Chemicals102 Isophthalic Acid Relic Chemicals82 Isopropyl Alcohol Relic Chemicals82 Iso Amyl Bromide Pacific Biochem Private Limited82 Iso Butyl Bromide Mody Chemi Pharma Pvt. Ltd. 47 Isobulyraldehyde Kip Chemicals Pvt. Ltd.81 Iso Butyl Bromid Pacific Biochem Private Limited 82 Isoconazole Nitrate Balaji Corporation89 Isochroman Ram Enterprise 76 Isoflupredone Acetate Balaji Corporation89 Isolated Soya Protine Powder 90% Kems Raw Pharma93 Isoniazide Vinworld Healthcare P. Ltd147 Isoniazid Ip / Bp Rajshi Chemical & Products 143 Iso Octane Mivon Chemicals 28 Isophorone Khushbu Dye Chem Pvt. Ltd.71 Krishna Solvechem Ltd.21 Iso Propyl Alchohol (IPA) Kanchan Rasayan 34 Krishna Solvechem Ltd.21 Mivon Chemicals 28 Khushbu Dye Chem Pvt. Ltd.71 Amita Chemicals102 Gandhi Chemicals 144
& Ambroxol -Hd
& Chemicals127
Usp
Pharma76
Ltd.145
PRODUCTS INDEX
Chemstar Global Products LLP76
Iso Propyl Alcohol (IPA) Malay Enterprise167
Keshav Hichem Pvt. Ltd. 21
Iso Propyl Alcohol BP
Kanchan Rasayan 34
Iso Propyl Alcohol IP
Kanchan Rasayan 34
Iso Propyl Alcohol USP
Kanchan Rasayan 34
Iso Propyl Bromide
Pacific Biochem Private Limited82
Iso Propyl Myristate
Siddhivinayak Pharma160
Mivon Chemicals 28
Iso Propyl Palmited
Siddhivinayak Pharma160
Regent Chemicals 41
Iso Propyl Acetate
Chemex Organochem Pvt. Ltd.69
Iso Proply Alcohol (IPA) Western Pharma105
Iso Propyl Bromide
Mody Chemi Pharma Pvt. Ltd. 47
Isopropyl Myristate
Kanchan Rasayan 34
Isopropyl Palmitate
Kanchan Rasayan 34
Isopropyl Thiophenol
Stratechem (I) Pvt. Ltd. 88
Isotretinoin
Panchsheel Organics Limited91
NDC Drug & Chemical Co.Pvt.Ltd. 154
Isotretinoin Pellets
Panchsheel Organics Limited91
Isovaleraldehyde Jay Chem Marketing128
Isoxsuprine Hcl Ip
Kahan Pharmaceuticals 08
Shriya Pharma & Surgical42
Isoxsuprine HCL IP/ BP
Hritik Chemicals Pvt. Ltd.99
Isotretinoin
Balaji Corporation89
Isotridecyl Stearate
Heni Drugs Pvt. Ltd.49
Iso Tretinoin Ip/Bp/Usp Hiten Pharma Chem152
Isoxepac (intermediate Of Olopatadine Hydrochloride)
Synchrom Laboratory Pvt Ltd146
Ispaghula Husk IP/ BP
Hritik Chemicals Pvt. Ltd.99
Itaconic Acid
Nisha Chemicals71
Itopride
Hap Enterprise67
NDC Drug & Chemical Co.Pvt.Ltd. 154
Itopride HCL
International Drug & Chemical Co.165
Tivan Sciences Pvt. Ltd.40
Itraconazole
Sheetal Chem 101
Vinworld Healthcare P. Ltd147
DM Pharma22
Itraconazole (22% / 40%/ 44%)
Kahan Pharmaceuticals 08
Itracornazole Usp
Kahan Pharmaceuticals 08
Itraconazole Pellets
Western Pharma105
Itraconazole Pellets 20%/ 22% / 44% / 40%
Balaji Corporation89
Sheetal Chem101
Ivabradine HCL
DM Pharma22
International Drug & Chemical Co.165
Ivabradine
Balaji Corporation89
Ivermactin
Parshwa Pharma Chem Pvt. Ltd.40
NDC Drug & Chemical Co.Pvt.Ltd. 154
Ivermectin Ep Vi / Ip Crystal Pharma76
Ivermectin Ip/ Ipvet
U.K. Vet Chem65
Ivermectine Ip
Balaji Corporation89
Japan Wax / Substitute (H)
Flora Dye Chem 126
Jelly Wax
Flora Dye Chem 126
Jojoba Wax
Flora Dye Chem 126
Jojoba Oil
Kamakhya ImpexFlap
Jet Mill/Microniser Bags
FiltraTech Solutions India Private Limited 147
Kaolin / China Clays
Suraiya Private Ltd.93
Ketoconazole
Nova Chemiie 24
Parshwa Pharma Chem Pvt. Ltd.40
Ketoconazole IP/BP/USP/EP
Aril Pharmaceuticals6/7
Ketoprofen
NDC Drug & Chemical Co.Pvt.Ltd. 154
Unimax Group 20
Maharshee Laboratories Pvt. Ltd. 133
Ketoprofen Ep DM Pharma22
Ketoprofen
international drug & chemical co.165
Ketoprofen
International Drug & Chemical Co.165
Ketorolac Tromethamine
Jay Chem Marketing128
Ketosulfone Of Etoricoxib
Prudence Pharma Chem Ear Panel / 81
Ketrolac Tromethamine
Sheetal Chem 101
Ketorolac Tro [Tab/Inj] Ip/Usp
Aril Pharmaceuticals6/7
Knitting Oil
Krishna Antioxidants Pvt. Ltd.87
Kunsil Fs 200 (Fumed Silica)
Keshav Hichem Pvt. Ltd. 21
Kokum Butter
Aditi Essentials51
Konjac Gum
Labh Ingredients152
Kokum Butter - IHS
Arjun Beeswax Industries169
Kojic Acid & Kojic Acid Dipalmitate
North India Pharma92
Kojic Acid Dipalmitate
Oceanic Laboratories Pvt. Ltd.44
Kojic Acid Dipalmitate
Oceanic Laboratories Pvt. Ltd.44
Kyron T – 134 / T-314
international drug & chemical co.165
Korkem 200 Ip/Usp (Fumed Silica)
Keshav Hichem Pvt. Ltd. 21
Iso Propyl Alcohol
Keshariya Corporation80
L(+) Tartaric Acid
Nisha Chemicals71
Maruti Petrochem55
L(+) Tartaric Acid (Bag)
Khushbu Dye Chem Pvt. Ltd.71
L-Arginine Base
Raivat Impex Pvt. Ltd.59
L-Arginine HCL
Raivat Impex Pvt. Ltd.59
L-Carnitine Base / HCL
Raivat Impex Pvt. Ltd.59
L-Carnitine L Tartrate
Raivat Impex Pvt. Ltd.59
L-Carnosine
Raivat Impex Pvt. Ltd.59
L-Citrulline
Raivat Impex Pvt. Ltd.59
L-Citrulline Dl Malate
Raivat Impex Pvt. Ltd.59
L-Cysteine Base
Raivat Impex Pvt. Ltd.59
L-Glutamine
Raivat Impex Pvt. Ltd.59
L-Glutathione Reduced
Raivat Impex Pvt. Ltd.59
L-Histidine Base / HCL
Raivat Impex Pvt. Ltd.59
L-Isoleucine
Raivat Impex Pvt. Ltd.59
L-Methionine
Raivat Impex Pvt. Ltd.59
L-Ornithine HCL
Raivat Impex Pvt. Ltd.59
L-Ornithine L Aspartate
Raivat Impex Pvt. Ltd.59
L-Phenylalanine
Raivat Impex Pvt. Ltd.59
L-Theanine
Raivat Impex Pvt. Ltd.59
L-Threonine
Raivat Impex Pvt. Ltd.59
L-Tryptophan
Raivat Impex Pvt. Ltd.59
L-Tyrosine
Raivat Impex Pvt. Ltd.59
L-Valine
Raivat Impex Pvt. Ltd.59
L Alanine Nisha Chemicals71 Chemkart163
L Amino Acids Chemkart163
L-Arabinose
Croma Chemical Corporation106
L Arginine Chemkart163
L Arginine a Ketoglutarate (AAKG) Chemkart163
L Arginine Asparate Chemkart163
L Arginine Granular Chemkart163
L Arginine HCL Chemkart163
L Arginine L Aspartate Panchsheel Organics Limited91
L- Arginine (L-series ) siddhivinayak pharma160
L Arginine Nitrate Chemkart163
L Arginine Pyroglutamate Chemkart163
L Asparagine Anhydrous Chemkart163
L Asparagine Monohydrate Chemkart163
L Aspartic Acid Chemkart163
Lauryl Bromide Pacific Biochem Private Limited82 Laboratory Instruments
AVI Scientific (India)35 Large Character Ink Jet Printers Advanced Industrial Micro Systems 25
L-Camphor-10-Sulfonic Acid 99%
Ram Enterprise 76
L Carnitine Base Chemkart163
L Carnitine Fumarate Chemkart163
L Carnitine HCL Chemkart163
L Carnitine Tartrate Chemkart163
L Castor Oil
H K Enterprise151
L Citrulline DL Malate 2:1 / 1:1 Chemkart163
L Cysteine Base Chemkart163
L Cysteine HCL Monohydrate Chemkart163
L Glutamic Acid
Nisha Chemicals71 Chemkart163
L Glutamic Acid HCL Chemkart163
L Glutamine Chemkart163
L Glutamine Alpha Ketoglutarate Chemkart163
L- Glutathion Reduced Jakson Pharma104 North India Pharma92
L Heavy Liquied Parafin Oil
H K Enterprise151
L Histidine Base Chemkart163
L Histidine HCL Chemkart163
L Homocysteine Chemkart163
L Isoleucine Chemkart163
L Leucine Chemkart163
L Light Liquied Parafin Oil
H K Enterprise151
L Lycine Nisha Chemicals71
L-Lysin Parshwa Pharma Chem Pvt. Ltd.40
L-Lysine (Hcl) SDA Product17
L Lysine Acetate Chemkart163
L Lysine Base Chemkart163
L Lysine HCL Chemkart163
L-Lysine Monohydrochloride Feed Grade
Rosetta Life Care Private Limited14
L-Lysine Sufate (Feed Grade)
Rosetta Life Care Private Limited14
L Malic Acid Chemkart163
L-Mandelic Acid Ram Enterprise 76
L Methionine Chemkart163
L Petrolium Jelly
H K Enterprise151
L Rubber Oil
H K Enterprise151
L-Thyroxin Sodium Panchsheel Organics Limited91
L - Lysine Mono Hcl 106.5%
Crystal Pharma76
L - Methyl Folate
B.Pankaj & Co.84 DM Pharma22
L Norvaline Chemkart163
L Ornithine alpha Keyoglutarate Chemkart163
L Ornithine HCL Chemkart163
L Ornithine L Aspartate Chemkart163
L - Ornithine L-Aspartate (Lola) North India Pharma92
L Phenylalanine Chemkart163
L Proline Chemkart163
L Pyroglutamic Acid Chemkart163
L Serine Chemkart163
L Serine Metyl Ester HCL Chemkart163
L Tartaric Acid Amita Chemicals102
L Theanine Chemkart163
L Threonine Chemkart163
L-Threonine 106.5% Feed Grade
Rosetta Life Care Private Limited14
L-Theronine F.G.106.5% SDA Product17
L-Tryptophan Crystal Pharma76 Chemkart163
L-Tryptophan 106.5% SDA Product17
L Tyrosine Chemkart163
L Valine Chemkart163
L Valine Methyl Ester HCL Chemkart163
Lab Stirrers, Centrifuges, Magnetic Stirrers B.J.
Chemicals71
202 THE MAZADA PHARMA GUIDE
Scientific Co.
Labetalol Hap Enterprise67 NDC Drug & Chemical Co.Pvt.Ltd. 154 Labetalol HCL Prudence Pharma Chem Ear Panel / 81 Labetalol Hydrochloride Aril Pharmaceuticals6/7 Large Character Hand Inkjet Advanced Industrial Micro Systems 25 Label roll printer Advanced Industrial Micro Systems 25 Laboratory Fume Hood Plastic Fabricators59 Lacosamide NDC Drug & Chemical Co.Pvt.Ltd. 154 Lactase Asiel Chemipharma35 Lactose 103
200 Mesh Keshav Hichem Pvt. Ltd. 21 Lactic Acid Siddhivinayak
Vinworld Healthcare
Neha Pharma
Sheetal Chem 101 Lactic
Khushbu
Nisha
Lactic Acid
Jakson
Lactic Acid
300
Jakson
Acid
Jakson Pharma104
Acid
Jakson
Acid FCC 88 Dev Pharmaceuticals 164
Acid Liquid
162
/
Pharma160
P. Ltd147
Pvt. Ltd.165
Acid (Bag)
Dye Chem Pvt. Ltd.71 Lactic Acid 80%, 88% & 90%
Bacillus 150 Billion Cfu/Gm
Pharma104
Bacillus
Billion Cfu/Gm
Pharma104 Lactic
Bacillus 6 Billion
Lactic
Bacillus 6000 Billion
Pharma104 Lactic
Lactic
PRODUCTS INDEX
Nisha Chemicals71
Lactic Acid Powder
Nisha Chemicals71
Lacto Bacillus Spronge
Crystal Pharma76
Light Liquid Paraffin - IP / BP / USP / EP
Arjun Beeswax Industries169
Liquid Paraffin - IP / BP / USP / EP
Arjun Beeswax Industries169
Lactose
Regent Chemicals 41
Western Pharma105
Parshwa Pharma Chem Pvt. Ltd.40
Krishna Solvechem Ltd.21
Modern Dairies39
Lactulose Concentrate Usp
Jakson Pharma104
Lamotrigine
NDC Drug & Chemical Co.Pvt.Ltd. 154
Lamotrigine Ip
Aril Pharmaceuticals6/7
Lanoline Anhydrous
Kems Raw Pharma93
Lansoprazole Ip/Usp
Sheetal Chem 101
Lansoprazole IP/ Usp Pellets
Sheetal Chem101
Lansoprazole Sodium Sterile
Nova Chemiie 24
Lansoprazole Sodium Sterile (Lyophilized)
Nova Chemiie 24
Lactobacillus rahmnosus GG 200B Cfu/g
90 Elementos Pvt. Ltd. 104
Lanthanum Chloride Indian Platinum Pvt. Ltd.158
Lanthanum Nitrate Indian Platinum Pvt. Ltd.158
Lapatinib
Jay Chem Marketing128
Lapatinib Ditosylate (onco)
Vinworld Healthcare P. Ltd147
Lasamide Krishna Solvechem Ltd.21
Pellets
Pharma105
Corporation89
Leveling Agents Krishna Antioxidants Pvt. Ltd.87
Vinworld Healthcare P. Ltd147 Aril Pharmaceuticals6/7 DM Pharma22
Unimax Group 20
Levetiracetam SR Granules 75%, 80%
YSK Laboratories Pvt. Ltd.56
Levetiracetam USP
Vinworld Healthcare P. Ltd147
Levetiracetam Ip
Aril Pharmaceuticals6/7
Levocetrizine Panchsheel Organics Limited91 DM Pharma22
Levocetrazine Di Hcl Ip
Aril Pharmaceuticals6/7
Levocetrizine Di HCL IP/BP
Hritik Chemicals Pvt. Ltd.99
Levocetrizine Di Hcl IP/USP Kahan Pharmaceuticals
Hcl Nova Chemiie
Parshwa Pharma Chem Pvt. Ltd.40
Levocetirizine Hydrochloride
Hydrochloride Ip
Chem
Levoctrizine HCl IP Malay Enterprise167
Levodopa international drug & chemical co.165
Levo Bupivacaine HCl Shamrock Pharmachem38 Levosalbutamol Sulphate
Pharma Pvt. Ltd.25
Raj Chem84
Healthcare P.
Pharmaceuticals
Levofloxacin Hemihydrate IP/BP/USP Espee Pharma Chem Pvt. Ltd.94
Pharmaceuticals6/7
Enterprise167 Rati Pushp Intermediates Pvt. Ltd.37
Levonorgestrel
Panchsheel Organics Limited91
Hritik Chemicals Pvt. Ltd.99
Levonorgestrel Ip/Bp/Usp Balaji Corporation89
Levo salbutamol Sulphate
Pharma22
Drug & Chemical Co.Pvt.Ltd.
Levo Salbutamol Sulphate Ip
Hap Enterprise67
Shriya Pharma & Surgical42
Ip
Pharmaceuticals
Aditi Essentials51
CSV Pharmaceuticals India Pvt. Ltd.169
Lemongrass Oil
CSV Pharmaceuticals India Pvt. Ltd.169
L-glutathione
CSV Pharmaceuticals India Pvt. Ltd.169
Laxatives / Pregnancy
Chemical Matrix166
Lead Acetate
Indian Platinum Pvt. Ltd.158
Lead Bromide
Qualikems Lifesciences Pvt. Ltd.139
Lead Carbonate
Qualikems Lifesciences Pvt. Ltd.139
Lead Chloride
Qualikems Lifesciences Pvt. Ltd.139
Leather Enzyme Enzyme Bioscience57
Lead Iodide
SVG Pharma Lifesciences Pvt. Ltd.145
Qualikems Lifesciences Pvt. Ltd.139
Lead Nitrate
Indian Platinum Pvt. Ltd.158
Qualikems Lifesciences Pvt. Ltd.139
Lead Oxide Yellow
Qualikems Lifesciences Pvt. Ltd.139
Lead Peroxide
Qualikems Lifesciences Pvt. Ltd.139
Lead Sulphate
Qualikems Lifesciences Pvt. Ltd.139
Lebetalol Hcl Ip
Balaji Corporation89
Leetiracetam Inventys58
Leflunomide
Panchsheel Organics Limited91
Leflunomide Ip/Bp/Usp
Pramukh Pharmachem Pvt. Ltd.80
Leishman Stain
Oxford Laboratory Chemicals141
Lemon Oil
Kamakhya ImpexFlap
Lemongrass Oil
Kamakhya ImpexFlap
Levender Oil
Kamakhya ImpexFlap
Lemon Peel Extract
Global Merchants25
Lemon Wax
Flora Dye Chem 126
Lemongrass Oil
Aditi Essentials51
Lenalidomide (onco)
Vinworld Healthcare P. Ltd147
Letrazole
Balaji Corporation89
international drug & chemical co.165
Dazzle Corporation88
Letrozole USP
Vinworld Healthcare P. Ltd147
Levocetirizine Di Hcl.
Dazzle Corporation88
Levamisole Hcl Bp/Usp
Crystal Pharma76
Levamlodipine
Prudence Pharma Chem Ear Panel / 81
International Drug & Chemical Co.165
Healthcare P. Ltd147
Chemiie
Levosulpiride Ip Aril Pharmaceuticals6/7
Levosulpride
Hap Enterprise67
Levothyroxine Sodium Balaji Corporation89
L-Glutamic Acid Bp
Suprim Chemicals76
Lidocain Base Inventys58
Shamrock Pharmachem38
Lidocain Base Usp
Hiten Pharma Chem152
Lidocaine HCL IP/BP
Hritik Chemicals Pvt. Ltd.99
Lidocaine Hydrochloride Monohydrate IP/BP/USP/EP
Chemino Pharma Ltd94
Lidocaine IP/BP/USP/EP
Chemino Pharma Ltd94
Light Kaoline
Kems Raw Pharma93
LightKaolin
Reenold Enterprises137
Light Kaolin Natural B.P.
Hritik Chemicals Pvt. Ltd.99
Light Liquid Parafin
Malay Enterprise167
Maruti Petrochem55
Light Magnesium Oxide
Arco Pharma126/164
Lignocaine Base Usp Jakson Pharma104
Lignocain Hcl Ip/Bp Hiten Pharma Chem152
Lignocaine Hcl Ip / Bp / Usp
Kahan Pharmaceuticals 08
Linagliptin
Hap Enterprise67
NDC Drug & Chemical Co.Pvt.Ltd. 154
Bakul Aromatics and Chemicals Pvt. Ltd.103
Calyx Chemical & Pharmaceuticals Ltd.23
Linagliptin- INH
Progress Life Sciences Pvt. Ltd.29
Linagliptine Ip/Bp/Usp
International Drug & Chemical Co.165
Lincomycin Hcl
Crystal Pharma76
Linelozid
DM Pharma22
Linezolid
Aril Pharmaceuticals6/7
NDC Drug & Chemical Co.Pvt.Ltd. 154
Dazzle Corporation88
Linezolid IP/BP
Hritik Chemicals Pvt. Ltd.99
Linseed Oil
Malay Enterprise167
Siddhivinayak Pharma160
Krishna Solvechem Ltd.21
Liothyronine Sodium (T3 )
Balaji Corporation89
Lipase SDA Product17
Asiel Chemipharma35
Liquid Bromine 99.5% Min.
Mody Chemi Pharma Pvt. Ltd. 47
Liquid Carbon Dioxide Dev International158
Liquid Chlorine Dev International158
Liquid Glucose
Siddhivinayak Pharma160
Shree Chemicals117
THE MAZADA PHARMA GUIDE 203
Nisha Chemicals71 Siddharth International101 H K Enterprise151 Maruti Petrochem55 Lauryl Amine Oxide Kanchan Rasayan 34 Lauryl Myristyl Alcohol Kanchan Rasayan 34 Lauryl
Lasoprazole
Western
Latanoprost Balaji
Aara Pharma150 Laureth-7 Kanchan Rasayan 34 Lauric Acid Kanchan Rasayan 34
Myristyl Alcohol – C 1214 H K Enterprise151 Lavender Oil
24
Levetiracetam Nova Chemiie
08 Levocetirizine
24
NDC
154 Levocetrizine
101
Drug & Chemical Co.Pvt.Ltd.
Sheetal
Shree
Crystal
Nova
24 Vinworld
Ltd147
08
Orex
Levofloxacin
Pharma76
Chemiie
Kahan
Aril
Malay
DM
154
NDC
Kahan
08 Levosulpiride
Vinworld
Nova
24
NDC
154
Levosulbutamol
DM Pharma22
Drug & Chemical Co.Pvt.Ltd.
Dev International158 Maruti Petrochem55 Liquid Glucose So 2 Free Shree Raj Chem84 Liquid Glucose I.P / Usp Keshav Hichem Pvt. Ltd. 21 Lipid Lowering Agent Chemical Matrix166 Liquid Paraffin Ketan Chemical Corporation119 Liquid Paraffin (Heavy / Light) Dev International158 Liquorice Extract Global Merchants25 Lisinopril Parshwa Pharma Chem Pvt. Ltd.40 Calyx Chemical & Pharmaceuticals Ltd.23 Lisinopril BP/EP/USP/IP Vinworld Healthcare P. Ltd147 Lisinopril Usp Shriya Pharma & Surgical42 Lithium Bromide Krishna Solvechem Ltd.21 Lithium Bromide Anhydrous 99.5% Min. Mody Chemi Pharma Pvt. Ltd. 47 Lithium Bromide Solutions 55% Mody Chemi Pharma Pvt. Ltd. 47 Lithium Carbonate DM Pharma22 Kronox Lab Sciences Limited218 Lithium Carbonate/Hydroxide Amita Chemicals102 Lithium Chloride Anhydrous Mody Chemi Pharma Pvt. Ltd. 47 Lithinum Chloride Solution 50% Mody Chemi Pharma Pvt. Ltd. 47 Lithium Hydroxide Monohydrate Jay Chem Marketing128 Mody Chemi Pharma Pvt. Ltd. 47 Lithium Iodide Hydrate SVG Pharma Lifesciences Pvt. Ltd.145 Lithium Molybdate & Chromate ( 20% Solution) Mody Chemi Pharma Pvt. Ltd. 47 Liver / Yeast Extract Powder / Honey Siddhivinayak Pharma 160 Liver Extract Paste Eklavya Biotech Pvt. Ltd.103 Liver Extract Powder Eklavya Biotech Pvt. Ltd.103 Liver Crude 1:15 (Inj.) /1:30 Crystal Pharma76 Liver Extract Powder / Paste Crystal Pharma76 Liver Extract Paste /yeast Extract Paste Siddhivinayak Pharma160 Liquor Ammonia Riddhi Siddhi Dye Chem 137 Liquid Bromine Pacific Biochem Private Limited82 L-Lysine Hydrochloride Usp Suprim Chemicals76 Locust Bean Gum Locust Bean Gum Low Methoxyl Amidated Pectin (Citrus) Low Methoxyl Pectin - Apple Labh Ingredients152 Advance in Organics LLP128 Lomefloxacine Hcl Panchsheel Organics Limited91 Loperamide Vinworld Healthcare P. Ltd147 NDC Drug & Chemical Co.Pvt.Ltd. 154 Loperamide Hcl Usp Balaji Corporation89 Loratidine Parshwa Pharma Chem Pvt. Ltd.40 Hap Enterprise67 DM Pharma22 NDC Drug & Chemical Co.Pvt.Ltd. 154 Loratidine IP/BP/USP Aril Pharmaceuticals6/7 Lorazepam Bp/Ep Aril Pharmaceuticals6/7 Lorazepam Melitracin Luconic Chemicals103 Lornoxicam – INH Progress Life Sciences Pvt. Ltd.29 Lornoxicam IP/BP/USP international drug & chemical co.165 Lornoxicam Nova Chemiie 24 Zuhhad International 86 DM Pharma22 NDC Drug & Chemical Co.Pvt.Ltd. 154 Lornoxicam In-H Aril Pharmaceuticals6/7 Losartan Potassium IP/BP Hritik Chemicals Pvt. Ltd.99 Losartan Potassium Dazzle Corporation88 Losartan Pottassium IP/BP/USP Aril Pharmaceuticals6/7 Losartan Potassium Ip/Usp Shriya Pharma & Surgical42 Losartan Potassium Sheetal Chem 101 NDC Drug & Chemical Co.Pvt.Ltd. 154 Losartan Potassium Usp Kahan Pharmaceuticals 08 Loteprednol Balaji Corporation89 Louryl Alcohol 2.5/3/6/7/9/Mol Meru Chem Pvt. Ltd.105 Loxoprofen Sodium Unimax Group 20 L-Threonine Suprim Chemicals76
PRODUCTS INDEX
L-Lysin Mono
Espee Pharma Chem Pvt. Ltd.94
Lubricity Improvers For Diesel
Krishna Antioxidants Pvt. Ltd.87
Luliconazole
Nova Chemiie 24
Panchsheel Organics Limited91
Balaji Corporation89
Vinworld Healthcare P. Ltd147
Aara Pharma150
DM Pharma22
NDC Drug & Chemical Co.Pvt.Ltd. 154
Luliconazole In-H
Kahan Pharmaceuticals 08
Luliconazole Ip
Shriya Pharma & Surgical42
Luliconazole IP/BP
Hritik Chemicals Pvt. Ltd.99
Lumefantrine
Balaji Corporation89
Western Pharma105
Panchsheel Organics Limited91
Nova Chemiie 24
Vinworld Healthcare P. Ltd147
Lumefantrine IH / USP
Malay Enterprise167
Lumefantrine USP/PHI
Topnotch Chemicals Pvt. Ltd.23
Lutein Powder 10%
North India Pharma92
Lycopene Powd & Liq
North India Pharma92
Lycopine 6, 10%
Crystal Pharma76
Lynestrenol
Hritik Chemicals Pvt. Ltd.99
Lysine Mono Acetate
Panchsheel Organics Limited91
M A A H K Enterprise151
M-bromo Anisole
Pacific Biochem Private Limited82
M-bromo Nitro Benzene Pacific Biochem Private Limited82
Magnesium Stearate IP/BP/USP
J R Drugchem Pvt. Ltd.Back Inside Cover
Magnesium L-Threonate
Labh Ingredients152
Modified Starch
Labh Ingredients152
Maduramycin Ammonium 1% Feed Grade
Rosetta Life Care Private Limited14
Magaldrate
Kems Raw Pharma93
Magnesium Amino Acid Chelate
Eklavya Biotech Pvt. Ltd.103
Malt Extract Paste
Eklavya Biotech Pvt. Ltd.103
Magnesium Phosphate Dibasic
Raivat Impex Pvt. Ltd.59
Malt Extract Powder
Eklavya Biotech Pvt. Ltd.103
Manganese Amino Acid Chelate
Eklavya Biotech Pvt. Ltd.103
Manganese Acetate Advance in Organics LLP128
Mannon Oligosachharide
Eklavya Biotech Pvt. Ltd.103
Molybdanum Amino Acid Chelate
Eklavya Biotech Pvt. Ltd.103
Magaldrate Ip/bp/usp/ep Elite Chemicals89
Maelic Anhydride
Mivon Chemicals 28
Relic Chemicals82
Mdk 200 (Colloidal Silicon Dioxide)
Keshav Hichem Pvt. Ltd. 21
Malto Dexstrine
Keshariya Corporation 80
Meglumine
Croma Chemical Corporation106
Meglumine Ip/Bp/Usp
Pramukh Pharmachem Pvt. Ltd.80
Methanol
Keshariya Corporation 80
Apra Innovative Pvt Ltd19
Metals & Alloys
Bombay Test House Private Limited93
Meat Extract Paste
Eklavya Biotech Pvt. Ltd.103
Meat Extract Powder
Eklavya Biotech Pvt. Ltd.103
Meat Peptone
Eklavya Biotech Pvt. Ltd.103
Mentha Oil
Eklavya Biotech Pvt. Ltd.103
Menthol Crystal
Eklavya Biotech Pvt. Ltd.103
Methyl Ethyl Ketone
Keshariya Corporation80
Methyl Salicylate
Vikram Aromatics144
M.C.C.P
Siddhivinayak Pharma160 Global Merchants25
MCCP IP/BP/USP Ph 101,102,112,200 international drug & chemical co.165
M.D.C
Shree Raj Chem84
Siddhivinayak Pharma160
Khushbu Dye Chem Pvt. Ltd.71
H K Enterprise151
Macrolides
Calyx Chemical & Pharmaceuticals Ltd.23
Maduramycin Ammonium
Crystal Pharma76
Magaldrate IP / BP / USP
Gangotri Inorganic (P) Ltd.18
Magnesium Acetate
Kronox Lab Sciences Limited218
Advance in Organics LLP128
Magnesium Aluminium Silicate
Elite Chemicals89
Kems Raw Pharma93
Magnesium Carbonate
Kronox Lab Sciences Limited218
Magnesium Carbonate (IP/BP/USP)
Gangotri Inorganic (P) Ltd.18
Magnesium Carbonate Light/heavy Ip/bp/usp/ep/technical
Elite Chemicals89
Magnesium Carbonate Light
Gautam Pharma Chem84
Magnesium Citrate
Navnidh Pharma lab84
Magnesium Citrate
Advance in Organics LLP128
Magnesium Chloride Anhydrous Pure
Kronox Lab Sciences Limited218
Magnesium Chloride Hexahydrate
Qualikems Lifesciences Pvt. Ltd.139
Kronox Lab Sciences Limited218
Magnesium Chloride Hexahydrate Ultra Pure (Low Calcium)
Kronox Lab Sciences Limited218
Magnesium Chloride Ip/bp/usp
Elite Chemicals89
Magnesium Chloride Special Grade (Bromide Free)
Kronox Lab Sciences Limited218
Magnesium Citrate
Kronox Lab Sciences Limited218
Advance in Organics LLP128
Magnesium Gluconate
Kronox Lab Sciences Limited218
Magnesium Gluconate BP/USP
Vinworld Healthcare P. Ltd147
Magnesium Hydroxide
Kems Raw Pharma93
Magnesium Hydroxide Ip/bp/usp/ep/technical
Elite Chemicals89
Magnesium Hydroxide Carbonate
Elite Chemicals89
Magnesium Hydroxide (IP/BP/USP)
Gangotri Inorganic (P) Ltd.18
Magnesium Hydroxide IP/ BP
Hritik Chemicals Pvt. Ltd.99
Magnessium Hydroxide Paste Western Pharma105
Magnesium Hypophosphite
Kronox Lab Sciences Limited218
Magnesium Lactate
Nisha Chemicals71
Kronox Lab Sciences Limited218
Magnesium L-Threonate
Labh Ingredients152
Modified Starch
Labh Ingredients152
Magnesium Oxide
Ashapura Intermediates 119
Meru Chem Pvt. Ltd.105
Dev International158
Kronox Lab Sciences Limited218
Magnesium Oxide IP/ BP
Hritik Chemicals Pvt. Ltd.99
Magnesium Oxide IP / BP / USP
Gangotri Inorganic (P) Ltd.18
Magnesium Oxide Light/heavy Ip/bp/usp/ep/technical
Elite Chemicals89
Magnesium Oxide Light / Heavy
DM Pharma22
Magnesium Phosphate
Kronox Lab Sciences Limited218
Magnesium Phosphate
Pari Chemicals136
Magnesium Silicate IP / BP / USP
Gangotri Inorganic (P) Ltd.18
Magnesium Stearate
Siddhivinayak Pharma160
Regent Chemicals 41
Kronox Lab Sciences Limited218
Magnesium Stearate IP/BP
Hritik Chemicals Pvt. Ltd.99
Magnesium Stearate Ip/Bp/Usp
Hiten Pharma Chem152
Magnesium Stearate Ip/bp/usp/ep
Elite Chemicals89
Magnesium Sulfate 7h2o
Kronox Lab Sciences Limited218
Magnesium Sulfate Dried
Kronox Lab Sciences Limited218
Magnesium Sulphate
Navnidh Pharma Lab84
SDA Product17
Kems Raw Pharma93
HK Group76
Magnesium Sulphate Hexahydrate IP [Injectable]
Arco Pharma126/164
Magnesium Sulphate Anhydrous
Qualikems Lifesciences Pvt. Ltd.139
Kronox Lab Sciences Limited218
Magnesium Sulphate Anhydrous Usp & Extra Pure
Kronox Lab Sciences Limited218
Magnesium Sulphate Heptahydrate
Qualikems Lifesciences Pvt. Ltd.139
Magnesium Sulphate Heptahydrate Ultra Pure (Low Iron)
Kronox Lab Sciences Limited218
Manganese Sulphate - ATUL & Local Make
Ashapura Intermediates119
Magnesium Sulphate - All Grades
Ashapura Intermediates119
Magnesium Trisilicate
Kems Raw Pharma93
Magnesium Trisilicate (IP/BP/USP)
Gangotri Inorganic (P) Ltd.18
Mango Butter - IHS
Arjun Beeswax Industries169
Mango Butter: Ultra Refined
CSV Pharmaceuticals India Pvt. Ltd.169
Menthol Crystals IP/BP/USP
CSV Pharmaceuticals India Pvt. Ltd.169
Milk Thistle (Silymarin)
CSV Pharmaceuticals India Pvt. Ltd.169
Moringa Leaf & Seed Extract
CSV Pharmaceuticals India Pvt. Ltd.169
Magnesium Chloride - Technical & LR Grade
Ashapura Intermediates119
Magnesium Trisilicate Ip/bp/usp/ep
Elite Chemicals8
Marviroc
Calyx Chemical & Pharmaceuticals Ltd.23
Maize Bran Powder
SDA Product17
Maize Starch Powder IP / BP
Arco Pharma126/164
Maize Starch
Siddhivinayak Pharma160 Western Pharma105
Reenold Enterprises137
Maize Starch Best Quality (Food Grade)
Shree Chemicals117
Maize Starch Ip/Bp Shree Chemicals117
Maize Starch Powder
Parshwa Pharma Chem Pvt. Ltd.40
Shree Chemicals117
Maize Starch Powder IP Arco Pharma126/164
Malachite Green Indian Platinum Pvt. Ltd.158 Maleic Anhydride
Hichem Pvt. Ltd. 21
Chemical Corporation 78
Chemicals82 Maleic Acid HK Group76 Malt Diastase Kems Raw Pharma93
Malt Extract Shree Raj Chem84
Maltodextrin Powder Shree Chemicals117
Manganese Chloride
Kronox Lab Sciences Limited218
Manganese Chloride Anhydrous
Kronox Lab Sciences Limited218
Manganese Chloride Tetrahydrate
Qualikems Lifesciences Pvt. Ltd.139
Magnesium Chloride Flakes (Jcw Make)
Riddhi
SDA Product17
Meru Chem Pvt. Ltd.105 Chemstar Global Products LLP76
Manganese Sulphate – All Grades Ashapura Intermediates 119 Mangenese Sulphate Monohydrate Kronox Lab Sciences Limited218 Mannitol Siddhivinayak Pharma160 Chemkart163
Malay Enterprise167
Mannitol Pellets
Hritik Chemicals Pvt. Ltd.99
Mannitol Powder IP [Pyrogen Free] Arco Pharma126/164
Mannitol Spray Dried (SD1& SD2)
Hritik Chemicals Pvt. Ltd.99
Marbofloxacin Ip/Bp/Ep Diligent Life Care38
Marbofloxacin
NGL Fine - Chem Limited105
Matlcoat 3250- Metal Corrosion In Inhibitor
Shreedhar Enterprise155
Matlcoat 3251 – Descalant Cum Corrosion Inhibitor
Shreedhar Enterprise155
MCCP
Parshwa Pharma Chem Pvt. Ltd.40
Hritik Chemicals Pvt. Ltd.99
MCT Oil Chemizo Enterprise166 Mcgregory Oil Aditi Essentials51 MDC Kanchan Rasayan 34 Maruti Petrochem55 MDI
Impex Pvt. Ltd.59 Mebendazole Ip/Usp
204 THE MAZADA PHARMA GUIDE
Keshav
Paresh
Relic
Siddhi Dye Chem 137 Magnesium Chloride Crystal Riddhi Siddhi Dye Chem 137 Manganese Gluconate Vinworld Healthcare P. Ltd147 Manganese Gluconte Anhydrous Kronox Lab Sciences Limited218 Manganese Sulphate Crystal Pharma76
Maruti
Dazzle
Mannitol Raivat
Mannitol
Hritik
Mannitol
Petrochem55
Corporation88
Impex Pvt. Ltd.59
Fine Grade (F1, F2, & F3)
Chemicals Pvt. Ltd.99
Ip / BP / USP / Ph.eur
Paresh Chemical Corporation 78 H K Enterprise151 Meat Bone Meal SDA Product17 M.E.G. Gandhi Chemicals 144 Melatonin Raivat Impex Pvt. Ltd.59 Methyl
Raivat
Shree
Crystal
Mebeverine
Panchsheel Organics
Aril Pharmaceuticals6/7 NDC Drug & Chemical Co.Pvt.Ltd. 154 Hap Enterprises 59 Mebeverine Hcl
Kahan Pharmaceuticals 08 Mebeverine Hcl -Sr 54%, 60% Pellets Panchsheel Organics Limited91 Meclizine Hap Enterprise67 NDC Drug & Chemical Co.Pvt.Ltd. 154 Meclizine Hcl Panchsheel Organics Limited91 Medium Chain Triglyceride (MCT OIL ) Siddhivinayak Pharma160 Medium Chain Triglycerides (Mct Oil/GTCC/CCTG) Heni Drugs Pvt. Ltd.49 Medium Chain Triglycerides USP (MCTOil) Krishna Solvechem Ltd.21 Medroxy Progesterone Acetate Balaji Corporation89 Mefenamic Acid Vinworld Healthcare P. Ltd147 Neha Pharma Pvt. Ltd.165 Mefenamic Acid IP/BP/USP Maharshee Laboratories Pvt. Ltd. 133 Mefenamic Acid IP/BP Kahan Pharmaceuticals 08 Shriya Pharma & Surgical42 Mefenamic Acid IP/BP/USP Nova Chemiie 24 Mefenamic Acid IP/BP/USP/EP 600MT/Annum Nira Life Sciences Pvt. Ltd.25 Mefloquine Jay Chem Marketing128
Sulfonyl Methane
Raj Chem84
Pharma76
Hcl
Limited91
Ip
PRODUCTS INDEX
Meta Toluene Diamine (MTD)
Thana Acid & Chemical Co145
MEG
Khushbu Dye Chem Pvt. Ltd.71
Paresh Chemical Corporation 78
H K Enterprise151
Maruti Petrochem55
Meglumine (N-Methyl-D-Glucamine)
Maruti Industries24
Megnesium Chloride – AR/ LR / Technical
Ashapura Intermediates 119
Mefenamic Acid Usp/Ip/Bp Rolence Pharma & Chemicals127
MEK
Khushbu Dye Chem Pvt. Ltd.71
H K Enterprise151
Mesalamine Ip/Bp/Usp
Pramukh Pharmachem Pvt. Ltd.80
Melamine
Khushbu Dye Chem Pvt. Ltd.71
Ashapura Intermediates 119
Reenold Enterprises137
Thana Acid & Chemical Co145
Melatonin
Panchsheel Organics Limited91 Chemkart163
NDC Drug & Chemical Co.Pvt.Ltd. 154
Melatonin 99% Powder
North India Pharma92
Melitracin Hcl In-H Aril Pharmaceuticals6/7
Melittracen Hcl
Hap Enterprise67
NDC Drug & Chemical Co.Pvt.Ltd. 154
Meloxicam
NDC Drug & Chemical Co.Pvt.Ltd. 154
Reenold Enterprises137
Meloxicam - BP/USP
Progress Life Sciences Pvt. Ltd.29
Meloxicam Ip / Bp
Kahan Pharmaceuticals 08
Meloxicam IP/BP/USP/EP
Chemino Pharma Ltd94
Membrane Filter Papers & Syringe Filters
B.J. Scientific Co. 162
Menthol
Shree Raj Chem84
Maruti Petrochem55
Menthol / Camphor / Thymol Dev International158
Mephenesin
Nova Chemiie 24
Meprobamate
Neha Pharma Pvt. Ltd.165
Merbromine Powder
Kems Raw Pharma93
Mercuric Iodide Red Lr/Ar
Oxford Laboratory Chemicals141
Mercuric Acetate ACS
Heni Drugs Pvt. Ltd.49
Mercuric Bromide ACS
Heni Drugs Pvt. Ltd.49
Mercuric Chloride ACS
Heni Drugs Pvt. Ltd.49
Mercuric Iodide Red ACS
Heni Drugs Pvt. Ltd.49
Mercuric Nitrate Monohydrate ACS
Heni Drugs Pvt. Ltd.49
Mercuric Oxide Red ACS
Heni Drugs Pvt. Ltd.49
Mercuric Oxide Yellow ACS
Heni Drugs Pvt. Ltd.49
Mercuric Sulfate ACS
Heni Drugs Pvt. Ltd.49
Mercuric Thiocynate
Heni Drugs Pvt. Ltd.49
Mercurous Chloride ACS
Heni Drugs Pvt. Ltd.49
Mercurous Iodide
Heni Drugs Pvt. Ltd.49
Mercurous Nitrate Dihydrate ACS
Heni Drugs Pvt. Ltd.49
Mercurous Iodide
Heni Drugs Pvt. Ltd.49
Mercurous Nitrate Monohydrate-ACS
Heni Drugs Pvt. Ltd.49
Mercuric Sulfate-ACS
Heni Drugs Pvt. Ltd.49
Mercuric Oxide Yellow-ACS
Heni Drugs Pvt. Ltd.49
Mercuric Oxide Red-ACS
Heni Drugs Pvt. Ltd.49
Mercuric Nitrate Monohydrate-ACS
Heni Drugs Pvt. Ltd.49
Mercuric Chloride Lr/Ar
Oxford Laboratory Chemicals141
Mercuric Chloride-ACS
Heni Drugs Pvt. Ltd.49
Mercuric Sulphate Lr/Ar
Oxford Laboratory Chemicals141
Mercury Ammoniated Lr/Ar
Oxford Laboratory Chemicals141
Meropenam
Balaji Corporation89
Meropenem Sterile (Blended With Sodium Carbonate Sterile)
Nova Chemiie 24
Mesalamine
Nova Chemiie 24
Aril Pharmaceuticals6/7
NDC Drug & Chemical Co.Pvt.Ltd. 154
Mesalamine ( Mesalazine )
Aril Pharmaceuticals6/7
Mesalamine/Mesalazine-IP/BP/USP/EP
Oceanic Laboratories Pvt. Ltd.44
Mestanolone
Panchsheel Organics Limited91
Meta Amino Phenol (Map)
Krishna Solvechem Ltd.21
Methyl Benzoate (Perfumery Grade)
Gbl Chemical Limited73
Meta Bromo Anisole
Krishna Solvechem Ltd.21
Meta Bromo Anisole / Meta Chloro Anisole
Kip Chemicals Pvt. Ltd.81
Meta Chloro Propiophenone
Chemino Pharma Ltd94
Meta Chloro
Zuhhad International 86
Meta Cresol Pure 99%
Ketan Chemical Corporation119
Meta Hydroxy Acetophenone
Krishna Solvechem Ltd.21
Metadoxine
DM Pharma22
Hap Enterprise67
NDC Drug & Chemical Co.Pvt.Ltd. 154
Meta Para Cresol (Mixed Cresol)
Ketan Chemical Corporation119
Meta Phosphoric Acid
Qualikems Lifesciences Pvt. Ltd.139
Meta Phosphoric Acid Sticks
Oxford Laboratory Chemicals141
Meta Toluic Acid
Chemaroma Drug House 91
Asiel Chemipharma35
Meta Xylene
Meru Chem Pvt. Ltd.105
Metal Powders / Turnings
Powder Pack Chem129
Metal Salts
Powder Pack Chem129
Metal Salts Lr/Ar Grades
Oxford Laboratory Chemicals141
Metamizole Sodium
Unitrade Agencies70
Metaprolol Succinate
Siddhivinayak pharma 160
Metaxalone Inh
Aril Pharmaceuticals6/7
Metformin HCL Nova Chemiie 24
Parshwa Pharma Chem Pvt. Ltd.40
Vinworld Healthcare P. Ltd147
NDC Drug & Chemical Co.Pvt.Ltd. 154
Hap Enterprises59
Dazzle Corporation88
Metoprolol Succinate / Tartrate
Dazzle Corporation88
Metformin HCI IR Granules 86.6%, 95%
YSK Laboratories Pvt. Ltd.56
Metformin HCI SR Granules 75%, 80%
YSK Laboratories Pvt. Ltd.56
Metformin
Kahan Pharmaceuticals 08
Metformin Hcl #103/80/60 Ip /Bp
Aril Pharmaceuticals6/7
Metformin Hcl Ip / Bp
Shriya Pharma & Surgical42
Metha Acrylic Acid (MAA)
Nisha Chemicals71
Paresh Chemical Corporation 78
Methandienone
Balaji Corporation89
Methane Sulfonic Acid
Nisha Chemicals71
Qualikems Lifesciences Pvt. Ltd.139
Methane Sulfonic Anhydride
Stratechem (I) Pvt. Ltd.
Methane Sulphonyl Chloride
Maruti Petrochem55
Qualikems Lifesciences Pvt. Ltd.139
Methane Sulphonyl Chloride (MSC)
Nisha Chemicals71
Methanol
Khushbu Dye Chem Pvt. Ltd.71
Krishna Solvechem Ltd.21
Gandhi Chemicals 144
H K Enterprise151
Apra Enterprises19
Methotrexate
Vinworld Healthcare P. Ltd147
Methotrexate Usp
Balaji Corporation89
Methoxsalen Usp
Aril Pharmaceuticals6/7
Methoxy Acetyl Chloride
Krishna Solvechem Ltd.21
Methoxy Propanol
Paresh Chemical Corporation 78
Maruti Petrochem55
Methoxy Propyl Acetate
Paresh Chemical Corporation 78
Maruti Petrochem55
Methyal Predanisolone
Balaji Corporation89
Methyl Prednisolone
Unimax Group 20
Methyal Predanison
Balaji Corporation89
Methyl-2-Iodo Benzoate
Krishna Solvechem Ltd.21
Methyl Aceto Acetate
Nisha Chemicals71
Meru Chem Pvt. Ltd.105
Methyl Benzene Sulfonate Chloride
Stratechem (I) Pvt. Ltd. 88
Methyl Carbitol
Paresh Chemical Corporation 78
Methyl Cellosolve
Paresh Chemical Corporation 78
Methyl Chloro Formate
Krishna Solvechem Ltd.21
Methyl Cobalamine
Vinworld Healthcare P. Ltd147
Parshwa Pharma Chem Pvt. Ltd.40
DM Pharma22
Neha Pharma Pvt. Ltd.165
NDC Drug & Chemical Co.Pvt.Ltd. 154
Chemino Pharma Ltd94
Hap Enterprises9
MethylCobalamine Ip/Jp
Aril Pharmaceuticals6/7
Siddhivinayak Pharma160
Nova Chemiie 24
Methylcobalamin / Hydroxycobalamin
Dev International158
Methylcobalamine IP
Malay Enterprise167
Methyl Coblamine
Balaji Corporation89
Methyl Cobalamine I.P
Shriya Pharma & Surgical42
Methyl Cobalamin IP/BP
Hritik Chemicals Pvt. Ltd.99
Methyl Coblamine Ip / Jp
Kahan Pharmaceuticals 08
Pravinchandra & Co.13
Methyl Cyclo Hexane
Krishna Solvechem Ltd.21
Kip Chemicals Pvt. Ltd.81
Ketan Chemical Corporation119
Methyl Ethyl Ketone (MEK)
Krishna Solvechem Ltd.21
Apra Enterprises19
Apra Innovative Pvt Ltd19
Methyl Folate Calcium
Siddhivinayak Pharma160
Parshwa Pharma Chem Pvt. Ltd.40
Methyl Formate
Apra Enterprises19
Apra Innovative Pvt Ltd19
Thana Acid & Chemical Co145
Methyl Iso Butyl Ketone (MIBK)
Mivon Chemicals 28
Nisha Chemicals71
Krishna Solvechem Ltd.21
Apra Enterprises19
Apra Innovative Pvt Ltd19
Methyl Metha Acrylate (MMA)
Nisha Chemicals71
Paresh Chemical Corporation 78
Meru Chem Pvt. Ltd.105
Apra Enterprises19
Apra Innovative Pvt Ltd19
Methyl Orange
Oxford Laboratory Chemicals141
Methyl Salicylate
Pharma Pvt. Ltd.148 Methyl Para Toluene Sulfonate Stratechem (I) Pvt. Ltd. 88 Methyl Paraben Dev International158
Petrochem55 Methyl Paraben Ip Suprim Chemicals76 Methylprednisolone
THE MAZADA PHARMA GUIDE 205
88
Panchsheel Organics Limited91 NDC Drug & Chemical Co.Pvt.Ltd. 154 Hap Enterprises59 Methylprednisolone Hemisuccinate Rumit Group Of Companies78 Methyl Prednisolone Ip Pravinchandra & Co.13 Hiten Pharma Chem152 Methyl Prednisolone Acetate Nova Chemiie 24 Pravinchandra & Co.13 Methyl Prednisolone Acetate Ip Hiten Pharma Chem152 Methyl Prednisolone Sod. Succinate Vinworld Healthcare P. Ltd147 Methyl Pyruvate Indian Platinum Pvt. Ltd.158 Methyl Salicylate Ip Hiten Pharma Chem152 Methyl Salicylate IP/BP Mehta Associates84 Methyl Sulfonyl Methane Chemkart163 Methyl Tert Butyl Ether (MTBE) Nisha Chemicals71 Mivon Chemicals 28 Meru Chem Pvt. Ltd.105 Methylene Chloride Kanchan Rasayan 34 Western Pharma105 Dev International158 Methylene Chloride (MDC) Malay Enterprise167 Gandhi Chemicals 144 Methylene Chloride Bp Kanchan Rasayan 34 Methylene Chloride Ip Kanchan Rasayan 34 Methylene Di Chloride (MDC) Mivon Chemicals 28 Krishna Solvechem Ltd.21 Dev International158 Apra Enterprises19 Metoclopramide NDC Drug & Chemical Co.Pvt.Ltd. 154 Metoclopramide Hcl Nova Chemiie 24 Metoprolol Succinate Nova Chemiie 24 Metoprolol Succinate / Tartrate NDC Drug & Chemical Co.Pvt.Ltd. 154 Metoprolol Succinate Ip Balaji Corporation89 Aril Pharmaceuticals6/7 Metoprolol Succinate Usp/Ip Shriya Pharma & Surgical42 Methyl Silyl Ester Unimax Group 20 Metoprolol Tartrate Nova Chemiie 24 Metoprolol Tartrate Ip Aril Pharmaceuticals6/7 Metronidazole Parshwa Pharma Chem Pvt. Ltd.40 Metronidazole Salts Nova Chemiie 24 Metronidazole Ip/Bp Aril Pharmaceuticals6/7 MFA (Triacontanol) Powder & Fomulation-2%, 1%, 0.1%, 0.05% S.A.I. Products132 MIBK Khushbu Dye Chem Pvt. Ltd.71 H K Enterprise151 Maruti Petrochem55 Microcrystalline Cellulose IP/BP/USP
J R Drugchem Pvt. Ltd. Back Inside Cover Micafugnin Sodium Balaji Corporation89 Miconazole Nitrate.I.P. Mehta Associates84 Dazzle Corporation88 Miconazole Nitrate IP/BP/EP/USP Maharshee Laboratories Pvt. Ltd. 133 Miconazole Nitrate IP/BP/USP Nova Chemiie 24 Micro Crystalline Cellulose Gautam Pharma Chem84 Micro Crystalline Cellulose & All Grade Ip/Bp/Usp Hiten Pharma Chem152 Micro Waxes Flora Dye Chem 126 Microcrystalline Cellulose Sodium Starch glycolate Regent Chemicals 41 Microcrystalline Wax
Rare
Maruti
(101/102/112)
PRODUCTS INDEX
Balaji Corporation89
Microcrystaline Wax
Western Pharma105
Microcrystalline Wax IP,NF
Flora Dye Chem 126
Microbiological Assays. And Others.
Bombay Test House Private Limited93
Microcrystalline Hydroxyapatite
North India Pharma92
Microliter Syringes
B.J. Scientific Co. 162
Mifepristone
Balaji Corporation89
Vinworld Healthcare P. Ltd147
Milk Calcium Powder
North India Pharma92
Milk of Magnesia
Elite Chemicals89
Milk of Magnesia IP / USP
Gangotri Inorganic (P) Ltd.18
Milk Thistle Extract 80%
Global Merchants25
Minoxidil Usp
Aril Pharmaceuticals6/7
Mirtazapine
Hap Enterprise67
NDC Drug & Chemical Co.Pvt.Ltd. 154
Mirtazepine Usp
Aril Pharmaceuticals6/7
Misoprostol
Aara Pharma150
Vinworld Healthcare P. Ltd147
Microcrystalline Wax - IP / USP
Arjun Beeswax Industries169
Microbalances
Khushboo Scientific13
Misoprostol Hpmc( 1%)
Balaji Corporation89
Mix Xylene
Mivon Chemicals 28
Khushbu Dye Chem Pvt. Ltd.71
Paresh Chemical Corporation 78
Maruti Petrochem55
Mixed Carotenoids 10%, 20%, 30%
North India Pharma92
Mixed Xylene
Apra Enterprises19
Apra Innovative Pvt Ltd 19
M M A
H K Enterprise151
Apra Enterprises19
Apra Innovative Pvt Ltd 19
Monosulfiram BP
Mahaveer ChemicalsEar Panel
Mono / Di / Tri Sodium Phosphate
Vinipul Chemicals Pvt. Ltd.31
Mono Ammonium Phosphate
Vinipul Chemicals Pvt. Ltd.31
Mono Potassium Phosphate
Vinipul Chemicals Pvt. Ltd.31
Advance in Organics LLP128
Modafinil Bp
Aril Pharmaceuticals6/7
Modified Starch (Food Grade)
Shree Chemicals117
Moly Trioxide
Indian Platinum Pvt. Ltd.158
Mometasone Fumorate Ip/Usp
Hiten Pharma Chem152
Mometasone Furoate
Balaji Corporation89
Nova Chemiie 24
DM Pharma22
Mometasone Furoate/Monohydrate
Unimax Group 20
Mometasone Furoate Ip / Bp
Kahan Pharmaceuticals 08
Siddhivinayak pharma 160
Mometasone Furoate IP/ BP/ USP
Hritik Chemicals Pvt. Ltd.99
Monk Fruit Extract 25% Chemkart163
Monosodium Phosphate
Pari Chemicals136
Mono Calcium Phosphate
Meru Chem Pvt. Ltd.105
Mono Calcium Phosphate (Monohydrate / Anhydrous)
Tri Calcium Phosphate
Pari Chemicals136
Mono Ethylene Glycol
Relic Chemicals82
Mono Chloro Benzene
Khushbu Dye Chem Pvt. Ltd.71
Stratechem (I) Pvt. Ltd. 88
Monoethanolamine
Paresh Chemical Corporation 78
Monoethanolamine Thioglycolate
Synchrom Laboratory Pvt Ltd146
Mono Ethyl Alcohol
Apra Enterprises19
Apra Innovative Pvt Ltd 19
Mono Ethyl Amine 78%
Krishna Solvechem Ltd.21
Mono Methyl Amine (30%)
Relic Chemicals 82
Mono Methyl Amine (40%)
Relic Chemicals 82
Mono Ethylene Glycol (MEG)
Mivon Chemicals
Meru Chem Pvt. Ltd.105 Mono Ethanolamine
Mivon Chemicals
Mono Isopropyl Amine 78%
Krishna Solvechem Ltd.21
Mono Methyl Amine (MMA)
Krishna Solvechem Ltd.21
Mono Phosphate
Siddhivinayak Pharma160
Montelukast Sodium
Aril Pharmaceuticals6/7
NDC Drug & Chemical Co.Pvt.Ltd. 154
Dazzle Corporation88
Montelukast Granules 6.8%
YSK Laboratories Pvt. Ltd.56
Mono Sodium Glutante
SDA Product17
Mono Sodium Phosphate (Dihydrate/Anhydrous) Advance in Organics LLP128 Mono Sodium Phosphate
Krishna Solvechem Ltd.21
SDA Product17
Meru Chem Pvt. Ltd.105
Monocalium Phosphate (Mcp)
SDA Product17
Mono Phosphate
Advance in Organics LLP128
Monoethanolamine (MEA)
Krishna Solvechem Ltd.21
Monoethylene Glycol (MEG)
Krishna Solvechem Ltd.21
Monosulfiram North India Pharma92
Montelukast
Aara Pharma150
DM Pharma22
Montelukast Ip
Sheetal Chem 101
Kahan Pharmaceuticals 08
Montelukast Sodium
Hap Enterprise67
Montelukast Sodium Ip
Aril Pharmaceuticals6/7
Shriya Pharma & Surgical42
Montelukast Sodium IP/BP
Hritik Chemicals Pvt. Ltd.99
Montelukast Sodium IP/BP/USP Nova Chemiie
Morantel Citrate Crystal Pharma76
Morpholine
Khushbu Dye Chem Pvt. Ltd.71 Krishna Solvechem Ltd.21 Maruti Petrochem55
MOS Feed Grade
Rosetta Life Care Private Limited14
Mosapride Citrate Dihydrate Ip
Aril Pharmaceuticals6/7 Metoclopramide Hap Enterprise67
Chloro Acetic Acid (MCA)
Chemz148 Moxifloxacin
Healthcare P.
Hcl
Pukhraj122
Mulberry Extract North India Pharma92
Multani Mitti
Suraiya Private Ltd.93 Multi-Functional Additives For Krishna Antioxidants Pvt. Ltd.87 Multiple Phase Reaction Filtromix Equipments LLP
Murexide
Oxford Laboratory Chemicals141
Murexide (Ammonium Purpurate)
Arnish Laborates Pvt. Ltd.103
Mupirocin Balaji Corporation89
Vinworld Healthcare P. Ltd147 Hap Enterprise67 Aara Pharma150
NDC Drug & Chemical Co.Pvt.Ltd. 154
Muffle Furnace
Kesar Control Systems49
Mupirocin
Hap Enterprise 67
Mycophenolate Mofetil Shamrock61
Myristic Acid Kanchan Rasayan 34 Siddharth International101 H K Enterprise151
MYLYNT - Thickener for Shampoo and Body Wash Labh Ingredients152
N‐Bromosuccinimide Relic Chemicals82
N‐Butyl Bromide Relic Chemicals82
N Bromo Succinimide
Pacific Biochem Private Limited82
N Butyl Bromide
Pacific Biochem Private Limited82
N, N –Dimethyl –P- Phenylenediamine Oxalate Ar
Oxford Laboratory Chemicals141
N-1 Napthyl Ethylene Diamine Di Hcl
Qualikems Lifesciences Pvt. Ltd.139
N-1 Naphthyl Ethylene Diamine Dihydrochloride Lr/Ar
Oxford Laboratory Chemicals141
N-2-Hydroxy Ethyl Phthalimide Arnish Laborates Pvt. Ltd.103
N-Acetyl L Carnitine Hcl
Raivat Impex Pvt. Ltd.59
N-Acetyl L Tyrosine Raivat Impex Pvt. Ltd.59
N-Acetylcysteine Bp DM Pharma22
N-Acetyl-Cystin
Siddhivinayak Pharma160
N-Acetyl-Cystin / L-Arginine (L-Series)
Siddhivinayak Pharma160
N-Acetyl DL-Methionine Chemkart163
N-Acetyl DL-Tryptophan Chemkart163
N-Acetyl L-Carnitine Chemkart163
N-Acetyl L-Cysteine Chemkart163
N-Acetyl L-Glutamic Acid Chemkart163
N-Acetyl L-Glutamine Chemkart163
N-Acetyl L-Tyrosine Chemkart163
N-ATCA, Brassinolide, C.C.C., etc. Yuvi Chemz148
N-Bromide Succinimide Krishna Solvechem Ltd.21 N-Bromo Succinimide
Phthalimide
Arnish Laborates Pvt. Ltd.103 N-Isopropyl Phthalimide Arnish Laborates Pvt. Ltd.103 N-Methyl Phthalimide Arnish Laborates Pvt. Ltd.103
(Meglumine)
Petrochem55
N-Methyl Pyrrolidone (NMP) Nisha Chemicals71
N,N’-Dicyclohexylcarbodiimide (1,3DCC)
Inventys58
N.O-Dimethylhydroxylamine Hydrochloride
Asiel Chemipharma35
N Octanol
Krishna Solvechem Ltd.21
N- Octyl Bromide
Krishna Solvechem Ltd.21
N- Octyl Chloride
Krishna Solvechem Ltd.21
N-Propanol
Mivon Chemicals 28
Khushbu Dye Chem Pvt. Ltd.71
N Pentanol
Krishna Solvechem Ltd.21
N-Pentyl Bromide
Mody Chemi Pharma Pvt. Ltd. 47
N Pentyl Chloride / Bromide
Krishna Solvechem Ltd.21
N-Phenyl Anthranilic Acid
Oxford Laboratory Chemicals141
N Propanol
Maruti Petrochem55
N-Propyl Acetate
Maruti Petrochem55
N-Propyl Bromide
Krishna Solvechem Ltd.21
Mody Chemi Pharma Pvt. Ltd. 47
N - Methyl Pipraazine
Om Pharma Chem48
Naphthelene Acetic Acid
Yuvi Chemz148
Nadifloxacin Ip
Shriya Pharma & Surgical42
Nalidixic Acid IP/BP/EP/USP
90 Elementos Pvt. Ltd. 104
Naloxone Hcl
Aril Pharmaceuticals6/7
Naloxone Hydrochloride
Balaji Corporation89
Nandrolone Decanoate / Phenylpropionate
Panchsheel Organics Limited91
Balaji Corporation89
Nandrolone Decanoate (ND) - IP / BP / EP / USP
VM Life Science108
Nandrolone Phenylpropionate (NPP) - IP / BP / USP
VM Life Science108
Nano Hydroxyapatite
Labh Ingredients152
Naphazoline Hcl/ Nitrate
Panchsheel Organics Limited91
Naproxen Sodium
Aril Pharmaceuticals6/7
Unimax Group 20
Nandrolonephenyl Propionate
Balaji Corporation89
Nattokinase
Asiel Chemipharma35
Natural Caffeine 99%
206 THE MAZADA PHARMA GUIDE
28
28
24
Yuvi
Vinworld
Ltd147 Nova Chemiie 24 Aril Pharmaceuticals6/7 NDC Drug & Chemical Co.Pvt.Ltd. 154 Moxifloxacin
Orex
Moxifloxacin
Orex
Mono
Hcl
Pharma Pvt. Ltd.25
Pharma Pvt. Ltd.25 MTBE Misrimal
149
Mody
Pharma Pvt. Ltd.
N-Bromo Succinimide (NBS) AD Pharmachem Pvt Ltd 30 N-Butanol Mivon Chemicals 28 Gandhi Chemicals 144 H K Enterprise151 Chemstar Global Products LLP76 Maruti Petrochem55 Apra Enterprises19 N-Butyl Bromide Mody Chemi Pharma Pvt. Ltd. 47 N-Butyl Bromide (NBB) AD Pharmachem Pvt Ltd 30 N-Butyl Nitril Asiel Chemipharma35 N-Butyric Acid Chemstar Global Products LLP76 N Butyric Acid / Iso Butyric Acid Jay Chem Marketing128 N-Butyl Metha Acrylate (NBMA) Nisha Chemicals71 N-Butyl Phthalimide Arnish Laborates Pvt. Ltd.103 NBA Khushbu Dye Chem Pvt. Ltd.71 N-Chloro Succinimide Krishna Solvechem Ltd.21 N-Chloro Succinimide Mody Chemi Pharma Pvt. Ltd. 47 N - Decene Chemaroma Drug House 91 N - Dodecene Chemaroma Drug House 91 N-Ethyl-D- Glucamine (Eglumine) NGL Fine - Chem Limited105 N - Heptane Mivon Chemicals 28 Khushbu Dye Chem Pvt. Ltd.71 N-Heptane / Formic Acid Apra Enterprises19 N - Hexene Chemaroma Drug House 91 N - Hexane Nisha Chemicals71 N - Hexanol Chemaroma Drug House 91 Krishna Solvechem Ltd.21 N Hexyl Pacific Biochem Private Limited 82 N-Hexyl Bromide Krishna Solvechem Ltd.21 N-Hexyl Chloride Krishna Solvechem Ltd.21 N-(Hydroxy Methyl) Phthalimide Arnish Laborates Pvt. Ltd.103 N-Hydroxy
Chemi
47
Mivon
28 Krishna Solvechem
N
Maruti
N-Methyl-D - Glucamine
NGL Fine - Chem Limited105 N-Methyl-2-pyrrolidone
Chemicals
Ltd.21
Methyl Piperazine
PRODUCTS INDEX
Global Merchants25
Natural Caffeine Extract
CSV Pharmaceuticals India Pvt. Ltd.169
Natural Emulsifying Wax O/ W
Flora Dye Chem 126
Natural Progesterone (Micronise)
Balaji Corporation89
Nebivolol Hcl
Balaji Corporation89
Nebivolol Hcl Ip
Aril Pharmaceuticals6/7
Nebivolol Hydrochloride
Maruti Industries24
Neroli Oil
Kamakhya ImpexFlap
Oregano Oil
Neocuproine
Oxford Laboratory Chemicals141
Neomycin Sulphate
Shree Raj Chem84
Crystal Pharma76
Neomycin Sulphate Ip
U.K. Vet Chem65
Neomycin Sulphate IP/BP
Hritik Chemicals Pvt. Ltd.99
Neostigmine Methyl Sulfate / Bromide
Panchsheel Organics Limited91
Neotame
Malay Enterprise167 Chemkart163
Nepafenac
Balaji Corporation89
Aara Pharma150
Nepafenac (Sterile & Micronised)
Siddhivinayak Pharma160
Neutral Protease
SDA Product17
Nevirapine
Jay Chem Marketing128
Niacin
Rajshi Chemical & Products 143
Nova Chemiie 24
Vita-Min Probitic93
Niacin Ip
Crystal Pharma76
Niacinamide
Western Pharma105
Parshwa Pharma Chem Pvt. Ltd.40
DM Pharma22
NDC Drug & Chemical Co.Pvt.Ltd. 154
Dev International158
Kahan Pharmaceuticals 08
Niacinamide IP/BP
Hritik Chemicals Pvt. Ltd.99
Nitric Acid 61%, 72%, 68%
Thana Acid & Chemical Co145
Nitro Benzene
Thana Acid & Chemical Co145
Niacinamide IP/BP/USP
Shree Raj Chem84
Rajshi Chemical & Products 143
Malay Enterprise167
Nova Chemiie 24
Kahan Pharmaceuticals 08
Nickel Ammonium Sulphate
Qualikems Lifesciences Pvt. Ltd.139
Nickel Base Catalyst
Omkar Lab155
Nickel Carbonate
Qualikems Lifesciences Pvt. Ltd.139
Nickel Iodide
SVG Pharma Lifesciences Pvt. Ltd.145
Nickle Oxide
Omkar Lab155
Nickel Phosphate
Qualikems Lifesciences Pvt. Ltd.139
Nickel Sulphate Heptahydrate
Qualikems Lifesciences Pvt. Ltd.139
Nickel Sulphate Hexahydrate
Qualikems Lifesciences Pvt. Ltd.139
Niclosamide Bp Vet
Crystal Pharma76
Nicorandil Luconic Chemicals103
B.Pankaj & Co.84
siddhivinayak pharma 160 DM Pharma22
Nicorandil Ip/Bp Pramukh Pharmachem Pvt. Ltd.80
Nifidipine
Hap Enterprise67
NDC Drug & Chemical Co.Pvt.Ltd. 154
Nimodipine Ep North India Pharma92
Nimesulide
Shree Raj Chem84
Vinworld Healthcare P. Ltd147
Nova Chemiie 24
Parshwa Pharma Chem Pvt. Ltd.40
NDC Drug & Chemical Co.Pvt.Ltd. 154
Nimesulide Bp
Kahan Pharmaceuticals 08 Hap Enterprise67
Nimesulide IP/BP
Hritik Chemicals Pvt. Ltd.99
Ninhydrin
Arnish Laborates Pvt. Ltd.103
Nitazoxanide
Ngl Fine Chem Ltd. 105
Nova Chemiie 24
Nitration Reaction
Pacific Biochem Private Limited82
Nitroscanate
NGL Fine - Chem Limited105
Nitrazepam Ip Ip
Aril Pharmaceuticals6/7
Nitrile Flocked Line Gloves
Hetal International30
Nitric Acid 80% and 106%
Sunraj Chemical co.168
Nitrofurantoin Mono/Anhydrous
Panchsheel Organics Limited91
Nitrofurazone
Panchsheel Organics Limited91
Nitrofurazone Bp/Usp
Crystal Pharma76
Nitrofurantoin Pellets
Panchsheel Organics Limited91
Nitroxynil BP
NGL Fine - Chem Limited105
Nizatidine
DM Pharma22
N-Octyl Bromide
Mody Chemi Pharma Pvt. Ltd. 47
Pacific Biochem Private Limited
82 N-Octane
Chemaroma Drug House 91
Nomegestrel
Hritik Chemicals Pvt. Ltd.99
N Pentyl Bromide
Pacific Biochem Private Limited82
N-Pentanol
Chemaroma Drug House 91
N Propyl Bromide
Pacific Biochem Private Limited82
Nonylated Diphenylamine
Krishna Antioxidants Pvt. Ltd.87
Nonyl Phenol Ethoxylate
Yuvi Chemz148
Nootropic Chemical Matrix166
Noradrenaline Bitartrate
Panchsheel Organics Limited91
Balaji Corporation89
Norandrenaline Bitartrate
Panchsheel Organics Limited91
Norethisterone / Norethindrone (NET) - IP / BP / EP / USP
VM Life Science108
Norethisterone Acetate
Balaji Corporation89
Panchsheel Organics Limited91
Norethisterone Enanthate
Balaji Corporation89
Norethistrone Ip/Bp
Balaji Corporation89
Norfloxacin
Nova Chemiie
Norgentamine
Panchsheel Organics Limited91
Norgestrel
Panchsheel Organics Limited91
Hritik Chemicals Pvt. Ltd.99
Normal Hexane
Apra Enterprises19
Apra Innovative Pvt Ltd19
Nortriptyline
Luconic Chemicals103
Nortriptyline Hcl
NDC Drug & Chemical Co.Pvt.Ltd. 154
Nortriptyline Hcl Ip/Bp
Aril Pharmaceuticals6/7
Nutraceuticals Raw Material
international drug & chemical co.165
Nucleotides Products international drug & chemical co.165
O-Benzyi Hydroxylamine Hydrochi
Arnish Laborates Pvt. Ltd.103
O-Benzyl Salbutamol
Orex Pharma Pvt. Ltd.25
Oxfendazole
Orex Pharma Pvt. Ltd.25
Oxyclozanide
Orex Pharma Pvt. Ltd.25
O Chloro Benzo Nitrile (oCBN) Inventys58
O-Nitrobenzaldehyde / 2-Nitrobenzaldehyde
Croma Chemical Corporation106
Online Flying Laser
Advanced Industrial Micro Systems 25
Octane Boosters
Krishna Antioxidants Pvt. Ltd.87
Octanol
Mivon Chemicals 28
H K Enterprise151
Octenyl Succinate Starch
Labh Ingredients152
Octanol (2-EH)
Khushbu Dye Chem Pvt. Ltd.71
Octinoxate (octyl P-methoycinnamate)(o.m.c.)
Siddhivinayak Pharma160
Octreotide Acetate
Balaji Corporation89
Octyl Phenol 8 / 10ml
Meru Chem Pvt. Ltd.105
Octyl Salicylate
Heni Drugs Pvt. Ltd.49
Ofloxacin
Parshwa Pharma Chem Pvt. Ltd.40
Vinworld Healthcare P. Ltd147
Kahan Pharmaceuticals 08
Ofloxacin Ip
Shriya Pharma & Surgical42
Ofloxacin IP/BP
Hritik Chemicals Pvt. Ltd.99
Ofloxacin IP/BP/USP
Espee Pharma Chem Pvt. Ltd.94
Shree Raj Chem84
Aril Pharmaceuticals6/7
Nova Chemiie 24
Ofloxacin Ip Malay Enterprise167
Oil Arachies
Kems Raw Pharma93
Based Silicone Wax
Dye Chem
Pharma93
Pharma93
Neem Refine
Raw Pharma93
Olive
Raw Pharma93
NDC Drug & Chemical Co.Pvt.Ltd.
THE MAZADA PHARMA GUIDE 207
24
Oil
Flora
126 Oil
Oil
Oil
Oil
Kems
154 Reenold Enterprises137 Olanzapine IP/BP/USP Aril Pharmaceuticals6/7 Oleic Acid Siddharth International101 Maruti Petrochem55 Oleic Acid (Indian / Imported) H K Enterprise151 Oleic Acid Emulsolic Eco Kanchan Rasayan 34 Oleic Acid Indolic Grade Kanchan Rasayan 34 Oleic Acid Lopour Kanchan Rasayan 34 Oleic Acid Lubolic 15 Kanchan Rasayan 34 Oleic Acid Lubolic 20 Kanchan Rasayan 34 Oleic Acid Lubolic 21 Kanchan Rasayan 34 Oleic Acid Lubolic E Kanchan Rasayan 34 Oleic Acid Pure Oleic 91% Kanchan Rasayan 34 Oleoresin Paprika DM Pharma22 Oleum Acid 25% and 65% Sunraj Chemical co.144 Oleoresins/Butter CSV Pharmaceuticals India Pvt. Ltd.169 Oley Amine Ethoxylate (2.0 mole) Yuvi Chemz148 Olium Lini Siddhivinayak Pharma160 Olive Oil Global Merchants25 Olive Wax Flora Dye Chem 126 Olmesartan IP/BP/USP Kahan Pharmaceuticals 08 Olmesartan Calyx Chemical & Pharmaceuticals Ltd.23 Olmesartan Medoxomil Nova Chemiie 24 DM Pharma22 NDC Drug & Chemical Co.Pvt.Ltd. 154 Olmesartan Medoxomil Ep/Bp DM Pharma22 Olmesartan Medoxamil Ip Aril Pharmaceuticals6/7 Olopatadine Aara Pharma150 Olopatadine HCl Progress Life Sciences Pvt. Ltd.29 Omega 3 Fatty Acid (Veg) North India Pharma92 Omega 3 Fatty Acid Powder Panchsheel Organics Limited91 Omeprazole 20 MG+ Domperidone 10 MG Pellets Kahan Pharmaceuticals 08 Omeprazole Magnesium Ip Aril Pharmaceuticals6/7 Omeprazole Pellets Panchsheel Organics Limited91 Western Pharma105 Omeprazole (EC) & Domperidone (SR) Pellets Sheetal Chem101 Omeprazole Ec Pellets (7.5% / 8.5%) Kahan Pharmaceuticals 08 Omeprazole Magnesium IP/BP/USP Sheetal Chem 101 Kahan Pharmaceuticals 08 Omeprazole Powder Vinworld Healthcare P. Ltd147 Omeprazole Powder IP/ Usp Pellets Sheetal Chem101 Omeprazole Powder / Pellets 7.5 % / 8.5% Sheetal Chem 101 Oncology Chemical Matrix166 Ondansetron Hap Enterprise67 NDC Drug & Chemical Co.Pvt.Ltd. 154 Ondansetrone Hcl Balaji Corporation89 Ondansetrone HCL BP / USP Maharshee Laboratories Pvt. Ltd. 133 Ondansetron Hcl Ip/Bp/Usp Pramukh Pharmachem Pvt. Ltd.80 Ondencentron Hcl Usp Aril Pharmaceuticals6/7 Ondansetron HCL/Base Vinworld Healthcare P. Ltd147 Ondansetron Hydrochloride Nova Chemiie 24 Orange Oil Maruti Petrochem55 Vikram Aromatics144 Orange Wax Flora Dye Chem 126 Organic Manure SDA Product17 Organic Waxes Flora Dye Chem 126 Orlistat international drug & chemical co.165 Balaji Corporation89 Orlistat -20%, 50% Pellets Panchsheel Organics Limited91 Orlistat 106%/Usp Unitrade Agencies70 Other Various Grade Are Available Gbl Chemical Limited73 Orlistate Pellets (30% / 40% / 50% / 60%) Kahan Pharmaceuticals 08 Ores & Minerals Bombay Test House Private Limited93 Ornidazole Parshwa Pharma Chem Pvt. Ltd.40 Kahan Pharmaceuticals 08 Online CIJ Replacement Inkjet Advanced Industrial Micro Systems 25 Ornidazole IP Malay Enterprise167 Shriya Pharma & Surgical42 Ornidazole IP/ BP Hritik Chemicals Pvt. Ltd.99 Ornidazol IP/BP/USP Espee Pharma Chem Pvt. Ltd.94 Nova Chemiie 24 Orphenadrine Citrate Luconic Chemicals103 Maharshee Laboratories Pvt. Ltd. 133 Ortho Chloro Benzonitrile Krishna Solvechem Ltd.21 Ortho Toluene Diamine (OTD) Thana Acid & Chemical Co145 OrthoNitroAniline Reenold Enterprises137 Ortho Chloro Toluene Ketan Chemical Corporation119
Castor Bss Kems Raw
Linseed Refine Kems Raw
Kems
Olanzapine
PRODUCTS INDEX
Ortho Cresol
Ketan Chemical Corporation119
Ortho Dichloro Benzene (Odcb)
Ketan Chemical Corporation119
Ortho Nitrobenzoic Acid / 2-Nitrobenzoic Acid
Croma Chemical Corporation106
Ortho Phenylene Diamine (OPDA)
Krishna Solvechem Ltd.21
Ortho Phthalaldehyde
Asiel Chemipharma35
Ortho Toluic Acid
Asiel Chemipharma35
Chemaroma Drug House 91
Ortho Toluene Para Toluene Sulfonamide Mixture
Stratechem (I) Pvt. Ltd. 88
Ortho Toluene Para Toluene
Stratechem (I) Pvt Ltd.88
Ortho Toluene Sulfonamide
Stratechem (I) Pvt. Ltd. 88
Ortho Xylene
Mivon Chemicals 28
Maruti Petrochem55
Apra Enterprises19
Apra Innovative Pvt Ltd19
Orthoxylene
Khushbu Dye Chem Pvt. Ltd.71
Oseltamivir Phosphate IP Balaji Corporation89
Osmium Tetroxide 99.103%
Croma Chemical Corporation106
Oven Incubator Furnace
B.J. Scientific Co. 162
Oven
Avi Scientific (India)168
Oxaceprol
Shriya Pharma & Surgical42
Oxacillin Sodium Sterile Nova Chemiie 24
Oxalic Acid
Mivon Chemicals 28
Khushbu Dye Chem Pvt. Ltd.71 Misrimal Pukhraj122
Oxalic Acid 99%/ 105%
Meru Chem Pvt. Ltd.105
Oxcarbazepine DM Pharma22
Oxetacaine
Oxfendazole BP VET / EP Chemino Pharma Ltd94
Oxfendazole
Reenold Enterprises137
Oxiconazole
Balaji Corporation89
Oxidized Polyethylene Wax
Flora Dye Chem 126
Oxybenzone / Avobenzone / Omc
Siddhivinayak Pharma160
Oxybenzone USP (BP-3) Maharshee Laboratories Pvt. Ltd. 133
Oxybutynin Hcl
Aril Pharmaceuticals6/7
Oxyclozanide
Crystal Pharma76
Oxyclozanide BP VET /EP
Chemino Pharma Ltd94
Oxymetazoline
Aril Pharmaceuticals6/7
Oxytetracycline
Crystal Pharma76
Ozokerite Wax
Flora Dye Chem 126
Ozokerite Wax - IHS
Arjun Beeswax Industries169
Patent Search, PNIS & FTO
Gnanlex Associates LLP169
Patent Enforcement, Opposition, Gnanlex Associates LLP169
Patent Expiry Status Report (Worldwide)
Gnanlex Associates LLP169
Patent Landscaping
Gnanlex Associates LLP169
Patent Mining and R&D Coordination
Gnanlex Associates LLP169
Patentability Consultancy / Workaround Solutions
Gnanlex Associates LLP169
Patents – Specification & Claim Drafting, Trademarks – Filing - Prosecution & Litigation
Filing, Prosecution & Litigation
Revocation and Related Suits
Gnanlex Associates LLP169
P-Amino Methyl Benzoic Acid (Tranexamic Acid)
Pramukh Pharmachem Pvt. Ltd.80
P Chloro Phenyl Glycine (pCPG) Inventys58
P-Toulenesulfonylurea
Maruti Industries24
P.E.G
Siddhivinayak Pharma160
PEG 4000
Chemizo Enterprise166
PEG 200/400/600/6000
Paresh Chemical Corporation 78
PPG 400/1000/2000
Paresh Chemical Corporation 78
P.G
Siddhivinayak Pharma160
PG- Tech
Malay Enterprise167
PG- USP
Malay Enterprise167
PVPK-30
Malay Enterprise167
P.V.P. K-30 / K-90 Exci Gen P.V.P.K - 30
Siddhivinayak Pharma160
Packaging & Packaging Products Testing
Bombay Test House Private Limited93
Paints, Varnish
Bombay Test House Private Limited93
Paper & Pulp
Bombay Test House Private Limited93
Paliperidone
Luconic Chemicals103
Palladium 10% on Alumina
Indian Platinum Pvt. Ltd.158
Palladium
Indian Platinum Pvt. Ltd.158
Palladium 5% on Asbestos
Indian Platinum Pvt. Ltd.158
Palladium Acetate
Indian Platinum Pvt. Ltd.158 Omkar Lab155
(EC) & Domperidone (EC) Pellets
Chem101
Pantoprazole & Rabeprazole Pellets Sheetal Chem101
Pantoprazole Sodium Sesq IP/USP/BP Pellets
Sheetal Chem101
Pantoprazole Sodium
Corporation88
Pellets
Pharma105
Panchsheel Organics Limited91 Pantoprazole Sodium Vinworld Healthcare P. Ltd147
Hap Enterprise67
NDC Drug & Chemical Co.Pvt.Ltd.
Pantaprazole Sodium Ip
Shriya Pharma & Surgical42 Malay Enterprise167 Aril Pharmaceuticals6/7 Pantoprazole Sodium Ip / Bp Kahan Pharmaceuticals
Pantoprazole Sodium Sesquihydrate IP/ BP
Hritik Chemicals Pvt. Ltd.99
Pantoprazole Sodium Sterile Balaji Corporation89
Chemiie
Sodium Sterile (Lyophilized)
Chemiie
Pantoprazole Sterile Shamrock61
Papan Ip
Jakson Pharma104
Papain
Asiel Chemipharma35
Papain Ip / Pure
Kems Raw Pharma93
Papain Usp / Refine /5x/7x
Kems Raw Pharma93
Paroxetine Hcl
Panchsheel Organics Limited93
Paper Seal Concentrate (Fire Retardants)
Relic Chemicals93
Raw Pharma93
Para Chloro Benzoyl Chloride
Asiel
Petrochem55 Paraformaldehyde 91% & 105% (Powder & Prills)
Nisha Chemicals71
Ketan Chemical Corporation119
Paroxetine Hcl IP/BP/USP
Aril Pharmaceuticals6/7
Paroxetine Hydrochloride Hemihydrate Ip
Shriya Pharma & Surgical42
Parvaquone Ngl Fine Chem Ltd.
Patchouli Oil (Indonesia , Sulawesi & Sumatra)
Aditi Essentials51
Pharma Enzyeme
Enzyme Bioscience57
PCMX – Para Chloro Meta Xylenol
Kip Chemicals Pvt. Ltd.81
Pearlcare DS-400- Cold process pearlizing Agent
Kip Chemicals Pvt. Ltd.81
Pea Protein Isolate
Raivat Impex Pvt. Ltd.59
Pectin
Kems Raw Pharma93
Pectinase
SDA Product17
Asiel Chemipharma35
PEA (Palmitoylethanolamide)
international drug & chemical co.165
PEG Khushbu Dye Chem Pvt. Ltd.71
PEG 150 di-stearate
Kanchan Rasayan 34
Kip Chemicals Pvt. Ltd.81
PEG 200 / 400
Maruti Petrochem55
PEG 200 / 400 / 600 / 4000 / 6000
Mivon Chemicals 28
PEG 400 / 1500 / 4000 / 6000
Regent Chemicals 41
Pemetraxed Di- Sodium Heptahydrate (onco)
Vinworld Healthcare P. Ltd147
Pentoxifylline
Bakul Aromatics and Chemicals Pvt. Ltd.103
Pentaarythritol Nisha Chemicals71
Pentamethyl Cyclopentadienyl Rhodium (III) Chloride Dimer Indian Platinum Pvt. Ltd.158
Pheniramine Maleate Ip/Bp/Usp
Siddhivinayak Pharma160
Pheniramine Maleate IP/BP/EP/USP
Maharshee Laboratories Pvt. Ltd. 133
Pentoprazole Sodium Parshwa Pharma Chem Pvt. Ltd.40
Pentoprazole Sodium Ses.
Sheetal Chem 101
Peppermint Oil
Amita Chemicals102
Global Merchants25
Peppermint Oil
CSV Pharmaceuticals India Pvt. Ltd.169
Pepsin Asiel Chemipharma35
Pepsin (1:3000) international drug & chemical co.165
208 THE MAZADA PHARMA GUIDE
Chemical
Aril Pharmaceuticals6/7 NDC Drug &
Co.Pvt.Ltd. 154
5% on Charcoal Indian Platinum
Palladium 5% on BASO4
Pvt. Ltd.158
Palladium
Catalyst Indian Platinum Pvt.
Palladium Black Indian Platinum Pvt. Ltd.158 Palladium Catalysts Indian Platinum Pvt. Ltd.158 Omkar Lab155 Palladium Chemicals Indian Platinum Pvt.
Palladium Chloride Indian Platinum
Ltd.158 Omkar Lab155 Palladium Chloride (59-60% Pd ) Oxford Laboratory Chemicals141 Palladium Compound Omkar Lab155 Palladium Metal Omkar Lab155 Para Methoxy Benzyl Amine 90 Elementos Pvt. Ltd. 104 Palladium Nitrate Omkar Lab155 Palladium on Alumina Indian Platinum Pvt. Ltd.158 Palmitoylethanolamide (PEA) Heni Drugs Pvt. Ltd.49 Palladium On Carbon Omkar Lab155 Palladium Oxide Omkar Lab155 Palladium Plating Chemicals Indian Platinum Pvt. Ltd.158 Palladium Sulphate Indian Platinum Pvt. Ltd.158 Omkar Lab155 Palm Wax Flora Dye Chem 126 Palmatic Acid Mivon Chemicals 28 Siddharth International101 H K Enterprise151 Pamabrom Bakul Aromatics and Chemicals Pvt.
Pancreatin Siddhivinayak Pharma160 Nova Chemiie 24 Pancreatin IP Jakson Pharma104 Pantaprazole Balaji Corporation 89 Pantoprazole 40 Mg Ec + Domperidone 30 Mg Sr Kahan
08 Pantoprazole 40 Mg Ec + Levosulpride 91 Mg Sr Kahan Pharmaceuticals 08 Pantoprazole
Sheetal
Alumina
Ltd.158
Ltd.158
Pvt.
Ltd.103
Pharmaceuticals
Dazzle
Pantoprazole
Western
154
08
Nova
24 Pantoprazole
24
Nova
Para Amino
Kems
Para Amino Phenol Purified Grade 90 Elementos Pvt. Ltd. 104 Para Amino Phenol 90 Elementos Pvt. Ltd. 104 Para Amino acetanilide 90 Elementos Pvt. Ltd. 104 Para Bromo Phenol Mody Chemi Pharma Pvt. Ltd. 47 Para Bromo Toluene Mody Chemi Pharma Pvt. Ltd. 47 Krishna Solvechem Ltd.21 Para Chloro Benzene Sulfonamide Stratechem (I) Pvt. Ltd. 88 Para Chloro Benzene Sulfonyl Chloride Stratechem (I) Pvt Ltd.88 Para Chloro Benzo Nitirle Chemaroma Drug House 91 Para Toluic Acid Chemaroma Drug House 91 Para Chloro Benzene Sulfonate (Sodium Salt) Stratechem (I) Pvt. Ltd. 88 Para Chloro Benzene Sulfonyl Stratechem (I) Pvt. Ltd. 88
Benzoic Acid
Chemipharma35 Para Chloro Benzyl Cyanide Asiel Chemipharma35 Para Chloro Meta Cresol Arco Pharma126/164 Kems Raw Pharma93 Para Chloro Thiophenol Stratechem (I) Pvt. Ltd. 88 Para Chloro Toluene Ketan Chemical Corporation119 Para Cresol Pure 99% Ketan Chemical Corporation119 Para Hydroxy Benzaldehye Asiel Chemipharma35 Para Nitro Benzyl Alcohol Arnish Laborates Pvt. Ltd.103 Pera Protien (Vegan) Chemkart163 Para Thiocresol Stratechem (I) Pvt. Ltd. 88 Para Toluic Acid Asiel Chemipharma35 Para Toluene Sulfonic Acid (Ptsa) Ketan Chemical Corporation119 Para Toluene Sulphonic Acid Sheetal Chem 101 Para Toluene Sulphonic Acid Sheetal Chem101 Para Toluene Sulphonic Chloride Sheetal Chem101 Para Toluene Sulfonyl Chloride Stratechem (I) Pvt. Ltd. 88 Ram Enterprise 76 Paracetamol Nova Chemiie 24 Parshwa Pharma Chem Pvt. Ltd.40 Kahan Pharmaceuticals 08 Paracetamol Ip Shriya Pharma & Surgical42 Paracetamol Granules 83%, 90%, 96% YSK Laboratories Pvt. Ltd.56 Paracetamol IP/BP Hritik
Paracetamol IP/BP/USP Shree Raj
Malay
Vinworld Healthcare P.
DM Pharma22 Parachlorobenzophenone Asiel Chemipharma35 Parafin Wax H K Enterprise151 Paraffin/Wax Dispersants Krishna Antioxidants Pvt. Ltd.87 Paraffin Wax Fully Refined Mivon Chemicals 28 Paraffin Wax IP, BP , USP Flora Dye Chem 126 Paraformaldehyde Nisha Chemicals71 Paraformaldehyde
Khushbu
Paraformaldehyde 91%
Mivon Chemicals 28 Meru Chem
Maruti
Chemicals Pvt. Ltd.99
Chem84
Enterprise167
Ltd147
105%
Dye Chem Pvt. Ltd.71
& 105%
Pvt. Ltd.105
105
PRODUCTS INDEX
Pepsin (1:3000. Ip)
Jakson Pharma104
Peptone - Gelatin / Proteose
Kems Raw Pharma93
Peptone (Bactro/ Pharma)
Kems Raw Pharma93
Peptone Fermentation Grade
Eklavya Biotech Pvt. Ltd.103
Peptone Paste
Eklavya Biotech Pvt. Ltd.103
Peptone Pharma Grade
Eklavya Biotech Pvt. Ltd.103
Peptone Regular Grade
Eklavya Biotech Pvt. Ltd.103
Protein Hydrolysate Liquid (Soya/Casein//Rice/Fish)
Eklavya Biotech Pvt. Ltd.103
Protein Hydrolysate Powder (Soya/Casein/Gelatine/Rice/)
Eklavya Biotech Pvt. Ltd.103
Per Chloro Ethylene
Mivon Chemicals 28
Per-Iodic Acid
SVG Pharma Lifesciences Pvt. Ltd.145
Peracetic Acid
Indian Platinum Pvt. Ltd.158
Permethrin North India Pharma92
Siddhivinayak Pharma160 Aara Pharma150
Petophenone Hcl Luconic Chemicals103
P-Floxacin Pure Crystal Pharma76
PH, ION, TDS, Conductivity Meters
B.J. Scientific Co. 162 Pharmaceutical APIs & Excipients Chemizo Enterprise166
Piperine Extract
CSV Pharmaceuticals India Pvt. Ltd.169
Pomegranate Extract/peel
CSV Pharmaceuticals India Pvt. Ltd.169
Phenazone Panchsheel Organics Limited91
Nova Chemiie 24
Phenylbutazone
Dazzle Corporation88
Phenazone IP Siddhivinayak Pharma160
Pheniramine Maleate IP/BP/USP
Siddhivinayak Pharma160
Pheniramine Base
Oceanic Laboratories Pvt. Ltd.44
Pheniramine Maleate-IP/BP/USP/EP
Oceanic Laboratories Pvt. Ltd.44
Phenylglyoxylicacid Methyl Ester
Stratechem (I) Pvt Ltd.88
Phenyl Mercuric Acetate IP/BP/EP/USP
Heni Drugs Pvt. Ltd.49
Phenyl Mercuric Nitrate IP/BP/EP/USP Heni Drugs Pvt. Ltd.49
Phenyl Mercuric Oleate
Heni Drugs Pvt. Ltd.49
Phenobarbital [Plain/Sodium] Ip Aril Pharmaceuticals6/7
Phenylephrine Hcl
Kahan Pharmaceuticals 08
Phenidone A/B(1-phenyl-3pyrazolidone)92-43-3
Yuvi Chemz148
Phenyl Hydrazine (solution)
Yuvi Chemz148
Phenobarbital Base / Sodium Neha Pharma Pvt. Ltd.165
Phenobarbitone
Nova Chemiie 24
Phthalic Anhydride
Relic Chemicals 82
Thana Acid & Chemical Co145
Phenol
Mivon Chemicals 28
Khushbu Dye Chem Pvt. Ltd.71
Meru Chem Pvt. Ltd.105
Phenolphthalein lp
siddhivinayak pharma 160
Phenolphthalein Yellowish White-IP Heni Drugs Pvt. Ltd.49
Phenolphthalein White IP/USP
Heni Drugs Pvt. Ltd.49
Phenoxyethanol-10
Kanchan Rasayan 34
Phenoxyethanol-150
Kanchan Rasayan 34
Phenolphthalein © Heni Drugs Pvt. Ltd.49
Phenolphthalein White-IP, USP
Heni Drugs Pvt. Ltd.49
Phenoxyethanol-25
Kanchan Rasayan 34
Phenoxyethanol-5
Kanchan Rasayan 34
Phenyl Acetyl Chloride
Krishna Solvechem Ltd.21
Stratechem (I) Pvt. Ltd. 88
Phenol Gandhi Chemicals 144
Phenyl Hydrazine
Krishna Solvechem Ltd.21
Phenyl Hydrazine HCL
Krishna Solvechem Ltd.21
Phenyl Mercuric Acetate
Indian Platinum Pvt. Ltd.158
Oxford Laboratory Chemicals141
Phenyl Mercuric Nitrate
Oxford Laboratory Chemicals141
Phenylephrine
Aril Pharmaceuticals6/7
Phenytoin Base/Sodium
Nova Chemiie 24
Pheniramine Base
Oceanic Laboratories Pvt. Ltd.44
Phosphattidylserine Chemkart163
Phosphomolybdic acid
Indian Platinum Pvt. Ltd.158
Phosphoric Acid
Stratechem (I) Pvt. Ltd. 88
Ashapura Intermediates 119
Dev International158
Phosphoric Acid (Tech / Food Grade)
H K Enterprise151
Phosphoric Acid - Food Grade
Keshariya Corporation80
Phosphoric Acid 93%
Mivon Chemicals
Khushbu Dye Chem Pvt. Ltd.71
Krishna Solvechem Ltd.21
Rajan Dye Chem155
Phosphoric Acid 91% / 93% (Technical & Food Grade)
Meru Chem Pvt. Ltd.105
Potassium Bromide Powder
Pacific Biochem Private Limited82
Potassium thioglycolate
Synchrom Laboratory Pvt Ltd146
Potassium Di Hydrogen Ortho Phosphate
Advance in Organics LLP128
Phosphoric Group
Dev International158
Phosphorous Oxychloride (Pocl3)
Ketan Chemical Corporation119
Phosphorous Oxy Chloride
Krishna Solvechem Ltd.21
Phosphorous Pentachloride
Krishna Solvechem Ltd.21
Phosphorous Pentachloride (Pcl5)
Ketan Chemical Corporation119
Phosphorous Pentoxide (P2o5)
Ketan Chemical Corporation119
Phosphorous Trichloride
Krishna Solvechem Ltd.21
Phosphorous Trichloride (Pcl3)
Ketan Chemical Corporation119
pH meter
Khushboo Scientific13
Phosphotungstic Acid
Indian Platinum Pvt. Ltd.158
Photo Stability Chamber
Phthalide
Asiel Chemipharma35
Phthalimide
Arnish Laborates Pvt. Ltd.103
Phytase 5000 Granules
SDA Product17
Phytase 5000ftu/Granular/Powder
SDA Product17
Phytomenadione Premix
Panchsheel Organics Limited91
Phytosterol And Other Ester
Panchsheel Organics Limited91
Phenyl Ethyl Alcohol
Chemaroma
& Surface Coating
Test House Private Limited93
Potassium Sulphate
Vinipul Chemicals Pvt. Ltd.31
Pimecrlimus
Balaji Corporation89
Pimecrolimus
drug & chemical co.165
Chemiie
Pip. Citrate.IP / Pip.Hexa.IP Mehta Associates84
Pipercillin + Tazobactum Sodium Sterile (8:1)
Nova Chemiie
Piperidine
Meru Chem Pvt. Ltd.105
Piprazine Anhydrous
Meru Chem Pvt. Ltd.105
Piracitam IP
Malay Enterprise167
Piroxicam - BP/USP
Progress Life Sciences Pvt. Ltd.29
Piroxicam
Reenold Enterprises137
Piroxicam-β-Cyclodextrin complex
Progress Life Sciences Pvt. Ltd.29
Piroxicam Ip / Bp / Usp
Kahan Pharmaceuticals 08
Piroxicam IP/BP/USP/EP
Chemino Pharma Ltd94
Piroxicam Pellets
Western Pharma105
Pitofenone Hydrochloride
Rumit Group Of Companies78
Pitofenone HCL
Tivan Sciences Pvt. Ltd.40
Pitofenone HCL INH
Maharshee Laboratories Pvt. Ltd. 133
Plaster of Paris I.P.
Hritik Chemicals Pvt. Ltd.99
Platinum Chloride (40% Pt )
Oxford Laboratory Chemicals141
Poly Aluminium Chloride
Keshariya Corporation80
Dev International158
Poly Anionic Cellulose
Labh Ingredients152
Poly Ethylene Glycol (200/400/600/1000/1500/4000/6000)
Meru Chem Pvt. Ltd.105
Poly Ethylene Glycol-7 Glyceryl Cocoate
Kanchan Rasayan 34
Poly Glycerol Stearate
Dev International158
Poly Iso Butane 10 / 30 / 200
Mivon Chemicals 28
Poly Phosphoric Acid (Ppa)
Ketan Chemical Corporation119
Polyelcetrolite
Keshariya Corporation80
Polymyxin B Sulphate
Vinworld Healthcare P. Ltd147
Polyquat-7
Kanchan Rasayan 34
Polyquaternium 10 (Pq-10)
Dev International158
Polyquaternium 7(Pq-7 )
Dev International158
Polysorbate 80/60/40/20
Dev International158
Polyoxyl 20 Cetostearyl Ether - USP
Arjun Beeswax Industries169
Polysorbate 20 - IP / BP / USP / EP
Arjun Beeswax Industries169
Polysorbate 80 - IP / BP / USP / EP
Arjun Beeswax Industries169
Polythylene Glycol 3350 - BP / USP / EP
Arjun Beeswax Industries169
Polythylene Glycol 400 - BP / USP / EP
Arjun Beeswax Industries169
Polythylene Glycol 4000 - IP / BP / USP / EP
Arjun Beeswax Industries169
Polythylene Glycol 600 - BP / USP / EP
Arjun Beeswax Industries169
Polythylene Glycol 6000 - IP / BP / USP / EP
Arjun Beeswax Industries169
Polyvinyl Acetate Phthalate (Pvap) Usp
G. M. Chemie Pvt. Ltd.143
Ponceau 4r Lake
Standardcon Pvt. Ltd.150
Posaconazole
Sheetal Chem 101
Potash Flakes
Maruti Petrochem55
Potassium Bi Carbonate
Nisha Chemicals71
Potassium Chloride
Vinipul Chemicals Pvt. Ltd.31
Potassium Chloried IP [ORS / Injectable]
Arco Pharma126/164
Potassium Chloride ACS
Rare Pharma Pvt. Ltd.148
Potassium Bromide Ir Spectroscopy
Oxford Laboratory Chemicals141
Potassium Carbonate
Dev International158
Potassium Carbonate Powder
Nisha Chemicals71
Potassium Carbonate Powder / Granular
Meru Chem Pvt. Ltd.105
Maruti Petrochem55
Potassium Chloride
Keshariya Corporation80 Potasium Chloride – IP/ Technical Ashapura Intermediates 119
Potassium Chloroplatinate
Oxford Laboratory Chemicals141
Potassium Monopersulfate
Relic Chemicals82
Potassium Iodate Lr/Ar
Oxford Laboratory Chemicals141
Potassium Iodide Lr / Ar Oxford Laboratory Chemicals141 Povidone Iodine
Nitrate
Intermediates 119
Permanganate Dev International158
Potassium Phthalimide
Arnish Laborates Pvt. Ltd.103
Potassium Tellurite
Oxford Laboratory Chemicals141
Pyridoxal 5 Phosphate
Raivat Impex Pvt. Ltd.59
Phenytion Sodium Luconic Chemicals103
Phosphorous Tribromide
Mody Chemi Pharma Pvt. Ltd. 47
Phytase (2900/5000/10000) Granular
Crystal Pharma76
Pine Bark Extract
North India Pharma92
Pine Oil (All Grades)
Vikram Aromatics144
Pioglitazone Hcl Ip
Aril Pharmaceuticals6/7
Pipracilline + Tazobactam Sterile
Balaji Corporation89
Piperazine 76%
Krishna Solvechem Ltd.21
Piperazine Anhydrous
Krishna Solvechem Ltd.21
Piperine 103%
North India Pharma92
Pivaloyl Chloride
Krishna Solvechem Ltd.21
Plasticware
B.J. Scientific Co. 162
Plastics & Polymer Materials
Bombay Test House Private Limited93
Platinum 5% on Charcoal
Indian Platinum Pvt. Ltd.158
Platinum Acetate Omkar Lab155
Platinum Black Indian Platinum Pvt. Ltd.158
Platinum Black Powder
Indian Platinum Pvt. Ltd.158
Platinum Catalyst Omkar Lab155
Platinum Chloride
Indian Platinum Pvt. Ltd.158 Omkar Lab155
Platinum Compound Omkar Lab155
Platinum Oxide Adams Catalyst
Indian Platinum Pvt. Ltd.158
Platinum on Charcoal
Indian Platinum Pvt. Ltd.158
Platinum Metal
Indian Platinum Pvt. Ltd.158 Omkar Lab155
Platinum Nitrate Omkar Lab155
Platinum Oxide Omkar Lab155
Platinum Sulphate Omkar Lab155
PMEDA Krishna Solvechem Ltd.21
Poly (Dipropyleneglycol) Phenylphosphite (Dhop)
Krishna Antioxidants Pvt. Ltd.87
Pollution and Environmental Studies
Bombay Test House Private Limited93
Polyamine Based Shale Stabilizers
Krishna Antioxidants Pvt. Ltd.87
Polybutene - 1300 - 2400- 950
Mivon Chemicals 28
Polyethylene Wax
Flora Dye Chem 126
Polyethylene Glycol-200
THE MAZADA PHARMA GUIDE 209
28
Kesar
Systems 49 Phthalic Anhydride Mivon Chemicals 28
Control
Drug House 91 Picosulfate Sodium Nova Chemiie 24 Picric Acid Indian
Pigments
Bombay
Platinum Pvt. Ltd.158
international
Pioglitazone
NDC Drug
Chemical Co.Pvt.Ltd. 154 Nova
24
Hcl
&
24
Potassium
Ashapura
Kahan Pharmaceuticals 08
Potassium
PRODUCTS INDEX
Shree Vallabh Chemical48
Polyethylene Glycol-300
Shree Vallabh Chemical48
Polyethylene Glycol-1000
Shree Vallabh Chemical48
Polyethylene Glycol-1500
Shree Vallabh Chemical48
Polyethylene Glycol-3350
Shree Vallabh Chemical48
Polyethylene Glycol-4000
Shree Vallabh Chemical48
Polyethylene Glycol-6000
Shree Vallabh Chemical48
Polyethylene Glycol-8000
Shree Vallabh Chemical48
Polyethylene Glycol-10000
Shree Vallabh Chemical48
Polymyxin B suplhate
Vinworld Healthcare P. Ltd147
Polysorbate 80
Malay Enterprise167
Posaconazole
Balaji Corporation89
Potassium Acetate
Kronox Lab Sciences Limited218
Potassium Benzoate
Kronox Lab Sciences Limited218
Potassium Bitartrate
Kronox Lab Sciences Limited218
Potassium Bromate
Mody Chemi Pharma Pvt. Ltd. 47
Potassium Bromate / Bromide / Chloride
HK Group76
Potassium Bromide
Qualikems Lifesciences Pvt. Ltd.139
Kronox Lab Sciences Limited218
Potassium Carbonate
Khushbu Dye Chem Pvt. Ltd.71
Kronox Lab Sciences Limited218
Potassium Carbonate Anhydrous Powder
Kronox Lab Sciences Limited218
Potassium Chloride
Pravina Pharma Chem Products150
Navnidh Pharma Lab84
SDA Product17
Kronox Lab Sciences Limited218
Potassium Chloroplatinate
Indian Platinum Pvt. Ltd.158
Potassium Chromate
Qualikems Lifesciences Pvt. Ltd.139
Potassium Citrate
Kronox Lab Sciences Limited218
Advance in Organics LLP128
Potassium-D-Saccharate
Zuhhad International 86
Potassium Dichromate
Qualikems Lifesciences Pvt. Ltd.139
Potassium Dihydrogen O-Phosphate
Qualikems Lifesciences Pvt. Ltd.139
Potassium Fluoborate
Regal Remedies Limited36
Potassium Fluoride
Regal Remedies Limited36
Qualikems Lifesciences Pvt. Ltd.139
Potassium Hexa Chloro Platinate
Indian Platinum Pvt. Ltd.158
Potassium Hydrogen Carbonate
Kronox Lab Sciences Limited218
Potassium Hydrogen Slfate
Kronox Lab Sciences Limited218
Potassium Hydrogen Sulphate
Qualikems Lifesciences Pvt. Ltd.139
Potassium Hydroxide Pallets
Siddhivinayak Pharma160
Qualikems Lifesciences Pvt. Ltd.139
Kronox Lab Sciences Limited218
Potassium Iodate
SVG Pharma Lifesciences Pvt. Ltd.145
Potassium Iodate / Iodide
Crystal Pharma76
Siddhivinayak Pharma160
Meru Chem Pvt. Ltd.105
Powder Filling
Advanced Industrial Micro Systems 25
Potassium Iodide
DM Pharma22
SVG Pharma Lifesciences Pvt. Ltd.145
Kronox Lab Sciences Limited218
Pouch Packing
Advanced Industrial Micro Systems 25
Potassium Iodoplatinate Indian Platinum Pvt. Ltd.158
Potassium Magnesium Citrate
Navnidh Pharma lab84
DM Pharma22
Potassium Metabisulphite
Pari Chemicals136
Potassium Meta Bi Sulphite
Krishna Solvechem Ltd.21
Kronox Lab Sciences Limited218
Potassium Meta Par Iodate
SVG Pharma Lifesciences Pvt. Ltd.145
Potassium Nitrate
SDA Product17
Qualikems Lifesciences Pvt. Ltd.139
Kronox Lab Sciences Limited218
Potassium Phosphate Dibasic
Kronox Lab Sciences Limited218
Potassium Phosphate Monobasic
Kronox Lab Sciences Limited218
Potassium Sodium Tartrate
Kronox Lab Sciences Limited218
Potassium Sorbate
Mivon Chemicals 28
Kronox Lab Sciences Limited218
Global Merchants25
HK Group76
Potassium Sorbate
U.K. Vet Chem65
Potassium Sulphate
Kronox Lab Sciences Limited218
Potassium-Tert-Butoxide
Ram Enterprise 76
Potassium Tetrachloroplatinate
Indian Platinum Pvt. Ltd.158
Pott. Bicarbonate
Meru Chem Pvt. Ltd.105
Poultry Feed Supplements
Gautam Pharma Chem84
Pour Point Depressants
Krishna Antioxidants Pvt. Ltd.87
Povidone Iodine
Parshwa Pharma Chem Pvt. Ltd.40
DM Pharma22
Povidione Iodine IP/ BP
Hritik Chemicals Pvt. Ltd.99
Povidone Iodine Stabilised
DM Pharma22
Powder-Liquid Mixing
Filtromix Equipments LLP149
Powder-Powder Mixing
Filtromix Equipments LLP149
Powdered Oyster Shell JP
Gangotri Inorganic (P) Ltd.18
PP Tray For Tray Dryers
Plastic Fabricators59
PP Pall Ring & Telerate Tower Packing
Plastic Fabricators59
PP Scoop & Scrapper
Plastic Fabricators59
PP Strainers & Ejectors
Plastic Fabricators59
PP Impeller
Plastic Fabricators59
Pramoxine Hcl
Aril Pharmaceuticals6/7
Praziquantel
Panchsheel Organics Limited91
Nova Chemiie 24
Reenold Enterprises137
NGL Fine - Chem Limited105
Praziquantel Ip / Bp / Usp / Ep
Crystal Pharma76
Precious Metal Catalysts/Compounds
Omkar Lab155
Precious Metal salts
Omkar Lab155
Pre-Pro Biotic Blend
international drug & chemical co.165
Precipitated Calcium Silicate NF
Kanchan Rasayan 34
Precipitated Silica Elite Chemicals89
SDA Product17
Precipited Silica / Hydrated Lime
Gangotri Inorganic (P) Ltd.18
Precipited Silica / Silicon Dioxide HK Group76
Pregabalin Usp/Ip/Bp
Rolence Pharma & Chemicals127
Pregabalin
Dazzle Corporation88
Pregabaline-IP/BP/USP/EP
Oceanic Laboratories Pvt. Ltd.44
Prednisolone
Unitrade Agencies70
Vinworld Healthcare P. Ltd147
Rumit Group Of Companies78
Prednisolone Ip
Hiten Pharma Chem152
Pregabalin Kahan Pharmaceuticals 08
Prednisolone Acetate
Panchsheel Organics Limited91
Rumit Group Of Companies78
Prednisolone Acetate Ip
Hiten Pharma Chem152
Prednisolone Sodium Ip
Hiten Pharma Chem152
Predanisolone Sodium Phosphate Ip
Balaji Corporation89
Prednisolone Sodium Phosphate
Unimax Group 20
Prednisolone Sodium Metasulfobenzoate
Unimax Group 20
Pregabaline
Sheetal Chem 101
Jay Chem Marketing128
Balaji Corporation89
Nova Chemiie 24
Parshwa Pharma Chem Pvt. Ltd.40
Aara Pharma150
Maruti Industries24
NDC Drug & Chemical Co.Pvt.Ltd. 154
Pregabalin - INH/USP
Progress Life Sciences Pvt. Ltd.29
Pregabaline Ip
Aril Pharmaceuticals6/7
Shriya Pharma & Surgical42
Pregabalin Ip/Bp/Ep/Usp
Diligent Life Care38
Pregelatinised Starch IP / BP / USP
Arco Pharma126/164
Pregelatinized Starch (Pharma Grade)
Shree Chemicals117
Pressure Gauge :
Centrifuge
Speed Indicator
Avi Scientific (India)168
Prilocaine
Balaji Corporation89
Prilocaine Hydrochloride BP/EP/USP
Chemino Pharma Ltd94
Prilocaine IP/BP/EP/USP
Chemino Pharma Ltd94
Pro-Pre Biotic Blend
international drug & chemical co.165
Probiotic Blend 1 To 200 Billion Cfu
Jakson Pharma104
Probiotics
Enzyme Bioscience57
Prochlorperazine Maleate Inh
Aril Pharmaceuticals6/7
Prochlorperazine Maleate Ip
Shriya Pharma & Surgical42
Procyclodine
Luconic Chemicals103
Proflavine Hemisulphate
Kems Raw Pharma93
Progesterone
Panchsheel Organics Limited91
Parshwa Pharma Chem Pvt. Ltd.40
Vinworld Healthcare P. Ltd147
NDC Drug & Chemical Co.Pvt.Ltd. 154
Progesterone (PGS) - IP / BP / EP / USP
VM Life Science108
Promethazine Hcl Ip
Aril Pharmaceuticals6/7
Propionaldehyde
Krishna Solvechem Ltd.21
Propanolol Hcl IP/BP/USP Aril Pharmaceuticals6/7
Propionic Acid
Mivon Chemicals 28
Chemstar Global Products LLP76
Propofol Maharshee Laboratories Pvt. Ltd. 133
Dye Chem Pvt. Ltd.71
Chemicals71
Solvechem Ltd.21
Chemicals102
Petrochem55
Merchants25
Chemicals82
Propylene Glycol China Propylene Glycol (Pg) I.P / Ffg / Usp
Keshav Hichem Pvt. Ltd. 21
Propylene Glycol (Technical / Usp) H K Enterprise151
Propylene Glycol / Glycerin
Dev International158
Propylene Glycol Tech / Food Grade Meru Chem Pvt. Ltd.105
Propylene Glycol Usp Mivon
/ Ep
Organics Limited91
Propyl Paraben
Chemicals76
Raj Chem84 Dev International158
Petrochem55 Protease
Chemipharma35 Protein Hydrolysate
Pharma76 Espee Pharma Chem Pvt. Ltd.94
Protin Liq. / Powder
(20% / 30% /60%)
Ltd.165
Purified Talc IP/BP/USP
K Enterprise151
Gangotri Inorganic (P) Ltd.18
PVA 173
Misrimal Pukhraj122
PVPK-30
Global Merchants25
Regent Chemicals 41
Pyrantel Pamoate
NDC Drug & Chemical Co.Pvt.Ltd. 154
Pyrantel Embonate / Pamoate
Dazzle Corporation88
Pyrazinamide Vinworld Healthcare P. Ltd147
Pyruvic Acid Indian Platinum Pvt. Ltd.158
Pyridine Mivon Chemicals 28
Krishna Solvechem Ltd.21
Meru Chem Pvt. Ltd.105
Pyridine Hydro Bromide (PHBR)
Krishna Solvechem Ltd.21
Pyridine Hydrofluoride
Regal Remedies Limited36
Pyridostigmine Bromide
Panchsheel Organics Limited91
Pyridoxal - 5 - Phosphate (Nutri P5p)
International Drug & Chemical Co.165
Pyridoxine Hydrochloride
Unitrade Agencies70
Pyrogallol
Croma Chemical Corporation106
Pyronin G (Y)
Oxford Laboratory Chemicals141
Pyronin B
Oxford Laboratory Chemicals141
Quercetin
North India Pharma92
Raivat Impex Pvt. Ltd.59
Quercetine 103%
CSV Pharmaceuticals India Pvt. Ltd.169
Quitiapine Fumerate
Vinworld Healthcare P. Ltd147
Aara Pharma150
Quetiapine Fumarate Ip
Aril Pharmaceuticals6/7
Quetiapine Fumarate
Dazzle Corporation88
Quetiapine
Maharshee Laboratories Pvt. Ltd. 133
Quetiapine Fumarate
210 THE MAZADA PHARMA GUIDE
Krishna
Kems
Kronox
Jay
Labh
Khushbu
Nisha
Krishna
Amita
Maruti
Global
Relic
Propyl Amines-Mono And Di Propyl Amines
Solvechem Ltd.21 Propyl Gallate
Raw Pharma93
Lab Sciences Limited218 Propylene Carbonate
Chem Marketing128 Propylene Glycol Alginate
Ingredients152 Propylene Glycol
Paresh Chemical Corporation 78
Regent
Maruti
Propylene
Nisha
Propyl Gallate Nova
Dev
Chemicals 28
Chemicals 41
Petrochem55
Glycol Technical
Chemicals71
Chemiie 24
International158 Propyl Gallate Bp
Siddhivinayak Pharma160 Propylthiouracil Panchsheel
Crystal
Suprim
Shree
Maruti
Asiel
Siddhivinayak
Protin Liquid
Kems Raw
Propiophenone Shamrock Pharmachem38 Providone Iodine Shree Raj Chem84 Prucalopride Succinate Sheetal Chem 101 PseudoEphedrine HCL Neha
Chemical
Hritik
PTMEG
Paresh
78 Pure
H
Pharma160
Pharma93
Pharma Pvt.
Psychostimulant
Matrix166 Psyllium Husk U.S.P.
Chemicals Pvt. Ltd.99
1000/2000
Chemical Corporation
Lauryl Alcohol – C 12
PRODUCTS INDEX
Calyx Chemical & Pharmaceuticals Ltd.23
Quick Lime
SDA Product17
Quinine Di Hcl
Vinworld Healthcare P. Ltd147
Quinine Di-HCl BP
Malay Enterprise167
Quinine HCl BP
Malay Enterprise167
Quinine Hydrocholoride
DM Pharma22
Quinine Salts
Nova Chemiie 24
Quinine Sulphate
DM Pharma22
Quinine Sulphate USP
Malay Enterprise167
Quinoline Yellow Lake
Standardcon Pvt. Ltd.150
Quetiapine Fumrate
NDC Drug & Chemical Co.Pvt.Ltd. 154
Quetiapine Fumarate Ip
Shriya Pharma & Surgical42
Quetiapine Fumarate
Calyx Chemical & Pharmaceuticals Ltd.23
Quitiapine Vildagliptin
Vinworld Healthcare P. Ltd147
R-(+)-N-Benzyl-1-Phenylethamine
Asiel Chemipharma35
Rabeprazole 20 Mg Ec + Domeperidone
30 Mg Sr
Kahan Pharmaceuticals 08
Rabeprazole 20 Mg Ec + Levosulpride
91 Mg Sr
Kahan Pharmaceuticals 08
R-3-Carbamoylmethyl-5-Methylhexanoic Acid (Rcmh)
Rolence Pharma & Chemicals
127
Rabeprazole Pellets
Western Pharma105
Panchsheel Organics Limited91
Rabeprazole Sodium Sheetal Chem 101
Dazzle Corporation88
Rabeprazole Sodium Ip
Aril Pharmaceuticals6/7
Kahan Pharmaceuticals 08
Rabeprazole Sodium IP Pellets
Sheetal Chem101
Rabeprazole Sodium (EC) & Domperidone (SR) Pellets
Sheetal Chem101
Racecadotril
Aril Pharmaceuticals6/7
Ractopamine Hcl
DM Pharma22
NGL Fine - Chem Limited105
Rafoxanide Bp Vet Crystal Pharma76
Raloxifene Hcl
Nova Chemiie 24
Ramipril
Balaji Corporation89
Ramipril
Aril Pharmaceuticals6/7
Ramipril IP/BP
Aril Pharmaceuticals6/7
Ranitidine
Vinworld Healthcare P. Ltd147
Ranitidine HCL (IP/ DC grade)
Vinworld Healthcare P. Ltd147
Raney Nickel
Indian Platinum Pvt. Ltd.158
Raney Nickel Catalyst
Omkar Lab155
Ranolazine
Shriya Pharma & Surgical42
Rapeseed Meal
SDA Product17
Rapeseed Wax
Flora Dye Chem 126
Reactors
Emco Engineering Pvt. Ltd.161
Red Food Colour
Indian Platinum Pvt. Ltd.158
Refined Glycerine
Keshav Hichem Pvt. Ltd. 21
Refined Bentonites
Suraiya Private Ltd.93
Refind Linseed Oil
Hiten Pharma Chem152
Refined Rice Bran Wax (DR Wax)
Flora Dye Chem 126
Refining And Reprocessing Catalyst
Omkar Lab155
Refrigerator
Avi Scientific (India)168
Resazurin Sodium Salt
Oxford Laboratory Chemicals141
Residue Wax
Flora Dye Chem 126
Resist Salt
Misrimal Pukhraj122
Resist Salt (30%)
Resist Salt (50%)
Resist Salt (80%)
Resist Salt (103%)
Riddhi Siddhi Dye Chem 137
Resins & Adhesives
Bombay Test House Private Limited93
Resorcinol
Zuhhad International 86
Sheetal Chem101
Resorcinol Powder
Indian Platinum Pvt. Ltd.158
Resveratrol Extract
North India Pharma92
Resveratrol
Raivat Impex Pvt. Ltd.59
Rheovis – HEUR PU Thickener for Paint Industry
Kip Chemicals Pvt. Ltd.81
Rhodium Metal
Omkar Lab155
Rhodium On Carbon Omkar Lab155
Rhodium Powder
Indian Platinum Pvt. Ltd.158
Rhodium Salts & Compound
Omkar Lab155
Riboflavin 5 Phosphate Sodium IP
Malay Enterprise167
Riboflavin Sodium Phosphate
NDC Drug & Chemical Co.Pvt.Ltd. 154
Riboflavin Sodium Phosphate Ip
Hap Enterprise67
Rice Bran
SDA Product17
Rice Bran Oil
SDA Product17
Rice Bran Wax
Flora Dye Chem 126
Arjun Beeswax Industries169
Rice Ddgs
SDA Product17
Rice Flour
SDA Product17
Rice Gluten
SDA Product17
Rice Wax
Flora Dye Chem
Ricobendazole
Reenold Enterprises137 NGL Fine - Chem Limited105
Kahan Pharmaceuticals
Rifabutin BP/EP/USP Vinworld Healthcare P. Ltd147 Ring Hydrogenation
Risedronate Sodium / Acid
Pharma150
Calcium
Corporation88
Rosuvastatin Calcium Ip
Shriya Pharma & Surgical42
Rosuvastatin Calcium IP/BP
Hritik Chemicals Pvt. Ltd.99
Rosuvastatin Calcium IP/BP/USP
Aril Pharmaceuticals6/7
Rotary Double Cone Vacuum Dryer
Emco Engineering Pvt. Ltd.161
Rotary Evaporators,TLC Kits etc
Co.
Rotational Viscometer ViscoQC 103
Khushboo Scientific13
Rotational Viscometer ViscoQC 300
Khushboo Scientific13
Rotational Viscometer with Heli-Plus
Khushboo Scientific13
Roxithromycin IP/BP
Hritik Chemicals Pvt. Ltd.99
Roxithromycin
Unimax Group
Rumit Group Of Companies78
Roxithromycin IP/BP/USP
Nova Chemiie
Roxarsone
Reenold Enterprises137
Rubber & Rubber Products
Bombay Test House Private Limited93
Rubidium Chloride 99.99%
Croma Chemical Corporation106
Ruthenium 0.5% on Alumina
Indian Platinum Pvt. Ltd.158
Ruthenium Chloride
Indian Platinum Pvt. Ltd.158
Ruthenium On Alumina
Indian Platinum Pvt. Ltd.158
Ruthenium on Carbon
Indian Platinum Pvt. Ltd.158
Ruthenium Powder
Indian Platinum Pvt. Ltd.158
Ruthenium Salt
Indian Platinum Pvt. Ltd.158
Ruthenium Salts & Compound
Omkar Lab155
Ruthenium Trichloride
Indian Platinum Pvt. Ltd.158
Rutin
Panchsheel Organics Limited91
Rutin Nf 11
Shree Raj Chem84
Rutoside Trihydrate
Jakson Pharma104
Rutoside
Raivat Impex Pvt. Ltd.59
Rutoside Trihydrate 103%
North India Pharma92
International drug & chemical co.165
Rxcipients® FM 1000
Kanchan Rasayan 34
S-Adenosyl Methionine (SAMe) Chemkart163
S-Amlodipine
Hap Enterprise67
NDC Drug & Chemical Co.Pvt.Ltd. 154
S-Amlodipine Base [Levamlodipine Base]
Prudence Pharma Chem Ear Panel / 81
S- Amlodipine Besylate [Levamlodipine Besylate]
Prudence Pharma Chem Ear Panel / 81
S-Amlodipine Besylate Ip Kahan Pharmaceuticals 08
S-Amlodipine Besylate Inh
Aril Pharmaceuticals6/7
S.L.S Powder
Shree Raj Chem84
S.S.G
Siddhivinayak Pharma160
Sdic - 60% (Granular & Tablet)
Keshav Hichem Pvt. Ltd. 21
Saccharomyces Boulardii _ 40B Cfu/g 90 Elementos Pvt. Ltd. 104
Safflower Oil Krishna Solvechem Ltd.21
Saffron Aditi Essentials51
Safinamide Maharshee Laboratories Pvt. Ltd. 133
Salbutamol Sulphate
NDC Drug & Chemical Co.Pvt.Ltd. 154
Shriya Pharma & Surgical42
Orex Pharma Pvt. Ltd.25
Salicyaldehyde >106% / 99.5%
Chemizo Enterprise166
Salbutamol Sulphate Ip/Bp
Shriya Pharma & Surgical42
Salbutamol Sulphate IP/BP/EP
Kahan Pharmaceuticals 08 Salicylaldehyde Sheetal Chem101
Maruti Petrochem55
Salicylic Acid
Kronox Lab Sciences Limited218
Salicylic Acid Ip
Hiten Pharma Chem152
Salinomycin 12% (Fg)
Crystal Pharma76
Salicyaldehyde >106% / 99.5%
Chemizo Enterprise166
Salicylamide Rare Pharma Pvt. Ltd.148
Salbutamol Intermediate Pacific Biochem Private Limited82
Salmeterol Xinafoate – EP
Progress Life Sciences Pvt. Ltd.29
Salt (Sodium Chloride) SDA Product17
SAMe DM Pharma22
Sandalwood Hard Resin (Ethanol Based)
Aditi Essentials51
Sandalwood Oi (Indian , African Australian)
Aditi Essentials51
Sandalwood Powder (De-Oiled)
Aditi Essentials51
Sandalwood Powder (Pure)
Aditi Essentials51
Saponin
Oxford Laboratory Chemicals141
Sartaconazole
Balaji Corporation89
Sarpograelate HCL
Calyx Chemical & Pharmaceuticals Ltd.23
Saw Palmetto Oil
Global Merchants25
Kamakhya ImpexFlap
Scalewin
Dev International158
Scouring Agents
Krishna Antioxidants Pvt. Ltd.87
Scrubber
Plastic Fabricators59
Seamin 103 –Pyrolysis Oil Decoloring
Shreedhar Enterprise155
Sebacic Acid
Maruti Petrochem55
Secnidazole
Nova Chemiie 24
Secondary Butyl Bromide
Pacific Biochem Private Limited82
Sea Buckthorn Oil
Kamakhya ImpexFlap
Selegiline HCL
Neha Pharma Pvt. Ltd.165
Selenium Dioxide
Gautam Pharma Chem84
Selenium Amino Acid Chelate
Eklavya Biotech Pvt. Ltd.103
Sedative, Hypnotic
Calyx Chemical & Pharmaceuticals Ltd.23
Selenous Acid
Balaji Corporation89
Self Emulsifying Wax Base W/O
Flora Dye Chem 126
Sell & Purchase Of Surplus Chemicals And Pharma Intermediates
Surplus Trade Solutions Pvt. Ltd.80
Sensuous Inds. Gloves
Hetal International30
Stearyl Trimethyl Ammonium Chloride
Yuvi Chemz148
Serratiopeptidase
Asiel Chemipharma35
Kahan Pharmaceuticals 08
Serratiopeptidase (Ec) Aril Pharmaceuticals6/7
Jakson Pharma104
Semi-Micro
Khushboo Scientific13
Serratiopeptidise Entric Coated
Balaji Corporation89
Serratiopeptidase Gran Ip
Aril Pharmaceuticals6/7
Serratiopeptidase Plain/Coated
Nova Chemiie 24
Serratiopeptidase Plain / Granules
International Drug & Chemical Co.165
Serratiopeptidase Plain Powder
Jakson Pharma104
Sertaconazole Nitrate
NDC Drug & Chemical Co.Pvt.Ltd. 154
Setraline Bp/Ep/Usp
DM Pharma22
Sertralin Hcl Ip
Aril Pharmaceuticals6/7
Stearic Acid - IP / BP / USP / EP
Arjun Beeswax Industries169
Sevelamer Carbonate
DM Pharma22
Sevelamer Carbonate / Hydrochloride
Panchsheel Organics Limited91
Sevelamer Hcl
THE MAZADA PHARMA GUIDE 211
126
08
54
Nova Chemiie 24 Risperidone Ep/Bp Aril Pharmaceuticals6/7 Nova Chemiie 24 Ritalinic Acid Maruti Industries24 Rivaroxaban Maruti
Chemino
Krishna
Aara
Rosemary
Global
Rosehip
Kamakhya
Rosuvastatin
DM Pharma22 Rosuvastatin
Tivan Sciences Pvt. Ltd.40 Rosuvastatin Maharshee Laboratories Pvt. Ltd. 133 Rosuvastatin Calcium Nova Chemiie 24 Vinworld Healthcare P. Ltd147 NDC Drug & Chemical Co.Pvt.Ltd. 154
Amarjyot Chemical Limited
Industries24
Pharma Ltd94 Rizoflavin/ B2 5 Phosphate Dev International158 Rop Enhancers
Antioxidants Pvt. Ltd.87 Rosavastatin Calcium Panchsheel Organics Limited91
Oil
Merchants25
Oil
ImpexFlap
Ip/Ep
Dazzle
B.J.
162
Scientific
20
24
PRODUCTS INDEX
DM Pharma22
Shale Inhibitors
Krishna Antioxidants Pvt. Ltd.87
Shea Butter (Refined)
Aditi Essentials51
Shea Butter - IHS
Arjun Beeswax Industries169
Stearyl Alcohol - IP / BP / USP / EP
Arjun Beeswax Industries169
Sunflower Wax - IHS
Arjun Beeswax Industries169
Shellac Bleached Powder
Gautam Pharma Chem84
Shellac Wax
Flora Dye Chem 126
Shrimp Head Powder
SDA Product17
Shrimp Meal Powder
SDA Product17
Sildenafil Citrate
Panchsheel Organics Limited91
Vinworld Healthcare P. Ltd147
Hap Enterprise67
NDC Drug & Chemical Co.Pvt.Ltd. 154
Sitagliptin Granules 25.30%
YSK Laboratories Pvt. Ltd.56
Sildenafil Citrate Granules 25%
YSK Laboratories Pvt. Ltd.56
Sildenafil Citrate IP/BP/USP
Kahan Pharmaceuticals 08
Sildenafil Ip
Sheetal Chem 101
Silicone Quaternium-22 Conditioning Agent
Kip Chemicals Pvt. Ltd.81
Silicone Quaternium-22 -Premium Conditioning Agent
Kip Chemicals Pvt. Ltd.81
Silicone Wax
Flora Dye Chem 126
Silyl Ester
Unimax Group 20
Senna Extract
CSV Pharmaceuticals India Pvt. Ltd.169
Shea Butter Refined
CSV Pharmaceuticals India Pvt. Ltd.169
Shilajit Extract
CSV Pharmaceuticals India Pvt. Ltd.169
Spearmint Oil
CSV Pharmaceuticals India Pvt. Ltd.169
Silodosin
Panchsheel Organics Limited91
Balaji Corporation89
Sheetal Chem 101
Prudence Pharma Chem Ear Panel / 81
Dazzle Corporation88
Sitagliptin
Dazzle Corporation88
Silodocin In-H
Kahan Pharmaceuticals 08
Silver Chloride
Indian Platinum Pvt. Ltd.158
Silver Chromate
Indian Platinum Pvt. Ltd.158
Silver Diethyl Dithiocarbamate
Oxford Laboratory Chemicals141
Silver Iodate
Indian Platinum Pvt. Ltd.158
Silver Iodide
Indian Platinum Pvt. Ltd.158
SVG Pharma Lifesciences Pvt. Ltd.145
Silver Lactate
Indian Platinum Pvt. Ltd.158
Silver Metal Powder
Indian Platinum Pvt. Ltd.158
S-Methoprene
NGL Fine - Chem Limited105
Silver Metal Salts
Oxford Laboratory Chemicals141
Silver Nanoparticles
Indian Platinum Pvt. Ltd.158
Silver Nitrate AR / LR
Indian Platinum Pvt. Ltd.158
Oxford Laboratory Chemicals141
Silver Nitrate / Oxide / Bromide / Sulphate
HK Group76
Silver Nitrate Crystal
Indian Platinum Pvt. Ltd.158
Silver Nitrite
Indian Platinum Pvt. Ltd.158
Silver Oxide
Indian Platinum Pvt. Ltd.158
Silver Sufadiazine
Indian Platinum Pvt. Ltd.158
Silver Sulfate
Indian Platinum Pvt. Ltd.158
Silver Sulfadiazine
Nova Chemiie 24
DM Pharma22
Silver Sulphadiazine
Kems Raw Pharma93
Silver Sulphadazine USP
Vinworld Healthcare P. Ltd147
Silver Sulphate
Indian Platinum Pvt. Ltd.158
Silver Sulphate Lr/Ar
Oxford Laboratory Chemicals141
Silver Triflate
Indian Platinum Pvt. Ltd.158
Silver Trifluroacetic Acid
Indian Platinum Pvt. Ltd.158
Silymarine North India Pharma92
Silymarin (Milk Thistle)
Raivat Impex Pvt. Ltd.59
Silymarin UV 80% Chemkart163
Simithicon
Siddhivinayak Pharma160
Simethicon 103%
Kems Raw Pharma93
Simethicone 30 %/ 103 %
Hritik Chemicals Pvt. Ltd.99
Simethicone 103% IP/USP
Topnotch Chemicals Pvt. Ltd.23
Simethicone 30% EMULSION USP Topnotch Chemicals Pvt. Ltd.23
Simethicon Emulsion 30%
Raw Pharma93
USP, Dimithicone IP.SP
Laborates Pvt. Ltd.103
–INH
Phosphate
Corporation80
Pukhraj122 H K Enterprise151 Maruti Petrochem55
Sodium Starch Glycollate IP/BP/USP (Maize, Potato)
J R Drugchem Pvt. Ltd.Back Inside Cover
Sodium Acetate
Eklavya Biotech Pvt. Ltd.103
Sodium Alginate (ALGYSOTM)
Labh Ingredients152
Sodium CMC
Labh Ingredients152
Sodium Starch Glycollate
Labh Ingredients152
Sodium Acetate Anhydrous
Advance in Organics LLP128
Sodium Acid Pyro Phosphate
Advance in Organics LLP128
Sodium Chloride
Vinipul Chemicals Pvt. Ltd.31
Sodium Chloride IP [ORS / Injectable]
Arco Pharma126/164
Sodium Hexameta Phosphate 76%
Vinipul Chemicals Pvt. Ltd.31
Sodium Hyaluronate
Raivat Impex Pvt. Ltd.59
Sodium Hydrogen Ortho Phosphate
Advance in Organics LLP128
Sodium Oxalate
Vinipul Chemicals Pvt. Ltd.31
Sodium Tripholyphosphate
Pari Chemicals136
Sodium Thio Sulphate
Vinipul Chemicals Pvt. Ltd.31
Sodium Stearyl Fumarate Ih/Bp/Usp
Pramukh Pharmachem Pvt. Ltd.80
Sodium Butyrate
Eklavya Biotech Pvt. Ltd.103
Sodium Propionate
Eklavya Biotech Pvt. Ltd.103
Sorbitan Mono Laurate Ethoxylate
Shree Vallabh Chemical48
Sorbitan Mono Stearate Ethoxylate
Shree Vallabh Chemical48
Sorbitan Mono Oleate Ethoxylate
Shree Vallabh Chemical48
Sorbitan Tri Oleate Ethoxylate
Shree Vallabh Chemical48
Soda Ash (Bag)
Khushbu Dye Chem Pvt. Ltd.71
Sodium Acetate
Riddhi Siddhi Dye Chem137
Vinipul Chemicals Pvt. Ltd.31
Sodium Acetate Anhydrous
Kronox Lab Sciences Limited218
Sodium Acetate Trihydrate
Kronox Lab Sciences Limited218
Riddhi Siddhi Dye Chem 137
Sodium Acetate Anhydrous / Ceystals
Ashapura Intermediates 119
Sodium Acetate / Benzoate / Citrate
Meru Chem Pvt. Ltd.105
Sodium Acid Phosphate
Siddhivinayak Pharma160
Kronox Lab Sciences Limited218
Sodium Acid Pyrophosphate
Pari Chemicals136
Sodium Acid Phosphate Dihydrate
Kronox Lab Sciences Limited218
Sodium Acid Pyro Phosphate
Krishna Solvechem Ltd.21
Sodium Alginate
Misrimal Pukhraj122
Sodium Alginate IP / BP/ USP / EP
Amit Hydrocolloids53
Sodium Arsenate Lr/Ar
Oxford Laboratory Chemicals141
Sodium Arsenite Lr/Ar
Oxford Laboratory Chemicals141
Sodium Ascorbate
Kronox Lab Sciences Limited218
Sodium Ascorbate IP / BP
Rosetta Life Care Private Limited14
Sodium Aluminium Phosphate
Advance in Organics LLP128
Pari Chemicals136
Sodium Azide S.A.I. Products132
Sodium Benzene Sulfonate
Stratechem (I) Pvt. Ltd. 88
Sodium Benzoate
Shree Raj Chem84
Siddhivinayak Pharma160
Crystal Pharma76
Mivon Chemicals 28
Krishna Solvechem Ltd.21
Keshariya Corporation80 Dev International158
Kronox Lab Sciences Limited218
Sodium Benzoate 99%
Ketan Chemical Corporation119
Sodium Benzoate Powder Jay Chem Marketing128
Sodium Bi Carbonate
Keshariya Corporation80
SDA Product17
Misrimal Pukhraj122 Paras Chem (India)166
Sodium Bi Carbonate IP / BP
Pharma126/164
Sodium Biocarbonate Ip
Pharma Chem Products150
/
Sodium Borohydride Mivon Chemicals 28
Sodium BoroHydride (Powder/Granular) Jay Chem Marketing128
Sodium BoroHydride Powder Nisha Chemicals71 Maruti Petrochem55 Asiel Chemipharma35
Sodium Bromate Mody Chemi Pharma Pvt.
Biochem Private Limited82
Caprylate
Lab Sciences Limited218
Sodium Carbonate Kronox Lab Sciences Limited218
Sodium Carbonate Anhydrous Qualikems Lifesciences Pvt. Ltd.139 Kronox Lab Sciences Limited218
Sodium Carbonate Monohydrate
Qualikems Lifesciences Pvt. Ltd.139 Kronox Lab Sciences Limited218
Sodium Carboxymethyl Cellulose IP / BP / USP / EP Amit Hydrocolloids53
Sodium Carboxymethyl Cellulose (Cmc) Keshav Hichem Pvt. Ltd. 21
Sodium Chloride Pravina Pharma Chem Products150
Misrimal Pukhraj122
Kronox Lab Sciences Limited218
Sodium Chloride Ip/bp/usp
Elite Chemicals89
Sodium Meta-Bi-Sulphite
Yuvi Chemz148
Sodium Sulphite Extra Pure Yuvi Chemz148
Sodium Sulphite Pari Chemicals136
Sodium Chlorate Group Dev International158
Sodium Citrate
Siddhivinayak Pharma160
Mivon Chemicals 28
Jay Chem Marketing128
DM Pharma22
Sodium Cmc All Grade Dev International158
Sodium CMC (Pharma & Technical)
Ashwini Industries148
Sodium Citrate / benzoate / citric Acid
Siddhivinayak Pharma160
Sodium Citrate Anhydrous
Advance in Organics LLP128
Navnidh Pharma lab84
Sodium Citrate IP / BP [Dihydrate / Anhydrous] Arco Pharma126/164
Sodium Citrate Tribasic Kronox Lab Sciences Limited218
Sodium Citrate Ip / Usp / Bpbronopol
Keshav Hichem Pvt. Ltd. 21
Sodium Cobaltinitrite
Qualikems Lifesciences Pvt. Ltd.139
Sodium Cromoglicate Ip Aril Pharmaceuticals6/7
Sodium Cyanide Dev International158
Sodium Cyanide Group Dev International158
Sodium Cyanate
Amita Chemicals102
Sodium Dihydrogen Phosphate
Pari Chemicals136
Sodium Di Acetate
212 THE MAZADA PHARMA GUIDE
Arnish
Sirolimus Balaji
Sitagliptin
Progress
Sitagliptin
Balaji Corporation89 Kahan Pharmaceuticals 08 Sitagliptin Phosphate IP/ BP Hritik Chemicals Pvt. Ltd.91 Sizing Agents Krishna Antioxidants Pvt. Ltd.87 SLES 78% H K Enterprise151 SLES Liquid Kanchan Rasayan 34 SLES Paste Kanchan Rasayan 34 SLS Liquid Kanchan Rasayan 34 SLS Needle Kanchan Rasayan 34 SLS Paste Kanchan Rasayan 34 SLS Powder Kanchan Rasayan 34 Slack Wax Flora Dye Chem 126 Sls Powder Mivon Chemicals 28 Sludge Breakers Krishna Antioxidants Pvt. Ltd.87 Sport Nutrition Products international drug & chemical co.165 SMBS Khushbu Dye Chem Pvt. Ltd.71 SMX / TMP Hap Enterprise67 NDC Drug & Chemical Co.Pvt.Ltd. 154 Sulisobenzone USP (BP-4) Maharshee Laboratories Pvt. Ltd. 133 Soap
H K Enterprise151 Soaps, Detergents
Toiletries Bombay Test House Private Limited93 Solid Fuels & Petroleum Products Bombay Test House Private Limited93 Soapnut Extract Liquid Aditi Essentials51 Soapnut
Aditi Essentials51 Soda Ash Paras Chem (India)166 Mivon Chemicals 28 Malay
Keshariya
Kems
Simethicone
Corporation89
Life Sciences Pvt. Ltd.29
Noodles
&
Extract Powder
Enterprise167
Misrimal
Arco
Pravina
Indian
Sodium
Qualikems
Sodium
Ashapura
Kronox
Sodium Benzoate I.P. (Bp/Usp/Ep/Food Grade) Gbl Chemical Limited 73 Sodium Bicarbonate IP
BP Vinworld Healthcare P. Ltd147 Sodium Bismuthate
Platinum Pvt. Ltd.158
Bisulphate
Lifesciences Pvt. Ltd.139
Bisulphite
Intermediates 119
Lab Sciences Limited218 Sodium Bisulphite Pari Chemicals136
Ltd. 47 Sodium Bromide Mody Chemi Pharma Pvt. Ltd.
Krishna Solvechem
Qualikems Lifesciences
Sodium
Powder Pacific
Sodium
Pacific
47
Ltd.21
Pvt. Ltd.139
Bromide
Biochem Private Limited82
Bromide Solution
Sodium
Kronox
PRODUCTS INDEX
Advance in Organics LLP128
Sodium Dihyrogen Orthophosphate
Qualikems Lifesciences Pvt. Ltd.139
Sodium Ferededate
North India Pharma92
international drug & chemical co.165
Sodium Ferrocyanide
Dev International158
Sodium Fluoride
Qualikems Lifesciences Pvt. Ltd.139
Sodium Formate
Nisha Chemicals71
Ashapura Intermediates 119
Sodium Fusidate
NDC Drug & Chemical Co.Pvt.Ltd. 154
Sodium Gluconate
Krishna Solvechem Ltd.21
H K Enterprise151
Dev International158
Kronox Lab Sciences Limited218
Sodium Hexametaphosphate
Pari Chemicals136
Sod Selenite Inositol
U.K. Vet Chem65
Sodium Hexa Meta Phosphate (SHMP)
Krishna Solvechem Ltd.21
Sodium Hexa Meta Phosphate (Tech)
Riddhi Siddhi Dye Chem137
Sodium Humate
SDA Product17
Sodium Hyaluronate (Hyaluronic Acid)
North India Pharma92
Balaji Corporation89
Sodium Hydrogen Sulphate
Dev International158
Sodium Hydroxide Pallets
Siddhivinayak Pharma160
Qualikems Lifesciences Pvt. Ltd.139
Kronox Lab Sciences Limited218
Sodium Hypochloride
Keshariya Corporation 80
Sodium Hexametaphosphate
Pari Chemicals136
Sodium Iodate
SVG Pharma Lifesciences Pvt. Ltd.145
Sodium Iodide
SVG Pharma Lifesciences Pvt. Ltd.145
HK Group76
Sodium Lactate
Nisha Chemicals71
Sodium Lactate 60%
Vinworld Healthcare P. Ltd147
Sodium Lactate USP 60% Solution
Neha Pharma Pvt. Ltd.165
Sodium Lactate USP [Pyrogen Free]
Arco Pharma126/164
Sodium Lauryl Sulphate
Regent Chemicals 41
Arnish Laborates Pvt. Ltd.103
Kronox Lab Sciences Limited218
Sodium Lauryl Ethoxy Sulphate
Arnish Laborates Pvt. Ltd.103
Sodium Lauryl Sulphate - IP / BP / USP / EP
Arjun Beeswax Industries169
Sodium Meta Bi Sulphide
Keshariya Corporation80
Sodium Metabisulphite
Pari Chemicals136
Sodium Meta Bi Sulphite
Krishna Solvechem Ltd.21
Paras Chem (India)166
Kronox Lab Sciences Limited218
Sodium Meta Par Iodate
SVG Pharma Lifesciences Pvt. Ltd.145
Sodium Methoxide Powder
Nilesh Enterprises82
Sodium Methoxide Solution 30 %
Nilesh Enterprises82
Sodium Methyl Paraben
Dev International 158
Sodium Metasilicate (5h20/9h20)
Riddhi Siddhi Dye Chem137
Sodium Meta Bi Sulphite
Riddhi Siddhi Dye Chem137
Sodium Molybdate
Indian Platinum Pvt. Ltd.158
Qualikems Lifesciences Pvt. Ltd.139
Kronox Lab Sciences Limited218
HK Group76
Sodium Mono Fluoro Phosphate
Kronox Lab Sciences Limited218
Sodium Hexa Meta Phosphate
Advance in Organics LLP128
Sodium Nitrate
Khushbu Dye Chem Pvt. Ltd.71
Krishna Solvechem Ltd.21
Qualikems Lifesciences Pvt. Ltd.139
Kronox Lab Sciences Limited218
Sodium Nitrite
Khushbu Dye Chem Pvt. Ltd.71
Krishna Solvechem Ltd.21
Qualikems Lifesciences Pvt. Ltd.139
Kronox Lab Sciences Limited218
Sodium Hexa Meta Phosphate
Advance in Organics LLP128
Sodium Perborate
SDA Product17
Sodium Percarbonate
SDA Product17
Sodium Percarbonate – Granules / Tablets
Ashapura Intermediates 119
Sodium Phosphate Dibasic Anhydrous
Kronox Lab Sciences Limited218
Sodium Phosphate Dibasic Dihydrate
Kronox Lab Sciences Limited218
Sodium Phosphate Dibasic Dodecahydrate
Kronox Lab Sciences Limited218
Sodium Phosphate Dibasic Heptahydrate
Kronox Lab Sciences Limited218
Sodium Phosphate Dibasic Monohydrate
Kronox Lab Sciences Limited218
Sodium Phosphate Monobasic Anhydrous
Kronox Lab Sciences Limited218
Sodium Phosphate Monobasic Dihydrate
Kronox Lab Sciences Limited218
Sodium Phosphate Monobasic Monohydrate
Kronox Lab Sciences Limited218
Sodium Phosphate Tribasic Dodecahydrate
Kronox Lab Sciences Limited218
Sodium Phosphate Tribasicanhydrous
Kronox Lab Sciences Limited218
Sodium Pico Sulphate
Synthetic Molecules71
Sodium Picosulphate I.H.S.
Kahan Pharmaceuticals 08
Sodium Polyacrylate
Dev International158
Sodium Propionate
Meru Chem Pvt. Ltd.105
Kronox Lab Sciences Limited218
Sodium Propyl Paraben
Dev International158
Sodium Pyruvate
Indian Platinum Pvt. Ltd.158
Sodium salicylate
Rare Pharma Pvt. Ltd.148
Sodium Saccharine
Siddhivinayak Pharma160 international drug & chemical co.165
Sodium Sesqui Citrate
Navnidh Pharma Lab84
Sodium Selenate
Gautam Pharma Chem84
Sodium Selenite Pentahydrate
Kronox Lab Sciences Limited218
Sodium Silicate
Misrimal Pukhraj122
Sodium Silico Fluoride
Ashapura Intermediates 119
Sodium Starch Glycolate
Western Pharma105
Keshariya Corporation80
Sodium Starch Glycolate (Potato Based / Corn Base)
Amit Hydrocolloids53
Sodium Sulphate - DEEPAK, UPL, INDOFIL, RUBAMIN
Ashapura Intermediates119
Sodium Starch Glycollate IP/BP/USP international drug & chemical co.165
Hiten Pharma Chem152
Sodium Sterile
Espee Pharma Chem Pvt. Ltd.94
Sodium Succinate Anhydrous
Kronox Lab Sciences Limited218
Sodium Sulphate
Ashapura Intermediates 119
Qualikems Lifesciences Pvt. Ltd.139
Kronox Lab Sciences Limited218
Sodium Sulphate – 105% & 93%
Ashapura Intermediates 119
Sodium Sulphate Anhydrous
Keshariya Corporation80
Misrimal Pukhraj122
Sodium Sulphate Flakes
Keshariya Corporation80
Sodium Sulphide
Misrimal Pukhraj122
Sodium Sulphide Yellow Flakes
Krishna Solvechem Ltd.21
Sodium Sulphite
Krishna Solvechem Ltd.21
Kronox Lab Sciences Limited218
Sodium Tartrate
Kronox Lab Sciences Limited218
Sodium Thiocyanate
Krishna Solvechem Ltd.21
Sodium Thiosulphate
Ashapura Intermediates 119
Meru Chem Pvt. Ltd.105
Sodium thioglycolate(40%)
Synchrom Laboratory Pvt Ltd146
Sodium Thiosulphate Anhydrous
Qualikems Lifesciences Pvt. Ltd.139
Kronox Lab Sciences Limited218
Sodium Thiosulphate Pentahydrate
Kronox Lab Sciences Limited218
Sodium Toluenesulfonate (Sts)
Ketan Chemical Corporation119
Sodium Tri Poly Phosphate
Krishna Solvechem Ltd.21
Sodium Thiosulphate (Atulmake)
Riddhi Siddhi Dye Chem137
Sodium Thiosulphate (P) Crystal
Riddhi Siddhi Dye Chem137
Sodium Tungstate
Krishna Solvechem Ltd.21
Indian Platinum Pvt. Ltd.158
HK Group76
Sodium Sulphide Flakes (Yellow)
Riddhi Siddhi Dye Chem 137
Sodium Valporate
Siddhivinayak Pharma160
Luconic Chemicals103
Mirambika Pigment 55
Nova Chemiie 24
Sodium Valproate IP/ BP/ USP
Hritik Chemicals Pvt. Ltd.99
Sodium Valproate and Valproic Acid SR Granules 66.70%
YSK Laboratories Pvt. Ltd.56
Sodium Thiosulphate - ATUL Make
Ashapura Intermediates119
Sodium Percarbonate - Granules / Tablets
Ashapura Intermediates119
Sodium Silico Fluoride
Ashapura Intermediates119
Sodium Meta Bisulphite - China Make
Ashapura Intermediates119
Sodium Bisulphite
Ashapura Intermediates119
Sodium Sulphite - 105% & 93%
Ashapura Intermediates119
Sodium Nitrate - Deepak & Local Make
Ashapura Intermediates119
Sodium Nitrite - Deepak
Ashapura Intermediates119
Sol. Selenite Pure
Crystal Pharma76
Soild Liquid Gas Pressure / Vacuum
Filtromix Equipments LLP149
Solvent C-IX
Krishna Solvechem Ltd.21
Solvents & Acid
Powder Pack Chem129
Somaposppin
Balaji Corporation89
SPH [Sulfonamide] of CELECOXIB
Sorbitol Shree Raj Chem84 Siddhivinayak Pharma160 Khushbu Dye Chem Pvt. Ltd.71
THE MAZADA PHARMA GUIDE 213
Prudence Pharma Chem Ear Panel / 81 Sorafenib Tosylate Vinworld Healthcare P. Ltd147 Sorbic Acid Crystal Pharma76 HK Group76 U.K. Vet Chem65 Sorbitol 78% I.P / Usp Keshav Hichem Pvt. Ltd. 21
Keshariya
Gandhi Chemicals 144 Maruti Petrochem55 Sorbitol 78% Kanchan Rasayan 34 Sorbitol 78% BP Kanchan Rasayan 34 Sorbitol 78% IP Kanchan Rasayan 34 Malay Enterprise167 Sorbitol Liquid Meru Chem Pvt. Ltd.105 Sorbitol Liquid & Powder Dev International158 Sorbitol Powder Global
Sorbitol
Liquid IP/BP Hritik
Sorbitol Solution
Shree
Soya
North India
Soya Protein
Advance in Organics
Soy Protein
Chemkart163 Soya
Kems Raw Pharma93 Soya Protin Hydrolysate Powder 60% Kems Raw Pharma93 Soya Protin Hydrolysate Powder 80% Kems Raw Pharma93 Soya Protein Isolate SDA Product93 Soya Protein Powder SDA Product93 Soya Protin Powder Capsulation Grade Kems Raw Pharma93 Soya Fiber Eklavya Biotech Pvt. Ltd.103 Soya High Nitrogen Eklavya Biotech Pvt. Ltd.103 Soya Protein Isolate Eklavya Biotech Pvt. Ltd.103 Soybean Lecithin Krishna Solvechem Ltd.21 Soya Wax - IHS Arjun Beeswax Industries169 Soya Amino 50% & 80% Chemizo Enterprise166 Soybean Oil Krishna Solvechem Ltd.21 Soyabeen Meal SDA Product17 Soyabeen Oil SDA Product17 Sparfloxacin Sheetal Chem 101 Sparkler Filter Pads Sanjay Enterprises143 Specialised Waxes Flora Dye Chem 126 Spectacles Hetal International30 Spent Bromides Above 20% Noble Chemical Agency 102 Spent Hydrobromic Acid Noble Chemical Agency 102 Spent Raney Nickel Noble Chemical Agency 102 Spent Sodium Bromide Noble Chemical Agency 102 Spice Extracts Aditi Essentials51 Spices Grounds Aditi Essentials51 Spiramycin Unitrade Agencies70 Spironolactone Rumit Group Of Companies78 Spirulina Powder North India Pharma92 Stabilized Oxychloro Complex Medisearch Laboratories (Bombay) Pvt.
North India Pharma92 Stabilizing Agents Krishna Antioxidants Pvt. Ltd.87 Stable Bleaching Powder Dev International158 Stains & Indicators Oxford Laboratory Chemicals141 Stannous Chloride Kronox Lab Sciences Limited218 Stanozolol Panchsheel Organics Limited91 Balaji Corporation89 Standard Buffer Solutions B.J. Scientific Co.162 Starch Powder Keshariya Corporation80 Starch Soluble (Potato) Qualikems Lifesciences Pvt. Ltd.139 Steam Jawla Fish Powder SDA Product17 Steam Shrimp Meal Powder SDA Product17 Steam Sterilized Fish Meal SDA Product17 Steareth-2 Kanchan Rasayan 34 Skimmed Milk Powder Eklavya Biotech Pvt. Ltd.103 Steareth-20 Kanchan Rasayan 34 Steareth-21 Kanchan Rasayan 34 Stearic Acid Siddharth International101 Dev International158 Stearic Acid (Regular/Rubber Grade/43-45%/ 65%/90 %) H K Enterprise151 Streptococcus Species 200B Cfu/g
Corporation80
Merchants25
Powder/
Chemicals Pvt. Ltd.99
78% Ip
Chemicals117
Isoflavone
Pharma92
Isolate 90%
LLP128
Isolate 90%
Lecthin Powder /Paste
Ltd.94
PRODUCTS INDEX
90
Stearyl Alcohol – C 18
H K Enterprise151
Stevia Reb A 105-106% Chemkart163
STPP
Khushbu Dye Chem Pvt. Ltd.71
Ashapura Intermediates 119
Strontium Bromide
Qualikems Lifesciences Pvt. Ltd.139
Strontium Carbonate
Qualikems Lifesciences Pvt. Ltd.139
Strontium Chloride
Qualikems Lifesciences Pvt. Ltd.139
Strontium Nitrate
Qualikems Lifesciences Pvt. Ltd.139
Strontium Sulphate
Qualikems Lifesciences Pvt. Ltd.139
Styrene Phosphonic Acid
Rare Pharma Pvt. Ltd.148
Stryl Alcohol Siddhivinayak Pharma 160 Styphnic Acid Indian Platinum Pvt. Ltd.158
Styrenated Phenol (Sp)
Krishna Antioxidants Pvt. Ltd.87
Styrene Monomer
Khushbu Dye Chem Pvt. Ltd.71
H K Enterprise151
Apra Enterprises19
Apra Innovative Pvt Ltd19
Sticker Labeling
Advanced Industrial Micro Systems 25
Succinic Acid
Mody Chemi Pharma Pvt. Ltd. 47
Kronox Lab Sciences Limited218
Succinyl Choline Chloride
Balaji Corporation89
Sucralfate
Unitrade Agencies70
Parshwa Pharma Chem Pvt. Ltd.40 Inventys58
Sucraflate Usp
Progress Life Sciences Pvt. Ltd.29
Hiten Pharma Chem152
Kahan Pharmaceuticals 08
Sucralfate JP / USP
Malay Enterprise167
Sucralose
Jay Chem Marketing128 Chemkart163
Raivat Impex Pvt. Ltd.59
Succinic Acid
Relic Chemicals82
Sucralose USP
Malay Enterprise167
Sucrose IP/ BP/ USP
Hritik Chemicals Pvt. Ltd.99
Sugar Pharma Grade
Kems Raw Pharma93
Sugandmantri Oil
Aditi Essentials51
Sugarcane Wax
Flora Dye Chem 126
Sulbactam Sodium
Espee Pharma Chem Pvt. Ltd.94
Unitrade Agencies70
Sulbactam Sodium Sterile
Balaji Corporation89
Sulfasalazine
NDC Drug & Chemical Co.Pvt.Ltd. 154
Sulfasalazine USP
Vinworld Healthcare P. Ltd147
Hap Enterprise67
Sulfuryl Chloride
Krishna Solvechem Ltd.21
Ashapura Intermediates119
Sulphacetamide Sodium Vinworld Healthcare P. Ltd147
Sulphadiazine
Crystal Pharma76
NDC Drug & Chemical Co.Pvt.Ltd. 154
Sulphadimidine
Crystal Pharma76
Sulphamethoxane
Vinworld Healthcare P. Ltd147
Sulphanilamide
Croma Chemical Corporation106
Sulpholane
Krishna Solvechem Ltd.21
Sulphonic Acid
Khushbu Dye Chem Pvt. Ltd.71
Sulphur Dioxide
Krishna Solvechem Ltd.21
Sulfamethoxazole
Reenold Enterprises137
Sulphur Powder
Kems Raw Pharma93
Meru Chem Pvt. Ltd.105
Sulphuric Acid
Meru Chem Pvt. Ltd.105
Sultamycillin Tosylate
Shriya Pharma & Surgical42
Sumac Wax
Flora Dye Chem 126
Sumatriptan I.H.S.
Kahan Pharmaceuticals 08
Sumatryptylline
Luconic Chemicals103
Sun Dry Fish
SDA Product17
Sun Dry Fish Meal
SDA Product17
Sunflower Wax
Flora Dye Chem
Sunset Yellow Fcf Lake
Standardcon Pvt. Ltd.150
Soluble Starch
Labh Ingredients152
Stearic Acid
Mivon Chemicals 28
Sulbactum Sodium Sterile Nova Chemiie 24
Sulfonamide of Torsemide
Prudence Pharma Chem Ear Panel / 81
Sulphamic Acid
Keshariya Corporation80
Sulfadimidine Sodium Ayon pharmachem 168
Sulphadoxin
Shree Raj Chem84
Sulphaquinoxaline Sodium Crystal Pharma76
Sulphonamide Of Glibenclamide
Prudence Pharma Chem Ear
Sulphonamide Of Glimepiride
Prudence Pharma Chem Ear Panel / 81
Sugar free, 100% Pure Pectin
Labh Ingredients152
Sulphur Powder
Gautam Pharma Chem84
Sunflower Oil Krishna Solvechem Ltd.21
Surfactant Krishna Antioxidants Pvt. Ltd.87
Sweetners Chemkart163
Sweetners all range international drug & chemical co.165
Synthetic
Krishna Solvechem Ltd.21 THF Khushbu Dye Chem Pvt. Ltd.71
Table Adhesives Krishna Antioxidants Pvt. Ltd.87
Tabletop Inkjet Advanced Industrial Micro Systems
Table Salt SDA Product17
Tacrolimus Balaji Corporation89
Lab Sciences Limited218 Talc Purified
Powder
Pharma160
Gautam Pharma Chem93
Kems Raw Pharma77
Keshariya Corporation80 Reenold Enterprises137
Talcum powder IP/ BP/ USP
Hritik Chemicals Pvt. Ltd.99
Hcl
Chemiie
Tamsulosin HCL IP/BP
Hritik Chemicals Pvt. Ltd.91
Tamsulosin Hcl Sr Pellets (0.145% / 0.16%) Kahan Pharmaceuticals
Tamsulosin -Sr 0.1%, 0.2%, 0.4%Pellets
Panchsheel Organics Limited91
Tannic Acid
Kems Raw Pharma93
Tapentadol
Panchsheel Organics Limited91
Nova Chemiie 24
Tapentadol Ip
Aril Pharmaceuticals6/7
Tarazocine
Balaji Corporation89
Tapentadol Ip
Kahan Pharmaceuticals 08
Tapentadol HCL
Vinworld Healthcare P. Ltd147
Tcca - 90% (Granular & Tablet)
Keshav Hichem Pvt. Ltd. 21
Tartari Acid
Kronox Lab Sciences Limited218
Tartaric Acid Pellets
Hritik Chemicals Pvt. Ltd.99
Tartrazine Lake Standardcon Pvt. Ltd.150
Taurine
Terconazole
Balaji Corporation89
Testosterone (TES) - BP / EP / USP VM Life Science108
Testesterone Bp (And Derevetive)
Balaji Corporation89
Testesterone Cypionate
Balaji Corporation89
Testosterone Decanoate (TD) - BP / EP VM Life Science108
Testosterone Enanthenate / Decanoate / Cypionate / Undecanoate
Methyl Panchsheel Organics Limited91
Testosterone Phenylpropionate (TPP) – BP VM Life Science108
Testosterone Propionate (TP) - IP / BP / EP / JP / USP
VM Life Science108
Testosterone Undecanoate (TUD) – IH
VM Life Science108
B.J. Scientific Co. 162
Terlipressin Acetate
Balaji Corporation89
Tert-Butanol (TBA)
Chemstar Global Products LLP76
Tert Butyl Bromoacetate
Krishna Solvechem Ltd.21
Tert-Butyl Chloride (TBC)
Chemstar Global Products LLP76
Tert Butyl Dimethyl ChloroSilane
Maruti Petrochem55
Tert-Butylhydroquinone (TBHQ)
Chemstar Global Products LLP76
Tertiary Butanol
Mivon Chemicals 28
Krishna Solvechem Ltd.21
Maruti Petrochem55
Apra Enterprises19
Apra Innovative Pvt Ltd19
Tetramisole
NGL Fine - Chem Limited105
Tetra Pyro Phosphate
Advance in Organics LLP128
Tetra Sodium Pyrophosphate
Pari Chemicals136
Tetra Sodium Pyro Phosphate
Advance in Organics LLP128
Tertiary Butyl Amines
Krishna Solvechem Ltd.21
Tertiary Butyl Hydroquinone (TBHQ)
Dev International158
Temperature Sensor with Deep Freezer
Temperature Sensor with indicator Thermo hygrometer
Avi Scientific (India)168
Testosterone & Salts
Panchsheel Organics Limited91
Teterabutylammonium Hydrogen Sulphate (TBAHS)
Mody Chemi Pharma Pvt. Ltd. 47
Terpineol
Vikram Aromatics144
Tetrabutylammonium Bromide
Relic Chemicals82
Tetrabutylammonium Hydrogen Sulphate
Relic Chemicals82
Tetra Butyl Ammonium Bromide
Mody Chemi Pharma Pvt. Ltd. 47
Tetra Butyl Ammonium Bromide (TBAB)
AD Pharmachem Pvt Ltd 30
Yuvi Chemz148
Tetra Butyl Ammonium Hydrogen Sulphate (TBAHS)
214 THE MAZADA PHARMA GUIDE
Elementos
Ltd. 104 Stearic Acid - Distric Kanchan Rasayan 34 Stearic Acid - Hystric Kanchan Rasayan 34 Stearic Acid - Hytitre Kanchan Rasayan 34 Stearic Acid - Lubstric 995 Kanchan Rasayan 34 Stearic Acid - Textric Kanchan Rasayan 34
Acid - Textric Special Kanchan Rasayan 34
Pvt.
Stearic
34
Stearyl Alcohol Kanchan Rasayan
126
Panel / 81
Rubber Krishna Antioxidants Pvt. Ltd.87 Synthetic Silicone Wax Flora Dye Chem 126 Synthetic Wax Flora Dye Chem 126 T.C.P Siddhivinayak Pharma160 T D I H K Enterprise151 T.G.
Misrimal
Urea
Pukhraj122
25
Vinworld Healthcare
Limited91 Vinworld Healthcare P. Ltd147 NDC Drug & Chemical Co.Pvt.Ltd. 154 Reenold Enterprises137 Tadalafill
Sheetal Chem 101
Kronox
Western
Talc
Sheetal
101 Talcum
P. Ltd147 Tadalafil Panchsheel Organics
Usp
Talc
Pharma105
Powder
Chem
Siddhivinayak
Tamsulosin
Balaji
NDC Drug & Chemical Co.Pvt.Ltd. 154 Nova
24
Corporation89
08
Chemkart163 Raivat
Tazobactam Sodium Sterile Balaji Corporation89 Nova Chemiie 24 TEA 93% Maruti Petrochem55 TEA 99% Maruti Petrochem55 Tea Tree Oil Global Merchants25 TEG Paresh
Corporation 78 Technical Grade Urea (TGU) Apra Enterprises19 Apra Innovative Pvt Ltd19 Technical Grade Urea Thana Acid & Chemical Co145 Tolulene Disocyanates (TDI) Thana Acid & Chemical Co145 Tara Gum Labh Ingredients152 Telmisartan Panchsheel Organics Limited91 Nova Chemiie 24 NDC Drug & Chemical Co.Pvt.Ltd. 154 Dazzle Corporation88 Tenegliptin HCL Dazzle Corporation88 Torsemide Dazzle Corporation88 Telmisartan Ip Aril Pharmaceuticals6/7 Vinworld Healthcare P. Ltd147 Hap Enterprise67 Telmisartan IH / IP Malay Enterprise167 Telmisartan IP/BP/USP Jay Chem Marketing128 Telmisartan Ip/Ep/Usp Shriya Pharma & Surgical42 Telmisartan + Hydrochlorothiazide Pellets Panchsheel Organics Limited91 Teneligliptin Vinworld Healthcare P. Ltd147 Jay Chem Marketing128 DM Pharma22 Hap Enterprise67 NDC Drug & Chemical Co.Pvt.Ltd. 154 Shriya Pharma & Surgical42 Teneligliptin Hbr Nova Chemiie 24 Teneligliptin I.H.S. Kahan Pharmaceuticals 08 Tenofovir DM Pharma22 Teralin Chemaroma Drug House 99 Tenoxicam - BP/USP Progress Life Sciences Pvt. Ltd.29 Tenoxicam Sterile Nova Chemiie 24 Terbinafine Hcl Ip/Bp Aril Pharmaceuticals6/7 Terbinafine Hcl Usp Mahaveer Chemicals Ear Panel Terbinafine Hcl Ip / Bp / Ep Kahan Pharmaceuticals 08 Terbinafine Hydrochloride Ep/ Usp/Bp Shriya Pharma & Surgical42 Terbutalin Sulphate Aril Pharmaceuticals6/7 Parshwa Pharma Chem Pvt. Ltd.40 Terbutaline Sulphate Ip. Shriya Pharma & Surgical42
Impex Pvt. Ltd.59
Chemical
PRODUCTS INDEX
AD Pharmachem Pvt Ltd 30
Tetrabutyl Ammonium fluoride Trihydrate / 1M in THF
Regal Remedies Limited36
Tetraethylene Pentamine
Mivon Chemicals 28
Tetrahydrocurcumin
Balaji Corporation89
Tetra Hydro Furan
Mivon Chemicals 28
Krishna Solvechem Ltd.21
Maruti Petrochem55
Apra Enterprises19
Tetraethylammonium Fluoride Trihydrate/1Min THF
Regal Remedies Limited36
Tetrafluoroboricaciddiethyl
Regal Remedies Limited36
Tetramethylammonium Fluoride Trihydrate / 1M in THF
Regal Remedies Limited36
Tetramethyl Ammonium Hydroxide Pentahydrate
Croma Chemical Corporation106
Tetraphenyl Dipropyleneglycoldi Phosphite (Thop)
Krishna Antioxidants Pvt. Ltd.87
Tetrapotassium Pyrophosphate
Pari Chemicals136
Tetra Potassium Pyro Phosphate
Qualikems Lifesciences Pvt. Ltd.139
Tetra Sodium Pyro Phosphate
Qualikems Lifesciences Pvt. Ltd.139
Tetracycline Hcl
Crystal Pharma76
Nova Chemiie 24
Textile Softeners
Krishna Antioxidants Pvt. Ltd.87
Textile Enzyme
Enzyme Bioscience57
Thalidomide
Panchsheel Organics Limited91
Thallium Iodide
SVG Pharma Lifesciences Pvt. Ltd.145
Theobromine
DM Pharma22
Theophyllinie
DM Pharma22
Thermometers, Calibration Certificate for ISO
B.J. Scientific Co. 162
THF
Nisha Chemicals71
Tulathromycin
Calyx Chemical & Pharmaceuticals Ltd.23
Paresh Chemical Corporation 78
Tungstic Acid
HK Group76
Theophylline
Bakul Aromatics and Chemicals Pvt. Ltd.103
Thiamine Hcl
Parshwa Pharma Chem Pvt. Ltd.40
Thio Colchicoside
Regent Chemicals 41
Thyme Extract
CSV Pharmaceuticals India Pvt. Ltd.169
Triphala Extract
CSV Pharmaceuticals India Pvt. Ltd.169
Tripotassium Phosphate
Pari Chemicals136
Turmeric Oil
CSV Pharmaceuticals India Pvt. Ltd.169
Turpentine Oil
Vikram Aromatics144
Turmeric Oleoresins
CSV Pharmaceuticals India Pvt. Ltd.169
Thio Compounds
Stratechem (I) Pvt. Ltd. 88
Thio Phenol
Sheetal Chem 101
Stratechem (I) Pvt Ltd.88
Thiocarbonyl Hydrazide
Krishna Solvechem Ltd.21
Thymolphthalein
Heni Drugs Pvt. Ltd.49
Thiocolchicoside
Aril Pharmaceuticals6/7
Thiocolchicoside Ip
Balaji Corporation89
Kahan Pharmaceuticals 08
Thiocolchecoside Ip/Fp
DM Pharma22
Thioglycolic Acid
Mivon Chemicals 28
Thioglycolic Acid 80%
Jay Chem Marketing128
Thioglycolic Acid 80 / 99% & Derivative
Kip Chemicals Pvt. Ltd.81
Thiomalic Acid 99%
Balaji Corporation89
Thiomersal
Oxford Laboratory Chemicals141
Thionyl Chloride
Sunraj Chemical co.144
Ketan Chemical Corporation119
Krishna Solvechem Ltd.21
Ashapura Intermediates119
Thiophene
Kip Chemicals Pvt. Ltd.81
Thioure (Imported)
Keshariya Corporation80
Thiourea
Siddhivinayak Pharma160
Thymidine
Oxford Laboratory Chemicals141
Thyroxine Sodium
Balaji Corporation89
Tiamulin Funerate 10%
SDA Product17
Tiamuline Hydrogen Fumarate
Crystal Pharma76
Tiamulin Hydrogen Fumarate 10% Granular Feed Grade
Rosetta Life Care Private Limited14
Tiamulin Hydrogen Fumarate
U.K. Vet Chem65
Tibolone
Balaji Corporation89
DM Pharma22
Hritik Chemicals Pvt. Ltd.99
Ticagrelor
NDC Drug & Chemical Co.Pvt.Ltd. 154
Shriya Pharma & Surgical42
Tigecycline
Balaji Corporation89
international drug & chemical co.165
Tilmicosin Phosphate
U.K. Vet Chem65
Timolol Maleate
Jay Chem Marketing128
Tin Metal Granular
Qualikems Lifesciences Pvt. Ltd.139
Tioconazole
Balaji Corporation89
Titanium Dioxide
Hap Enterprise67
NDC Drug & Chemical Co.Pvt.Ltd. 154
Titanium Dioxide (Anatase/ Rutile)
Gautam Pharma Chem84
Titanium Dioxide ( E171 / Bp / Ecc /Fresenius / Isega / Jp / Kosher / Nf / Ohsas / Ph.eur / Star- K / Tse / Bse / Usp )
Chemi Enterprises LLP69
Tizanidin Hcl
Hap Enterprise67 Tizanidine Hcl IP/BP/USP
Chemiie
Tobramycin Sulphate
Vinworld Healthcare P. Ltd147 Top Labeling
Advanced Industrial
Toxin Binder (Datox)
SDA Product17
TPTZ
Croma Chemical Corporation106
Tramadol HCL
Neha Pharma Pvt. Ltd.165
Tramadole Hcl IP/BP/USP
Chem
Nova Chemiie
Tranexamic Acid
Parshwa Pharma Chem Pvt. Ltd.40
Balaji Corporation89
Aril Pharmaceuticals6/7
NDC Drug & Chemical Co.Pvt.Ltd.
Kahan Pharmaceuticals
Tranexamic Acid Ip
Shriya Pharma & Surgical42
Trans-1,2-Diaminocyclohexane Tetra Acetic Acid
Croma Chemical Corporation106
Transformer Oil
Ketan Chemical Corporation119
Travoprost
Balaji Corporation89
Aara Pharma150
Tray Wrapping
Advanced Ind. Micro Systems25
Trazodone HCL international drug & chemical co.165
Trehalose Chemkart163
Raivat Impex Pvt. Ltd.59
Trenbolone Acetate
Balaji Corporation89
Panchsheel Organics Limited91
Tretinoin /Microspheres
Panchsheel Organics Limited91
Tretinoin Ip / Bp / Usp
Siddhivinayak Pharma160
Tretinoin 99%
Balaji Corporation89
Tretinoin Pellets
Panchsheel Organics Limited91
Tretinoin Usp
DM Pharma22
Hiten Pharma Chem152
Triamcinolone DM Pharma22
Triamcinolone Acetonide (Micronized)
Balaji Corporation89
Triamcinolone Acetonide
Panchsheel Organics Limited91
Ltd.99
Solvechem Ltd.21
Tri-N-Butyl Amine
Krishna Solvechem Ltd.21
Tridecyl Phosphite (Tdp)
Krishna Antioxidants Pvt. Ltd.87
Triethylamine Trihydrofluoride
Regal Remedies Limited36
Triethylbenzylammonium Chloride ( TEBAC)
Mody Chemi Pharma Pvt. Ltd. 47
Tri Ethinolamine/diethinolamine
Siddhivinayak Pharma160
Trifluoro Acetic Acid
Maruti Petrochem55
Trifluoro Acetic Acid Anhydride
Maruti Petrochem55
Trifluoperazine Hcl
NDC Drug & Chemical Co.Pvt.Ltd. 154
Trifluperazine Hcl
Parshwa Pharma Chem Pvt. Ltd.40
Trifluperazine Hcl Ip
Aril Pharmaceuticals6/7
Trihexyphenidyl Hcl Ip
Aril Pharmaceuticals6/7
Tri Choline Citrate 50%/65%/78% Aq. Solution
Ayon pharmachem
168
Triisodecyl Monophenyl Dipropyleneglycol Di Phosphite (S34)
Krishna Antioxidants Pvt. Ltd.87
Trilauryl Phosphite (Tlp)
Krishna Antioxidants Pvt. Ltd.87
Trimetazidin
Hap Enterprise67
Trimethoprim
Reenold Enterprises137
Trimetazidine Ip/Bp/Usp
Pramukh Pharmachem Pvt. Ltd.80
Terinomie Ih/Ep
Pramukh Pharmachem Pvt. Ltd.80
Trimetazidine Hcl
Nova Chemiie 24
Tri Methoprime
Crystal Pharma76
Trimethorprim Vinworld Healthcare P. Ltd147
Tri Phenyl Phosphite (Tpp)
Ketan Chemical Corporation119
Krishna Antioxidants Pvt. Ltd.87
Tri Sodium Phosphate
Krishna Solvechem Ltd.21
Ashapura Intermediates 119 Meru Chem Pvt. Ltd.105
Paresh Chemical Corporation
Chemicals103
Trimetazidin
THE MAZADA PHARMA GUIDE 215
24
Nova
25 Tobramycine
Balaji
Tocotrienols
North India
Touch Screen Advanced Industrial
25 Tolfenamic Acid Panchsheel
Tolfenamic
Maharshee
Ltd. 133 Tolfenamic Acid BP/EP Nira Life Sciences Pvt. Ltd.25 Diligent Life Care38 Tolfenamic Acid (Oral & in-jectable) Nova Chemiie 24 Toldimfos Sodium Ngl Fine Chem Ltd. 105 Tolnaftate Kems Raw Pharma93 Nova Chemiie 24 Tolperisone Hap Enterprise67 NDC Drug & Chemical Co.Pvt.Ltd. 154 Tolperisone Hcl Jp Aril Pharmaceuticals6/7 Toltrazuril Rosetta Life Care Private Limited14 NGL Fine - Chem Limited105 Toulene Mivon Chemicals 28 Khushbu Dye Chem Pvt. Ltd.71 Paresh Chemical Corporation 78 Gandhi Chemicals 144 H K Enterprise151 Maruti Petrochem55 Apra Enterprises19 Toluene Diisocyanate (TDI) Chemstar
Tolytriazole Relic Chemicals 82 Topiramate NDC Drug & Chemical Co.Pvt.Ltd. 154 Topiramate Usp Aril Pharmaceuticals6/7 Torsemide Balaji
Panchsheel Organics Limited91 Prudence Pharma Chem Ear Panel / 81 Nova Chemiie 24 Hap Enterprise67 Synthetic Molecules71 NDC Drug & Chemical Co.Pvt.Ltd. 154 Touch Screen
Jet Printer Adv.
27
Micro Systems
Sulphate / Sterile
Corporation89
50%
Pharma92
Micro Systems
Organics Limited91
Acid Bp
Laboratories Pvt.
Global Products LLP76 Tolyltriazole Chemstar Global Products LLP76
Corporation89
Ink
Industrial Micro Systems
Sheetal
101
24
154
08
Triamterene
Organics Limited91 Tri‐N‐Butylamine Relic Chemicals82 Tri Butyl Tin Chloride Noble Chemical Agency 92 Tri-Calcium Phosphate IP / Feed Arco Pharma126/164 Tri-Calcium Phosphate
SDA Product17 Meru Chem Pvt. Ltd.105 Tri Calcium Phosphate (IP Grade) Vinworld Healthcare P. Ltd147 Tri Calcium Phosphate Advance in Organics LLP128 Tri Calcium Phosphate IP / BP / USP Gangotri Inorganic (P) Ltd.18 Tri Choline Citrate Crystal Pharma76 Suprim Chemicals76 Nova Chemiie 24 Tricholine Citrate 50% & 65% & 78% Solution – IHT M/S. Alba Organics.91 Tri Choline Citrate 50%/65%/78% Aq. Solution Ayon pharmachem 168 Triclabendazole Sheetal Chem 101 Ngl Fine Chem Ltd. 105 Siddhivinayak Pharma160 Reenold Enterprises137 Nova Chemiie 24 Triclabendazole Orex Pharma Pvt. Ltd.25 Triclabendazole BP VET/EP Chemino Pharma Ltd94 Triclabendazole Ip Kahan Pharmaceuticals 08 Tri Ethanol Amine (TEA) Dev International158 Tri Ethanolamine Siddhivinayak Pharma160 Tri Ethyl Amine (TEA) Dev International158 Mivon Chemicals 28 Khushbu Dye Chem Pvt. Ltd.71 Krishna Solvechem Ltd.21 Tri Ethyl Benzyl Ammonium Chloride (TEBACI) AD Pharmachem Pvt Ltd 30 Tri Ethyl Ortho Formate (TEOF) Krishna Solvechem
Krishna
Heni
Tri
Krishna
Krishna
Unimax Group 20 Triamcinolone Acetonide/ Base Hritik Chemicals Pvt.
Triamcinolone Salts Nova Chemiie 24
Panchsheel
(Tcp)
Ltd.21 Triethyl Amine HCL
Solvechem Ltd.21 Triethyl Citrate
Drugs Pvt. Ltd.49
Methyl Amine (TMA)
Solvechem Ltd.21 Tri Methyl Ortho Formate (TMOF)
Tri Ethylene Glycol Mivon Chemicals 28 Tri Ethanolamine Mivon Chemicals 28 Triethanolamine
78
Trihexyphendyl Luconic
PRODUCTS INDEX
NDC Drug & Chemical Co.Pvt.Ltd. 154
Trimethobenzamide HCl
Synthetic Molecules71
Triprolidine Hcl
Panchsheel Organics Limited91
DM Pharma22
Tris (2,4-Ditert-Butylphenyl) Phosphite
Krishna Antioxidants Pvt. Ltd.87
Tris (Tridecyl) Phosphite (Ttdp)
Krishna Antioxidants Pvt. Ltd.87
Tris Buffer
Mivon Chemicals 28
Triss Buffer AR 99.9%
Maruti Petrochem55
Tlmisartan Granules 20%
YSK Laboratories Pvt. Ltd.56
Tradalafil Granules 10%
YSK Laboratories Pvt. Ltd.56
Tris Dilbenzylideneacetone Pd0
Indian Platinum Pvt. Ltd.158
Tris Nonyl Phenyl Phosphite (Tnpp)
Krishna Antioxidants Pvt. Ltd.87
Trioxsalen Usp
Aril Pharmaceuticals6/7
Triprolidine HCL
Neha Pharma Pvt. Ltd.165
Trisodium Phosphate
Pari Chemicals136
Troxerutin
North India Pharma92
Trypsin Bp
international drug & chemical co.165
Tryptone
Eklavya Biotech Pvt. Ltd.103
Trypsin
Nova Chemiie 24
Jakson Pharma104
Asiel Chemipharma35
Trypsin Chymotrypsin
international drug & chemical co.165
Trypsin Chymotrypsin Mix (6:1)
Jakson Pharma104
Tubings, Rods, Crucibles, Plates, Beakers etc.
B.J. Scientific Co. 162
Turmeric Curcumin Powder 103%
DM Pharma22
Turmeric Extract
Global Merchants25
Toluene
Apra Innovative Pvt Ltd19
Turmeric Oleoresin
DM Pharma22
Tween-82-80
Siddhivinayak Pharma160
Tween 80
Crystal Pharma76
Siddhivinayak Pharma160
Tween-80 (Polysorbate 80) / Tween-20
Meru Chem Pvt. Ltd.105
Tylosin Phosphate
Crystal Pharma76
Tylosin Phosphate 10%
Unitrade Agencies70
SDA Product17
Tylosin Phosphate 10% Granular Feed Grade
Rosetta Life Care Private Limited14
Tylosin Tartrate Bp Vet Pure
Crystal Pharma76
Tylosin Tartrate
U.K. Vet Chem65
UDCA
Aara Pharma150
NDC Drug & Chemical Co.Pvt.Ltd. 154
UV/Vis - Uv5
Khushboo Scientific13
Urea
Qualikems Lifesciences Pvt. Ltd.139
Kronox Lab Sciences Limited218
Reenold Enterprises137
Ultrasonic/Heat Tube Sealing
Advanced Industrial Micro Systems 25
Urea Hydrofluoride
Regal Remedies Limited36
Urea Techincal Grade
Keshariya Corporation80
Uridine
Croma Chemical Corporation106
Ulipristal Acetate
Balaji Corporation89
DM Pharma22
Hritik Chemicals Pvt. Ltd.99
Ursodeoxycholic Acid
Vinworld Healthcare P. Ltd147
Kahan Pharmaceuticals 08
Ursodeoxycholic Acid IP
Balaji Corporation89
Ursodeoxycholic Acid Ip/Ep.
Shriya Pharma & Surgical42
Ursodeoxycholic Acid (UDCA) IP/EP
Hritik Chemicals Pvt. Ltd.99
Urapidil
Bakul Aromatics and Chemicals Pvt. Ltd.103
Vacuumed Tray Dryer
Emco Engineering Pvt. Ltd.161
Vacuum Pumps
AVI Scientific (India)35
Valacyclovir
Balaji Corporation89
Valporic Acid
Luconic Chemicals103
Valproic Acid IP/ USP
Hritik Chemicals Pvt. Ltd.99
Valacyclovir HCI/USP
Shamrock Pharmachem38
Valsartan
Panchsheel Organics Limited91
Valsartan IP/BP/USP
Luconic Chemicals103
Valthamate Bromide
Luconic Chemicals103
VAM
Khushbu Dye Chem Pvt. Ltd.71
H K Enterprise151
Vancomycine Hcl Sterile
Balaji Corporation89
Vancomycin Hydrochloride Sterile
Nova Chemiie 24
Vanillin Chemstar Global Products LLP76
Vacuum Oven
Kesar Control Systems49
Vertical Autoclave
Kesar Control Systems49
Vedilagliptin Ip
Kahan Pharmaceuticals 08
Veg Pancreatain(Ip/Bp/Usp)
Asiel Chemipharma35
Venlaflexime
Aril Pharmaceuticals6/7
Venlafaxine
Hap Enterprise67
Venlafaxine Bp/Ep/Usp
DM Pharma22
Venlafaxine Hcl
NDC Drug & Chemical Co.Pvt.Ltd. 154
VGEL Kulfi Stab
Labh Ingredients152
VGEL L/4
VGEL Prime
VGEL Thick Shake
VGEL Water Lolly Stab
Labh Ingredients152
Venpocitine
DM Pharma22
Vernier Calipers, Gauges etc.
B.J. Scientific Co. 162
Verapamil Hcl
Kahan Pharmaceuticals 08
Vetiver Essential Oil
Amita Chemicals102
Vermectin IP VET
Siddhivinayak Pharma160
Veterinary Product Chemical Matrix166
Vigabatrin
Balaji Corporation89
Vildagliptin Nova Chemiie 24
Vinworld Healthcare P. Ltd147
NDC Drug & Chemical Co.Pvt.Ltd.
Shriya Pharma & Surgical42
Calyx Chemical & Pharmaceuticals Ltd.23
Vildagliptin Granules 25.30%
YSK Laboratories Pvt. Ltd.56
Vildagliptin IP/BP Hritik Chemicals Pvt. Ltd.99
Vinyl Acetate Paresh Chemical Corporation
Vinyl Acetate Monomer (VAM)
Apra Enterprises19 Apra Innovative Pvt Ltd19
Viscosity Index Improver For Hydraulic & Gears
Krishna Antioxidants Pvt. Ltd.87
Vit B1/B2/B6/B12/D3
Siddhivinayak Pharma160
Vitamins
Shreenath Chemicals82
Vitamins (Pharma/Feed Grade)
Dazzle Corporation88
Vitamin-A 1,00,000i.U
SDA Product17
Vitamin-A 106.5%Liquid
SDA Product17
A Acetate
Parshwa Pharma Chem Pvt. Ltd.40
Vitamin A Acetate 325/500 cws Chemkart163
Vitamin A Acetate Dry Powder
Shree Raj Chem84
Vitamin A Acetate Powder
Malay Enterprise167
Vitamin-Ad2
SDA Product17
Vitamin AD3
Malay Enterprise167
Vitamin Ad3 1000/200
SDA Product17
Vitamin AD3 Feed Grade
Hritik Chemicals Pvt. Ltd.99
Vitamin A Palmitate 1.7 Miu
Malay Enterprise167
Vitamin A Palmitate
Shree Raj Chem84
Vitamin A Palmitate / Acetate
Dev International158
Vitamin All
Crystal Pharma76
Vitamin B1 Hcl
Nova Chemiie
Viramin B1 HCl (Thiamine Hydrochloride)
Malay Enterprise167
Vitamin B1 (Thiamine Mono Nitrate/HCl)
Chemizo Enterprise166
Vitamin B1 Hcl / Mono
Shree Raj Chem84
Vinworld Healthcare P. Ltd147
Hritik Chemicals Pvt. Ltd.99
Vitamin B1 Mono
Nova Chemiie
Vitamin B1 Mono (Thiamine Mononitrate)
Malay Enterprise167
Vitamin B 1 (Thiamin Mono / HCL ) Dev International158
Vitamin B12
Dev International158
Vita-Min Probitic93
Vitamin B12 (Cyanocobalamine ) Malay Enterprise167
Chemiie
Vitamin B12 1% Feed Grade
Rosetta Life Care Private Limited14
Vitamin B12 Ip
Kahan Pharmaceuticals
Vitamin B2
Vitamin
Vitamin E -50% - (Pharma Grade) Panchsheel Organics Limited91
Vitamin E 50% Powder (Food/Pharma Grade) Chemizo Enterprise166
Vitamin E 50% Food / Pharma Grade Rosetta Life Care Private Limited14
Vitamin E 50% Powder Feed Grade Rosetta Life Care Private Limited14
Vitamin E Acetate
Shree Raj Chem84
Global Merchants25
Vitamin E Feed / Dry Powder
Shree Raj Chem84
Vitamin E Liquid (DL-Alpha Tocopherol)
Malay Enterprise167
Vitamin E Liquid /50 % Powder Feed Grade
Hritik Chemicals Pvt. Ltd.99
Vitamin E Liquid / Dry Powder
Dev International158
Vitamin K Dev International158
Vitamin K1
North India Pharma92
Nova Chemiie 24
Vitamin K1 Liquid ( Phytomenadione ) Balaji Corporation89
Vitamin K2 ( Mk4 )Menatetrenone
Balaji Corporation89
North India Pharma92
Vitamin K2-7(Mk7)Menaquinone
Balaji Corporation89
North India Pharma92
Vitamin K2-7 (Menaquinone)
Panchsheel Organics Limited91
Vitamin K 3 Feed / Pharma
Kems Raw Pharma93
Vitamin E Powder 50%
Malay Enterprise167
Vitamin Oil 93.94% Feed Grade
Rosetta Life Care Private Limited14
Vitamin Premix
SDA Product17
Vitamin A - • Acetate / Palmitate Dry Powder • Liquid
Vita-Min Probitic93
Vitamin E - • Acetate Dry Powder • Liquid
Vita-Min Probitic93
Vitamin D3 - • Dry Powder • Liquid
Vita-Min Probitic93
216 THE MAZADA PHARMA GUIDE
154
78
Oils
24
24
24
Nova
08
Five
Shree Raj
Vitamin B2 Shree
Hritik
Pvt. Ltd.99 Vita-Min Probitic93 Vitamin B2
Malay Enterprise167 Nova Chemiie 24 Vitamin B2 80% Feed Grade Rosetta Life Care Private Limited14 Vitamin B2 80% Fg U.K. Vet Chem65 Vitamin B2 5 Hritik Chemicals Pvt. Ltd.99 Vitamin B2 5 Phosphate Nova Chemiie 24 Vit.B 2 5 Phosphate Ip/Bp Hiten Pharma Chem152 Vitamin B2 Pharma and Grade Unitrade Agencies70 Vitamin B5 (Calcium Pantothinate) Nova Chemiie 24 Vitamin B6 Shree Raj Chem84 Hritik Chemicals Pvt. Ltd.99 Vitamin B6 (Pyridoxol 5 Phosphate) Nova Chemiie 24 Vitamin B6 (Pyfidoxine HCl) Malay Enterprise167 Vitamin B 6 (Pyridoxine ) HCL Dev International158 Vitamin B7 (Biotin) Nova Chemiie 24 Vitamin C Hap Enterprise67 NDC Drug & Chemical Co.Pvt.Ltd. 154 Vitamin C (Acorbic Acid ) Nova Chemiie 24 Chemizo Enterprise166 Vit. B25 Kahan Pharmaceuticals 08 Vitamins - All series international drug & chemical co.165 Vitamin C Coated Food / Pharma Grade Rosetta Life Care Private Limited14 Vitamin C Coated IP Malay Enterprise167 Vitamin C Food / Pharma Grade Rosetta Life Care Private Limited14 Vitamin C Plain Shree Raj Chem84 Vitamin C Plain /Coated Hritik Chemicals Pvt. Ltd.99 Vitamin C Plain IP Malay Enterprise167 Vitamin C Plain & Coated Balaji Corporation89 Nova Chemiie 24 Vitamin D 600/50,000 I.U SDA Product17 Vitamin D2 1 Lac IU Shah TC32 Vitamin D2 40 MIU Shah TC32 Vitamin D2 103/500 cws Chemkart163 Vitamin D3 Shree Raj Chem84 Malay Enterprise167 Nova Chemiie 24 Vitamin D3 40 MIU Shah TC32 Vitamin D3 Fg U.K. Vet Chem65 Vitamin D3 5 Lac IU Shah TC32 Vitamin D3 103/500 cws Chemkart163 Vitamin D 3 (Cholecalciferol ) Dev International158
Phosphate
Chem84
Raj Chem84
Chemicals
(Riboflavin)
Rosetta
Siddhivinayak
Hap
SDA
NDC
D3 Powder (5Lac IU/GM) Feed Grade
Life Care Private Limited14 Vitamin D3 Stabillized
Pharma160 Vitamin E 50%
Enterprise67
Product17 Chemkart163
Drug & Chemical Co.Pvt.Ltd. 154
PRODUCTS INDEX
Pharmaceuticals77
Shagun Pharmaceuticals77
Pharmaceuticals77
Pharmaceuticals77
Shagun Pharmaceuticals77
Pharmaceuticals77
Pharmaceuticals77
Pharmaceuticals77
Shagun Pharmaceuticals77
Virging Blackseed Oil
Shagun Pharmaceuticals77
Virging Moringa Oil
Shagun Pharmaceuticals77
Virging Safflower Oil
Shagun Pharmaceuticals77
Voglibose IP/BP/USP
Aril Pharmaceuticals6/7
Voglibose Siddhivinayak Pharma160 Balaji Corporation89
Vinworld Healthcare P. Ltd147
Aara Pharma150 DM Pharma22
Corporation89
Panchsheel Organics Limited91 Vulkanox BKF- Rubber Antioxidant Kip Chemicals Pvt. Ltd.81 Warfarin Sodium Ip Hap Enterprise67
Waffle Premixes (LA-WA)
Labh Ingredients152
Wallpaper Adhesives
Labh Ingredients152
Warfarin Sodium Clathrate-IP/BP/USP/EP
Oceanic Laboratories Pvt. Ltd.44
Water Based Silicone Wax Flora Dye Chem 126
Control Systems49
Systems49
- Drinking & Effluent
Test House Private Limited93
International158
Chemicals41
Granulation
Equipments LLP149
Agents
Antioxidants Pvt. Ltd.87 Wheatgerm Oil Kamakhya ImpexFlap Wheat Bran Powder SDA Product17
Grains SDA Product17 Whey Protein Concentrate Chemkart163
Dairies39 Eklavya Biotech Pvt. Ltd.103
Protein Isolate Chemkart163
Eklavya Biotech Pvt. Ltd.103
dexstrine Keshariya Corporation80
Bees Wax - IP / BP / USP / EP
Beeswax Industries169
Petroleum Jelly - IP / BP / USP / EP
Beeswax Industries169
Dextrin 163 Shree Chemicals117
Petroleum Jelly IP/ BP Hritik Chemicals Pvt. Ltd.99
Wright Stain
Oxford Laboratory Chemicals141
Wood Seal A (Fire Retardants) Relic Chemicals
Bees Wax - IP / BP / USP / EP
Arjun Beeswax Industries169 Yellow Phenolphthalein USP
Heni Drugs Pvt. Ltd.49
Yellow -USP
Heni Drugs Pvt. Ltd.49
Yellow Petroleum Jelly - IP / BP / EP
Arjun Beeswax Industries169
Xanthan Gum Chemstar Global Products LLP76 Sheetal Chem 101
Siddhivinayak Pharma160 Krishna Solvechem Ltd.21
Meru Chem Pvt. Ltd.105
Lab Sciences Limited218
Chloride 80%
Chemicals Pvt. Ltd.31 Zinc Chloride – Liqd. / Powder / Anhydrous
Pharma76
Xylometazoline Hcl Panchsheel Organics Limited91 Xylometazoline Hcl Ip Aril Pharmaceuticals6/7 Xylometazoline- Nasal Spray
Corporation89
Food Colour
Platinum Pvt. Ltd.158 Ylang Ylang Oil Kamakhya ImpexFlap
Yeast Extract Paste Eklavya Biotech Pvt. Ltd.103 Yeast Extract Powder F Eklavya Biotech Pvt. Ltd.103 Yeast Extract Powder R Eklavya Biotech Pvt. Ltd.103 Z. P. T. O
Pharma160
(Fg) Granular
Laboratories Pvt. Ltd.44
Zinc Acetate
Platinum Pvt. Ltd.158
Lab Sciences Limited218
in Organics LLP128
Picolinate
Laboratories Pvt. Ltd.44
Zinc Acetate Pure Kems Raw Pharma93
Zinc Amino Acid Chelate
Eklavya
Zinc Sulphate & More... Yuvi Chemz148
Zinc Sulphate Heptahydrate
Lifesciences Pvt. Ltd.139
Lab Sciences Limited218 Zinc Sulphate Monohydrate USP
Pharma126/164 Zinc Sulphide (Venator)
Chemical Corporation106 Zinc Sulphite
Lifesciences Pvt. Ltd.139
Lab. Pvt. Ltd44 Zolpidem Tartrate Ip
THE MAZADA PHARMA GUIDE 217 AGENT IN PHARMACEUTICAL RAW MATERIALS KRUNAL V. VORA Mob : 9029224805 / 9321224805 Vora_krunal @yahoo.in Contact: B/004 , Nandanvan CHS, D.S Nagar, New Bldg no. 1, Narsing Lane, Opp N.l High School, Malad (W), Mumbai- 400064 Tel : 8169878803 l l E-mail : v.voraandsons@gmail.com V. VORA & SONS VIJAY R. VORA Mob : 9322266920 / 9699127200 vijayrvora@gmail.com Vitamin C - • Plain Dry Powder • Coated Dry Powder Vita-Min Probitic93 Vitamin AD3 - • Dry Powder Vita-Min Probitic93 Virgin Almond Oil
Oil
Shagun
Virgin Coconut
Virgin Grapeseed Oil
Virgin
Oil
Virgin
Oil
Virgin
Virgin
Shagun
Virgin Jojoba Oil Shagun
Karanja
Mustard
Shagun
Neemseed Oil Shagun
Sesame Oil Shagun
Virgin Walnut Oil
Voriconazole Balaji
Walk
Kesar
Water
Bombay
Water
Dev
Waxes Regent
Wet
Filtromix
Wetting
Krishna
Wheat
in Chamer
Chillers Kesar Control
Water
Treatment Group
Modern
Whey
White
White
Indian
White
Soft Paraffin IP,BP Flora
Chem 126 White
Wax Flora
126 White
White
White
Arjun
White
Arjun
Food Colour
Platinum Pvt. Ltd.158
/ Yellow / Yellow
Dye
/Yellow
Dye Chem
82
Yellow
Dev
Xanthan
Jay
Crystal
Raivat
Xylazine
NGL Fine
Limited105 Xylene
Oxford Laboratory
Xylenol
Oxford
Maruti Petrochem55 Advance in Organics LLP128 Labh Ingredients152 Xanthan Gum All Grade
International158 Xanthan Gum (200 Mesh) Malay Enterprise167
Gum (80 Mesh & 200 Mesh)
Chem Marketing128 Xanthan Gum Usp
Pharma76 Xylanase SDA Product17 Xylitol Powder
Impex Pvt. Ltd.59
HCl
- Chem
Cyanol Ff
Chemicals141
Orange
Laboratory Chemicals141 Xylometazoline IP/BP/USP Crystal
Yellow
Indian
Balaji
Siddhivinayak
Zeaxanthin North
Zeopharm® 250 Kanchan Rasayan 34 Zeopharm® 600 Kanchan
34 Zinc
Crystal
Oceanic
India Pharma92
Rasayan
Pharma76 Zinc Polynicotinate
Indian
Kronox
Advance
Zinc
Oceanic
Biotech Pvt. Ltd.103 Zinc Bacitracin
Healthcare P. Ltd147 Zinc Baitracin Balaji Corporation89 Zinc bis glycinate B.Pankaj & Co.84 Zinc Bromide Mody Chemi Pharma Pvt. Ltd.
Indian
Kronox
Hritik
Zinc
Kronox
HK
Navnidh
Advance
Kronox
Qualikems
Zinc
Kronox
Zinc
SVG Pharma
Zinc
Balaji
Panchsheel
Zinc
Indian Platinum
Zinc
Gautam
Crystal
Ketan Chemical
DM
SDA
Kronox Lab Sciences
Zinc
Ashapura
Zinc
Meru Chem
Advance
Zinc
Siddhivinayak
Zinc
Suprim
Indian
Zinc
Elite
Zinc
Indian
SDA
Vinworld
47 Zinc Carbonate
Platinum Pvt. Ltd.158
Lab Sciences Limited218 Zinc Carbonate IP/BP
Chemicals Pvt. Ltd.99
Chloride
Zinc
Vinipul
Group76 Zinc Citrate
Pharma lab106
in Organics LLP128 Zinc Citrate Dihydrate
Lab Sciences Limited218 Zinc Fluoride
Lifesciences Pvt. Ltd.139
Gluconate
Lab Sciences Limited218
Iodide
Lifesciences Pvt. Ltd.145
Mono Methionine
Corporation89
Organics Limited91
Nitrate
Pvt. Ltd.158
Oxide
Pharma Chem84
Pharma76
Corporation119
Pharma22
Product17
Limited218
Oxide – 99%
Intermediates 119
Oxide / Sulphate
Pvt. Ltd.105 Zinc Phosphate
in Organics LLP128
Pyrithione
Pharma160
Stearate
Chemicals76
Platinum Pvt. Ltd.158
Stearate Ip/bp/usp
Chemicals89
Sulphate
Platinum Pvt. Ltd.158
Product17 Zinc Sulphate Hepta Hydrate / Mono Hyadrate HK Group76
Qualikems
Kronox
Kronox
Khandelwal
Aril
Nova
Zopiclon Sheetal Chem 101
Hazardous
Recycling
Lab Sciences Limited218 Zinc Sulphate Monohydrate
Arco
Croma
Qualikems
Zolendronic Acid
Pharmaceuticals6/7
Chemiie 24
SERVICES :-
and Non-Hazardous Waste Management
Solutions Pvt. Ltd.161
COPOEIA GRADE FINE
PR TER CTURER & EXPOR A MANUFFA
CHEMICALS
ODUCT LIST
AILABLE IN GRADES : IP / BP / USP/ EP/ FCC/ MUL AVA
l ALUMINUM AMMONIUM SULFATE (AMMONIUM ALUM) CAS 7784-25-0
l ALUMINIUMPOTASSIUMSULPHA TA ATTE (POTTAASSIUMALUM) CAS 7784-24-9
l ALUMINIUMSULPHAATTE CAS : 7784-31-8
l AMMONIUM CARBONATE CAS : 800-73-5
l YBADA AMMONIUM MOLLY ATTE CAS:12054-85-2
l AMMONIUM ACETTAATE CAS :631-61-8
l AMMONIUM SULFFAATE CAS : 7783-20-2
l AMMONIUM PHOSPHATE CAS :7783-28-0
l BISMUTH SUBCARBONATE CAS :04-10-5892
l BISMUTH SUBNITRAATTE CAS 1304-85-4
l BISMUTHCITRAATTE CAS :813-93-4
l BENZOIC ACID CAS :65-85-0
l XY BUTYLATED HYDRO YAANISOLE CAS :25013-16-5
l BUTYLAT HYDROXYTOLUENE CAS 128-37-0
l BOREX SODIUM BORATE CAS 1330-43-4
l BORIC ACID CAS 1303-86-2
l CALAMINE CAS 8011-96-9
l CALCIUM ACETTAATE CAS 574326-0
l CALCIUM CARBONATE CAS 471-34-1
l CALCIUM GLUCONATE CAS 18016-24-5
l CALCIUM CHLORIDE DIHYDRATE CAS 10035-04-8
l CALCIUM CITRAATTE CAS 813-94-5
l CALCIUMSULPHAATTE CAS 7778-18-9
l CARBAMIDE PEROXIDE CAS 124-43-6
l CITRIC ACID ANHYDROUS CAS 77-92-9
l CITRIC ACID MONOHYDRATE CAS 5949-29-1
l CALCIUMPHOSPHATEDIBASICDIHYDRA AT ATTE CAS : 7789-77-7
l CALCIUM PHOSPHAATTE DI BASIC ANHYDROUS CAS 7757-93-9
l CALCIUM PHOSPHAATTE TRIBASIC CAS 7758-87-4
l CALCIUM HYPOPHOSPHITE CAS:7789-79-9
l AHYDRA TE PENT CUPRIC SULFA TA ATTE CAS 7758-99-8
l CUPRIC SULFATE ANHYDROUS CAS 7758-98-7
l COPPERACETTAATE CAS 142-71-2
l COPPER CARBONATE CAS 12069-69-1
l CUPRIC CHLORIDE CAS 10125-13-0
l CHROMIUM PICOLINATE CAS 14639-25-9
l CALCIUMLACTATAATTE CAS 5743-47-5
l EDETTAATE CALCIUM DISODIUM CAS 23411-34-9
l TE DISODIUM DIHYDRA EDETTA A ATTE CAS 6381-92-6
l FERROUS SULPHAATTE DRIED CAS 13463-43-9
l AHYDRA FERROUS SULFATE HEPT ATTE 7782-63-0
l FERRIC AMMONIUM CITRATE CAS 1185-57-5
l MAGNESIUMACETATAATTE CAS 16674-78-5
l MAGNESIUM PHOSPHAATTE CAS 7757-87-1
l MAGNESIUMCARBONAATTE CAS 546-93-0
l ORIDEHEXAHYDRA MAGNESIUM CHL ATTE CAS 7791-18-6
l MAGNESIUMSTEARAATTE CAS:557-04-0
l MAGNESIUMCITRAATTE CAS:3344-18-1
l MAGNESIUM HYPOPHOSPHITE CAS 10377-57-8
l A MAGNESIUM SULFATTE7H2O CAS 10034-99-8
l A MAGNESIUM SULFATTEDRIED CAS 7487-88-9
l MAGNESIUM SULPHATE ANHTDROUS CAS :7487-88-9
l UCONA MAGNESIUM GL ATTE CAS 3632-91-5
l MANGANESE GLUCONTE ANHYDROUS CAS 6485-39-8
l A MAGNESIUM LACTATTE CAS 18917-93-6
l MAGNESIUM OXIDE CAS 1309-48-4
l POTASSIUMACETA TA TAATTE CAS :127-08-2
l POTASSIUMBENZOA TA ATTE CAS:582-25-2
l POTTAASSIUM HYDROGEN CARBONATE CAS298-14-6
l A POTTAASSIUMHYDROGENSLFATTE CAS 7646-93-7
l POTTAASSIUMCARBOBATE CAS 584-08-7
l POTTAASSIUM CHLORIDE CAS 7440-09-7
l POTASSIUMCITRA TA ATTE CAS 866-84-2
l POTASSIUMNITRA TA ATTE CAS 7757-79-1
l POTTAASSIUM METABI SULFITE CAS 16731-55-8
l POTTAASSIUMHYDROXIDE PELLETS CAS 1310-58-3
l POTTAASSIUMIODIDE CAS 7681-11-0
l POTASSIUMPHOSPHA TA ATTEMONOBASIC CAS 7778-77-0
l ASSIUM PHOSPHA POTTA ATTE DIBASIC CAS 7758-11-4
l POTTAASSIUMSODIUMTARTRATE CAS 6381-59-5
l POTASSIUM SORBATE CAS 592-00-1
l ARTRA ASSIUM BIT POTTA TA ATTE CAS 868-14-4
l PROPYL GALLAATTE CAS 121-79-9
l POTTAASSIUMSULPHATE CAS 7778-80-5
l POTTAASSIUMBROMIDE CAS 03-02-7758
l SODIUM ACETTAATE TRIHYDRATE CAS 6131-90-4
l SODIUM ACETTAATE ANHYDROUS CAS 127-09-3
l SODIUMASCORBAATTE CAS 134-03-2
l SODIUMCARBONAATTE CAS-144-55-8
l SODIUM BENZOATE CAS 532-32-1
l SODIUM CARBONAATTE ANHYDROUS CAS 497-19-8
l SODIUMCARBONATEMONOHYDRA AT ATTE CAS 06-11-5968
l SODIUM CHLORIDE CAS 7647-14-5
l SODIUM CITRAATTE TRIBASIC CAS 03-04-6132
l SODIUM PHOSPHATE MONOBASIC MO
CAS 10049-21-5
l SODIUM PHOSPHATE MONOBASIC ANH CAS 7558-80-7
l SODIUM HYDROXIDE PELLETS CAS 13
l SODIUM LAURYLSULFATE CAS151-21
l SODIUM METTAABISULPHITE CAS7681-5
l YBDA SODIUM MOLLY ATTE CAS 10101-40-6
l SODIUM SULFITE CAS 7757-83-7
l SODIUM PHOSPHATE DIBASIC ANHYDR
CAS 7558-79-4
l SODIUM PHOSPHATE DIBASIC DODECA CAS 10039-32-4
l TEDIBASICHEPT SODIUM PHOSPHA TAAH
CAS 7782-85-6
l SODIUM PHOSPHATE DIBASIC DIHYDR
CAS 10028-24-7
l SODIUM PHOSPHATE DIBASIC MONOH 118830-14-1
l SODIUM PHOSPHATE TRIBASIC DODEC CAS 10101-89-0
l SODIUM PHOSPHATE TRIBASICANHYD
CAS : 7601-54-9
l SODIUM NITRITE CAS : 7632-00-0
l SODIUMTARTRA TA ATTE CAS : 6106- 24-7
l TEPENT SODIUM THIOSULPHA TAAHYDRA
CAS : 10102-17-7
l A SODIUM THIOSULFATTEANHYDROUS : 7
l SODIUMSULPHAATTE CAS : 7757-82-6
l SODIUM SULFITE CAS : 775783-7
l STTAANNOUS CHLORIDE CAS : 10025-69-
l SUCCINIC ACID CAS : 110-15-6
l SODIUM SUCCINAATTE ANHYDROUS CAS
l SALICYLIC ACID CAS : 69-72-7
l SODIUM GLUCONATE CAS : 527-07-1
l SODIUM PROPIONAATTE CAS : 137-40-6
l SODIUMSELENITEPENTTAAHYDRATE CAS: 26970-82-1
l SODIUM ACID PHOSPHATE DIHYDRATE CAS : 13475-35-0
l SODIUM BISULPHITE CAS : 7631-90-5
l TARTTAARIACID CAS : 87-69-4
l TALC CAS : 14807-96-6
l UREA CAS : 57-13-6
l A ZINC ACETTAATTE CAS : 5970-45-6
l ZINC CARBONATE CAS : 3486-35-9
l FERROUSFUMARAATTE CAS141015
FERROUS FUMARA CAS 141-01-5
l FUMARIC ACID CAS 110-17-8
l LITHIUM CARBONAATTE CAS 554-13-2
l MANGENESESULPHATEMONOHYDRA AT ATTE CAS 10034-96-5
l MANGANESE CHLORIDE CAS 05-01-7773
l SODIUM CAPRYL
l SODIUM MONO F CAS 10163-15-2
l SODIUM NITRATE
l SODIUM PHOSPH 13472-35-0 KRONOX LAB S

Corporate Office & Mob: + 93132 310
Email: sales@kron Website: www.kron
7681-49-4
7631-99-4
l ZINCCITRATEDIHYDRATE CAS:5990
ZINC CITRATE DIHYDRATE CAS : 5990-
l ZINC OXIDE CAS : 1314-13-2
l AHYDRA TE HEPT ZINC SULPHA TA ATTE CAS
l TEMONOHYDRA ZINC SULPHA ATTE CAS: l ZINC CHLORIDE CASE : 7646-85-7
l ZINC GLUCONATE CASE : 04-02-4468
CIENCES LIMITED. Works adralDsit:V : Block No. 284 l Village: Dabhasa l P a adodara l Guja 74 / 9909966408 lFax: +91 2662 244088 oxlabsciences.com, info@kronoxlabsciences.com oxlabsciences.com
218 THE MAZADA PHARMA GUIDE
PRODUCTS
l l l l l l SPECIALITY PRODUCTS l l l l l l l TI COMPENDIAL
SPECIALITY
l
TIFIED COMP OSHER CER , GLP A GMPP, P, , ISO9001, FSSC 2200, FSSAI, HALAL& K T PA A V
PHARMA
) NY NOHYDRATE YDROUS 10-73-2 -3 7-4 OUS AHYDRAATTE HYDRATE RAATTE YDRATE CAS CAHYDRAATTE ROUS A ATTE 772-98-7 1 : 150-90-3 32-9 : 7446-20-0 7446-19-7 arat l India. TE SODIUM ACID PHOSPHA l OW IRON) TRA PURE (L TE UL TAAHYDRA AT MAGNESIUM SULPHATE HEPT l MAGNESIUMSULPHAATTEANHYDROUSUSP&EXTRAPURE l OW CALCIUM) TRA PURE (L LT AT MAGNESIUM CHLORIDE HEXAHYDRATE UL l ORIDE ANHYDROUS PURE MAGNESIUM CHL l ORIDE ANHYDROUS PURE CALCIUM CHL l LTTRAPURECALCIUMCARBONAATTEPRECIPITEDUL l PRODUCTS PECIALITY T AT TA TRI POT S ASSIUM PHOSPHA
TE AMMONIUM CARBONA l ATTE AMMONIUM BI CARBONA l TE (EP / BP/ USP) A CALCIUMACETTA l ORIDE SPECIAL GRADE (BROMIDE FREE) CALCIUM CHL l ORIDE ANHYDROUS MANGANESE CHL l ORIDE SPECIAL GRADE (BROMIDE FREE MAGNESIUM CHL l TE ANHYDROUS POWDER ASSIUM CARBONA POT l PRODUCTS PECIALITY OUS HIGH PURITY (TPP) S E ANHYDR
TE
DIHYDRA A ATTE CAS
ATE CAS :
LUOROPHOSPHAATTE CAS
MONOBASIC










Published and Edited by Mr. Prakash Anjalekar, on behalf of Mazda Publications, Gala No. 1A, Sharma Compound, Old Nagardas Road, Andheri (E), Mumbai - 4000 069, Maharashtra. • Tel.: 8652813388 • Email : mazdapharmaguide@gmail.com